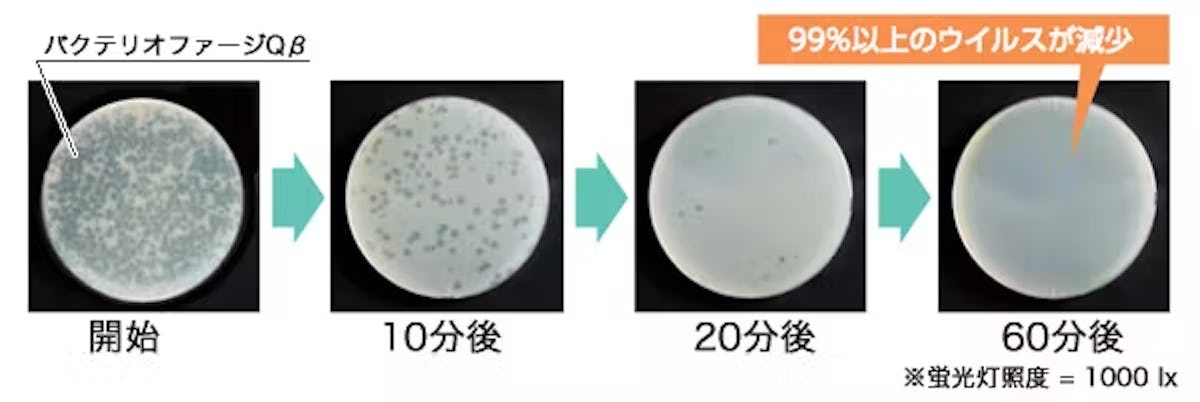

よくある質問
-
窓枠に物干し竿を取り付けることはできますか?

可能です。窓枠に設置できる物干し竿をご用意しています。
使用時は90度開いて物干し竿になり、使わないときは折りたたんでコンパクトに収納できます。必要なときだけ使えるため、空間をすっきり保ちながら室内干しに対応できます。
-
窓枠にガラス棚を取り付けることはできますか?
 可能です。窓枠部分にガラス棚を設置することで、小物置きやディスプレイスペースとして活用できます。空間をすっきり保ちながら実用性も高めることができます。
可能です。窓枠部分にガラス棚を設置することで、小物置きやディスプレイスペースとして活用できます。空間をすっきり保ちながら実用性も高めることができます。 -
障子部分を鏡に変更することは可能でしょうか?

可能です。障子部分を鏡に替えた「上げ下げミラー」としてご利用いただけます。
開口部をそのまま活かし、大きな鏡として使用することができるので、スペースを圧迫せず、すっきりとした空間づくりが可能です。
-
方眼罫(暗線)の間隔は何ミリですか?
 縦横ともに100ミリ間隔で区切られており、各マスの中央(50ミリ位置)に補助線が入っています。
縦横ともに100ミリ間隔で区切られており、各マスの中央(50ミリ位置)に補助線が入っています。
-
中桟はつきますか?
枠の強度保持のため、高さ800mm以上は中桟がつきます。 -
アクリルも広幅面取り加工はできますか
 可能です。「広幅面取り加工」の他、アクリルの側面を斜めに切り落とす「斜面取り加工」もご指定いただけます。
可能です。「広幅面取り加工」の他、アクリルの側面を斜めに切り落とす「斜面取り加工」もご指定いただけます。 -
なぜインド企業が注目されているのですか?
中国に匹敵する「規模の経済」を持ちながら、地政学的なリスクが比較的低く、コスト競争力と高いエンジニアリング技術を両立しているためです。 -
このニュースは日本のペロブスカイト開発に影響しますか?
はい。Waareeのような大手企業がガラス基板などの周辺部材を内製化し、欧州でエコシステムを構築すれば、ペロブスカイト太陽電池の量産フェーズにおける基板調達の選択肢やコスト構造に影響を与える可能性があります。
-
Waareeはペロブスカイトも作るのですか?
現在の主力はTOPConやHJT(ヘテロ接合)ですが、ガラスやセル製造の基盤を持っているため、将来的にペロブスカイトとのタンデム型へ移行する技術的・設備的ポテンシャルは極めて高いと言えます。 -
ペロブスカイトはいつから一般的に使われるようになりますか?
2025年現在、各地で実証実験が最終段階にあります。今回のEUの停滞を受け、政策的な後押しが強まれば、2020年代後半には都市部での商用利用が本格化すると予測されます。 -
なぜガラス加工技術が重要なのですか?
ペロブスカイト層は水分や酸素に弱いため、ガラスで精密に「封止(パッケージング)」する必要があるからです。長寿命化の鍵はガラス技術が握っていると言っても過言ではありません。 -
このカーテンだけで家の電気をすべて賄えますか?
現段階では難しいです。カーテンはあくまでスマホ充電や照明、家電の補助電力、および家庭用蓄電池への充電用として設計されています。しかし、エネルギーの「地産地消」には大きく貢献します。
-
室内でも本当に発電するのですか?
はい、発電します。BiLight社の製品は室内光(約500ルクス)でも駆動するよう調整されています。これがシリコン太陽電池にはない、ペロブスカイト特有の強みです。
-
発売はいつ頃ですか?
CES 2026での発表モデルであり、具体的な一般販売日は未定ですが、製品の完成度から見て2026年内の市場投入が期待されています。
-
どのような構造で発電するのですか?
従来のシリコン系のような厚い基板ではなく、薄膜の積層構造で成り立っています。
- 基板:ガラスやプラスチックフィルム
- 電荷輸送層:電子(マイナス)と正孔(プラス)をそれぞれ運ぶ層
- ペロブスカイト層:光を吸収し電荷を発生させる中心層(光吸収層) これらをナノメートル単位の薄さで積層することで機能します。
-
シリコン太陽電池との決定的な違いは?
「製造プロセス」と「形状」です。シリコンは高温でのインゴット生成とスライスが必要ですが、ペロブスカイトは溶液を塗布(印刷)するだけで製造可能です。また、フィルム状にできるため、曲面への設置が可能です。 -
ペロブスカイト太陽電池の寿命はいつ頃解決されますか?(将来性への関心)
2025年〜2026年にかけて限定的な用途から実用化が始まり、2030年頃にはシリコン製に匹敵する「20年以上の耐久性」の確立が予測されています。
- 現在の到達点:研究段階では既に連続2,000時間〜4,000時間の安定動作(屋外換算で数年分相当)が確認されており、IoT機器や屋内用などの「短〜中期利用」のフェーズには既に到達しています。
- 解決の鍵(封止技術):ペロブスカイト層は水分や酸素に弱いため、これらを完全に遮断する「高度なガラス封止(パッキング)技術」の開発が急ピッチで進んでいます。
- 将来の展望:2030年までの目標として、建材一体型(BIPV)として窓や外壁で20年以上稼働させるための、より堅牢な保護基板(強化ガラスや特殊バリアフィルム)との一体化が進められています。
-
日本のどの企業が開発をリードしていますか?
積水化学工業、東芝、パナソニックなどが世界トップクラスの技術を保有しており、各社が異なる強みを持って開発を牽引しています。
企業名 主な強み・特徴 積水化学工業 独自の「封止技術」により、世界初となるフィルム型の屋外耐久性を実現。2025年の事業化を目標としている。 東芝 「大面積化」に強みを持ち、フィルム型で世界最高の発電効率を記録。ビルの壁面設置などを想定。 パナソニック 建材一体型(BIPV)に注力。ガラスと太陽電池を一体化させた「発電するガラス」の実証実験をリード。 リコー 室内光(微弱光)での発電効率に優れ、電池交換不要のIoTデバイス用として既に製品展開を開始。 エネコート・テクノロジーズ 京都大学発のスタートアップ。三菱商事などと提携し、高効率かつ鉛フリーな材料開発に強み。 日本はペロブスカイトの主原料である「ヨウ素」の世界産出量シェア約30%(世界2位)を占めており、資源サプライチェーンの観点からも日本企業が世界をリードできる非常に有利な立場にあります。
世界市場の動向
Waaree社(インド)の動向 -
「アクアガラス」は取り扱っていますか?
「アクアガラス」は「アルトドイッチェK」とも呼ばれるガラスです。弊社ではアルトドイッチェKという名前で取り扱っております。

弊社から購入いただいたお客さまが寄せてくださった事例がございますので、併せてご覧ください。
カフェ風のリビングに!新築住宅の間仕切りと建具に「アルトドイッチェK」を使用した事例 (STUDIO KAZE様)
ご希望の方はお気軽にこちら(0120-12-4466)までお問合せください。
-
「中国産」の「モールガラス」はありますか?また他国と違いがありますか?
弊社では中国産のモールガラスの取扱いはございません。ヨーロッパ産のモールガラスのみの取扱いとなります。そのため、中国産とヨーロッパ産の違いは分かりかねます。
-
チェッカーガラスを縦・横共に目合わせしてほしいです
目合わせ加工は、縦方向・横方向のどちらか一方のみとなります。田の字に並べた場合の縦・横両方の目合わせは出来かねます。
横方向で目合わせした場合 縦方向で目合わせした場合 

縦方向での目合わせは出来ない 横方向での目合わせは出来ない 目合わせ加工は、縦方向・横方向のどちらか一方のみとなります。田の字に並べた場合の縦・横両方の目合わせは出来かねます。
横方向で目合わせした場合 縦方向で目合わせした場合 

縦方向での目合わせは出来ない 横方向での目合わせは出来ない -
「ぼかし山水」のサイズ(寸法)を変更すると絵柄はどうなりますか?
ご希望のサイズに合わせ、ぼかし山水の絵柄の一部を切り取って製作する形となります。切り取る絵柄の場所は自由です。例えば、写真のように赤枠の部分を切り取って製作することもできます。
-
「アルトドイッチェK」とフロートガラスを「合わせガラス加工」できますか?

アルトドイッチェKに合わせガラス加工はできかねます。
「合わせガラス」はガラスとガラスの間に中間膜(フィルム)を挟み込んで製作しています。今回ご質問頂いた「アルトドイッチェK」を含む、「両面ともに表面に凹凸があるガラス」は、中間膜(フィルム)との間に気泡が入り込んでしまうため、合わせガラス加工を行うことができません。
-
「アルトドイッチェK」の「うねり」の多い箇所でカットしていただけますか?
「アルトドイッチェK」は切り取る箇所によって柄は変わりますが、切り取る箇所の指定は出来かねます。ご了承ください。
-
「アルトドイッチェK」は両面に凹凸の柄があるガラスですか?
「アルトドイッチェK」は両面にテクスチャー(凹凸)があるガラスです。表面・裏面ではテクスチャーの規模が異なります。表面はテクスチャーが多く、裏面はテクスチャーが少ないです。
アルトドイッチェKの無料サンプルがございますので、是非 実際に手にとって確認してみてください。
-
外部サッシに「モールガラス」を使うと割れやすいですか?
「モールガラス」をペア加工し窓に設置するとのことですが、普通のガラスと同様に外部サッシにご利用できます。割れやすさは普通のガラスと変わりありません。 -
「DNA-0189」、「CTE-001」はガラスの色が違いますか?
「カラードアンティーク(DNA-0189)」と「クリアテクスチャ(CTE-001)」のガラスは製造元が異なるため、ガラスの色が若干違っております。
-
「デザインガラス」に「ステンド加工」はできますか?
デザインガラスに「ステンド加工」はできかねます。
目隠し効果をご希望であれば、向こうが見えにくい「型板ガラス」、向こう側が見えたほうがよろしければ、「透明ガラス」がおすすめです。


-
「デザインガラス」はガラスカッターでカットできますか?
モールガラス、アルトドイッチェK等の片面がつる面のデザインガラスであれば、つる面からガラスカッターでカットできます。
ただチェッカーガラスの様に両面に凹凸があるデザインガラスは切り難く、失敗しやすいため、プロによるカットをお勧めします。
弊社ではカット等のガラスの加工サービスも行っておりますので、お気軽にご相談ください。
-
「デザインガラス」で「角の丸い水槽」を作って頂けますか?
弊社ではデザインガラスの曲げは行っておりません。また、ガラスの曲げは1方向のみとなりますので、水槽などの製作はできかねます。ご了承ください。 -
家具屋で購入したローボードのすりガラスは修理可能ですか?
弊社ではガラスを家具に取り付けるなどの修理は出来かねますが、ご希望通りのガラスを制作し、お送りすることは可能です。
切断面が隠れる場合は、断面に凹凸が残り手の切れない程度の糸面取り加工がおすすめです。
-
テレビを載せる耐重量35キロ程度のガラス板を製作できますか?
ご希望通りのガラス板の製作が可能です。
ガラス板の厚みですが、耐重量35キロ程度の場合は厚み8ミリがおすすめです。
-
「酒瓶」を縦割りにできますか?
弊社では「酒瓶」を縦割りにできません。弊社のガラス加工はガラス板のみで、ビン等の加工には対応しておりません。 -
ガラスにミラーシートを貼ることは可能ですか?
ミラーシートをガラスに貼り付けるサービスはございません。
当社で取り扱いのあるシール状のミラーをご購入いただき、お客様ご自身で貼り付けていただく形になります。

-
桜の花びらの形をしたガラスをべベルのように面取り加工することはできますか?
桜の花びらのような形の場合、切り込み部分に広幅面取りを施すのは難しいです。涙形でしたら、サイズによってはご用意はできるかもしれません。
また、特殊なガラスになりますので、通常のガラスの価格と比べ高価になってしまいます。
-
スマートフォン等の保護シート(ガラス)の裁断依頼は出来ますか?
既製品の裁断や、裁断のみのご依頼は受け付けておりません。
市販のガラスフィルムに使用される、「ゴリラガラス」などの「化学強化ガラス」の販売は可能です。
-
ダイヤモンドカットなどのクリスタルガラスの四角いフォトスタンドの製作は可能ですか?
ガラスのフォトスタンドは、弊社では製作が出来かねます。
フォトスタンドに収める前面のガラスや、色紙を挟む平板のガラスのご用意は可能でございます。お気軽にご連絡ください。
-
レーザー彫刻のために「ソーダガラス」が必要ですが、取り扱いはありますか?
弊社で「フロートガラス」として販売しているガラスと、ご希望されている「ソーダガラス」は同じものですので、ご用意することが可能です。 -
「キッチンディバイダー」の図面のPDFはもらえますか?
寸法入り図面のPDF送付、可能です。お問合せページからお気軽にお申し付けください。 -
「青板ガラス(フロートガラス)」(10t)を指定のRに曲げたのちに外周を切り出す加工は可能ですか?
-
車のリヤガラスは作成できますか?
製作することは可能です。ただ、弊社でご用意できるガラスは全て建材用のガラスですので、車検などの条件を満たすものをお作りすることは出来かねます。
-
透明な板の下にライトを仕込む場合、強化ガラス・フロートガラス・アクリルのどれが良いですか?
ガラスやアクリル板の下にライトを仕込む場合、それほど温度が上がらないのであればどれでもご使用頂けます。
種別 耐熱温度 アクリル板 約80℃ フロートガラス(普通透明ガラス) 約110℃ 強化ガラス 約200℃ アクリル板は小傷がつきやすいので予めご了承ください。強化ガラスと比べてフロートガラスの方がお安くご用意できますので、普通ガラスがおすすめです。
-
防犯カメラのケースのガラス交換は可能ですか
ケースの交換用ガラスの制作は可能です。
ご希望のガラスのサイズ・厚みをお知らせ頂ければ、すぐにお見積りをご用意いたします。
-
ドーム状(半球状)のガラス加工は出来ますか?
ドーム状に3Dの曲げ加工は製作が出来かねます。
弊社で加工可能な形状は一方向にのみ曲げが入っているガラスとなります。
-
薄板ガラスはガラスカッターで切断できますか?
薄板ガラスの場合も、ガラスカッターでカットすることが可能です。 -
ガスオーブンレンジのガラスにおすすめの耐熱ガラスを教えて
ガスオーブンレンジに使用される場合、耐熱温度が700℃ある「ネオセラム」という耐熱ガラスがおすすめです。
耐熱温度が500℃の「テンパックス」という耐熱ガラスもあるのですが、こちらは急激な熱変化があると割れてしまいますので、オススメしません。
-
テーブルのガラス天板はフロートガラスと強化ガラスのどちらの方が需要が多いですか?
お子様のいらっしゃるご自宅では、安全面で強化ガラスを選ばれる方が多いです。
どちらの種類もよく使用されていますが、お子様のいらっしゃるご自宅ですと安全面で強化ガラスを選ばれる方が多くみられます。
強化ガラスはフロートガラスの3~4倍ほど強度が強く、万が一の破損の際には破片状ではなく全面に粒状に割れますので、安全性が高いガラスです。
-
店舗の「強化ガラス」のドアを「アクリル」に交換できますか?
交換は出来かねますが、お届けは可能でございます。
仮に、お届けまでであれば対応可能でございますが、厚みが3ミリまたは5ミリでのご用意となります。サイズと加工内容をお伝え下されば、詳しいお見積りをご提案させていただきますので、お申し付けください。
-
腕時計の保護ガラス用の直径14ミリ・R7・厚み1ミリ以下のガラスはありますか?
お求めやすい価格で「テンパックス」がございます。
一般的に腕時計のガラスに使われているものは、硬く、傷がつきにくい「サファイアガラス」という特殊なガラスになりますが、こちらはとても高価な素材なため、価格が高くなります。
お求め易い価格ですと、「テンパックス」という硬いガラスがございます。こちらの場合、ご希望の厚み(0.85ミリまたは0.9ミリ)ですとご用意できかねますが、 ご希望の厚みに近い0.7ミリ、または1.1ミリでしたらご用意可能です。
サファイアガラス テンパックス 

お求めやすい価格で「テンパックス」がございます。
一般的に腕時計のガラスに使われているものは、硬く、傷がつきにくい「サファイアガラス」という特殊なガラスになりますが、こちらはとても高価な素材なため、価格が高くなります。
お求め易い価格ですと、「テンパックス」という硬いガラスがございます。こちらの場合、ご希望の厚み(0.85ミリまたは0.9ミリ)ですとご用意できかねますが、 ご希望の厚みに近い0.7ミリ、または1.1ミリでしたらご用意可能です。
サファイアガラス テンパックス 

-
ベッドの桟をガラスをフロストガラスで隠したいのですが、もっと安いガラスはありますか?
ベッドの桟を隠すのであればカラー合わせガラスの不透明タイプをおすすめします。
不透明タイプのカラーは2色「ディープホワイト」および「ディープブラック」がございます。
不透過なカラー合わせガラスですと価格もフロストガラスの半分程になりますので、ご検討ください。

-
厚み0.5ミリの薄板ガラスを直径10ミリ~15ミリの円形にカットできますか?
厚み0.5ミリのガラスを直径10ミリ~15ミリの円形に切ることは可能です。 -
海中にいるようなイメージのガラスで強度が強いものはありますか?
海のイメージですと「カラー合わせガラス」がおすすめです。
2枚のガラスの間に色のフィルムを挟んだ合わせガラスですので、万が一破損した場合も、フィルムがガラスの飛散を防止する効果がございます。
サイズなどお決まりになりましたらお見積りをご用意致しますので、お気軽にお申し付けください。

-
5ミリ厚ガラス用の「アクリルスタンド」はありますか?
弊社では3、4、8ミリ用のアクリルスタンドのみ取り扱いがございます。
高さ約500ミリまでのパネルを立て掛けて飾ることができるコの字型のアクリルスタンドです。A4サイズのウェルカムボードやステンドグラスを飾るのに多く採用されています。


-
障子用ガラスを安く購入する方法を教えてください
ぼかし山水という障子用ガラスを希望のサイズにカットする方法をおすすめします。
サイズが823ミリ × 508ミリ、厚み3ミリ、切断処理Cランクの透明ガラス4枚を製作した場合、234,844円(2016年9月16日現在)となります。
「ぼかし山水」という障子用ガラスを希望のサイズにカットした場合ですと、約22万円くらいお安くなります。ぼかし山水という障子用ガラスですが、デザインが43種類あります。お好みのデザインを選んでいただき、ご希望のサイズにカットする流れとなります。
-
フロストガラスの凹凸面に印刷をすることはできますか?
フロストガラスの凹凸面にも印刷は可能です。
フロストガラスはガラスの表面をサンドブラストしてフッ酸処理を施したガラスです。凹凸のある面に印刷を行うことで、フロストガラス特有の凹凸感を残しながら、歪みなどのない綺麗な印刷を行うことが可能です。
実際に印刷した場合の見え方実際に印刷した場合、このような仕上がりになります。一般的な透明ガラスに比べて、凹凸がある分ツヤや光の反射などはほとんどありません。
また、印刷の仕上がりは普通のガラスに印刷した時と変わりなく、ドット柄も歪みなどなく綺麗に印刷されています。



フロストガラス以外にもにも様々なガラス、鏡に印刷が可能です。お希望のガラスがある場合は、印刷が可能なガラスか一度お問い合わせください。ガラスや鏡、アクリルに印刷を行った場合の見え方はこちらをご覧ください!
-
「キッチンディバイダー」に厚み5ミリのガラスは使えますか?
「キッチンディバイダー」はガラス厚8ミリ用のため、ガラス厚5ミリの商品はご使用できかねます。
ガラス厚8mmの「フロストミラーガラス」や「フロストガラス」であれば、組み合わせることができます。ただ、「フロストミラーガラス」は裏面が綺麗ではないため、キッチンディバイダーへの取り付けは推奨されません。
-
キッチンの油はねを防止するガラスは何がいいですか?
油はねを防止するガラスには「強化ガラス」がおすすめです。
強化ガラスは耐熱温度が200℃と高いので、揚げ物の際にも安心してご使用いただけます。また、一般的に使用される透明ガラスに比べて強度があり割れにくく、万が一割れてしまっても粒状になって割れるため破片が鋭くならず安全です。
キッチン周りの汚れを防ぎたい場合は、ぜひこちらのお電話番号(0120-12-5537)までお気軽にお問合せください。
-
厚みのあるフロートガラス切りっぱなしの切断面はどのようになりますか?
厚みのあるフロートガラスを切断した際は、切断面に凹凸が出ることがございます。
凹凸があるとご希望の寸法に収まらないことがありますので、指定のサイズにするためにアラズリ加工をかけることがございます。
部分的にアラズリ加工を施した場合は、次ような切断面になります。


 テーブルトップにご使用される場合など、ガラスの切断面を綺麗に仕上げたい場合には磨き加工をおすすめします。
テーブルトップにご使用される場合など、ガラスの切断面を綺麗に仕上げたい場合には磨き加工をおすすめします。 -
型板ガラスのルーバー窓を網入りの型板ガラスに交換できますか?
ガラスの厚みは大きくなりますが、問題なく交換することができます。
型板ガラス(Before)
 網入り型板ガラス(After)
網入り型板ガラス(After)
 ルーバー窓の交換で、他に気になる点、ご不明な点がある方はこちらのお電話番号(0120-12-4466)までお気軽にお問合せください。
ルーバー窓の交換で、他に気になる点、ご不明な点がある方はこちらのお電話番号(0120-12-4466)までお気軽にお問合せください。 -
分割したフロートガラスを合わせると、つなぎ目はどういった見え方になりますか?
フロートガラスは完全に透明ではなく、フロートガラス特有のクリアな緑色をしております。緑色が際立つのはつなぎ目、こちらは強化ガラスも同様の見え方となります。
緑色の線が引かれ、ひとつのデザインであるかのように見えますので、違和感なく映えます。実際にテーブル天板に使用した写真をご覧ください。


-
「ラミネートガラス」は取り扱っていますか?
「ラミネートガラス」は「合わせガラス」とも呼ばれるガラスです。弊社では合わせガラスという名前で取り扱っております。
他にご不明な点がある方や購入を検討される方はこちらのお電話番号(0120-12-4466)までお気軽にお問合せください。

-
「床用ガラス」の支えの掛かりはどれくらい必要ですか?
ガラス厚の2倍以上が枠の上にかかるように設置してください。
床用ガラスを設置する場合、基本的にガラス四方を枠に収める形になります。

そのため、四方枠の上にガラスの厚みの2倍以上掛かるように設置をお願いしています。
例えば 16ミリ厚(8ミリ + 8ミリ)の床用ガラスであれば、掛かりが16ミリ × 2 = 32ミリ以上必要になります。
ガラスの厚み(ミリ) 16ミリ (8ミリ + 8ミリ) 掛かり(ミリ) 32ミリ以上
※ ガラスの厚み16ミリ × 2倍 = 32ミリ 床ガラスのことでご不明な点がある方はこちら(0120-12-4466)までお気軽にご相談ください。
床ガラスのことでご不明な点がある方はこちら(0120-12-4466)までお気軽にご相談ください。 -
室内ドアの「ガラスの取り付け方」を教えてください
ガラスをはさむように押え縁でネジ止めして取り付けます。取り付けイメージがございますので、以下の図をご覧ください。

-
様々な種類のガラスの無料サンプルが欲しいのですが、お送り頂けますか?
通常、無料カットサンプルは5点まで、無料レンタルサンプルは2点まででお願いしております。
※無料レンタルサンプルは、お届けから1週間程で返却をお願いしております。
-
溶接用の遮光ガラスの色指定はできますか?
当社で取り扱いのある遮光ガラスは、緑色の1種類のみとなります。
-
サイズが2000ミリを超えるアクリル板は入手できますか?
アクリル(割れないガラス)の最大サイズ(1600×3600ミリ)の範囲内であれば製作可能です。
-
テーブルトップに「滑り止めシール」を使用すると、どのような見た目になりますか?
滑り止めシールは、直径1センチほどで厚みがなく薄いため目立ちません。「滑り止めシール」を使用したテーブルのお写真をご確認ください。

横から見るとこのような感じです。ほとんど浮かず、ベタ置きの状態になります。
滑り止めシールなし 滑り止めシールあり 

横から見るとこのような感じです。ほとんど浮かず、ベタ置きの状態になります。
滑り止めシールなし 滑り止めシールあり 

-
床用ガラスを安く購入する方法を教えてください
滑り止め無しタイプにしたり、ガラスを分割したりすることでお安くなります。

大きいサイズを1枚で購入 大きいサイズを分割して購入 サイズ 1510ミリ × 1200ミリ 503ミリ × 1000ミリ 枚数 1枚 3枚 滑り止め あり なし 価格 472,234円 217,002円 この場合だと、滑り止めタイプのガラス1枚と比べ、約半分の価格となりました。
価格についてのご相談もお気軽にお問い合わせください。
-
「遮熱ガラス(熱線反射ガラス)」を使用して、室内側からしか見えないようにできますか?
完全に見えなくすることはできません。
「明るい方からは暗い方が見えない」という遮熱ガラス(熱線反射ガラス)の特性上、昼間は外の方が明るいため「室内から外」の景色が見え、「外からは鏡のように反射」します。
また、夜間は室内の方が明るいため「外から室内」の様子が見え、「室内からは鏡のように反射」して見えます。
完全に見えなくすることはできないため、夜間はカーテン等を使用してて目隠しをされることをおすすめします。
一例として、昼間の窓ガラスの様子をご覧ください。
外から見た場合 室内から見た場合 

完全に見えなくすることはできません。
「明るい方からは暗い方が見えない」という遮熱ガラス(熱線反射ガラス)の特性上、昼間は外の方が明るいため「室内から外」の景色が見え、「外からは鏡のように反射」します。
また、夜間は室内の方が明るいため「外から室内」の様子が見え、「室内からは鏡のように反射」して見えます。
完全に見えなくすることはできないため、夜間はカーテン等を使用してて目隠しをされることをおすすめします。
一例として、昼間の窓ガラスの様子をご覧ください。
外から見た場合 室内から見た場合 

-
強化ガラスにサンドブラストやエッチング加工は可能ですか?
強化ガラスは深い傷が入るとガラス全面が粉々に割れてしまう特性を持っているため、堀りの深さを浅く加工するサンドブラストは可能ですが、深く彫るエッチングは不可となります。 -
IHクッキングヒーターの前にガラスの間仕切りを作りたい
-
「チェッカーガラス」を「ペアガラス」に加工できますか?
「チェッカーガラス(ヒシクロス)」と「透明ガラス」のペア加工でご用意が可能です。
チェッカーガラス以外のデザインガラスでもペア加工ができますのでお気軽にお問い合わせください。

-
ステンドグラスを縮小して注文する際の「最小サイズ」を教えてください
絵柄によって最小サイズは異なります。
弊社のステンドグラスは描線が細くても5ミリ程ございますので、サイズを大幅に縮小しますと描線がくっついてしまうことがあります。ご希望のサイズをお伝えいただければ製作可否をご連絡させていただきますので、お気軽にご相談ください。
また、下の表のように、元のステンドグラスの縦横比と異なる縦横比に縮小する場合、絵柄をすべて入れようとするとバランスが崩れますのでご注意ください。
元のサイズ 縮小したいサイズ イメージ 

サイズ 600ミリ × 1200ミリ
210ミリ × 120ミリ
縦横比 1 : 2 7 : 4 このような場合は、縮小をするのではなく、元の絵柄の一部分を切り取る「部分取り」がおすすめです。
絵柄によって最小サイズは異なります。
弊社のステンドグラスは描線が細くても5ミリ程ございますので、サイズを大幅に縮小しますと描線がくっついてしまうことがあります。ご希望のサイズをお伝えいただければ製作可否をご連絡させていただきますので、お気軽にご相談ください。
また、下の表のように、元のステンドグラスの縦横比と異なる縦横比に縮小する場合、絵柄をすべて入れようとするとバランスが崩れますのでご注意ください。
元のサイズ 縮小したいサイズ イメージ 

サイズ 600ミリ × 1200ミリ
210ミリ × 120ミリ
縦横比 1 : 2 7 : 4 このような場合は、縮小をするのではなく、元の絵柄の一部分を切り取る「部分取り」がおすすめです。
-
「ステンドグラス」に木枠がある場合・ない場合で納期は変わりますか?
ステンドグラスの内容にもよりますが、既製の柄を拡大縮小してご用意する場合は、木枠を付けても付けなくても納期は変わりません。 -
縦900ミリ × 横450ミリのステンドグラスをデザインから提案してほしい
ご使用の用途・デザインを伺った上でお見積させていただきます。
デザインについて
手書きのイラストやお写真からも制作が可能です。デザインによって価格が変わりますので、お見積りの際に簡単なイメージやお写真をお送りください。素板について
今回の場合は、ガラスの種類は「F4K(型板ガラス霞4ミリ)」でお見積りを考えております。他にご希望がございましたら、お気軽にお申し付けください。描線について
片面描線ですと、裏側は描線が薄くぼやけて見えます。両面に描線を描くことも可能です。片面描線・両面描線の2案でお見積りをご用意します。余白について
四方に余白がご必要でしたら、ご注文の際に余白寸法をご指定いただけます。詳細はフルオーダーステンドグラスの商品ページをご確認ください。
-
「DNA-0189」、「CTE-001」の無料レンタルサンプルをお送り頂けますか?
恐れ入りますが、「カラードアンティーク(DNA-0189)」と「クリアテクスチャ(CTE-001)」は無料カットサンプルのみで、無料レンタルサンプルのご用意がございません。ご了承ください。
種類 無料カット
サンプル無料レンタル
サンプルカラードアンティーク(DNA-0189) ○ × クリアテクスチャ(CTE-001) ○ × -
コの字アングルの間仕切りの見積もりで、ガラス寸法が開口部より小さいサイズになっているのはどうしてですか
コの字アングルを上下に取り付けてガラスの間仕切りを作る際には、ガラスのサイズを開口部よりも5ミリ小さく作ることが奨励されています。
弊社ではお客様から開口部のサイズをお伺いし、開口部のサイズから、コの字アングルの厚み・コーキングの余白を引いたガラス寸法を計算しております。
こちらの例では開口部の高さが500ミリとなっておりますので、コの字アングルを上下に取り付ける場合にはガラスの縦幅は495ミリになります。
ガラスが開口部に収まるように計算してお見積りしておりますので、ご安心ください。

-
「ガラス棚受けブラケット」の図面・サイズを見せてもらうことは可能ですか?
こちらが弊社の「ガラス棚受けブラケット」の図面になります。図面内に各部のサイズを記載しておりますので、お手持ちの支柱に合うかご確認ください。
-
プラモデルなどを置く飾り棚の細長い形状のガラスは強化ガラスでしょうか?
強化ガラスは、長辺:短辺=10:1の比率を超えると、熱入りの際に反りが発生する可能性が大きくなります。
この比率を超える場合は、反りが少ない「フロートガラス」をおすすめします。
また、「フロートガラス」も棚板としてご利用に充分な耐久性がありますので安心して使用いただけます。

-
「ガラス棚受けダボ」は石膏ボードでも使えますか?
石膏ボードでは使用できません。
石膏ボードが非常にもろく弱いため、ダボを留めるメス(金具)が取れてしまいます。
弊社で取り扱いのあるすガラス棚受けダボは、「ガラス地用」と「ガラス地中間板用」と「木地用」の3種類のみとなります。

-
建築業者ですが、ガラスを直接注文できますか?
工務店さま、建具店さま、リフォーム業者さま、ハウスメーカーさま、ガラス店さま、内装店さま、全ての建築業者さまが、OOKABE GLASS へガラスを直接ご注文いただけます。
ガラスの購入を検討の際はこちらのお電話番号(0120-12-4466)までお気軽にお問合せください。

-
工務店・建具店さんにガラスを直接送っていただけますか?
工務店・建具店さまに直接お送りすることが可能です。
送り先がご自宅では無い場合は、お問合せの際にその旨を弊社オペレーターにお申し付けください。

-
ガラスの中で一番薄いものの厚みは何mmですか?
0.03ミリの「極薄板ガラス(UTG)」が一番薄いガラスです。
-
ガラスの無料カットサンプルのサイズを教えてください
5センチ~10センチ程度の小さなサイズとなります。
-
届いたガラスが割れていたのですが、返送する際にどうやって梱包すればいいですか?
万が一、商品に不良品があった場合、お客様の方で梱包していただき返送をお願いしております。到着時に梱包されていたダンボールを捨てずに、もう一度ダンボールで包んで周りをガムテープで巻いて固定してください。
返送時の梱包方法
このようにダンボールに包んだ後、ガムテープで固定していきます。破損しているガラスでケガをしないよう気をつけて梱包を行ってください。
商品によって梱包形態が異なりますが、ガラスがはみ出さない安全な状態で梱包をお願いします。


 ガラスのことで不明な点がある方はこちらのお電話番号(0120-12-4466)までお気軽にお問合せ下さい。専門スタッフが丁寧に対応いたします。
ガラスのことで不明な点がある方はこちらのお電話番号(0120-12-4466)までお気軽にお問合せ下さい。専門スタッフが丁寧に対応いたします。 -
オーダーガラス板.comのサイトで図面を送信する際のメールアドレスを教えてください
下記のメールアドレスにお願いします。
メール : shop@ookabe-glass.com
-
お問合せやお見積り等の際、伝えたい事柄をオペレーターに上手く伝えるにはどうすれば良いですか?

電話上では言葉のやり取りのみとなってしまうため、オペレーターのイメージと、お客様のイメージとで、ズレが生じる場合がございます。
図面や絵をFAX・メールでお送り下されば情報が共有され、お客様とオペレーターのイメージが合致し、お話をスムーズに進めることができます。
手書きの図面で結構ですので、お手数ですがFAX・メールをお送りください。よろしくお願い致します。
- FAX : 0776-54-4566
- メール : shop@ookabe-glass.com
-
印刷したガラスは、屋外や水回りで使えますか?
屋外や水回り、地下などの湿気の多い場所での使用は、印刷のひび割れや剥がれの原因となりますので推奨しておりません。
直接水が当たる場所での使用は避け、コーキングをしたり、印刷面を室内側に向けたりしてご使用ください。
-
オンデマンドフルカラー印刷したガラスは、屋外や水回りで使えますか?
屋外や水回り、地下などの湿気の多い場所での使用は、印刷のひび割れや剥がれの原因となりますので推奨しておりません。
直接水が当たる場所での使用は避け、コーキングをしたり、印刷面を室内側に向けたりしてご使用ください。
-
銀モールガラスはありますか?
-
木枠で区切られている家具扉や建具の形状に合わせて、ガラスを加工してもらえますか?
曲線や複雑な形状の家具扉用ガラスをご希望の場合は、無料お見積りフォームから図面や手描きのイラストなどをお送りください。製作の可否を確認のうえ、お見積りをご返信いたします。 なお、一見すると木枠でガラスが区切られているように見える家具扉でも、実際にはガラスが1枚でつながっている場合があります。お手数ですが、お問い合わせ前に一度、ガラスが実際に区切られているか(1枚のガラスでつながっていないか)をご確認ください。
なお、一見すると木枠でガラスが区切られているように見える家具扉でも、実際にはガラスが1枚でつながっている場合があります。お手数ですが、お問い合わせ前に一度、ガラスが実際に区切られているか(1枚のガラスでつながっていないか)をご確認ください。 -
どんな窓にも内窓インプラスは付けられますか?
内窓インプラスには、一部、取り付けできない窓があります。
【取り付けできない窓の一覧】
窓の種類 窓の形状 取り付け不可の理由 内倒し窓 
室内側に倒して開けるため、内窓をつけるとぶつかって開けられなくなります。 回転窓 
窓が回転して動く構造のため、内窓の枠と干渉して動かせなくなります。 内開き窓 
室内に向かって開くため、内窓があると物理的に開閉できなくなります。 クーラー付き窓 
通気口が内窓で塞がれてしまうためクーラーの運転ができなくなります。 換気扇付き窓 
換気経路を内窓が遮ってしまうため、換気が機能しなくなります。 上げ下げ窓 
窓の開閉時、内側に倒す動作と内窓がぶつかるため設置できません。 天窓 
天井や傾いた場所にあるため、内窓が水平に取り付けられず、水漏れや落下の危険があります。 角度が90°以外の
L字型の窓
L字型の窓(コーナー窓)に内窓を設置する場合、方立(ほうだて)と呼ばれる部材が必要になります。コーナーの角度が90°以外(80°の鋭角や120°の鈍角など)の場合は、対応できる方立がないため取り付けができません。
直角以外のコーナー窓に内窓を付けたいという方には、メルツエンサッシ内窓をご提案しています。方立の角度・寸法をオーダーメイドで製作可能であるため、曲面の外窓など様々な窓タイプに対応できます。
※コーナー角が90°の場合は取り付け可能です。 メーカー仕様の「コーナー方位」を設置することで内窓の取り付けが可能になります。内窓インプラスには、一部、取り付けできない窓があります。
【取り付けできない窓の一覧】
窓の種類 窓の形状 取り付け不可の理由 内倒し窓 
室内側に倒して開けるため、
内窓をつけるとぶつかって開けられなくなります。回転窓 
窓が回転して動く構造のため、
内窓の枠と干渉して動かせなくなります。内開き窓 
室内に向かって開くため、
内窓があると物理的に開閉できなくなります。クーラー付き窓 
通気口が内窓で塞がれてしまうため
クーラーの運転ができなくなります。換気扇付き窓 
換気経路を内窓が遮ってしまうため、
換気が機能しなくなります。上げ下げ窓 
窓の開閉時、内側に倒す動作と内窓が
ぶつかるため設置できません。天窓 
天井や傾いた場所にあるため、
内窓が水平に取り付けられず、
水漏れや落下の危険があります。角度が90°以外の
L字型の窓
L字型の窓(コーナー窓)に内窓を設置する場合、
方立(ほうだて)と呼ばれる部材が必要になります。
コーナーの角度が90°以外(80°の鋭角や
120°の鈍角など)の場合は、対応できる
方立がないため取り付けができません。直角以外のコーナー窓に内窓を付けたいという方には、
メルツエンサッシ内窓をご提案しています。
方立の角度・寸法をオーダーメイドで製作可能であるため、
曲面の外窓など様々な窓タイプに対応できます。※コーナー角が90°の場合は取り付け可能
です。メーカー仕様の「コーナー方位」
を設置することで内窓の取り付けが可能に
なります。 -
「室内からは外の景色が見え、室外からは室内が見えない」ような窓ガラスはありますか?
当社では「マジックミラー」をご提案しています。

マジックミラーは、外の明るさと室内の明るさの差によって見え方が変わるガラスです。
昼間のように外が明るく、室内が比較的暗い場合は、室内から外の景色が見えて、外からは鏡のように反射して室内が見えません。
ただし、夜間など明るさの条件が逆になると、外から室内が見える状態になります。
そのため、「1日中、内側から外が見えて、外側から中が見えない」という状態を維持できるガラスは残念ながらありませんが、条件によって視線を遮る効果を得られるマジックミラーであればご用意可能です。
当社ではマジックミラーの無料サンプルもご用意していますので、お気軽にご相談ください。
外からの視線が気になる場合は「瞬間調光ガラス」もおすすめ

「瞬間調光ガラス スイッチビュー」は、透明・不透明を瞬時に切り替えられるガラスです。
開放感が欲しい場合は、透明にして窓からの景色を楽しむことができ、外からの視線が気になる場合は不透明にしてプライバシーを確保することができます。
使用シーンに合わせて開放感とプライバシー確保を両立できるため、ホテルの浴室にも採用いただいているガラスです。
-
中空ポリカに穴あけ加工はできますか?
-
木製シェルフ(レールタイプ)の取り付け方がわかりません
こちらからご確認ください。 -
木製シェルフ(レールタイプ)の詳細な寸法を教えて下さい
詳細な寸法は図のようになります。幅(W)は450mm、600mm、と商品ごとに異なります。

-
アルミシェルフ(レールタイプ)の取り付け方がわかりません
こちらからご確認ください。 -
アルミシェルフ(レールタイプ)の詳細な寸法を教えて下さい
詳細な寸法は図のようになります。幅(W)は300mm、450mm、600mm、と商品ごとに異なります。

-
ポリカーボネートで枠のないケースは作れますか?
恐れ入りますが、ポリカーボネートは接着剤との相性が悪く、接着部分に気泡が入ってしまうため、枠のないケースを製作することができません。
透明なケースをご希望の場合は、アクリルでの製作をご提案しております。アクリルであれば接着がきれいに仕上がり、立方体だけでなく円柱型などの形状にも対応可能です。仕上がりや強度の面でも安心してお使いいただけますので、ぜひご相談ください。
-
一部の面のみ曲がっているケースは作れますか?
 恐れ入りますが、当商品は画像のような平面と曲面を組み合わせた形状は製作できません。あらかじめご了承ください。
恐れ入りますが、当商品は画像のような平面と曲面を組み合わせた形状は製作できません。あらかじめご了承ください。 -
テンパードアに飛散防止フィルムを貼ることはできますか?
フレームの取付後であれば、飛散防止フィルムの貼り付けが可能です。
※周囲にわずかな隙間が生じる場合がございますが、効果・ご使用に支障はございません。
-
ドアのガラス部分を「色ガラス」にすることはできますか?
厚み8ミリまでの色ガラスに対応しています。
ご希望の際はお電話・お見積りフォームよりご相談ください。 -
アクリルパイプに「穴あけ加工」や「切り込み加工」はできますか?

当社のアクリルパイプは、「穴あけ加工」や「切り込み加工」が可能です。
丸穴や角穴など、加工の形状もご指定いただけます。
加工をご希望の方は、図面や簡単なイラストをお送りいただくと、スムーズにお見積もりいただけます。お気軽にご相談ください。
-
穴あけ加工で「小数点◎ミリ」といった細かいサイズの指定はできますか?
当社の穴あけ加工は、細かいサイズの指定も可能です。
細かいサイズで穴あけ加工をする場合は、ウォータージェット加工での穴あけとなります。
-
届いた段ボールに記載のある重量は商品の重量ですか?

段ボールに記載のある重量は、商品の重さではなく、配送用の「容積重量」です。
容積重量とは、荷物の大きさ(体積)から計算された「見かけの重さ」のことで、送料の計算に使われる数値です。
容積重量は「縦×横×高さ(センチ)÷5000」で計算できます。例えば、商品重量10kg、縦50センチ、横50センチ、高さ50センチの段ボールの場合、50×50×50÷5000=25kgが容積重量となります。送料は、実際の重さと容積重量を比べて大きいほうが採用される仕組みなので、この場合は要請給料の25kg分送料がかかるということになります。
-
IHトッププレートを交換したいのですが、「ネオセラムN-11」は販売していますか?
IH調理器などに使用されるガラス「ネオセラムN-11」は、IH機器本体のメーカーが専用部品として製品に組み込んでいるため、一般販売はされておらず、当社でもお見積りや販売の対応ができません。
恐れ入りますが、お求めの際はご使用の調理器メーカーへ直接お問い合わせいただきますようお願いいたします。
-
ポリカーボネートは曲げやすいですか?
ポリカーボネートは、80°~90°まで曲げても割れにくいという特徴があります。
そのため、熱をかけずに冷間でも曲げ加工が可能です。
-
アクリルブロックの製作はできますか?
-
アクリルの接着加工はできますか?
-
発行された領収書確認時に「ポップアップウィンドウがブロックされました」と表示されるときの対処法を教えて。
ご利用中のブラウザでポップアップブロックが有効になっている場合にこのようなメッセージが表示されることがございます。下記の手順でポップアップブロックを無効にしてからご利用ください。Google Chromeをご利用のお客様

右上のアイコンをクリック

設定をクリック

プライバシーとセキュリティを選択

サイトの設定を開く

ポップアップとリダイレクトを選択

「サイトがポップアップを送信したりリダイレクトを使用したりできるようにする」にチェックをつける
Microsoft Edgeをご利用のお客様

ブラウザーの上部の […] アイコンをクリック

設定を選択

プライバシー、検索、サービスを選択

サイトのアクセス許可をクリック

すべてのアクセス許可を選択

ポップアップとリダイレクトをクリック

サイトの追加を選択し、https://www.order-glass.com/を貼り付け・登録する
Safariをご利用のお客様

「設定」(または「環境設定」)を選択

Webサイトのタブを開く

左下のポップアップウィンドウを選択

サイト名の右側のボタンをクリック

[許可]に変更
-
施工計画書に必要な書類を用意できますか?
-
会員情報のメールアドレスを変更できますか?
サイトにログインし、マイページにある『会員情報変更』をクリックします。
『ログインの情報』をご選択いただき、変更内容を入力してください。弊社では、ログイン情報の変更ができませんので、お客様ご自身で変更いただくようよろしくお願いいたします。
-
今使っている強化ガラスをカットすることできますか?
強化ガラスは一度「強化処理」を施すと、後からカットや穴あけなどの再加工はできません。無理にカットしようとすると、一気に粉々に割れてしまう性質があるため、大変危険です。
サイズ変更をご希望の場合は、安全かつ正確にカットされた「サイズオーダー」での新規ご注文をおすすめしております。
-
網入りガラスに穴あけ加工はできますか?
網入りガラスは穴あけ加工を行うと高い確率で破損する恐れがあるため、当社では加工はお受けしておりません。
-
極薄板ガラスはハサミでカット可能ですか?
強度の低下や割れの原因となるため、お客様ご自身でのカットはできません。
ご希望のサイズがある場合は、安全かつ正確にカットした「サイズオーダー」でのご注文をおすすめしております。
-
万が一ガラスが割れても安全ですか?
はい、本製品には強化ガラスを使用しているため、万が一割れた場合でも、破片が細かく粉々になるように割れる性質があります。
尖った大きな破片になりにくいため、通常のガラスに比べてケガのリスクが大幅に軽減されています。 -
「キッチン油はねガードセット」はスタンドも付属していますか?
はい、セット品のため、ガラスとスタンドの両方が付属しています。届いてすぐにご使用いただけます。
-
アクリワーロンは曲げ加工できますか?
曲げ加工には対応しておりません。
-
アクリルパイプに底板を接着する加工は可能ですか?
はい、対応可能です。ただし、以下の条件があります:
・パイプの外径は300φ(ミリ)まで
・パイプの長さは500L(ミリ)まで
・底板の厚みは3ミリまたは5ミリのみ対応可能ご希望のサイズや仕様によっては対応できない場合もありますので、詳しくはお問い合わせください。
-
1ミリ以下の薄いガラスを、普通のガラスカッターでカットできますか?
通常のガラスカッターだと力加減が難しくガラスが割れる恐れがあるため、0.05~1.5ミリのガラスに対応しているガラスカッターPROを使用してカットすることをおすすめします。
-
ファイアライトは自分でカットできますか?
ガラスカッターという道具を使って、ご自分でカットすることが可能です。
-
ダブルやコーナーレスの突き合わせ部分は、どのような仕様になっていますか?
突き合わせ部分の仕様がわかるお写真などをご用意しますので、一度お問い合わせください。 -
取付できない場所などはありますか?
新築の場合は、基本的に取り付けが可能です。取り付け可能かご不安な方は、図面を送っていただければ当社にて取り付け可否をご確認します。お気軽にご相談ください。 -
網戸のメッシュサイズはどれくらいですか?
メッシュサイズがわかるお写真などをご用意しますので、一度お問い合わせください。 -
ボックスの色は選べますか?
ボックスの色は、白色のみをご用意しています。
-
縦引き(上から下へのスライド)でも使用できますか?
縦引きの網戸としても使用いただけます。
縦引きの場合、最大サイズは1000ミリ×1000ミリまでのご用意が可能です。
-
アクリルパイプを水槽として使用できますか?
水槽としてのご使用は可能です。
ただし、パイプを塞ぐような形でアクリル板とアクリルパイプを接着したいなどのご希望の場合、水密が必要な接着には対応しておりません。水密の必要がない場合は、溶接接着が可能です。※水密:水槽・管などが水を全く漏らさず、水の圧力に耐える状態
-
アイアン窓の寸法公差は?
寸法公差±1ミリです。
ただし、「長辺が2000ミリを超える場合」または「短辺が1000ミリを超える場合」は、寸法公差±1.2ミリとなります。 -
ペアガラスは接着加工できますか?
申し訳ございませんが、ペアガラスは製法上の理由により、接着加工ができません。あらかじめご了承ください。 -
割引が適用される基準を教えて。
会員割引および枚数割引は、当社の基準に基づいて適用されます。割引適用に関する具体的な理由や基準については、個別にお答えすることができかねます。予めご理解いただけますようお願いいたします。 -
インボイス対応の領収書は発行できますか?
はい、可能です。
マイページの「購入履歴」から、領収書をPDF形式でダウンロードいただけます。
▼マイページはこちら
https://www.order-glass.com/shop/member/mypage/▼領収書の発行方法はこちら
https://www.order-glass.com/shop/payment/#sec-2-9※代金引換の場合は、運送会社との二重発行を避けるため「請求書」を発行いたします。ご希望の方はお気軽にお申し付けください。
-
インボイス制度に対応していますか?
はい、対応しています。
当社は下記の通り、適格請求書発行事業者登録番号を取得しています。当社から発行する領収書・請求書はインボイスに対応しています。
【登録番号】T121000100810 -
ログイン用のメールアドレスもパスワードも忘れてしまった場合の対処法を教えてください。
お客様のご登録情報を確認しますので、過去のご注文番号を添えてお電話(0120-12-4466)・お問い合わせフォームより一度お問い合わせください。 -
ログイン用のパスワードを忘れてしまった場合の対処法を教えてください。
フォームより、ご登録いただいているメールアドレスをご入力ください。パスワードの再設定方法をメールでお知らせします。 -
パスワードを再設定したいが、再設定用のメールが届かない場合の対処法を教えてください。
再設定用のメールが届かない場合、ご入力いただいたメールアドレスに誤りがないか、今一度ご確認ください。
正しいメールアドレスをご入力いただいているにもかかわらず再設定用メールが届かない場合は、当社でご登録情報を確認の上、再設定方法をご案内いたします。
お手数ですが、お電話またはお問い合わせフォームよりお問い合わせください。
-
支払方法を「掛払い.com」または「後払い.com」にした場合、支払い期日を延長することはできますか?
支払い期日の延長については、運営会社の(株)キャッチボールへ直接お問い合わせください。
【電話番号】
掛払い.com:03-4326-3433
後払い.com:03-4326-3600 -
代金引換で支払った場合、領収書は発行できますか?
代金引換でお支払いの場合、運送会社が発行する「受領書」が領収書の代わりになります。 -
会員登録前に注文してしまい会員割引が適用されなかった。注文後でも適用できますか?
会員割引はご注文前のご登録が必要となるため、すでにご決済いただいている場合は割引対象外となります。 -
使用用途に最適なガラスの種類や厚みを知りたい。

無料お見積りフォームにて、お問い合わせを受け付けています。
使用用途など必要事項を入力し、ガラスの種類や厚みは「おまかせ」を選択してお送りください。当店がおすすめをご提案します。
-
「デザインガラスサンプル・アソートボックス」を注文する方法を教えて。
「デザインガラスサンプル・アソートボックス」は、弊社姉妹サイトの「e-sample.jp」またはお電話(0120-12-4466)よりご注文をお受けしております。
数に限りがございますので、すぐにご注文いただけるお電話がおすすめです。
-
サンプルを請求する方法を教えて。
サンプルのご請求は、弊社姉妹サイトの「e-sample.jp」から依頼をお受けしております。
-
注文可能なガラスの枚数を教えて。
当店では、ガラス1枚から注文が可能です。100枚以上の大量注文も受け付けています。 -
特注品の加工・製作が可能か知りたい。
無料お見積りフォームから、ご希望のサイズ・加工などを記載してお送りください。
製作・可否を確認し、お見積りをご返信いたします。
-
板ガラスを裁断のみで注文した場合、手が切れないように面取りはしてありますか?
板ガラスを裁断のみ(無料)で注文した場合、手が切れない面取りはしてありません。
面取りをご希望の方は、ご希望の処理をお選びください。
当店では、ガラスの切断面を4ランクに分けています。用途やご予算、ご希望に合わせてご指定いただけます。 糸面取り
糸面取り手が切れない程度に軽く面取り
 磨き加工(アラズリ)
磨き加工(アラズリ)まっすぐに仕上げる
 磨き加工(ミガキ)
磨き加工(ミガキ)まっすぐ・ツヤツヤな仕上がり
 切りっぱなし
切りっぱなし手が切れるほど鋭い
-
会員登録をしたのに割引されていない場合の対処方法を教えて。
OOKABE会員に登録しても割引価格にならない場合、一度ログインし直してから、再度カートにで購入手続きをお試しください。
それでも反映されない場合、お手数ですがお見積りフォームから見積依頼後、ご注文にお進みいただくか、お電話(0120-12-4466)にてご注文いただくようお願いいたします。
-
ガラス用の「工具」や「金物」を購入する方法を教えて。
ガラス用の「工具」は下記からご購入いただけます。ガラス用の「金物」は当店の姉妹店であるガラスのホームセンター「ギヤマン」でご購入いただけます。 -
カートで注文した商品をキャンセルしたい場合、注文から何日後までに手続きが必要か教えて。
カートで注文した商品をキャンセルしたい場合、以下の日時までにキャンセルの手続きをお願いします。
午前中にご注文した場合
当日12:00までにご連絡ください。午後にご注文した場合
翌営業日の12:00までにご連絡ください。※製作が進んでいるとキャンセルできない場合がありますので、ご了承ください。
※商品のキャンセルは、お電話(0120-12-4466)またはお問い合わせフォームで承っております。お急ぎの方はお電話でご連絡ください。 -
カート注文後、注文確認メールが届かない場合の対処を教えて。
注文確認メールが届かない場合、下記のようなことが原因として考えられますので、 一度ご確認をお願いいたします。
- お客様が登録したメールアドレスが誤っている
- 迷惑メール、受信拒否などに設定されている
- メールボックスの容量が一杯になっている
※注文確認メールが届かない場合でも、ご注文がご購入履歴に反映されている場合は、 正常に注文が完了しております。
上記のいずれにも当てはまらない場合は、お電話(0120-12-4466)またはお問い合わせフォームから以下の情報と注文確認メールが届かない旨をお伝えください。
- お客様のお名前
- お客様の電話番号
-
カート注文後、注文確認メールが届くまでの時間を教えて。
カート注文後、1営業日以内に注文確認メールが届きます。
営業日:月曜日~土曜日
営業時間:9:00~18:00 -
銀行振込(前払い)をする場合、振込先が書かれたメールが届く時間を教えて。
銀行振込(前払い)をする場合、ご注文後、1営業日以内にお振込先や発送日のご連絡をいたします。
(営業日:月曜日~土曜日 営業時間:9:00~18:00) -
支払い手数料はいくらかかるのか教えて。
支払い手数料は以下の通りです。
銀行振込(前払い)・請求書後払いの場合
各銀行にて定められた振込手数料をお支払いください。代金引換の場合
代引金額に応じて、以下の代引き手数料をお支払いください。代金引換額 代引手数料(税込) 1万円未満 330円 1万円以上 無料 -
利用できる支払方法を教えて。
-
荷揚げ(商品を搬入口から指定の部屋や場所まで運び入れること)をしてほしい場合、依頼する手続きを教えて。
荷揚げのご依頼は、お電話(0120-12-4466)またはお問い合わせフォームで承っております。お急ぎの場合はお電話(0120-12-4466)にてご連絡ください。
※荷揚げには別途費用がかかります。
-
カート注文後、商品が発送されるまでの時間を教えて。
カート注文後、商品が発送されるまでの時間は、商品によって異なります。発送日が決まり次第、注文後にご連絡します。
お急ぎの場合は、お電話(0120-12-4466)またはお問い合わせフォームまでお問い合わせください。
-
商品の配送先を注文後に変更する方法を教えて。
商品の配送先を注文後に変更したい場合、以下の日時までにお電話(0120-12-4466)またはお問い合わせフォームからご連絡をお願いします。
午前中にご注文した場合
当日12:00までにご連絡ください。午後にご注文した場合
翌営業日の12:00までにご連絡ください。 -
到着時間の指定ができないケースを教えて。
以下の条件がどちらも当てはまる場合、日時指定ができません。
- 幅と高さの合計が1400ミリよりも大きい場合
- 商品を個人宛に送る場合
-
到着時間の指定をする場合、指定できる時間帯を教えて。
到着時間を指定できる時間帯は、商品のサイズによって変わります。
-
到着日は、注文日の何日後から指定できるのか教えて。
ご注文いただく商品・サイズによって、製作期間が異なります。
お急ぎの方は、お電話(0120-12-4466)またはお問い合わせフォームにてご連絡ください。
-
注文した商品の到着日が知りたい。
ご注文後の注文確認メールにて「お届け予定日」をご連絡していますので、ご確認ください。 -
希望商品の最短納期が知りたい。

-
納品書を送ってもらうための手続きを教えて。

納品書を依頼するための手続きは特にございません。
商品に納品書を同梱します。※当店では金額の記載がない納品書をお送りしています。金額の記載が必要な場合は、注文確認画面の「備考欄」に「納品書への金額掲載必要」とご記入ください。
-
返品・返金の手続きを教えて。
お問い合わせフォームにて必要事項を記入し、送信ボタンを押してください。担当のスタッフが迅速に対応します。 -
商品の返品・交換・返金対応をしてもらえる期間を教えて。
返金・返品・交換をお受けできる期間は、以下の通りです。
・運送中に商品が破損していた場合
商品到着から14日以内・お客様が商品を誤って破損した場合
・お客様が商品のサイズを間違えて注文した場合ブロンズ会員 30日以内 シルバー会員 ゴールド会員 プラチナ会員 90日以内 ※保証額の割合や上限、保証期間は会員ランクによって異なります。詳しくはこちらをご確認ください。
-
返金・返品・交換ができるケースや、保証内容を教えて。
返金・返品・交換ができるのは、以下のようなケースです。それぞれのケースで、保証内容が異なります。
- 運送中に商品が破損していた場合:100%保証
- お客様が商品を誤って破損した場合:最大100%保証(最高上限額60,000円)
- お客様が商品のサイズを間違えて注文した場合:最大100%保証(最高上限額50,000円)
※保証額の割合や上限、保証期間は会員ランクによって異なります。詳しくはこちらをご確認ください。
※以下のような場合は返金・返品・交換をお受けしておりません。
- 取り付け、貼り付け等、施工されている場合
- 第三者に販売された場合
- 送り先から、現場等へ移動された場合
-
届いた商品が受け取り時に割れていた場合の返金額を教えて。
ご注文の商品が受け取り時に割れていた場合、商品代金の100%を当社にて負担して、商品を再製作いたします。
-
商品のサイズを間違えて指定していた場合の返金額を教えて。
ご注文の商品サイズをお客様が間違えていた場合、商品代金の最大100%、かつ、最大50,000円(税込)までを当社にて負担して、商品を再製作いたします。
保証額の割合や上限、保証期間は会員ランクによって異なります。詳しくは下の表、またはこちらをご確認ください。
 ※【ブロンズ会員様へのご案内】商品の発送後にサイズ・種類・厚みの間違いが発覚した場合は、保証額が商品代金の50%(上限3万円)となります。発送前に今一度、ご注文内容の再確認をお願いいたします。
※【ブロンズ会員様へのご案内】商品の発送後にサイズ・種類・厚みの間違いが発覚した場合は、保証額が商品代金の50%(上限3万円)となります。発送前に今一度、ご注文内容の再確認をお願いいたします。 -
届いた商品を自分で割ってしまった場合の返金額を教えて。
ご注文の商品をお客様が誤って割ってしまった場合、商品代金の100%、かつ、最大60,000円(税込)までを当社にて負担して、商品を再製作いたします。
保証額の割合や上限、保証期間は会員ランクによって異なります。詳しくは下の表、またはこちらをご確認ください。

-
参考納まり図はありますか?
お問い合わせをいただいた方に、メールでお送りしております。 -
現物を確認することはできますか?
福井県福井市にて、横4メートルの網戸を確認いただけます。希望される方はお問い合わせください。 -
製品の強度は?
2種類のJIS試験を実施し、合格しております。
①網の保持力試験(40キロの重りにて合格)
②開閉試験(開閉回数1万回にて合格)
試験成績表をご希望の方は、お問い合わせください。 -
浴室扉の飲み込みは何ミリ見ればいいですか?
通常窓の飲み込みと同じで12ミリ見ていただければ大丈夫です。
例:内寸+縦横12ミリ=実寸 -
カウンターチャンネルを使用する場合、ガラスは最大何ミリまで使用可能ですか?
W2000ミリ×H300ミリまで使用可能です。 -
ステンレス内装用パネルは、曲げ加工はできますか?
曲げ加工はできません。 -
アクリル(泡入り)の泡の数を増やしたり減らしたりできる?
仕上がっている板をカットしているため、泡の数をオーダーで作ることはできません。 -
サインスタンド(傾斜タイプ)のガラスの対応厚みは?
5ミリです。 6~8ミリを使いたい場合は、「傾斜挟み込みタイプ」であれば使用可能です。 -
サウナ用のドアを探しています。テンパードアとガラスドアの違いは?
テンパードアは埋め込みするタイプで、ガラスドアは壁付のヒンジで固定するタイプです。
サウナの場合は壁付のヒンジで固定するタイプが一般的です。 -
L型バーハンドル GP2670の先端部分(キャップ部分)の素材は?
ハンドル本体と同じ、鏡面またはMB仕上げです。 -
フローラガラスの目合わせ加工は可能ですか?
柄の目合わせが可能です。柄の方向と同じ方向での目合わせ加工のみとなります。(例:縦柄の場合縦目合わせのみ) -
アクリルと塩ビはどちらの方が傷つきにくいですか?
アクリルの方が傷つきにくく、劣化もしにくいです。 -
スチールボードをチョーク用に印刷加工はできますか?
印刷加工はできますが、チョークでの書き込みはできません。水性ペンでの記入が必要となります。 -
枠を付けた状態でスチールボードを用意していただくことは可能ですか?
アルミミラーエッジガードであれば、枠をつけてのご用意が可能です。 -
ストライプ柄のビジオサン・エストラド・モールガラス12ミリ幅で迷っています。安価でおすすめの商品はどれですか?
一番安価なのは、モールガラス(12ミリ幅)です。次に安価なのがエストラド(5ミリ幅)、最後にビジオサン(5ミリ幅)となります。
モールガラス12ミリ幅がストライプ柄の中で一番人気の商品です。ガラスの向こう側を見えにくくしたい場合は、ピッチが細かいエストラドやビジオサンがおすすめです。 -
セッティングブロックはカットできますか?
ゴム製のため、カッターでカットできます。 -
フロストガラスやすりガラスなどにフィルムを貼ることは可能ですか?
ツル面になら貼り付けることが可能です。 -
極薄板ガラスの素材は?
ホウケイ酸ガラスです。 -
ガラス管の材料証明書は発行可能ですか?
発行可能です。 -
石英ガラスの耐熱温度は?
約1000℃です。 -
モールガラスの柄は両面にありますか?
柄は片面のみです。片面はまっすぐな状態になっています。 -
中空ポリカは、+0ミリ/-0ミリ指定できますか?
指定できません。公差±2ミリとなるので、事前に注文サイズの調節をお願いします。 -
ペアガラスをコーナー用に上から見て45°カット加工できますか?
製作できません。断面はまっすぐでのご用意となります。 -
SAG-025 アルトドイッチェKを使用したステンドグラスは製作できますか?
アルトドイッチェKなど、気泡が入るガラスへのステンド加工はできません。
気泡のあるガラスを使用したい場合は「ステンド風アイアン窓 アイアンフレームIII」がおすすめです。 -
バックアップ材の直径は?
直径6ミリです。 -
エッチング加工は屋外で使用できますか?
屋外用の仕様で用意可能です。見積もりをご用意するので、ご相談ください。 -
ぼかし効果のあるもので、かつ汚れが目立ちにくいガラスは?
フロストガラスをおすすめします。 -
フロストガラスをテーブル天板(直置き)した場合の見え方は?
フロストガラスは、対象物と密着しているとほとんど透明のように見えます。
テーブルトップとして使う際に、テーブルの上に直に敷くとフロストの乳白のような風合いはなくなってしまうのであらかじめご了承くださいませ。 -
ZIProllのスポンジテープの厚みは?
厚みは3ミリになります。 -
アクリルの乳半は透けないですか?
触ると若干透けて見える程度です。光もわずかに透過します。 -
ブルーペンガラス(色ガラスブルー)はありますか?
ブルーは廃盤になっており、ご用意できません。
グリーン、ブロンズ、グレー、ブラックはご用意可能です。 -
内窓DIYキットの中空ポリカの種類は透明のみですか?
透明以外にも、乳半/クリアフロストなどがあります。 -
乳白のアクリルパイプは用意できますか?
L1000ミリまでであれば、ご用意可能です。 -
アルミ複合板にR加工はできますか?
可能です。 -
テンパックスに名入れ加工はできますか?
可能ですが、浅堀になる可能性があります。 -
ストライプ柄のビジオサン・エストラド・モールガラス12ミリ幅で迷っています。安価でおすすめの商品はどれですか?
一番安価なのは、モールガラス(12ミリ幅)です。次に安価なのがエストラド(5ミリ幅)、最後にビジオサン(5ミリ幅)となります。
モールガラス12ミリ幅がストライプ柄の中で一番人気の商品です。ガラスの向こう側を見えにくくしたい場合は、ピッチが細かいエストラドやビジオサンがおすすめです。 -
内窓DIYキットの中空ポリカは厚み何ミリですか?
中空ポリカの厚みは4ミリです。 -
ガラス用フィルムのみの購入は可能ですか?
購入いただけます。下記ページよりご希望の品番を指定いただければ、お見積いたします。
フィルムガラスの商品ページを見る
-
枠無しに変更した規格品フィルムミラーを、横並びで使用できますか?
製造上、つなぎ目に隙間ができる可能性があります。横並びで使用する場合は、大型連結タイプをおすすめします。 -
ステンレスキッチンパネルのつなぎ目はどのような施工を推奨していますか?
つなぎ目はコーキング等せずにそのまま施工いただくほうが、綺麗な見た目に仕上がります。 -
シンプル内窓DIYキットは浴室に設置できますか?
浴室にはご使用いただけません。浴室に内窓を使用したい場合には「インプラス 浴室仕様」または「フクマド(浴室簡易内窓)」がおすすめです。 -
コの字アングルに使用するセッティングブロックはカットできますか?
セッティングブロックはゴム製のため、カッターでカットできます。 -
強化ガラスはゆっくり割対応可能ですか?
強化ガラスはゆっくり割対象外です。強化ガラスの規格サイズ、フロートガラスにすることで、より安価にご購入いただけます。 -
色ガラス強化仕様と普通ガラス仕様で色味は変わりますか?
変わりません。 -
木枠選択ガラスシステムの寸法公差は?
寸法公差±3ミリです。 -
アクリルパイプに目盛加工はできますか?
できません。ガラス管には目盛加工可能です。 -
樹脂ガラスは型板仕様でも用意できますか?
できます。厚み2mm、3mm、4mmの3種類をご用意しています。 -
間仕切りポールH250ミリは製作できますか?
間仕切りポールは100ミリピッチでの製作となるため、H250ミリには対応しておりません。
ガラスの高さは1ミリ単位でご指定いただけますので、お気軽にご相談ください。 -
交換後のガラスは処分してもらえますか?
送料お客様負担の上、当社まで送っていただければ無料で処分します。 -
アクリルとポリカはどちらが傷つきやすいですか?
ポリカの方が傷つきやすいです。 -
注文したのにマイページの購入履歴がありません。
ログインせずに購入した場合、履歴に残らない可能性がございます。
原因をお調べしますので、お手数ですが0120-12-4466までご連絡ください。※注意※
施工案件は、システムの都合上で反映されません。
ただし、カートから注文した場合は、マイページの購入履歴は残ります。 -
領収書DLボタンがありません。
-
会員登録前にカート注文してしまった。購入履歴に反映されませんか?
購入履歴につきましては、弊社からのご注文確認メール送信後に反映されます。 -
飛散防止フィルムを貼ることで見え方は変わりますか?
透明なフィルムのため見え方は変わりません。 -
DIY内窓セットの取っ手を入れるコツを教えてください。
中空ポリカーボネートとフレームの間を軽く広げるようにしながら差し込むと、取っ手が入りやすくなります。 -
ポリカとアクリルどちらの方が透明度が高いですか?
アクリルの方が透明度が高いです。 -
油はガード ウォールタイプをビス止めできない場合の取り付け方法は?
両面テープとシリコンで取り付け可能です。 -
ガラスの厚み5ミリ用と8ミリ用のコの字アングルの厚みはどれくらいですか?
ガラスの厚み5ミリ用・8ミリ用共に、コの字アングルのアルミ製は厚み1ミリ・ステンレス製は厚み0.6ミリです。 -
ポリカーボネートは自分でカットできますか
アクリルカッターで切断可能です。
-
デザインガラスを自分でカットする際、ツル面側・ザラ面側どちらからカットすればいいですか
ツル面側にガラスカッターで線を入れてカットください。 -
キッチンディバインダーは自分でカットできますか
チップソー切断機でカットできます。
カットの際はゆっくり切断して、金具側面の取付穴は残してください。ただし、メッキ剥がれ等が起こるため、綺麗には切断が出来ない可能性があります。 -
シューズボックスの施工に下地は必要ですか?
シューズボックスの施工には下地が必要です。施工前に、ベニヤ・鉄板などの下地があることをご確認ください。
-
アソートボックスに入っているガラスを教えてください
アソートボックスのガラス一覧をご確認ください。
ご希望のガラスが含まれていない場合は、別途サンプルをご用意いたしますので、お気軽にお問い合わせください。 -
油はねガードセットにバックアップ材・セッティングブロックは付属されてますか
付属されています。
セット内容はこちらです。
・強化ガラス
・コの字アングル×2
・バックアップ材×1
・セッティングブロック×2 -
アルミ樹脂複合板に、印刷加工はできますか
可能です。
インクジェットシート+ラミネート貼りでのご対応となります。屋外での使用も可能です。 -
オンデマンド印刷は屋外で使えますか
オンデマンド印刷は傷や水分に弱いため、屋外では使用できません。
屋外での使用には、ガラスに彫り込みを入れて塗装する「エッチング印刷」がおすすめです。 -
1216×2432ミリより大きいカッティングマットを使いたい。
1216×2432ミリ以上の特大サイズをご希望の場合、複数枚のカッティングマットを突き合わせてご使用ください。
-
生地の洗濯方法を教えてほしい。
生地によって最適な洗濯方法は異なります。
回数 洗濯方法 遮熱タイプ 年1回 しわにならないようにたたみ、
ネットに入れて洗濯機で洗います防水タイプ 年1回 しわにならないようにたたみ、
ネットに入れて洗濯機で洗います採光タイプ 年2回 しわにならないようにたたみ、
ネットに入れて洗濯機で洗います -
使わない生地の保管方法を教えてほしい。
使わない生地はできるだけ湿気の少ないところで保管してください。 -
切断面を露呈した状態でも使用可能ですか?
使用可能です。
水がかかるような場所に施工する際は、劣化防止のため、切断面を保護してご使用ください。 -
屋外でも使用可能ですか?
屋外でも使用いただけます。
劣化防止のため、中間膜に水分が付着しないよう、コーキング処理などで保護してご使用ください。 -
「コの字チャンネル」「L字アングル」に同梱されている取付ビスの場所を教えてください。
「コの字チャンネル」「L字アングル」の本体に貼り付けられています。
-
ガラス間仕切りポール用に剥がして使ったビートの残り部分は使用できますか?
ポールに引っ掛ける部分が無くなってしまうため、使用できません。

-
高さが300mm以上のガラス間仕切りポールはありますか?
最大750mmまで、オーダーサイズでお作りすることが可能です。ただし、高さが750mmに近づくほど、直線的な使い方では倒れる危険性が高いため、倒れにくい「L字」や「T字」、「コの字」に設置してお使いください。
また、掲載している300mmのポールは、ガラスの上部をはみ出させて取り付けできるタイプで、ガラスの高さ 450mm まで対応しています。
- ポールの高さが高くても使える設置法

- ポールの高さが高い場合に使えない設置法

-
ガラス間仕切りポールに使用できるガラスの最大サイズはどのくらいですか?
間仕切りポールに設置するガラスの最大サイズは、ポールの高さによって異なります。
ポールの高さ+ポールの高さの半分までのサイズであれば倒れることなく安全にご利用いただけます。
例)高さ400ミリのポールの場合

-
ガラス間仕切りポールのポール部分の詳細な寸法を教えて下さい
ガラス間仕切りポールの詳細な寸法は下の図のようになります。ご確認ください。

-
フロストガラス等、他のガラスは使えますか?
可能です。お使いになりたいガラスについて、お気軽にお問い合わせください。
-
窓枠・格子のサイズを指定できますか?
ご指定いただけます。
製作可能かを判断するために、図面をお見積りフォーム・メールまたはFAXにてお送りください。 -
納まり図の製作は可能ですか?
可能です。
お支払い確認後に製作を開始しますので、納まり図をご希望の方は担当のオペレーターにお伝えください。 -
防水加工は可能ですか?
この商品は室内で使用することを前提に製造されているため、防水加工には対応しておりません。 -
オイル塗装は可能ですか?
可能です。
オイルは通常「クライデツァイト(自然塗料)」を使用しています。
ご希望のメーカーがあれば都度確認いたしますのでお気軽にお申し付けください。 -
抗菌ガラスの効果がある菌・ウイルスを教えてください。
大腸菌などの細菌やインフルエンザなどのウイルスの低減に効果を発揮します。
表は、実際に効果が確認できている抗菌・抗ウイルスの一例です。
抗菌性 ・大腸菌
・黄色ブドウ球菌
・緑膿菌
・レジオネラ
・メチリン耐性黄色ブドウ球菌(MRSA)
・多剤耐性緑膿菌(MDRP)
・多剤耐性アシネトバクター(MDRA) など抗ウイルス性 ・インフルエンザウイルス
・ライノウイルス
・ネコカリシウイルス など抗カビ性 ・黒毬カビ
・カンジタ、アルビカンス など -
ワーロンシートの防炎製品である「証明書」は発行できますか
「防炎製品認定品」と記載がある商品は、証明書のコピーが発行できます。ワーロンシートをご購入いただいたお客様の中で認定書が必要な方はお問い合わせフォーム・お電話にてご連絡ください。
対象商品
ワーロンシート ・日本の色シリーズ
・抗菌・抗ウイルスタイプワーロンプレート ・ベーシックシリーズ
・エバーライトシリーズ
・工芸和紙シリーズ -
一定の位置でガラスを止めることはできますか
 「上ストッパー(⑤)」を止めたい位置に設置しておけば、その場所でガラスを止めることが可能です。
「上ストッパー(⑤)」を止めたい位置に設置しておけば、その場所でガラスを止めることが可能です。 -
夜でも交換に来てほしいときの手続きを教えてください。
対応可能か確認いたしますので、当社まで一度お問い合わせください。 -
離島まで交換に来てほしいときの手続きを教えてください。
対応可能か確認いたしますので、当社まで一度お問い合わせください。 -
割れたガラスの種類がわからないときの対処法を教えてください。
割れたガラスの種類がわからなくても、一度当社にお電話ください。専門スタッフがガラスについてヒアリングいたします。 -
ガラスサイズの測り方を教えてください。

実際にガラスが見える部分を測ります。
正確なサイズは改めてサービススタッフが採寸いたしますので、厳密なサイズを測る必要はありません。
-
ガラスの厚みを測る方法を教えて。

-
極薄板ガラスの強度について教えてください。
強度試験(2点曲げ試験)の結果です。
D263 50.0×150.0mm 100μm 50μm 30μm No 破壊距離 換算値 破壊距離 換算値 破壊距離 換算値 [mm] [MPa] [mm] [MPa] [mm] [MPa] 1 24 365 11 383 6 439 2 25 351 6 705 6 439 3 25 351 6 705 6 439 4 27 325 6 705 6 439 5 27 325 7 603 6 439 6 28 313 6 705 6 439 7 28 313 6 705 6 439 8 28 313 6 705 6 439 9 28 313 6 705 6 439 10 28 313 6 705 6 439 min 24 313 6 383 6 439 max 28 365 11 705 6 439 ave 27 328 7 662 6 439 ※こちらは「ノンクラックカット」の結果になります。通常切断のデータはございません
-
ハニカム・サーモスクリーンは浴室にも使用できますか?
浴室での使用はおすすめめしておりません。
窓のスクリーンに使用する商品なのでカビ等に強いスクリーンを使ってはいますが、浴室などの直接水がかかるような高温多湿の場所では使用を避けてください。
-
「ハニカム・サーモスクリーン」がどれだけ日射熱を遮れるのか知りたい。
「ハニカム・サーモスクリーン」の日射遮蔽係数※は、以下のような数値になります。
※室内に流入する太陽光線の熱量を表す数値。値が小さいほど日射熱をよく遮ることができる。日射遮蔽係数
採光タイプ標準仕様 0.33 採光タイプ断熱レール仕様 0.15 普通透明ガラス(3ミリ厚) 1 ※(財)建材試験センター試験値
その他の生地・仕様の日射遮蔽係数については、お問い合わせください。
-
ペアガラスや樹脂サッシの窓に「ハニカム・サーモスクリーン」を取り付けたときの断熱効果は?
ペアガラスや樹脂サッシの窓に「ハニカム・サーモスクリーン」を取り付けたときの熱貫流率は、以下のような数値になります。樹脂サッシ+ペアガラスの窓に取り付けることで、1.7倍の断熱効果が期待できます。
断熱効果比較表
樹脂サッシ
Low-Eペアガラス
A12複合サッシ
アルゴンガス入り
Low-Eペアガラス
G16複合サッシ
ペアガラス
A12アルミサッシ
1枚ガラスサッシ 2.33※1 2.33※1 3.49※1 6.51※1 サッシ
+
ハニカム・サーモスクリーン1.45※2 1.45※2 1.83※2 2.42※2 サッシ
+
ハニカム・サーモスクリーン
断熱レール仕様1.37※2 1.37※2 1.71※2 2.20※2 ※1
一般社団法人日本サッシ協会ホームページ内『「建具とガラスの組み合わせ」による開口部の熱貫流率表(住宅用窓の簡易的評価による)』に準ずる値。※2
ハニカム・サーモスクリーン(採光タイプ生地)の熱貫流率[(財)建材試験センター実験参考値]を基に算出した試算値。上の表は「採光タイプ生地」での熱貫流率ですが、「防炎採光タイプ」「遮光タイプ」の生地も同程度の熱貫流率になるものと考えられます。
ペアガラスや樹脂サッシの窓に「ハニカム・サーモスクリーン」を取り付けたときの熱貫流率は、以下のような数値になります。樹脂サッシ+ペアガラスの窓に取り付けることで、1.7倍の断熱効果が期待できます。
断熱効果比較表
スクロールしてご覧いただけます樹脂サッシ
Low-Eペアガラス
A12複合サッシ
アルゴンガス入り
Low-Eペアガラス
G16複合サッシ
ペアガラス
A12アルミサッシ
1枚ガラスサッシ 2.33※1 2.33※1 3.49※1 6.51※1 サッシ
+
ハニカム・サーモスクリーン1.45※2 1.45※2 1.83※2 2.42※2 サッシ
+
ハニカム・サーモスクリーン
断熱レール仕様1.37※2 1.37※2 1.71※2 2.20※2 ※1
一般社団法人日本サッシ協会ホームページ内『「建具とガラスの組み合わせ」による開口部の熱貫流率表(住宅用窓の簡易的評価による)』に準ずる値。※2
ハニカム・サーモスクリーン(採光タイプ生地)の熱貫流率[(財)建材試験センター実験参考値]を基に算出した試算値。上の表は「採光タイプ生地」での熱貫流率ですが、「防炎採光タイプ」「遮光タイプ」の生地も同程度の熱貫流率になるものと考えられます。
-
Centorスクリーンシステムの施工に来てもらうことは可能ですか?
基本的にお客様にて施工をお願いしております。難しい場合はご相談ください。
-
Centorスクリーンシステムは腰高窓にも使えますか?
壁の開口部が動かず、開口部の上部が構造的にたわまない限り、さまざまな素材の開口部に取り付けることが可能です。
また、どのような窓でも網戸下部のBOXが取り付けられれば問題ありません。
-
Centorスクリーンシステムは浴室に使用できますか?
浴室への取付はご遠慮ください。
外付け製品のためある程度の耐水性能はございますが、浴室の密閉空間かつアルカリ性洗剤などの化学物質により変色・サビ・形状変化の可能性があるためおすすめできません。
-
スペーサーの素材と色はなんですか?
スペーサーは、グレーの樹脂素材のものを使用しています。
-
フレームのシルバーの部分をブラックにすることできますか?
塗装であれば、ブラックでご用意可能です。
※納期が1ヶ月~1.5ヶ月ほど掛かりますので、お急ぎの場合はお電話にてご相談ください。 -
コンベックスガラスは自分で切断できますか?
「ガラスカッター」を使って自分で切断することも可能ですが、デコボコが多いので、切断の失敗のリスクが高いです。高価なガラスですので、自分でお切りにならずに、当社でオーダーサイズでご注文されることをオススメします。
-
コンベックスガラスを外装や水周りに使うことはできますか?
コンベックスガラスを直接外装や水周りに使うことはできませんが、シーリング等しっかりしていただければ可能です。
また、外装用として複層ガラス(ペアガラス)にされるお客様もいます。複層ガラス(ペアガラス)にする場合は、外側のガラスを通常のガラス(あるいは熱線吸収ガラス)にして、内側のガラスをコンベックスガラスにしてください。
-
ハンドクラフトグラスのサンプルを見せていただくことは可能ですか?
ハンドクラフトグラスは、当社のサンプル専門の姉妹店「e-sample.jp」で取り扱っておりますので、是非ご覧ください。
-
ハンドクラフトグラスを「強化ガラス」に加工することはできますか?
ハンドクラフトグラスは、強化ガラスに加工可能です。実際にはオーダーサイズの強化ガラスに塗装をします。
-
アンティーク合わせガラスは自分で切断できますか?
アンティーク合わせガラスは、2枚のガラスを使用した「合わせガラス」の一種ですので、ご自身での切断はできません。オーダーサイズでの製作になります。
-
アンティーク合わせガラスに「穴あけ」は可能ですか?
アンティーク合わせガラスは、ご自身で穴を開けることはできません。穴あけが必要な場合は、ご注文の際に穴あけをご指示ください。
-
アンティーク合わせガラスを「強化ガラス」に加工することはできますか?
アンティーク合わせガラスを「強化ガラス」に加工することは可能です。強化ガラスをご希望の場合はお気軽にお問い合わせください。
-
アンティーク合わせガラスのサンプルを見せていただくことは可能ですか?
アンティーク合わせガラスのサンプルは、当社のサンプル専門の姉妹店「e-sample.jp」にて取り扱っております。
-
トレヴィガラスを「強化ガラス」に加工することはできますか?
トレヴィガラスは、強化ガラスに加工することはできません。
-
トレヴィガラスをペアガラスにすることは可能ですか?
可能です。外装に使うときに、複層ガラス(ペアガラス)にするのがオススメです。複層ガラスにする場合は、外側のガラスを通常のガラス(あるいは熱線吸収ガラス)にして、内側のガラスをデザインガラスにするようにしてください。
-
トレヴィガラスに穴あけは可能ですか?
不可能ではありませんが、表面が凸凹しており失敗されるリスクが高いので、穴開けは不可だと思ってください。
-
トレヴィガラスは自分で切断できますか?
「ガラスカッター」を使って自分で切断することも可能ですが、デコボコが多いため、切断の失敗の可能性があります。高価なガラスですので、自分でお切りにならずに、当社でオーダーサイズでご注文されることをオススメします。
-
デザインフィルムガラスのサンプルを見せていただくことは可能ですか?
デザインフィルムガラスは、サンプルのガラスをレンタルでお貸しすることができます。当社のサンプル専門の姉妹店「e-sample.jp」で受け付けております。
-
ガラスの一部のみにフィルムを貼ることはできますか?
可能です。目隠し程度にガラスの一部にフィルムを貼ることは可能です。お気軽にお問い合わせください。
-
デザインフィルムガラスを強化ガラスに加工することはできますか?
デザインフィルムガラスを強化ガラスに加工することは可能です。実際には、オーダーサイズの「強化ガラス」にフィルムを貼ります。
-
デザインフィルムガラスに穴あけは可能ですか?
デザインフィルムガラスに穴を開けることは可能です。穴あけが必要な場合は、ご注文の際に穴あけをご指示ください。
-
切子風ガラスを他の模様にして作れますか?
切子風ガラスと同じカットガラス技術「Vカット加工」を用いて、他の模様(デザイン)でも製作できます。デザインやガラスの大きさによって価格が変わります。無料でお見積もりいたしますので、まずはお気軽にご連絡ください。
-
サイトに掲載されている「切子風ガラス」商品写真のサイズを教えてください

商品画像として掲載している切子風ガラスのサイズは W300 × H300ミリとなります。また、柄の彫り幅は基本的に6ミリ。ガラスの厚みが3ミリの場合のみ3.5ミリになります。
-
クラックガラスのサンプルを見せていただくことはできますか?
クラックガラスは一部欠品中の商品を除き、サンプルガラスをレンタルでお貸しすることができます。ただ、大変人気のガラスですので、サンプルの数が不足する場合がありますのでご了承ください。当社のサンプル専門の姉妹店「e-sample.jp」からお求めください。
-
クラックガラスの打撃点を複数にすることはできますか?
打撃箇所を複数にすることはできません。
クラックガラスは、3枚のガラスで構成される「合わせガラス」の一種です。合わせ加工をした後に、3枚のガラスの真ん中の「強化ガラス」を割ることで製作します。強化ガラスの「全面が一気に割れる性質」を用いており、1箇所割ると、全体にクラック(ヒビ)が入ります。そのため、打撃点を複数箇所から入れることができません。
-
クラックガラスに穴あけは可能ですか?
クラックガラスは、構成される3枚のガラスのうちの真ん中のガラスが「強化ガラス」のためご自身で穴あけすることができません。穴あけが必要な場合は、予めご注文の際に穴あけをご指示ください。
-
クラックガラスは屋外で使えますか?
「屋内用」「屋外用」共にございます。屋外用はガラスを合わせる際の「中間膜(フィルム)」に防水性の高いものを使っております。
-
クラックガラスを自分で切断したいのですが可能ですか?
クラックガラスは製造後にカットすることができませんので、ご希望の寸法でサイズオーダーでのご注文となります。お見積をすぐにお出しできますので、こちらからお気軽にお問い合わせください。
-
クラックガラスの断面はどのような仕上がりですか?

クラックガラスは3枚のガラスを貼り合わせて、真ん中にある「強化ガラス」をクラックさせた製品です。
ガラスの特性上、中間の強化ガラスから細かな破片が落ちることがあります。中間の破片により手が切れる恐れがございますので、四辺に枠をつけて使用いただくことをオススメいたします。
-
パイプの長さは何ミリですか?
1本最大900ミリまで製作可能です。
オーダーカットも可能ですので、お気軽にお問い合わせください。 -
転び止め金具では何ミリ厚のガラスまで設置できますか?
厚み6ミリのガラスまで設置可能です。 -
機械の部品用のガラスを大量に購入できますか?
購入可能です。最大10%OFFの枚数割引が適用されます。過去にも100枚以上のご注文をいただきました。
大量注文いただいたお客様のご注文事例

商品名 フロートガラス サイズ 300 × 200ミリ (厚み 3ミリ) 枚数 100枚 用途 サンドブラスト機の窓の交換 -
MSDS(安全データシート)や品質証明書の用意はできますか?
できます。ご必要でしたらご注文前にお申し付けください。
-
ケイカル・石膏ボードに貼る場合、どれくらいの厚みが推奨ですか?
厚み1.0ミリ以上がおすすめです。 -
商品に表裏はありますか?
ございます。ガラス面が表、塗装面が裏面となります。
塗装面は傷つきやすくなっているため、拭き傷や小キズなどが製造の過程で付いてしまいますが、表面に影響はございません。
-
耐熱ガラスと防火ガラス(耐火ガラス)の違いは?

耐熱ガラスとは耐熱性の高いガラスのことで、防火ガラス(耐火ガラス)は基準の温度に基準の時間、割れずに耐えれるガラスのことです。
-
防火ガラスをペアガラス(複層ガラス)に出来ますか?
-
ステンレスキッチンパネルに磁石はつきますか?
通常、磁石はつきません。
磁石がつくようにしたいという場合は、「SUS430」で製作いたします。
希望の厚みやサイズが分かればお見積もりもご用意可能ですので、お気軽にお問合せください。 -
ワーロンシートの「強化和紙」「抗菌タイプ」「タフトップ」「ハイテック」の違いはなんですか?
商品 ワーロンシート(抗菌・抗ウイルスタイプ) PETホームワーロン
PETホームワーロン タフ・トップ
タフ・トップ ハイテックエース
ハイテックエース
破裂強さ※
(kPa)8161489431238構造  塩化ビニール樹脂
塩化ビニール樹脂
+
和紙
+
塩化ビニール樹脂 和紙
和紙
+
PET樹脂
+
和紙 一般的な障子紙の
一般的な障子紙の
約5倍の強化和紙 一般的な障子紙の
一般的な障子紙の
約3倍の強化和紙防音 ※破裂強さ(kPa)は、生地を突き破るときの抵抗強さを指します。数値が高ければ高いほど破れにくいです。
-
取り付け部材のサイズや素材など、詳細を教えてください。
内窓のタイプによって部材が異なります。詳しくは下記をご確認ください。①【暖窓】シンプル内窓DIYキット

【暖窓】シンプル内窓DIYキットフレーム
厚み:1.1ミリ
長さ:~2,000ミリ
素材:硬質PVC
色:ホワイト・ベージュ
【暖窓】シンプル内窓DIYキットフレーム取っ手付
厚み:1.1ミリ
長さ:~2,000ミリ
素材:硬質PVC
色:ホワイト・ベージュ
【暖窓】シンプル内窓DIYキットフレーム用上レール
厚み:1.5ミリ
長さ:~2,000ミリ
素材:硬質PVC
色:ホワイト・ベージュ
【暖窓】シンプル内窓DIYキットフレーム用下レール
厚み:1.5ミリ
長さ:~2,000ミリ
素材:硬質PVC
色:ホワイト・ベージュ②【暖窓】シンプル内窓DIYキットHI

【暖窓】シンプル内窓DIYキットHI
厚み:1.5ミリ
長さ:~1,840ミリ
素材:硬質PVC+軟質PVC
色:オフホワイト・ビスケット
【暖窓】シンプル内窓DIYキットHI用上レール
厚み:1.5ミリ
長さ:~1,827ミリ
素材:硬質PVC
色:オフホワイト・ビスケット
【暖窓】シンプル内窓DIYキットHI用下レール
厚み:1.5ミリ
長さ:~1,827ミリ
素材:硬質PVC
色:オフホワイト・ビスケット
【暖窓】シンプル内窓DIYキットHI用横カバー
厚み:1.3ミリ
長さ:~1,845ミリ
素材:硬質PVC
色:オフホワイト・ビスケット
L字型パネルフレーム
長さ:~1750
素材:硬質PVC
色:オフホワイト・ビスケット
【暖窓】シンプル内窓DIYキットHI用キャップ(4ヶ入り)
素材:硬質POM
【暖窓】シンプル内窓DIYキットHI用差込取っ手(1袋2個入り)
サイズ:H110×W60×D5ミリ
素材:硬質PVC
色:オフホワイト・ビスケット
【暖窓】シンプル内窓DIYキットHI用補強材
厚み:1ミリ
長さ:~1,840ミリ
素材:6063アルミ アルマイト仕上げ
色:シルバー
パネル1ミリ増厚材
厚み:1ミリ
長さ:~1,820ミリ
素材:硬質PVC③【暖窓】シンプル内窓DIYキットHI(戸車付)

【暖窓】シンプル内窓DIYキットHI
厚み:1.5ミリ
長さ:~2,188ミリ
素材:硬質PVC+軟質PVC
色:オフホワイト・ビスケット
戸車フレーム
厚み:1.5ミリ
長さ:~ 2020ミリ
素材:硬質 PVC+軟質 PVC
色:オフホワイト・ビスケット
【暖窓】シンプル内窓DIYキットHI(戸車付)用上レールHI
厚み:1.5ミリ
長さ:~2,097ミリ
素材:硬質PVC
色:オフホワイト・ビスケット
【暖窓】シンプル内窓DIYキットHI(戸車付)用下レールHI
厚み:1.5ミリ
長さ:~2,097ミリ
素材:硬質PVC
色:オフホワイト・ビスケット
【暖窓】シンプル内窓DIYキットHI(戸車付)用HI横カバー
厚み:1.3ミリ
長さ:~2,200ミリ
素材:硬質PVC
色:オフホワイト・ビスケット
【暖窓】シンプル内窓DIYキットHI(戸車付)用差込取っ手(1袋2個入り)
サイズ:H110×W60×D5ミリ
素材:硬質PVC
色:オフホワイト・ビスケット
【暖窓】シンプル内窓DIYキットHI(戸車付)用補強材HI
厚み:1ミリ
長さ:~2,165ミリ
素材:6063アルミ アルマイト仕上げ
色:シルバー
【暖窓】シンプル内窓DIYキットHI(戸車付)用段差スロープHI
長さ:~2,078ミリ
素材:硬質PVC
戸車用フレーム補強材
厚み:1.2ミリ
長さ:~1920ミリ
素材:6063 アルミ生地
戸車(2ヶ入り)
素材:ナイロン6 -
網入りガラスを曲げること・曲げ加工はできますか?
… -
網入りガラスを「すりガラス」にできますか?
ガラスの片面を「すりガラス」にすることが可能です。すりガラスは水がつく場所には適さないので、「網入り型板ガラス(霞柄くもりガラスタイプ)」がオススメです。
透明な「磨(みがき)」と、視界を遮る「霞(かすみ)」の違いをご覧ください。
… -
網入りガラスに防犯性能はありますか?
「網入りガラス」は、防火目的で作られています。網入りガラスの中のワイヤーは、ガラスを割って引きちぎれますので、あまり防犯効果は期待できません。
防犯性能が期待できるガラスには「防犯ガラス」という商品がございます。また、ガラスの片面を防犯ガラスにした複層ガラスをオーダーメイドするという手段もありますので、カスタマイズのご相談やお見積のご連絡をお待ちしております。
-
網入りガラスで和紙調のものに加工・製作はできますか?
「網入りガラス」の単板に和紙調のフィルムを貼ると「熱割れ」の原因になります。「合わせガラス」の2枚のガラス同士の間に和紙調のものを使うことで、製作可能です。
※ 熱割れ … ガラスの表面に温度差が生まれて生じるひび割れ
-
網入りガラスに「フロスト加工」はできますか?
ガラスの強度が落ちますが、「網入りガラス」への「フロスト加工」は可能です。
-
「網入りガラス」と「防音ガラス」で「合わせガラス」の製作・加工はできますか?
可能です。また、「網入りガラス」と「防音ガラス」以外に、他のガラスの組み合わせでの「合わせガラス」も製作可能です。合わせガラスの組み合わせのカスタマイズは、こちらからお気軽にご相談やお見積のご依頼をください。
-
「網入りガラスは熱割れする」と聞いたのですが、どのような現象ですか?
「網入りガラス」は、ガラスの中にワイヤー(金属製の網)が入っています。1枚のガラスですが、ガラスとワイヤーで「膨張係数」が異なるため、ヒビが入ってしまうことがあります。この現象を「熱割れ」と呼んでいます。
例えば、窓ガラスに網入りガラスを使用していて、冬季にその窓に太陽があたります。すると、ガラス表面の温度が上がります。一方で、窓枠サッシに隠れているガラス部分は、あまり温度が上がりません。ガラスの中央部分、ワイヤー、サッシに隠れたガラスの部分、それそれが膨張係数が違うため、耐久範囲を超えると割れます。
網入りガラスの熱割れを防ぐ方法
ポイントは、網入りガラスに熱をこもらせないこと。以下の様な状況での使用は避けてください。
- 窓ガラスの内側に紙を貼ったり、ペンキなどを塗る
- 網入りガラスにストーブなどの放射熱を直接当てる
- 網入りガラスにカーテン・家具などを密着させる
- 窓ガラスに特殊な陰をおとす
-
色ガラス(色つき)の「網入りガラス」はありますか?
色付きの網入りガラスは無いのですが、「型板ガラス」になっている網入りガラスはあります。
… -
「網入りガラス」に目隠し用フィルムを貼っても良いですか?
「網入りガラス」にはフィルムは貼らないでください。フィルムを貼った部分だけ日射吸収率が高くなり、「熱割れ」でガラスが割れます。
※ 熱割れ … ガラスの表面に温度差が生まれて生じるひび割れ
-
最大サイズより大きな「網入りガラス」を使いたい場合は、どうすれば良いですか?
1枚で実現できない寸法の場合は、複数のガラスに分割すると作れます。ガラスを分割することで、運賃、ガラスの料金などのコストも抑えることができます。
大きなガラスをそのまま商品をお客様の元へお届けする場合は、商品を鉄のパレットにのせて、パレットを大型トラックに積み込みし、天井クレーンやフォークリフトでの荷下ろしが必要になります。一方で、ユニック装備付きの大型トラックでも運搬は可能ですが、いずれにしてもチャーター便となります。
運送コストを減らすために、ガラスを分割して購入される方もいらっしゃいます。
-
Low-E複層ガラスに、防音性能・遮音効果はありますか?
-
Low-E複層ガラスに、防犯性能はありますか?
-
耐熱ガラスを自分で切断することはできますか?
耐熱ガラスは、ガラスカッターという道具を使って、ご自分で切断することが可能ですが、たいへん高価なガラスです。
オーダーメードで購入されることをお勧めいたします。 -
木製サッシに複層ガラス(ペアガラス)を入れることはできますか?

木製サッシにも複層ガラスを使えます。
単板の透明ガラスが2枚と空気層を隔てたオーソドックスなペアガラスから、ガラスが3枚のトリプルガラス、中空層を真空にした真空ガラス(スペーシアなど)ほか、溝幅とガラスの厚みが噛み合うものであれば組み合わせられます。
ガラスとサッシの相性のご相談は、お気軽に1度弊社スタッフにお声がけください。
-
複層ガラスに寿命はありますか?
複層ガラスは基本的には割れるまでずっと使うことができますが、耐用年数がよく10~15年、20~30年と言われます。サイトや店舗によって言われ方にばらつきがありますが、複層ガラスは種類が多数あるためです。ガラスの構成などによって耐用年数が変わります。
当社では、下記の場合に複層ガラスの交換を提唱しております。
- ガラスが曇ってきた
- ガラスが歪んできた
- ガラスにヒビが入った
また、交換時にはそれまでの複層ガラスから機能性を高めて交換されるお客様もいます。今後の住宅の断熱性能、防音性能、防犯性能を高めたいとお考えの方は安易に「前の複層ガラスと同じで」と交換せず、1度当社のスタッフにご相談ください。
-
ペアガラス(複層ガラス)に内部結露は発生しますか?
ペアガラス(複層ガラス)の空気層を密閉しているコーキングの劣化などで、内部結露が起こることがあります。内部結露は、写真のようにガラスとガラスの内側に水滴がついたり、曇ったりしてしまう現状です。


-
複層ガラスの「ペアマーク」とは何ですか?

ペアマークは、複層ガラスの室内側の右下に付いてくるマークです。
ガラスにはさまざまな種類があり、用途によってガラスの性能も変わってきます。その性能を表すマークとなります。
※製造メーカーごとにマークは異なり、AGC製品の場合は写真のようなマークになります。

「エコガラス」というマークがついていることもあります。これは、JISの断熱性能区分にもとづいて、ガラスの省エネ建材等級に区分された証。
等級ごとに「●」の数が設けられており、「●」が多いほど断熱性能に優れているという見方をします。
-
複層ガラス(ペアガラス)でも結露は発生しますか?

複層ガラスも室温、外気温、室内の湿度の条件から結露することがあります。室温、室内湿度ごとに、外気温が何℃のときに結露するかをまとめた表がこちら。
品種 室内湿度 60% 70% 80% 一枚ガラス
(単板ガラス)0℃ 2℃ 5℃ 複層ガラス -9℃ -3℃ 2℃ 品種 室内湿度 60% 70% 80% 一枚ガラス
(単板ガラス)8℃ 12℃ 15℃ 複層ガラス -1℃ -5℃ 11℃ ※一枚ガラス:透明ガラス3ミリ
※複層ガラス:透明ガラス3ミリ + 中空層6ミリ + 透明ガラス3ミリ結露しない条件を作り出す 真空ガラス「スペーシア」

複層ガラスのガラス同士の中空層を真空にすることで断熱性能を高めて、ほぼ結露しないといえる条件を作り出すのが真空ガラス「スペーシア」です。

先ほどと同じように、それぞれの室温、室内湿度別に、結露が起こる外気温をまとめたものがこちら。
品種 室内湿度 60% 70% 80% 一枚ガラス
(単板ガラス)0℃ 2℃ 5℃ 複層ガラス -9℃ -3℃ 2℃ スペーシア -29℃ -16℃ -6℃ スペーシアクール -41℃ -25℃ -12℃ 品種 室内湿度 60% 70% 80% 一枚ガラス
(単板ガラス)8℃ 12℃ 15℃ 複層ガラス -1℃ -5℃ 11℃ スペーシア -23℃ -9℃ 2℃ スペーシアクール -38℃ -20℃ -4℃ ※一枚ガラス:透明ガラス3ミリ
※複層ガラス:透明ガラス3ミリ + 中空層6ミリ + 透明ガラス3ミリ
結露するかは室温、室内湿度、外気温との関係で決まるので、どんな環境でも絶対に結露を防ぐ商品はありませんが、「スペーシア」「スペーシアクール」は、日本の気候から見ると、ほぼ結露が起きないと思ってもらって大丈夫です。
-
Low-E複層ガラスと、そうでない複層ガラスはどのように見分けますか?
ガラスの端に下記のように「Low-E」「エコガラス」といった印字がされています。日本板硝子製の「ペアマルチ」、AGC製の「サンバランス」の例をご紹介しますね。

日本板硝子製の「ペアマルチ」

AGC製の「サンバランス」
-
「やわらぎ無地」と「やわらぎ雲竜」の違いは?
「やわらぎ雲竜」は和紙の繊維を入れた雲のような模様が特徴で、「やわらぎ無地」は繊維が混ざっていない和紙のシンプルなデザインです。

-
テーブル天板に使用する場合、厚みは何ミリがいいですか?
5ミリ以上が安全に使用していただけておすすめです。
-
海外発送はできますか?
海外発送には対応しておりません。あらかじめご了承ください。
-
樹脂ガラスに自分で穴をあける方法を教えてください。
ドリルがあれば、プラスチックと同様に簡単に穴をあけられます。 -
網入りガラス「クロスワイヤ」は、どんなガラスですか?
網入りガラス、線入りガラスは、こちらの比較表をご覧いただくとわかりやすいです。
網入りガラス (磨) ヒシワイヤ クロスワイヤ
クロスワイヤ プロテックス
プロテックス
ワイヤーの間隔 
約20ミリ

約13ミリ

約50ミリ

網入りガラスは防火設備として、建設省告示第1360号などで定められています。防火設備は、火災を想定した加熱に20分間耐えられるものを指します。網入りガラスは割れたときに、ガラスが金網に引っかかるため破片が落ちません。そのため火の侵入や、破片による怪我を防ぐ効果があります。屋根やビルなど、高い場所にある窓に有効です。
-
高窓に設置したいのですが、操作チェーンの長さは変更できますか?
操作チェーンの長さは変更可能です。ご注文時にお問い合わせください。
-
表裏を反対にしてZIProllスクリーンタイプを取り付けることはできますか?
原則として、規定の取り付け方法による施工をお願いしております。規定の取り付け方法以外の施工については、一度ご相談ください。
-
スマートスピーカーなどで電動タイプの昇降はできますか?
電動タイプのリモコンは赤外線タイプではないため、現時点では対応できかねますが、一度ご相談ください。
-
ZIProllスクリーンタイプは日本製ですか?
日本国内(三重県津市)の自社工場で製造し、厳しい出荷検査をクリアした製品のみをご提供しています。
採寸は1mm単位でそのまま製作寸法に反映させ、すべて1台1台動作確認と調整を行っています。
一連の作業は、社内熟練工が手作業で行っています。 -
どのような保証がついていますか?
発送から1年以内は、不具合の調査・修理・交換を無償で行います。1年後からの不具合については、有償にて点検・修理対応を行います。
部品のモデルチェンジなどで互換性がなくなった場合でも、代替案をご提案するなど可能な限りサポートを行います。※ 保証期間内であっても、下記の場合は保証対象外になります
・不当な修理や改造による故障及び不具合
・製品の使用条件環境を超えた使用による故障及び不具合 -
電動タイプについて、ひとつのリモコンで複数のスクリーンを同時に操作することはできますか?
可能です。ご注文時にご相談ください。
-
電動での開閉は可能ですか?
10台以上をお求めの場合には電動の製品も対応できます。別途ご相談ください。
-
ボックスや生地の色は選べますか?
ボックスや生地の色は、白色のみをご用意しています。
-
スクリーンタイプを正面付けで取り付けた場合、ロールの左右から光が漏れ入るような隙間はできますか?
正面付け場合は下地の影響を受けるため、下地がフラットになっていれば光が漏れることはありません。
ガイドレールと壁の間に隙間ができる場合は、パテ・コーキング等で埋めるなどの処理を推奨しています。
-
電動タイプの場合電池切れ・劣化により開閉不可となることはないですか?
電動タイプの場合、【停電・電池切れ】の場合は開閉が不可となります。
-
施工まで依頼できますか?
10台以上ご注文の場合、施工まで対応いたします。
全国対応で施工にうかがいますので、お気軽にご相談ください。 -
取付できない場所などはありますか?
石膏ボードなど下地がない場所や、スクリーンの開閉時にクレセントなどが干渉する場所は、取り付けができません。お取り付け前に下地や奥行きをご確認ください。
-
無反射ガラスは自分でも切れますか?
… -
型板ガラスを自分で切ることはできますか?
… -
型板ガラスを強化ガラスにできますか?
はい、型板ガラスを強化ガラスにすることは可能です。強化ガラスにすることによって、同じ厚さの型板ガラスの5.8倍の耐風圧強度があります。
-
ラコベル ピュアホワイトの厚み、サイズはどれくらいですか?
ラコベル、ピュアホワイトの厚みは5ミリです。サイズは2250ミリ × 3210ミリです。
-
マテラックの厚み、サイズはどれくらいですか?
「マテラック」の厚みは4ミリです。サイズは2250ミリ × 3210ミリです。色は、ピュアホワイトの1色のみです。
-
高透過カラーガラス(内装用)の最大サイズは?
最大サイズは、2438ミリ × 1829ミリになります。
-
高透過カラーガラス(内装用)の厚みの種類は?
厚みの種類は、5ミリの1種類になります。
-
パイレックスは何に使われていますか?
パイレックスは、耐熱ガラスとしての特性を活かし、理科や化学の実験でよく使用されている ビーカーや温度計に利用されています。
-
パイレックスはどこで作られていますか?
1915年、アメリカのコーニング社によって「パイレックス」という耐熱ガラス製品が生まれました。コーニング社は、1879年、トーマス・エジソンの発明した白熱電球のガラス部分の生産していた会社として有名です。
-
すりガラスは、自分で切ることができますか?
… -
昭和レトロガラスの最大サイズ、厚みの種類は?
厚み 製作限界サイズ 発送可能サイズ 昭和レトロ風ガラス 3ミリ 900ミリ × 1800ミリ (12kg) 900ミリ × 1800ミリ (12kg) 昭和レトロ風ガラス 5ミリ 900ミリ × 1800ミリ (20kg) 900ミリ × 1800ミリ (20kg) 昭和レトロガラス レトロン 3ミリ 960ミリ × 1480ミリ (11kg) 960ミリ × 1480ミリ (11kg) ガラスを販売するときは、規格のサイズ(作り置きガラス)から切り出して販売します。 規格サイズの最大サイズ内であればどんな大きさでも可能です。
-
障子用ガラス(ぼかし山水)が割れてしまいました、同じ絵柄で作ってもらえますか?
残念ながら、同じ柄のガラスは制作できません。
ただ、似たようなほかし山水を作ることは可能です。フルオーダーで型紙をつくり、加工をします。コストも高くなりますし納期にも時間がかかります。
通常は、数十種類の中から柄をお選び頂いています。
-
内装専用カラーガラスを強化ガラスに加工することは出来ますか?
内装専用カラーガラスは塗装面を熱すると、色が変わってしまうため、強化ガラスに加工することは出来ません。
-
内装専用カラーガラスに自分で穴を開けることができますか?
内装専用カラーガラスは、ガラスサークルカッターや、ガラスドリルでの穴あけは困難ですが、コアドリルでの穴あけが可能です。
-
カラーガラスのビトロカラーとはどんなガラスですか?
ビトロカラーとは、AGC(株)が製造している内装専用カラーガラスです。
-
内装専用カラーガラスの最大サイズは?
最大サイズは、2438ミリ × 1829ミリとなります。
-
内装専用カラーガラスの厚みの種類は?
厚みの種類は5ミリの1種類になります。
-
内装専用カラーガラスの使用する際の注意事項は?
内装専用カラーガラスの使用上の注意は、下記の通りです。
- 内装専用です、外装には使えません。
- 内装に使用する際でも、直射日光の当たる場所や高温多湿の場所を避けて使って下さい。
- 接着剤にはPOSシールをお勧めします。
-
石英ガラス管の耐熱温度 (使用可能な温度) は?
「石英ガラス板」および「石英ガラス管」の耐熱温度と、「石英ガラス」の耐熱温度に特に違いはありません。
最高使用温度 常温使用温度 石英ガラス管 1000℃ 900℃ 常用使用温度・最高使用温度とは ?最高使用温度は、短時間のみ使用できる温度で、一瞬であれば、この温度まで耐えることが出来ます。また、常用使用温度は、連続して使用することが出来る温度で、この温度までであれば、連続して過熱しても大丈夫だといえる温度です。
-
石英ガラスを自分で切ることはできますか?
… -
バイコールを自分で切ることはできますか?
… -
防犯ガラスを自分で切る事はできますか?
いいえ、もちろんできません。自分で切れたとすると、防犯ガラスとしての機能がうすくなります。
防犯ガラスはガラスとガラスの間に特殊フィルムが密着されています。その為片側から切ったのでは切れませんし、両側から切っても切れません。ガラスの切り方は、簡単に説明すると表面にガラスカッターで傷をつけて、傷にそって割るような感じです。
-
色ガラス(ブラック・グレー)をテレビボードの扉に使用した場合、リモコンの赤外線は通しますか?
色ガラス(ブラック・グレー)は、赤外線を通します。赤外線の通り具合のことで気になる点がありましたら、お問い合わせフォームよりお気軽にご相談ください。 -
セラミックプリントガラスの柄・色の種類は?
日本では、日本板硝子(株)、AGC(株)の2社が製造しています。
それぞれの明細は下記の通りです。
日本板硝子(株)
パターン(柄)
- PLANE
- LINE0202
- LINE0403
- DOT0302-45°
- DOT0304-45°
- DOT0604-45°
- DOT0607-45°
色
- MWミストホワイト
- CWクリスタルホワイト
- SWサテンホワイト
- WHホワイト
- GRグレー
- BRブラック
- MGミストグリーン
- ABアクアブルー
- MBミストブルー
- BLブルー
- YEイエロー
AGC(株)
パターン(柄)
- ドット 0508
- パンチング 0508
- ストライプ 0712
- プレーン(全面ベタ)
色〔標準色〕
- ホワイト
- グレー
- ホワイトミスト
- グレーミスト
- ブラック
色〔特別色〕
- イエロー
- グリーン
- ブルー
- イエローミスト
- グリーンミスト
- ブルーミスト
-
フロストガラスに自分で穴を開けることができますか?
-
フロストガラスの耐熱温度は?
耐熱温度は、110℃となっています。
沸騰したお湯(100℃)をかけても割れないということになります。ただし、110℃以下でも、急激に冷やしたり、冷えたガラスに熱湯をかけるような急激な温度変化では割れてしまいます。
強化ガラスの耐熱温度は210℃ですので、熱湯や高温の油などを使われるキッチン周り等では、強度や安全度、耐熱温度のことを考えると、強化ガラスを使われることをお薦め致します。
常用使用温度・最高使用温度とは ?最高使用温度は、短時間のみ使用できる温度で、一瞬であれば、この温度まで耐えることが出来ます。また、常用使用温度は、連続して使用することが出来る温度で、この温度までであれば、連続して過熱しても大丈夫だといえる温度です。
-
フロストガラスは自分でも切れますか?
…フロストガラスは片面がザラザラ、片面がつるつるしていますので、ツルツルした面をカットしてください。ザラザラ面をカットすると失敗します。
-
低膨張防火ガラスに熱線反射タイプはありますか?
熱線反射タイプのご用意が可能です。素板に熱線反射ガラス、高性能熱線反射ガラスを使うことで熱線反射が可能になります。
低膨張防火ガラスの特性でもある、高い耐熱性と透明で網のないガラスと言うことだけではなく、熱線反射ガラスの特性もあわせもったガラスです。表面に金属膜加工されているため、適度な遮光効果と日射による温度の上昇をコントロールしてくれるほか、明るいまま快適な室内環境をつくる事が可能です。日射温度の上昇をおさえられれば、室内の急な温度の上昇を抑えてくれますね。(冷房のコストを抑えることが可能です。)
熱線反射ガラスを使う場合は、クリア色のみとなります。
高性能の熱線反射ガラスは、日中明るい室外から室内がみえにくいハーフミラー効果があります。
-
ゴリラガラス3の電気特性は?
ゴリラガラス3の電気的性質は下記のようになります。
-
ゴリラガラス3の性質は?
ゴリラガラスの機械的特性、熱的特性、光学的性質はそれぞれ下記のようになります。
-
ゴリラガラス3の透過率はどのくらいですか?
透過率は、光全体に対してガラスを透過する光の割合のことを言います。
下のグラフは、各波長の光を当てた際に、ゴリラガラス3がどれだけ光を透過したのかを表しています。

-
ゴリラガラスは穴を開けることが出来ますか?
ゴリラガラスは自分で穴あけすることはできません。
弊社で穴明け加工をする事は可能ですので、ご希望の場合は0120-12-4466までお気軽にお問合せ下さい。 -
ゴリラガラスは、自分で切ることが出来ますか?
ゴリラガラスをガラスカッターで切断すると切れるというよりも割れるという感じになり、サイズが正確になりません。
切断面は強化ガラスでは無くなりますので、オーダーサイズで注文されることをおすすめします。オーダー品は、切断後に化学強化加工しています。
-
フロートガラスは急激な温度変化に弱いですか?
常用使用温度・最高使用温度とは ?最高使用温度は、短時間のみ使用できる温度で、一瞬であれば、この温度まで耐えることが出来ます。また、常用使用温度は、連続して使用することが出来る温度で、この温度までであれば、連続して過熱しても大丈夫だといえる温度です。
-
フロートガラスはどんな大きさまで作れるのですか?
フロートガラスの最大サイズ
最大サイズは、ガラス工場の機械の大きさによって変わってきます。 また、厚みが2ミリや3ミリなど薄いガラスは割れやすい為、あまり大きなガラスは作れません。
規格サイズの最大寸法は2438ミリ × 3030ミリで、この範囲内であればどんな大きさでも可能です。
大体、ガラスを売るときは、規格のサイズ(作り置きガラス)から切り出して販売します。
※厚みが2ミリと3ミリのガラスは薄い為、2ミリ厚は813ミリ × 914ミリ、3ミリ厚は1219ミリ × 1829ミリと小さめの規格となっています。
特寸(とくすん)と言って、特別なサイズで製作することも可能(工場による)ですので、問い合わせてみてください。
分割することでコストを抑えることが出来ます !ほとんどの方が、ガラスを分割して製作しています。半分ずつ製作して並べて使っています。分割することで、運賃、ガラスの料金などのコストも抑えることが出来ます。
もし大きなガラスを、大きなまま商品をお客様の元へお届けする事となりますと、商品を鉄のパレットにのせて、そのパレットを大型トラックに積み込みし、荷下ろしの際も天井クレーンやフォークリフトでの荷下ろしが必要になります。また、ユニック装備付きの大型トラックでも運搬は可能ですが、いずれにしてもチャーター便となります。 その為、運送コストを減らす為にガラスを分割して購入される方もいらっしゃいます。 -
真空ガラス「スペーシア」は熱割れしますか?
下記のような場合に熱割れを起こすことがあります。ただし、頻繁に起こるものではなく、かなりレアなケースですのでご安心ください。また、熱割れをしない工夫もございますので、こちらをご覧ください。
熱割れの原因
- 冷暖房から吹き出した空気をガラス面に直接当てたり、ガラスに密着するようなロッカーやパーテーションの設置している
- ガラスの表面フィルムや紙などを貼ったり、塗料を塗る
- 室内側ガラスの近くにダンボール箱等、物を置く(一時的な仮置きの場合も同じ)
熱割れしないための工夫
- 二重サッシや内窓に使用する場合、スペーシアの保護キャップは必ず室外側に向けてください。
ただし、スペーシア静、スペーシアクール静はご使用になれません。

万一熱割れした場合
-
お問い合わせください。
電話での注文やお見積もり・ご相談は0120-12-4466までお気軽にお電話ください。
-
開口サイズの測り方を教えてください
 図のように窓枠の内側(木枠内側)からの高さ(H)・幅(W)を測ってください。
図のように窓枠の内側(木枠内側)からの高さ(H)・幅(W)を測ってください。 -
ガラスサイズの測り方を教えてください

サッシのW(横)とH(縦)のパッキンの内側(サッシの面)までを測ってください。
-
窓の開き方の種類を教えてください

引き違い窓 (2枚建て)
日本の窓で一番多く採用されている2枚の横引き窓です。
引き違い窓 (4枚建て)
窓が4枚の横引き窓です。
開き窓
縦方向を回転軸に、室内側へ開く窓です。
FIX窓
開閉ができない窓です。はめ殺し窓とも呼ばれます。その他の特殊な開き方の窓も施工可能な場合があります。下記フォームからお写真をお送りください。 -
補助金の申請は誰が行いますか?
補助金の申請は、当社が行いますので、お客様が手続きを行う必要は一切ありません。お気軽にお問合せください。
-
内窓とカバー工法では、どれくらい価格が違いますか?
概算ですが、カバー工法は内窓よりも2〜3倍費用がかかります。窓の性能により価格差も異なります。内窓とカバー工法で迷っている方は、それぞれのお見積りを出すことも可能ですので、お気軽にお見積りください。
-
先進的窓リノベ事業とこどもエコすまい支援事業は、店舗兼住宅も対象ですか?
「住宅」の部分のみ対象となります。店舗・オフィスは対象外です。
-
先進的窓リノベ2026事業の補助金は、どのような流れで還元されるのでしょうか?
当店では、リフォームの合計金額から補助金額を予め引いた金額をお客様に請求します。お支払後、補助金の振り込みを待たなくても良いため、安心してお支払いいただけます。
-
工事の後に補助金が通らない(却下)の場合はありますか?
工事の後に補助金が却下されることはありません。補助金申請の要件を満たしているか、当店が事前に確認していますので、安心してご依頼ください。
ただし、予算上限に達した場合は期間内でも受付が締め切られ、補助金が交付されない場合があります。 -
現地調査は、有料でしょうか?
現地調査費用は、通常5,000円です。当店限定で、通常価格5,000が無料になるキャンペーンを開催しています。先着100名様限定ですのでお早めにご連絡ください。お見積りも無料で行っていますので、お電話・フォームからお気軽にお問合せください。
-
親子2世帯で、一つの敷地内に家が2軒あります。今回の補助金制度では、一回目に私達(子)の家のリフォームを先に行い、次回は親世帯の家のリフォームを依頼するのは可能でしょうか?
別々のタイミングで申し込まれた場合でも、補助金は合計200万円までご利用いただけます。そのほか、「こんな場合は補助対象になるの?」といった不安・ご質問がございましたら、当店にお気軽にお問合せください。専門スタッフが最短1分で回答いたします。
-
乳白合わせの透過率を教えてください。

光の透過率は下記になります。
可視光線透過率は0〜100%の数値で表されており、0%に近いほど光を通しにくくなります。乳白合わせは50%以上の透過率のため、採光性を保ちながら視界を遮ってくれます。
ガラスの厚み 可視光線透過率 FL3+FL3 61.50% FL4+FL4 58.60% FL5+FL5 55.20% 
光の透過率は下記になります。
可視光線透過率は0〜100%の数値で表されており、0%に近いほど光を通しにくくなります。乳白合わせは50%以上の透過率のため、採光性を保ちながら視界を遮ってくれます。
ガラスの厚み 可視光線透過率 FL3+FL3 61.50% FL4+FL4 58.60% FL5+FL5 55.20% -
カバー工法の後悔やデメリットはありますか?
カバー工法のデメリットとして、元々の窓枠に新しい枠を被せるため、開口がやや小さくなることが挙げられます。
開口の大きさは変えずに窓リフォームを希望される方には、「ガラス交換」や「内窓の設置」をご提案しています。カバー工法のデメリットに少しでも不安がある方は、お気軽にご相談ください。
-
フロートガラス(透明ガラス)を床用ガラスに使用することはできますか?
床用ガラスとして使用可能です。当店で強度計算を行いますので、ご希望のサイズをお伝えください。 -
デザインペアガラス「デザートペア」は自分で切断できますか?
ペアガラスはご自身で切断できません
サイズオーダーでのご注文ができますので、お見積りフォームもしくお電話で、ご希望のサイズをお伝えください。
- お見積りフォーム
- お電話:0120-12-4466
-
夜景専用ガラス TEIEN(庭園)は「キリの良いサイズ」で注文したほうが 価格は安くなりますか?
極端に高くなることはありませんのでご安心ください。
501ミリなどキリの悪いサイズで注文すると価格が極端に高くなるとご心配の方が多くいらっしゃいますが、当社は面積により価格を決定しているので、500ミリが501ミリになったとしても極端に高くなることはありませんのでご安心ください。
ご希望のサイズでご注文されることをオススメいたします。
-
夜景専用ガラス TEIEN(庭園)は「確認用の図面」を作っていただけますか?
注文前の確認用の作図サービスも行っております。
複雑な形状や、穴あけ、コーナー加工など、注文する前に出来るガラスを確認したいと思います。当社では、注文前の確認用の作図サービスも行っておりますので、安心してガラスをご注文いただけます。作図をご希望の方はお気軽にお問い合わせください。
-
ガラスが「スペーシア」仕様の内窓はありますか?
スペーシア仕様の内窓のご注文も可能です。スペーシアにはいくつか種類があり、当社では「スペーシア」もしくは「スペーシアクール」をご提案することが多いです。
スペーシアとスペーシアクールの違い
「スペーシアクール」はスペーシアの遮熱性能をさらに高めた遮熱高断熱ガラスです。

-
規格品のステンドグラスのカットは可能ですか?

完成している規格品のステンドグラスの柄のデザインをそのままに、別途カット料金をいただき、カットできます。「半分に切断してほしい」といったご依頼をいただいております。
デザイン柄の描線の入り方でカットできない場合があるので、まずは1度ご相談ください。
① ステンドグラスをカットできる場合
描線とカット位置が沿っていない場合にカットできます。例えば、横にカットする際に縦に描線が入っている場合です。
描線や塗装部分を削るので、断面が隠れるドアなどの建具に入れてのご使用がオススメです。

② ステンドグラスをカットできない場合
描線に沿った切断はできません。当社では、カット位置をずらすか、「部分取り」などのオーダーサイズでのご注文を提案しております。

ステンドグラスの「部分取り」とは

ステンドグラスを、ご希望のサイズ・位置で柄の切り出しを行う加工です。
サイズや位置を教えていただければ、ご希望のデザインでデータを制作いたします。料金はガラスのサイズ、柄によって異なりますので、お気軽にご連絡ください。
-
内窓の枠の色はどんなものが選べますか?
当店では「インプラス (LIXIL製)」「プラマードU (YKK AP製)」「プラメイクEⅡ (三協アルミ製)」の内窓を取り扱っております。 それぞれの内窓製品のカラーバリエーションが一目でわかる比較表がございます。
それぞれの内窓製品のカラーバリエーションが一目でわかる比較表がございます。


-
他社製の内窓(二重窓)の製品と防音効果の違いはありますか?
「インプラス」とよく比較されるのが「プラマードU」です。両製品とも防音性能には違いはありません。
製品 遮音性能 インプラス
(LIXIL)T-4等級 ※ プラマードU
(YKK AP)T-4等級 ※ ※ ここでの「T-4等級」は、内窓単体ではなく既存の窓と内窓での性能です。
「T-4等級」というのは、サッシに対して「JIS(日本工業規格)」項目で性能等級が定義されている遮音性能を表すもので、最高ランクになります。
等級 遮音性能 ※ なし 15dB
程度T-1 25dB
程度T-2 30dB
程度T-3 35dB
程度T-4 40dB
程度 -
デザインペアガラス「デザートペア」のサンプルはありますか?
デザインペアガラス「デザートペア」シリーズは、姉妹店の「e-sample.jp」でA4サイズのサンプルガラスをレンタルでお貸ししております。大変人気のガラスですので、サンプルの数が不足する場合がありますのでご了承ください。
-
親子2世帯で、一つの敷地内に家が2軒あります。今回の補助金制度では、一回目に私達(子)の家のリフォームを先に行い、次回は親世帯の家のリフォームを依頼するのは可能でしょうか?
別々のタイミングで申し込まれた場合でも、補助金は合計200万円までご利用いただけます。そのほか、「こんな場合は補助対象になるの?」といった不安・ご質問がございましたら、当店にお気軽にお問合せください。専門スタッフが最短1分で回答いたします。
-
現地調査は、有料でしょうか?
現地調査費用は、通常5,000円です。当店限定で、通常価格5,000が無料になるキャンペーンを開催しています。先着100名様限定ですのでお早めにご連絡ください。お見積りも無料で行っていますので、お電話・フォームからお気軽にお問合せください。
-
工事の後に補助金が通らない(却下)の場合はありますか?
工事の後に補助金が却下されることはありません。補助金申請の要件を満たしているか、当店が事前に確認していますので、安心してご依頼ください。
ただし、予算上限に達した場合は期間内でも受付が締め切られ、補助金が交付されない場合があります。 -
先進的窓リノベ2025事業と子育てグリーン住宅支援事業は、店舗兼住宅も対象ですか?
「住宅」の部分のみ対象となります。店舗・オフィスは対象外です。
-
「内窓」と「カバー工法」では、どれくらい価格が違いますか?
概算ですが、カバー工法は内窓よりも2〜3倍費用がかかります。窓の性能により価格差も異なります。内窓とカバー工法で迷っている方は、それぞれのお見積りを出すことも可能ですので、お気軽にお見積りください。
-
窓ガラス交換のみで、既存サッシがアルミサッシでも使える補助金はありますか?
「みらいエコ住宅2026事業」をご利用いただけます。当店では、お客様がご利用いただける補助金を無料で診断いたします。お電話またはフォームからご依頼ください。
-
ガラス交換のみでも「先進的窓リノベ2026事業」の補助金は使えますか?
当店に材料+工事まで依頼いただければ、ガラス交換のみでも「先進的窓リノベ2026事業」の補助金を利用いただけます。その場合、既存サッシが樹脂サッシで、ガラスをスペーシアに交換するケースのみ、「先進的窓リノベ2026事業」の補助金の利用が可能です。
既存サッシがアルミサッシの場合は「みらいエコ住宅2026事業」をご利用いただけます。お客様がどちらの補助金に適用しているのか、無料で診断いたしますので、お電話またはフォームからご依頼くださ
-
窓の開き方の種類を教えてください

引き違い窓 (2枚建て)
日本の窓で一番多く採用されている2枚の横引き窓です。
引き違い窓 (4枚建て)
窓が4枚の横引き窓です。
開き窓
縦方向を回転軸に、室内側へ開く窓です。
FIX窓
開閉ができない窓です。はめ殺し窓とも呼ばれます。その他の特殊な開き方の窓も施工可能な場合があります。下記フォームからお写真をお送りください。 -
ガラスサイズの測り方を教えてください

サッシのW(横)とH(縦)のパッキンの内側(サッシの面)までを測ってください。
-
開口サイズの測り方を教えてください
 図のように窓枠の内側(木枠内側)からの高さ(H)・幅(W)を測ってください。
図のように窓枠の内側(木枠内側)からの高さ(H)・幅(W)を測ってください。 -
内窓の「窓枠の奥行き」はどこを測れば良いですか?

既存サッシの室内側に一番出ている部分から窓枠の先端までを測ってください。
-
既存窓が網入りガラスの場合、内窓を設置すると「熱割れ」する可能性があると聞いたのですが、設置しても問題ないですか?
既存の窓が網入りガラスの場合、ガラスに太陽光があたり、その熱でごく稀に割れることがあります。現地調査の際に、「熱割れ」の危険性が高い窓かどうかもあわせて確認いたしますので、まずはお電話・フォームからお気軽にご相談ください。
-
内窓「インプラス」に欠点やデメリットはありますか?
インプラスには、以下の4つのデメリットがあると言われています。
インプラスでよく言われる4つのデメリット①窓の開け閉めが2回必要になる 既存の窓の内側に新たに窓を設置するため、換気や出入りをする際、2枚の窓を開け閉めする必要があります。 ②サッシの掃除が2枚分必要になる レールや窓ガラスを2枚分掃除をする必要があります。 ③部屋が少し狭くなる 窓が内側に付いた分だけ、部屋が狭くなります。 ④取付に数万円の費用がかかる 大きな掃き出し窓に内窓を設置する場合、約55,000円(税込)の商品価格になります。 インプラスのメリット①断熱効果 内窓を付けることで今までの窓との間に空気層ができ、熱の移動を抑え窓の断熱性を上げます。 ②防音効果 今までの窓との間に空気層ができ、音の伝わりをカットし窓の防音性を上げる。防音ガラスと同等の効果があります。 ③結露防止 結露の原因とされる熱の移動を防ぎ、結露を防止します。 ④省エネ 断熱性が上がることにより、空調効率(冷暖房の効き)が良くなります。インプラスを設置しない窓と比較すると、電気代が1ヶ月1,000円以上、10年間で約20万円もおトクになります。 メリットが大きいから、「取り付けて良かった」と感じる方が多い

インプラスにはこのような4つのデメリットがありますが、実際に内窓を取り付けた方は、「取り付けて良かった」と感じている方が多くいらっしゃいます。
開け閉めや掃除などのデメリット以上に、断熱効果・防音・結露防止などのメリットを実感されています。

また、インプラスには「ダストバリア機能」が付いており、サッシ汚れの根本的な原因となる“ホコリ”を寄せ付けません。
この機能によって、「②サッシの掃除が2枚分必要になる」という負担が軽減されています。
インプラスは補助金で安く取り付けられる可能性が高い
インプラスはさまざまなリフォーム補助金の対象になっている内窓です。そのため、取り付け費用が不安でも、通常よりもお安く取り付けられる可能性が高いです。
-
インプラスの価格はどのくらいですか?
窓のサイズや、組み込むガラスによって価格が変わります。
インプラスの価格/一般的な窓サイズの場合

住宅で使用されている窓のサイズは、主に掃き出し窓などの「大窓サイズ」、腰高窓などの「中窓サイズ」、トイレの小窓などの「小窓サイズ」があります。
各窓サイズのとき、インプラスの価格は以下のようになります。
参考価格/引違い窓(2枚建て)・単板ガラス使用の場合
大窓サイズ
(横1700×縦1800ミリ)中窓サイズ
(横1700×縦1200ミリ)小窓サイズ
(横900×縦700ミリ)価格 商品価格
52,780円
52,780円商品価格
30,160円
30,160円商品価格
22,040円
22,040円
取り付け工事費も含めた価格は、都道府県によって変わります。
取り付け工事費も含めた価格をお伝えできますので、ご希望の方は無料お見積フォームからお見積りください。
備考欄に「施工希望」と記載いただけますと、スムーズに依頼できます。

インプラスの価格/組み込むガラスを変えた場合の参考価格
当店では、インプラスに組み込むガラスを280種類以上から選ぶことができ、お客様のご要望や目的に合わせたガラスをご提案しています。
インプラスに組み込むガラスによっても、購入価格が変わります。
断熱性能・結露防止効果をより高めたい方にオススメ 夏の日差しの熱を室内に入れたくない方にオススメ 

複層ガラス Low-E複層ガラス 現在の住宅では当たり前に使われている、最も一般的な断熱ガラス Low-E膜をガラスにコーティングすることで、断熱効果に遮熱効果が加わったガラス 防音効果をより高めたい方にオススメ 和室用に障子風の内窓を付けたい方にオススメ 

防音合わせガラス 和紙調ガラス/組子付き 2枚のガラスの間に特殊フィルムを挟みこんだ、防音専用のガラス ガラスに和紙調シートを貼りつけた、障子紙と格子風のガラス。 参考価格/引違い窓(2枚建て)の場合
大窓サイズ
(横1700×縦1800ミリ)中窓サイズ
(横1700×縦1200ミリ)小窓サイズ
(横900×縦700ミリ)単板ガラス
(透明ガラス3ミリ)商品価格
52,780円
52,780円商品価格
30,160円
30,160円商品価格
22,040円
22,040円複層ガラス
(FL3+A12+FL3)商品価格
77,140円
77,140円商品価格
44,660円
44,660円商品価格
29,000円
29,000円Low-E複層ガラス
(Low-E3+A12+FL3)商品価格
95,700円
95,700円商品価格
56,840円
56,840円商品価格
30,161円
30,161円防音ガラス
(FL3+防音フィルム+FL3)商品価格
89,536円
89,537円商品価格
60,213円
60,213円商品価格
29,335円
29,336円和紙調ガラス/組子付き
(和紙調ガラス3ミリ)商品価格
97,440円
97,440円商品価格
50,460円
50,460円商品価格
31,900円
31,900円※取り付け工事費も含めた価格は、都道府県によって変わります。

こちらで紹介した商品はあくまで一例です。他にも、目隠し効果のあるガラスを使ったり、ガラスの厚みを調整したりなど、お客様の細かなご要望に合わせたガラスをご用意できます。
当店スタッフがお客様にピッタリのガラスをご提案しますので、ぜひ一度お電話でご相談ください。
-
取付ビスの必要本数の目安は?
ビスは5山おきにとめるため、定寸1枚あたり(幅方向に4ヶ所)×(母屋の数)を目安にしてください。
※軒先部は3~4山おきにとめてください(定寸1枚あたり幅方向に5~7ヶ所)
※縦ピッチは「400~600㎜ピッチ」が推奨となりますが、母屋にあわせてとめてください。※定寸:655×3030㎜
-
波板ポリカの取り付け位置はどのように決めますか?
軒先の出幅
軒先の出幅は100㎜以下
強風地域は50㎜以下にしてください。母屋(受材)間隔
母屋(受材)の間隔は、一般地域は600㎜以下
強風多雪地域は500㎜以下にしてください。
-
ペアガラスの中で内部結露しにくいものはありますか?
内部結露する原因は「ガラス周囲の劣化」の場合と「室内外の温度差が大きい」場合があります。原因によって、内部結露しにくいペアガラスが変わります。
「ガラス周囲の劣化」が原因の場合は、空気層の中に湿った空気が入り込んでしまうため、どんなペアガラスでも内部結露します。
「室内外の温度差」が原因の場合は、ペアガラスの空気層が外気で冷やされて、空気層内の水分が水滴になることで発生します。この場合、空気層が真空やアルゴンガスのペアガラスは、内部結露がしにくくなります。
「室内外の温度差」が原因の場合、空気層に使われている空気の種類(主に、真空・アルゴンガス・乾燥空気の3種類)によって、発生しやすさが異なります。
ペアガラスの空気層 内部結露のしやすさ 真空 空気層内に水分がないため、内部結露は発生しません アルゴンガス 気体から液体になる温度は-180度ほどで大変低いため、内部結露はしにくくなります 乾燥空気 空気内に微量の水分を含んでいるため、室外と室内の温度が大きく違いがある場合、内部結露が発生する可能性があります -
ペアガラスが内部結露しています。DIYで修理することは可能ですか?
内部結露したペアガラスは、DIYで修理できます。
窓ガラスの交換方法を動画で解説していますので、自分でペアガラスを交換される方はこちらをご覧ください。
細かいステップごとに写真付きの解説もありますので、より詳しく見たい方は解説ページをご覧ください。
-
サンゴバンはどんなガラスをつくっていますか?
サンゴバンでは、建築用ガラス、自動車ガラス、ディスプレイ用ガラスなどを主に製造しています。
一般建築用として、フロートガラスや豊富なデザインのヨーロッパモダン型ガラス、防犯ガラスなどあります。
また、プロジェクト向け加工ガラスとして複層ガラスやセラミック印刷ガラス、防弾ガラスなどを製造しています。
-
日本電気硝子はどんなガラスをつくっていますか?
日本電気硝子では、ディスプレイ用のガラスを主として、建築用のガラスなども製造しています。
特に、液晶用ガラス基板では世界の生産量の20%を供給しています。
また、耐熱ガラスの製造においては、日本電気硝子では結晶化ガラスの技術を活用し、耐熱衝撃性や機械的強度、電気的特性などに優れたガラス製品を開発、提供しています。その中でもネオセラムという超耐熱結晶化ガラスは優れた特性を生かし、厨房機器や暖房器具、電子部品、工業用資材にまで幅広く使われています。
-
セントラル硝子はどんなガラスをつくっていますか?
セントラル硝子では、ガラスだけでなく化学品にも力を入れて製造しています。
建築・住宅用のガラスとしては、省エネ、防犯に対応したガラスを作っています。
また、自動車用ガラスとしては、安全性や環境性などに対応したガラスを提供しています。
-
日本板硝子はどんなガラスをつくっていますか?
日本板硝子では、建材用ガラス、自動車用ガラス、ガラス繊維、ディスプレイ用ガラス、他にも顔料などにも使用できるマイクログラスなどさまざまな分野で製造しています。
結露防止、省エネ、断熱、安全、防犯性など、日常生活になくてはならないガラスに注目した製品を製造しています。
また、日本板硝子は「ウム」という、瞬間的に色が変わるという特色のある瞬間調光ガラスを扱っています。
-
AGCはどんなガラスをつくっていますか?
AGCでは、建材用ガラス、自動車の窓ガラス、ディスプレイパネル用ガラスなど幅広く製造しています。
建材用ガラスでは、住宅の窓ガラスからドームのガラスまであらゆる場所で使用されています。
住宅用としては、結露の発生を防ぐものや、省エネ、防犯、インテリアとしても美しいデザインガラスなど生活のニーズに合わせたものがあります。
また、高層ビルや大規模な建物に使用される強化ガラス、倍強度ガラス、網入りガラス、複層ガラスなどを製造しています。
-
泡の入った、ハンドクラフトグラスはありますか?
はい、あります。
ハンドクラフトグラスには、バブルと言う種類があり、ガラスの表面に泡が加工されています。色もクリア、グレー、セピアと3色あります。右の写真は、セピアになります。
レトロなイメージにピッタリのガラスです。このガラスは、1枚1枚てづくりされていて、工芸品のように見えますよ。
ガラスの表面には、特殊樹脂加工されていてほどよい透明感があります。フロスト加工などにはない、透明感がまたおしゃれです。
ちなみにハンドクラフトグラスはバブルの他に、ストライプ、チップがあります。色は、クリア、グレー、セピアの3色あります。
-
ハンドクラフトグラスは、外装に使えますか?
使用可能です。特殊樹脂の加工されている面を室内側にしてご使用ください。
メンテナンスの際は、傷に注意して「柔らかい布」「スポンジ」を使い、スポンジの硬い面で強く擦ったりしないでください。また、洗剤は「中性洗剤」を使ってください。
-
ハンドクラフトグラスは、自分でも切れますか?
はい、ガラスカッターというものを使って簡単に切れます。
厚み10ミリぐらいまでなら簡単に自分でも切断できますので、DIY、日曜大工、 自分で窓ガラスの取替えなどを行う方には扱いやすいガラスと言えます。ガラスの切り方を動画で紹介 !
女性でも簡単に、切ることができます。ステンドグラスなどは、こうしてガラスを切って作られています。ただ、厚みが厚くなるほど切りにくくなります。
ガラスを切った後の切断面で手を切らないように十分ご注意下さい。 ガラスの切り方はとても簡単で、ガラスを切るのを一度見れば、結構すんなりと切れるようになります。
皆さん切り方を知らないだけで、本当に簡単なんです。 ガラスの切り方を動画で紹介するサイトを作りましたので、一度ご覧ください。ガラスの切り方の動画はこちら > ガラスのホームセンター「ギヤマン」
-
コンベックスガラスのサンプルを見せていただくことは可能ですか?
コンベックスガラスは、当社のサンプル専門の姉妹店「e-sample.jp」で取り扱っておりますので、是非ご覧ください。
-
和紙調合わせガラスを曲げること(曲げ加工)はできますか?
できません。
「和紙調合わせガラス」は、和紙調の特殊フィルムがガラスの表面に貼ってあります。ガラスを曲げるためには、加熱処理が必要になりますので、フィルムが貼ってあるとフィルムが溶けてしまい、曲げる加工はできません。
-
和紙調合わせガラスに、穴を開けることは出来ますか?
-
サンユーログレーとは

サンユーログレーは、旭硝子が販売する熱線吸収ガラスです。ガラスの原料に金属を加えることで、グレーに着色された製品。
日射を吸収する性能を高めたことで、夏の冷房負荷を減らします。また、カラーガラスとしてデザイン目的で使うこともできます。
規格・性能
品種 呼び厚さ
(ミリ)可視光(%) 日射(%) 紫外線
透過率(%)最大寸法
(ミリ)反射率 透過率 反射率 透過率 吸収率 サンユーログレー 5 5.7 49.8 5.6 51.6 42.8 23.6 3600 × 2400 6 5.4 43.9 5.4 45.8 48.8 19.4 8 5.1 33.8 5.0 36.1 58.9 13.2 3590 × 2380 規格・性能 (ペアガラスの場合)
サンユーログレーは、複層ガラス(ペアガラス)にすることも可能。遮熱性能に加えて、断熱性も獲得しました。
品種(商品名) 呼び厚さ (ミリ) 可視光(%) 日射(%) 紫外線透過率(%) 反射率 透過率 反射率 透過率 吸収率 GEFL6 + A6 + FL6 18 7.0 39.4 6.9 37.7 55.3 16.1 GEFL6 + A12 + FL6 24 GEFL6 + A6 + FL8 22 6.0 30.2 6.0 28.8 65.2 10.9 GEFL6 + A12 + FL8 28 ※GEFLはサンユーログレーの略称、Aは中空層、FLはフロートガラスです。
どんな風に見える?

写真右半分がサンユーログレー。ほのかな暗さで落ち着いた雰囲気になります。
熱線吸収ガラス (色ガラス) のバリエーション
 熱線吸収ガラスは原料に金属を加えますが、金属の種類によって色が変わります。遮熱だけではなく、デザインガラスとしても人気です。
熱線吸収ガラスは原料に金属を加えますが、金属の種類によって色が変わります。遮熱だけではなく、デザインガラスとしても人気です。 -
熱線吸収ガラスを曲げること(曲げ加工)はできますか?
はい、曲げガラスにできます。
曲げ加工とは

曲げ加工とは、金属製の型の上にのせた板ガラスを電気やガスを使用した加熱炉の中に入れ、ガラスの軟化温度付近(580~600℃)まで、徐々に加熱する加工。
軟化した板ガラスは、ガラス自身の重みにより金属製の型に沿って曲がります。曲がり終えたガラスは、加熱を止め炉内において熱をさまします。その時同時に熱加工によりガラスに発生した歪み・反りを取り除いてくれます。
-
熱線吸収ガラスの最大サイズは?
熱線吸収ガラスの最大サイズは、下記の表の通りです。
呼び厚さ(ミリ) 最大寸法(ミリ) 5 3600 × 2400 6 3600 × 2400 8 3590 × 2380 分割することでコストを抑えることが出来ます !
ほとんどの方が、ガラスを分割して製作しています。半分ずつ製作して並べて使っています。分割することで、運賃、ガラスの料金などのコストも抑えることが出来ます。
もし大きなガラスを、大きなまま商品をお客様の元へお届けする事となりますと、商品を鉄のパレットにのせて、そのパレットを大型トラックに積み込みし、荷下ろしの際も天井クレーンやフォークリフトでの荷下ろしが必要になります。また、ユニック装備付きの大型トラックでも運搬は可能ですが、いずれにしてもチャーター便となります。 その為、運送コストを減らす為にガラスを分割して購入される方もいらっしゃいます。 -
熱線吸収ガラスの厚みの種類は?
各色厚みは、5ミリ、6ミリ、8ミリの3種類になります。 -
開口部に熱線吸収ガラスを使うと、省エネ効果があるの?
はい、省エネルギー効果があります。
熱線吸収ガラスは、日射熱取得率が透明な板ガラス(フロートガラス)に比べて小さい為、熱負荷を軽くして省エネに貢献しています。冷房の負担を減らしてくれます。
日射を30~40%程度吸収してくれています。窓からの直射日光を適度に和らげてくれて、気持ちのよい空間を作ってくれます。
-
熱線吸収ガラスを使用する際の注意点は?
熱線吸収ガラスの使用上の注意は下記の通りです。
- 厚みが厚くなるほど色が濃くなり、熱線吸収率も高くなります。その為、普通のガラスよりも熱割れの原因になります。
- 冷暖房の吹き出し口から出てくる空気をガラス面に直接当てたり、ガラスに密着した厚手のカーテンを吊ったり、家具などを置くと熱割れの原因になります。
- ガラス面にペンキを塗ったり、紙を貼ったりしますと熱割れの原因になります。
-
サンカットΣとは

サンカットΣ(シグマ)は、AGCから販売されている熱線反射ガラスです。ガラス表面に特殊な金属膜をコーティングすることで、太陽光を反射する性能を高めた製品。
主にガラス面の多いオフィスビルなどで採用されています。
規格
品種(商品名) 呼び厚さ(ミリ) サンカットΣ クリア 6、8、10、12、15、19、6.8W、10W サンカットΣ ユーログレー 6、8 サンカットΣ ユーロブロンズ 6、8 サンカットΣ グリーン 6、8 ※Wは「ヒシワイヤ」を使っていることを示します。
最大サイズと最小サイズ
品種(商品名) 呼び厚さ(ミリ) 最大寸法(ミリ) 最小寸法(ミリ) サンカットΣクリア 6 3600 × 2500 70 × 100 8 3580 × 2460 100 × 100 10 3540 × 2420 100 × 100 12 3540 × 2420 150 × 150 15 3450 × 2300 19 PHW6、8 3000 × 1940 PHW10 サンカットΣユーログレー
サンカットΣユーロブロンズ
サンカットΣグリーン6 3600 × 2082 70 × 100 8 3580 × 2082 100 × 100 バリエーション

-
サンルックスとは
「サンルックス」はAGCから販売されている熱線反射ガラス製品です。板ガラスの表面に金属の膜をコーティングし、太陽光を遮る効果があります。
また、金属膜が光を反射して昼間の室内が見えにくい(ハーフミラー効果)ので、プライバシーを守ることもできます。
さらに、夏場の冷房費用を抑えたい場合に効果的。金属膜の種類によって、色や性能が異なります。
規格
品種(商品名) JIS種類区分 反射色調(OUT) 呼び厚さ(ミリ) 日射熱遮蔽性区分 耐久性区分 サンルックスSSB 3 B シルバー系 6 、 8 サンルックスTS30 2 B ブルー系 サンルックスSGY32 2 B シルバーグレー系 サンルックスTSL30 3 B シルバーライトブルー系 最大サイズと最小サイズ
品種(商品名) 呼び厚さ(ミリ) 最大寸法(ミリ) 最小寸法(ミリ) サンルックス 6 3600 × 2500 70 × 100 8 3580 × 2460 100 × 100 サンルックスの遮熱性能比較

上の図は、単板ガラス (左上) と複層ガラス (右上)、それにサンルックスペア (左下) を比較したもの。それぞれの遮熱性能を比べています。
注目すべきは、各イラストの右側に書かれている「日射熱取得率」という値。これは、日差しがガラス面を通して、室内に放出される割合を示したものです。値が小さいほど、ガラス面で多くの日射を反射・吸収している、つまり遮熱性能が高いことを意味します。遮熱性能が高いほど、夏の日差しを和らげる効果が高いということです。
日射熱取得率の数値を見ると、透明複層ガラスは75.2%。サンルックスペアは37.8%。サンルックスを使った複層ガラスは、日射しを防ぐ効果が2倍高いことが分かります。
日射熱取得率と可視光透過率
種類 日射熱取得率
η値可視光透過率
(%)複層透明ガラス(ペアガラス)
6ミリ + 12ミリ(乾燥中空層) + 6ミリ0.75 80.5 高遮熱性能熱線反射ガラス
サンルックス(TSL30) 8ミリ0.40 30.9 -
熱線反射ガラスは、強化加工できますか?
はい、熱処理を施し強化ガラスにすることが可能です。
熱線反射ガラスの表面には、金属膜がコーティングされていますがなんと強化加工の熱に耐えることができます。その為、強化加工可能です。
-
熱線反射ガラスとは
熱線反射ガラスは、ガラスの表面に極薄い金属膜をコーティングしたガラスです。
下記の様な特性を持っています。
- 金属膜が日射光遮り、透過し窓際の温度の上昇を和らげます。
- 冷房のコストを軽減できます。(省エネ効果)
- 強化ガラスもに簡単に加工できます。
※金属膜の面への傷にはご注意下さい。
※金属膜の加工がされている面を、室内側にしてお使い下さい。 -
光触媒ガラスの表面に、鳥の糞が付いたら汚れはとれますか?
いいえ、ひどい汚れはとれません。
大量の有機物の汚れ(油や鳥の糞など)や砂ぼこり砂けむりのひどいところでは、きれいな水道水で流して下さい。鳥の糞などのひどい汚れは、光触媒膜で汚れを分解しきれませんので水道水などでの、メンテナンスが必要となります。それでも、取り除けない汚れにつきましては、柔らかいスポンジと中性洗剤を使い汚れを直接落として下さい。その後、きれいな水道水で洗い流して下さい。
室外側(光触媒膜)のメンテナンスには、散水を行って下さい。キリ状のスプレーで散水して下さい。換気口、軒下、サッシの外枠、外壁などへの散水には十分ご注意下さい。
なお、室内面は、通常のガラス同様に拭き掃除が可能です。
-
光触媒ガラスの厚みの種類、最大サイズは?
光触媒ガラスは厚みが薄く割れやすいため、あまり大きなガラスは作れません。 ガラスを販売するときは、規格のサイズ(作り置きガラス)から切り出して販売します。 規格サイズの最大寸法は5000ミリ × 2400ミリで、この範囲内であればどんな大きさでも可能です。
素板には、熱線反射ガラスや高性能熱線反射ガラス、強化ガラス、倍強ガラスなども使うことが出来ます。
※熱線反射ガラスや高性能熱線反射ガラスを使う場合は、特殊金属膜面は室内側になります。(外気面には、光触媒のコーティングの面は直射日光があたり、十分な雨水があたるようにな場所に設置して下さい。)
最大サイズは、5000ミリ × 2400ミリです、ただし素板の最大サイズとなります。また1枚あたりのガラスの重量が260kg以下に制限されす。
分割することでコストを抑えることが出来ます !
ほとんどの方が、ガラスを分割して製作しています。半分ずつ製作して並べて使っています。分割することで、運賃、ガラスの料金などのコストも抑えることが出来ます。
もし大きなガラスを、大きなまま商品をお客様の元へお届けする事となりますと、商品を鉄のパレットにのせて、そのパレットを大型トラックに積み込みし、荷下ろしの際も天井クレーンやフォークリフトでの荷下ろしが必要になります。また、ユニック装備付きの大型トラックでも運搬は可能ですが、いずれにしてもチャーター便となります。 その為、運送コストを減らす為にガラスを分割して購入される方もいらっしゃいます。 -
光触媒ガラスを使用する際の注意点は?
光触媒ガラスの使用上の注意は、下記の通りです。
- クリーニング効果を高める為、光エネルギー、十分な雨水、流れ落ちる重力(垂直使用)が必要となります。
- 清掃不要なガラスではありません。光触媒クリーニングの効果が十分に発揮できる環境下では、汚れの分解、親水化、降雨、汚れの除去といったクリーニングを繰り返し、長期間にわたりきれいな状態が持続されます。
- 鉄錆などのガラス自身が変質してしまう汚れに対しては、クリーニング効果はありません。
-
光触媒ガラスってどんな所に使われているのですか?
光触媒ガラスは、セルフクリーニングの特徴をいかして、高層ビルなど簡単に掃除ができないところで使われています。
光触媒膜が汚れを分解し雨で汚れが流される、このサイクルを繰り返します。また、光触媒膜は、汚れの付着を防ぐ効果もあります。簡単に掃除のできない所などには、最適のガラスです。
-
和紙調合わせガラスは、自分でも切れますか?
はい、ガラスカッターというものを使って簡単に切れます。
厚み10ミリぐらいまでなら簡単に自分でも切断できますので、DIY、日曜大工、 自分で窓ガラスの取替えなどを行う方には扱いやすいガラスと言えます。ガラスの切り方を動画で紹介 !
女性でも簡単に、切ることができます。ステンドグラスなどは、こうしてガラスを切って作られています。ただ、厚みが厚くなるほど切りにくくなります。
ガラスを切った後の切断面で手を切らないように十分ご注意下さい。 ガラスの切り方はとても簡単で、ガラスを切るのを一度見れば、結構すんなりと切れるようになります。
皆さん切り方を知らないだけで、本当に簡単なんです。 ガラスの切り方を動画で紹介するサイトを作りましたので、一度ご覧ください。ガラスの切り方の動画はについて見る > ガラスのホームセンター「ギヤマン」
フィルムの貼っていない面から、ガラスカッターで切り、ガラスが完全に切れたらカッターで和風フィルムを切るような方法になります。
ただ、切断面で手を切ったり、切断面がきれいに仕上がりません、オーダーサイズでのご注文をオススメします。
-
ショップカラーとは
ショップカラーとは、セントラル硝子(株)が製造している内装専用カラーガラスです。ほんのりと色味の違う白系統のカラーバリエーションが豊富なシリーズで、半数以上が 高透過タイプ です。
※2020年9月末をもって販売中止となりました。
-
ウォールカラー とは
「ウォールカラー」は、日本板硝子(株)が製造しているフロート板ガラスの片面に特殊塗料を焼き付た内装専用カラーガラスです。50色以上もの豊富なカラーバリエーションと、塗装面を保護する特殊膜でハガレ、褪色しにくい点が特徴です。 -
フリーデザイン合わせガラスは、屋外で使用は可能ですか?
フリーデザイン合わせガラスは、内装専用商品です。屋外には使用できません。必ず、屋内で使用して下さい。
雨や水のあたらない、室内でご使用下さい。水に濡れてしまいますと、ガラスとガラスの間に挟んである特殊フィルムやPET膜がぬれてしまうことがあります。ご注意下さい。
特殊フィルム(中間膜、PET膜)は有機物質ですので、ガラスの温度が70度以上になると特殊フィルムに泡が発生することがありますのでご注意下さい。高温になることが、予想されるような場所での使用は、控えて下さい。
-
フリーデザイン合わせガラスはどんな所に使われていますか?
フリーデザイン合わせガラスは、中間膜に様々な模様を描くことで自分にあったデザインに自分だけのデザインにすることが出来ます。その為、使われる場所も様々ですが、玄関のエントランスなど印象に残るところや目を引くところに使われることが多いです。
和風にも洋風にもデザインすることができ、それぞれの場所にあったガラスにできること間違いなしです。
-
フリーデザイン合わせガラスとは
フリーデザイン合わせガラスは、簡単に言うと自分の好きなサイズ、好きなデザイン通りに作れる合わせガラスです。
ガラスとガラスの間に熱圧着する、中間膜のデザインをフルカラーでオーダーできますし、デジタルオーダーをそのまま印刷するため、版がいらず、短期間での制作が可能です。
合わせガラスですので、万が一割れても破片が飛び散りにくく、安全です。
(2020年9月1日販売終了)
-
パンチングメタルガラスの最大サイズは?
呼び厚さ 最大サイズ 商品名 7ミリ 1200 × 1800ミリ メタファイン、ラミメタル 8ミリ 914 × 2438ミリ 型板ガラス(霞)仕様のラミメタル 11ミリ 1200 × 2400ミリ ラミメタル -
パンチングメタルガラスは自分で加工できますか?
「パンチングメタルガラス」をご自身で加工することはできません。
ガラス + 特殊フィルム + パンチングメタル + 特殊フィルム + ガラス という、かなり頑強な構造になっています。そのため、表面のガラスをカットすることは出来ても、フィルムおよびメタル部分を同時に切ることは不可能です。パンチングメタルガラスはこの強さにより、高い防犯性能を得ています。お好みのサイズのパンチングメタルガラスがご入用の際は、オーダーサイズでご注文下さい。
-
床用ガラスの最大サイズは?
厚みによって最大サイズが違います。表をご用意いたしましたのでご参考ください。
厚み 最大サイズ (重量) 約12ミリ (5ミリ + 2.2ミリ + 5ミリ) 1200 × 2400ミリ (72kg) 約14ミリ (6ミリ + 2.2ミリ + 6ミリ) 1200 × 2400ミリ (86kg) 約18ミリ (8ミリ + 2.2ミリ + 8ミリ) 1200 × 1800ミリ (87kg) 約22ミリ (10ミリ + 2.2ミリ + 10ミリ) 1000 × 1800ミリ (90kg) 約26ミリ (12ミリ + 2.2ミリ + 12ミリ) 900 × 1800ミリ (98kg) 約32ミリ (15ミリ + 2.2ミリ + 15ミリ) 900 × 1400ミリ (95kg) -
ガラスってツルツル滑りませんか?
滑止(滑り止め)付きのタイプは、「ノンスリップ加工」と呼ばれる、適度な抵抗値を持たせて歩きやすくかつ滑りにくくする、という特殊加工が施されています。表面にポツポツとした凹凸が作られており、滑りを防止しているのです。 -
床材を透明にしたいのですが、強化ガラスとアクリルのどちらがよいですか?
「割れないガラス」とも呼ばれる「アクリル」と、割れにくく安全な「強化ガラス」ですが、最も床材に適しているのは「合わせ加工」を施した強化ガラスです。小傷がついてしまうアクリル素材に比べ、ガラス素材は傷がつきにくく、床にはもってこいと言えるでしょう。
さらに、合わせ加工を施した強化ガラスは、万が一割れてしまった際にも、破片の飛び散りも無く大変安全です。
-
高透過ガラスの別名は?
高透過ガラスの事を「高透明ガラス」と呼んでおられる方もいらっしゃいます。
高透過ガラスは、通常のフロートガラスに比べガラス独特の青みが抜けており、透過率が高く、透明感が増したガラスです。そのため、ガラス越しに見た物の色がガラスの色に影響を受けることなく忠実に再現されます。
普通のガラスは、ガラスの厚みが厚くなる分、ガラス特有の青みが強まりますが、高透過ガラスは「ガラスの厚みが増しても透明感のあるガラス」でショーケース等に採用した場合、ディスプレーの内容の美しさがひきたちます。また、ガラスにプリントする加工を用いると、はっきりした色が忠実に再現されるため、デザインの自由度が格段に広がります。
-
高透過ガラスの各厚みごとの、最大サイズは?
日本板硝子(株)の製品
製品名 呼び厚さ(ミリ) 最大寸法(ミリ) オプティホワイト 3 2,300 × 1,850 4 5 3,600 × 2,300 6 5,200 × 2,300 8 10 12 15 19 分割することでコストを抑えることが出来ます !
ほとんどの方が、ガラスを分割して製作しています。半分ずつ製作して並べて使っています。分割することで、運賃、ガラスの料金などのコストも抑えることが出来ます。
もし大きなガラスを、大きなまま商品をお客様の元へお届けする事となりますと、商品を鉄のパレットにのせて、そのパレットを大型トラックに積み込みし、荷下ろしの際も天井クレーンやフォークリフトでの荷下ろしが必要になります。また、ユニック装備付きの大型トラックでも運搬は可能ですが、いずれにしてもチャーター便となります。 その為、運送コストを減らす為にガラスを分割して購入される方もいらっしゃいます。 -
高透過ガラスの厚みの種類は?
5ミリ、6ミリ、8ミリ、10ミリ、12ミリ、15ミリ、19ミリがあります。
普通のガラス(フロートガラス)に比べると、厚みの種類が厚いものになります。(2ミリ、3ミリ、4ミリがありません)
-
高透過ガラスを強化ガラスや防犯ガラスにする事はできますか?
はい、高透過ガラスは防犯ガラスにする事も強化ガラスにすることも可能です。透過率が高いことからショーウィンドや冷蔵ケースなどと、防犯面、安全面でも安心してお使いいただけます。 -
高透過ガラスは何によく使われていますか?
-
高透過ガラスとは
高透過ガラスは通常のフロートガラスに比べ、ガラス独特の青みが抜けていて、透過率が高く、透明感が増したガラスです。ガラス越しに見た物の色がガラスの色に影響を受けることなく忠実に再現できます。
普通のガラスは、ガラスの厚みが厚くなる分、ガラス特有の青みが強まりますが、高透過ガラスは「ガラスの厚みが増しても透明感のあるガラス」でショーケース等に採用した場合、ディスプレーの内容の美しさがひきたちます。また、ガラスにプリントする加工を用いると、はっきりした色が忠実に再現されるため、デザインの自由度が格段に広がります。

-
線入りガラス「プロテックス」は、どんなガラスですか?
網入りガラス、線入りガラスは、こちらの比較表をご覧いただくとわかりやすいです。
網入りガラス (磨) ヒシワイヤ クロスワイヤ
クロスワイヤ プロテックス
プロテックス
ワイヤーの間隔 
約20ミリ

約13ミリ

約50ミリ

網入りガラスは防火設備として、建設省告示第1360号などで定められています。防火設備は、火災を想定した加熱に20分間耐えられるものを指します。網入りガラスは割れたときに、ガラスが金網に引っかかるため破片が落ちません。そのため火の侵入や、破片による怪我を防ぐ効果があります。屋根やビルなど、高い場所にある窓に有効です。

線入りガラスは網入りガラスと違い、防火設備には認定されていません。しかし通常のガラスに比べて、割れた際の飛散が少ないです。そのため窓の安全性を高めることができます。
-
網入りガラスを切断加工する場合は、どのような方法が良いですか?

下記ページでは、網入りガラスを「切断機加工」と「ウォータージェット加工」の2種類で切断・加工し、その仕上がりを比較しています。結果はウォータージェット加工の方が綺麗な切断面になります。網入りガラスを加工する際は、ウォータージェット加工をオススメします。
-
AGCの網入りガラスには、どんな製品がありますか?

AGCが製造・販売する網入りガラス・線入りガラスは「ヒシワイヤ」「クロスワイヤ」「プロテックス」の3種類。ヒシワイヤとクロスワイヤが網入りガラスで防火対策、プロテックスが線入りガラスで飛散防止の役目を果たします。
ガラスには「磨 (みがき)」と「霞 (かすみ)」があり、このうち霞は視界を遮る型板タイプです。
-
網入りガラス「ヒシワイヤ」は、どんなガラスですか?
網入りガラス、線入りガラスは、こちらの比較表をご覧いただくとわかりやすいです。
網入りガラス (磨) ヒシワイヤ クロスワイヤ
クロスワイヤ プロテックス
プロテックス
ワイヤーの間隔 
約20ミリ

約13ミリ

約50ミリ

網入りガラスは防火設備として、建設省告示第1360号などで定められています。防火設備は、火災を想定した加熱に20分間耐えられるものを指します。網入りガラスは割れたときに、ガラスが金網に引っかかるため破片が落ちません。そのため火の侵入や、破片による怪我を防ぐ効果があります。屋根やビルなど、高い場所にある窓に有効です。
-
クリアサイトとは
 「クリアサイト」はAGCが製造・販売する低反射ガラスです。ガラス表面の反射を抑えることで、ガラスの向こう側が見えやすくなりました。美術館の展示物や自動車のショールームなど、ガラスの映り込みを減らして綺麗に見せたい場合に活用できます。
「クリアサイト」はAGCが製造・販売する低反射ガラスです。ガラス表面の反射を抑えることで、ガラスの向こう側が見えやすくなりました。美術館の展示物や自動車のショールームなど、ガラスの映り込みを減らして綺麗に見せたい場合に活用できます。 -
低反射ガラスを曲げる事(曲げ加工)できますか?
いいえ、できません。
低反射ガラスは、ガラス両面に特殊な多層コーティングがしてあります。ガラスを曲げる為には、加熱処理が必要になります。コーティングが熱で溶けてしまいますので曲げる加工はできません。
-
低反射ガラスの各厚みの最大サイズは?
AGC(株)の製品
品種 厚み(ミリ) 最大寸法(ミリ) 低反射ガラス 3 2438 × 1829 5 3600 × 2400 8 10 -
低反射ガラスを使いたいのですが、注意することはありますか?
- 低反射ガラスは『見えにくいガラス』です、人がぶつからないようにご注意下さい。
- 傷や水濡れに注意してください。また、ステッカーなどは、剥がす時に傷になるおそれがありますので、貼らないで下さい。
- ガラスの表面は、堅いものでは拭かないでスポンジなどの柔らかいもので、中性洗剤を含ませて軽く拭いてください。
※内装専用ですので、外装でのは使用は避けてください。
※物がおかれるショーケースの天板などには、使用は避けて下さい。 -
低反射ガラスは加工が出来ない!と聞いたことがあるのですが本当ですか?
はい、出来ません。低反射ガラスは表面に特殊なコーティングを施してありますので、加工するときにこの膜に傷をつけてしまいます。穴あけ、磨き(切断面の処理)など、機械で加工するものはほとんど出来ないと思ってください。 -
低反射ガラスは自分でも切れますか?
はい、ガラスカッターというものを使って簡単に切れます。
厚み10ミリぐらいまでなら簡単に自分でも切断できますので、DIY、日曜大工、 自分で窓ガラスの取替えなどを行う方には扱いやすいガラスと言えます。ガラスの切り方を動画で紹介 !
女性でも簡単に、切ることができます。ステンドグラスなどは、こうしてガラスを切って作られています。ただ、厚みが厚くなるほど切りにくくなります。
ガラスを切った後の切断面で手を切らないように十分ご注意下さい。 ガラスの切り方はとても簡単で、ガラスを切るのを一度見れば、結構すんなりと切れるようになります。
皆さん切り方を知らないだけで、本当に簡単なんです。 ガラスの切り方を動画で紹介するサイトを作りましたので、一度ご覧ください。ガラスの切り方の動画について見る > ガラスのホームセンター「ギヤマン」
-
もっと大きな低反射ガラスを使いたいのですが、どうすればいいですか?
これ以上大きな低反射ガラスは作れませんので、ガラスを分割して製作し、半分ずつを並べて使っています。分割することでコストを抑えることが出来ます !
ほとんどの方が、ガラスを分割して製作しています。半分ずつ製作して並べて使っています。分割することで、運賃、ガラスの料金などのコストも抑えることが出来ます。
もし大きなガラスを、大きなまま商品をお客様の元へお届けする事となりますと、商品を鉄のパレットにのせて、そのパレットを大型トラックに積み込みし、荷下ろしの際も天井クレーンやフォークリフトでの荷下ろしが必要になります。また、ユニック装備付きの大型トラックでも運搬は可能ですが、いずれにしてもチャーター便となります。 その為、運送コストを減らす為にガラスを分割して購入される方もいらっしゃいます。 -
低反射ガラスは、どんな大きさまで作れるのですか?(低反射ガラスの最大サイズ)
低反射ガラスの最大サイズは厚み3ミリの場合は、2438ミリ × 1829ミリ、厚み5ミリ、8ミリ、10ミリの場合は、3600ミリ × 2400ミリになります。 -
低反射ガラスを、強化ガラスにすることは出来ますか?
低反射ガラスは、強化加工することが出来ません。 -
低反射ガラスの厚みの種類はどんなものがありますか?
低反射ガラスの厚みは3ミリ、5ミリ、8ミリ、10ミリの4種類です。 -
低反射ガラスは、どんなところに使うのですか?
低反射ガラスは博物館や美術館の展示ケース、店舗のショーウィンドウ、文字盤(壁掛け時計など)のカバーガラスなど、映り込みを抑制したい場所に利用されます。 -
額縁に使いたいのですが、低反射ガラスを使えばいいですか?
結論から言いますと、お勧めしません。確かに、額縁に低反射ガラスを使えば、蛍光灯などの映り込みを少なくすることが出来ます。
しかし、低反射ガラスは料金がかなり高いので、額縁のガラスには無反射ガラス(シルクサイト)というガラスをお勧めします。
-
低反射ガラスは、普通のガラスと見た目は違うのですか?
見た目は、普通のガラスと見た目はまったく同じです。 -
低反射ガラスとは
低反射ガラスとは、ガラス両面に特殊な多層コーティングを施し、表面反射を約0.8%に抑えたガラスです。
多層コーティングによる干渉を利用し、反射を抑えています。ガラス表面の映り込みが少なく、ガラスの向こう側がよく見えます。
室内だけでなく屋外面への使用も可能です。
普通のガラスでは蛍光灯が反射しているのが分かりますが、低反射ガラスは映りこんでいません。
無反射ガラス(シルクサイト)と違い、展示物をガラスから離しても、見栄えは変わりません。ショーケースやショーウィンドウなどによく使われるガラスです。あと、映り込みが少ないので、カメラやビデオの撮影などにもよく使われます。
※展示物をガラスから離してもぼやけません。
-
無反射ガラスの表面の加工は、どちら向きで使うの?
無反射ガラス(シルクサイト)は、両面とも細かい凹凸加工されています。加工されている面を手で触っても、側で見ても裏表が分かりません。両面に同じ加工がされていますので、表面の加工はどちら向きでも、効果は変わりません。
無反射ガラスは、反射光を表面の凹凸加工された部分で、眩しさや反射を抑えています。
このガラスを使用する際の注意事項は、対象となる展示物とガラスの距離がある場合は、型板ガラスのようにぼやけて見えます。必ず密着させてご使用下さい。このガラスは、絵画や写真等の額縁のカバーガラスとしてよく使われます。
もしも、対象物との密着が難しい場合は、低反射ガラスのご使用をお勧め致します。
-
無反射ガラスを切るときはどちらの面を切ればいいのですか?
無反射ガラスの表面には、細かい凹凸があります。この凹凸加工は両面に施してあります。その為、どちらから切っても切れ方は同じになります。
型板ガラスのように凹凸がはっきりしているガラスですと、模様の入った面から切ると、凹みの部分にガラスカッターで切り目が入らず、失敗していまいますが、このガラスは、そんな心配はありません。
ガラスの切り方はとても簡単で、ガラスを切るのを一度見れば、結構すんなりと切れるようになります。ガラスの切り方を動画で紹介するサイトを作りましたので、一度ご覧ください。
ガラスの切り方を動画で紹介 ガラスのホームセンター「ギヤマン」 -
無反射ガラスに穴をあけたり、加工をすることは出来ますか?
無反射ガラスは、普通のガラスと同じで比較的加工のしやすいガラスです。穴を開けたり、切ったりすることが可能です。切断面を綺麗にする磨きも出来るのですが、厚みが2ミリしかないことと、ほとんどが額縁で隠れるため、切ったまま使われることの多いガラスです。 -
もっと大きな無反射ガラスを使いたいのですが、どうすればいいですか?
これ以上大きな無反射ガラスは作れませんので、ガラスを分割して製作し、半分ずつを並べて使っています。分割することでコストを抑えることが出来ます !
ほとんどの方が、ガラスを分割して製作しています。半分ずつ製作して並べて使っています。分割することで、運賃、ガラスの料金などのコストも抑えることが出来ます。
もし大きなガラスを、大きなまま商品をお客様の元へお届けする事となりますと、商品を鉄のパレットにのせて、そのパレットを大型トラックに積み込みし、荷下ろしの際も天井クレーンやフォークリフトでの荷下ろしが必要になります。また、ユニック装備付きの大型トラックでも運搬は可能ですが、いずれにしてもチャーター便となります。 その為、運送コストを減らす為にガラスを分割して購入される方もいらっしゃいます。 -
無反射ガラスは、どんな大きさまで作れるの?(無反射ガラスの最大サイズ)
無反射ガラスの最大サイズは914ミリ × 813ミリが最大サイズです。 -
無反射ガラスを、強化ガラスにすることは出来ますか?
無反射ガラスは、強化加工することが出来ません。 -
無反射ガラスの厚みの種類は?
2ミリの一種類です。
※展示物から離すと曇って見えるため、これ以上厚いものを作っても意味がありません。
-
無反射ガラスは、ショーケースなどに使えますか?
展示物からガラスを離すと展示物がくもって見えますので、ショーケースなどには利用できません。
ショーケースやショーウィンドウ、撮影時の反射を抑えたい方は、低反射ガラスをお勧めいたします。低反射ガラスは、展示物からガラスを離してもクリアーに見えて、かつ反射を抑制してくれます。
-
無反射ガラスは、どんなところに使うのですか?
 額縁専用と思っていただいていいと思います。絵画、魚拓、写真など展示する額縁によく利用されます。
額縁専用と思っていただいていいと思います。絵画、魚拓、写真など展示する額縁によく利用されます。 -
無反射ガラスは、普通のガラスと見た目は同じなのですか?
無反射ガラスは、普通のガラスと見た目が全然違います。普通に見るとすりガラスのように見えます。(展示物からガラスを離すとすりガラスのようにくもって見えます。)ただし、写真や絵などと密着させることで、ガラスのように透明に見えます。
-
無反射ガラスとは
別名反射防止ガラスとも呼ばれているガラスです。
ガラスの表面に、ごく細かい凸凹をつけることにより、反射光を広く散らし、反射や映り込みを抑えたガラスです。
 写真で見ていただければ分かると思いますが、普通のガラスでは蛍光灯が映りこんでいますが、無反射ガラスは光を拡散させて映り込みがしていません。
写真で見ていただければ分かると思いますが、普通のガラスでは蛍光灯が映りこんでいますが、無反射ガラスは光を拡散させて映り込みがしていません。 -
ラミトーンとは

「ラミトーン」はAGCが製造・販売する、主にデザイン効果を目的とした合わせガラスです。「グラフィカルパターンシリーズ」と「クリスタルカラーシリーズ」の2種類あります。
特性
- デザイン効果
- 紫外線遮蔽
- 防犯対策
- 安全対策
- 視線制御
主な使用場所
- 戸建住宅
- 集合住宅
- オフィスビル
- 店舗・商業施設
-
Lamicolle(ラミコレ) とは

「Lamicolle (ラミコレ)」はAGC(株)が製造・販売する、内装専用の「装飾合わせガラス」です。
写真やイラストのデジタルデータをオンデマンドでPVB膜に印刷し、これを特殊フィルムで挟み込んだ装飾合わせガラスです。合わせ仕様なので割れにくく、また割れても破片が飛び散りにくいなど、安全性も高くなっています。
(2020年9月1日販売終了)
▼こちらのサイトで製作を依頼できます。
ガラス印刷(ガラスプリント)&鏡の印刷の専門サイト「ガラス印刷.com」特性
- デザイン効果
- 安全対策
主な使用場所
- 戸建住宅
- 集合住宅
- オフィスビル
- 店舗・商業施設
特殊フィルム「PVB膜」にデザインを印刷
PVB (ポリビニルブチラール) は、合わせガラスの中間膜として使われる素材です。接着力が強いため、万が一ガラスが割れても破片が脱落せず、飛び散りません。ラミコレでは、このPVB膜に柄やイラストをカラー印刷し、2枚のガラスの間に挟みます。
ラミコレには2種類の印刷膜があります

ラミコレには印刷膜 (PVB膜) と共に、特殊フィルムを挟み込みます。フィルムには「透明」と「乳白」の2種類あり、それぞれ違った見え方になります。
規格
タイプ ガラス 印刷膜(ミリ) 特殊フィルム(ミリ) 呼び厚さ(ミリ) 透明 FL3 0.8 0.4 7.2 FL4 9.2 FL5 11.2 乳白 FL3 0.4(乳白) 7.2 FL4 9.2 FL5 11.2 最大・最小サイズ
品種 最大サイズ
(ミリ)最小サイズ
(ミリ)参考材料価格
(円/m2、税別)ラミコレ 透明 FL3 + 印刷膜08 + 特殊フィルム04 + FL3 2300 × 1800 300 × 200 87,400 FL4 + 印刷膜08 + 特殊フィルム04 + FL4 3000 × 2000 92,000 FL5 + 印刷膜08 + 特殊フィルム04 + FL5 3600 × 2400 94,300 乳白 FL3 + 印刷膜08 + 特殊フィルム04乳白 + FL3 2300 × 1800 89,700 FL4 + 印刷膜08 + 特殊フィルム04乳白 + FL4 3000 × 2000 94,300 FL5 + 印刷膜08 + 特殊フィルム04乳白 + FL5 3600 × 2400 96,600 AGC「INGLASS(イングラス)」シリーズ
AGCの住宅向け内装ガラス「INGLASS(イングラス)」シリーズは、インテリアとしての価値を追求したブランドです。下記の4種類があります。
INGLASS(イングラス)シリーズ -
ペアガラスで防音にも優れたガラスは?

ペアガラスは、単体でも通常のガラスに比べて防音効果が高いです。
しかし、それよりも効果が高いのがAGCの「マイミュート」です。外が70dBでも、室内では35dB程度になります。
これはガラスのみの性能となっており、防音サッシと合わせることにより防音性能が発揮されます。ちなみに、70dBは大声での会話。35dBとは畳のすり足よりも静かな音。
 住んでいる地域によっては、生活を格段に快適にしてくれる素敵なガラスです。
住んでいる地域によっては、生活を格段に快適にしてくれる素敵なガラスです。 -
防音ガラス(合わせガラス)とは、どんな特性を持ったガラスですか?
- 遮音機能に優れている
合わせガラスの間の防音特殊フィルムがガラスの振動を吸収します。
- 破片が飛び散りにくい
ガラスと防音特殊フィルムが接着されているため、地震や衝撃などで万が一破損しても、破片が飛び散ったり、抜け落ちたりしにくい。
- 衝撃物が貫通しにくい
防音特殊フィルムは柔軟で強靱。衝撃物が貫通しにくくなっています。
- 紫外線を遮る効果
防音特殊フィルムによって、99%以上の紫外線をカットします。
-
防音ガラスの、厚み・大きさは?
AGC(株)の製品
品種 素板の呼び厚さの合計(ミリ) 最大寸法(ミリ) ラミシャット30 6 2400 × 1580 ラミシャット35 10 3600 × 1580 11.8 日本板硝子(株)の製品
品種 ガラスの構成 最大寸法(ミリ) ソノグラス フロート3ミリ + フロート3ミリ 2540 × 1885 フロート2ミリ + 型板4ミリ 1800 × 1200 -
型板ガラス、網入りガラスの遮音効果は?
なんと遮音効果は、同じ厚みのフロートガラスと同じなんです。
音を防ぐ為には、防音ガラスをお使い下さい。
-
窓を防音ガラスにしましたが、思っていたよりも効果がありません。なぜですか?
窓ガラスを防音ガラスにしただけでは、高い遮音効果が得られません。
遮音効果を高める為には、ガラス、サッシなどの開口部の他にも、壁、床、天井などの建物全体で総合的に防音対策をしていただく必要があります。
しかし、音の多くが開口部(窓など)から伝わってきます。音が気になったらまず、防音ガラスと防音サッシへの交換をオススメします。
-
音ってどうやって、伝わってきますか?
音を簡単に言うと、空気の振動のことです。
物体が振動して、空気に波を作り、それが空気中や物質を伝わって耳に届くと音として聞こえます。いやな音、いい音もすべて空気の振動によって発生しています。
-
防音ガラスは自分で切ることができますか?
いいえ、切ることはできません。
防音ガラスはガラスとガラスの間に特殊フィルムが密着されています。その為片側から切ったのでは切れませんし、両側から切っても切れません。ガラスの切り方は、簡単に説明すると表面にガラスカッターで傷をつけて、傷にそって割るような感じです。
-
防音ガラスを窓に使うだけで、本当に防音効果があるのですか?
実は、音はサッシからも漏れます!
せっかく防音ガラスに入れ替えても、サッシから音が漏れては意味がありません。
防音サッシとの組み合わせで、想像以上の防音効果が期待できます。 -
防音ガラスは、どんな所で使われていますか?
- 車の通行が多い道路の側にある家やビルの窓
- 電車の線路の近くにある家やビルの窓
- 繁華街の近くにある家やビルの窓
- ピアノやその他の楽器を弾く部屋のガラス、大音量で音楽を聴くAVルームの窓
などに使われています。
防音ガラスは、外から中に入ろうとする音、中から外に出ようとする音それぞれを防ぐ力があります。
-
防音ガラスは合わせガラスだと聞きましたが、本当ですか?
はい、2枚のガラスの間に防音特殊フィルムを挟み、加熱圧着した合わせガラスの事を、防音ガラスと呼んでいます。 -
スクールセーフィーとは、どのようなガラスですか?
 「スクールセーフィー」は、学校などの公共施設に向けた合わせガラスです。ガラスが割れても破片が飛び散らず、貫通もしにくいため、防犯や防災に役立ちます。スクールセーフィーのガラス面には、左のマークが入っています。学校施設においては、地震や台風などの自然災害、もしくは生徒がガラスに衝突することなどに備えることが必要です。また、外部からの不法侵入に備えることも重要な課題です。スクールセーフィーは、そうしたニーズに応える製品です。
「スクールセーフィー」は、学校などの公共施設に向けた合わせガラスです。ガラスが割れても破片が飛び散らず、貫通もしにくいため、防犯や防災に役立ちます。スクールセーフィーのガラス面には、左のマークが入っています。学校施設においては、地震や台風などの自然災害、もしくは生徒がガラスに衝突することなどに備えることが必要です。また、外部からの不法侵入に備えることも重要な課題です。スクールセーフィーは、そうしたニーズに応える製品です。 -
石英ガラスの平面度はどれくらいですか?
平面度とは、平面の滑らかさを表す数値です。
以下の数値は、3次元測定器を使用し、厚さ5ミリの「溶融石英ガラス」を測定した値です。
一片の長さ 平面度 300mm 200μm ※この数値は、実験で行った際に出た参考値で、製品を保証するための数値ではありません。
石英ガラスは、インゴットから切り出し、材料の表面を研磨する硝材になります。
厚みによって研磨の精度も変わるため、上表の値と数値も異なってきます。標準品の石英ガラスは、覗き窓などに使用することを想定しているため、平面度の精度はそれほど高くありません。平面度の優れた石英ガラスをお求めの場合は、表面の研磨加工をオススメします。
-
合成石英ガラスの光透過率は?
一般的な「合成石英ガラス」の光透過率は下記グラフの通りです。
- 縦軸は透過率 (transmittance:%)
- 横軸は波長 (wavelength:nm)
- グラフ内の数値は板厚 (thickness:mm)
を示します。
 「JIS Z 8120」によれば、可視光線として肉眼で捉えられる範囲は 360nm ~ 400nm であるとされ、紫外線はこれよりも小さい (短い) 波長を指します。
「JIS Z 8120」によれば、可視光線として肉眼で捉えられる範囲は 360nm ~ 400nm であるとされ、紫外線はこれよりも小さい (短い) 波長を指します。 -
石英ガラス (溶融石英ガラス) の光透過率は?
一般的な「石英ガラス (溶融石英ガラス)」の光透過率は下記グラフの通りです。
- 縦軸は透過率 (transmittance:%)
- 横軸は波長 (wavelength:nm)
- グラフ内の数値は板厚 (thickness:mm)
を示します。
 「JIS Z 8120」によれば、可視光線として肉眼で捉えられる範囲は 360nm ~ 400nm であるとされ、紫外線はこれよりも小さい (短い) 波長を指します。
「JIS Z 8120」によれば、可視光線として肉眼で捉えられる範囲は 360nm ~ 400nm であるとされ、紫外線はこれよりも小さい (短い) 波長を指します。 -
溶融石英ガラスと石英ガラスは違うのですか?
「溶融石英ガラス」と「石英ガラス」は同じものです。厳密には、水晶の粉末を、酸水素火炎や電気等で溶かして作る石英ガラスの事を、溶融石英ガラスと呼びます。 -
石英ガラスは何℃位で軟らかくなりますか?軟化点と融点は何℃ですか?
石英ガラスの軟化点は 約1700℃ほど です。
石英ガラスを変形させるには、加工温度である 1900℃ でも、相当強い力が必要です。石英ガラスは気体の蒸気圧が大きいために、固体から直接気体に移行するので融液状態にはなりません。
-
合成石英ガラスと石英ガラスは違うのですか?
「合成石英ガラス」と「石英ガラス」は違うものです。人工的に石英ガラスをさらに高純度 (泡や異質物、不純物が極めて少ない様子) にしたものを合成石英ガラスと呼びます。
合成石英ガラスは主に、光ファイバーや、半導体製造用器具、液晶ディスプレイなどに使われています。
-
石英ガラスはどのように製造されていて どんな種類がありますか?
石英ガラスは 約2000℃ という高温度でなくては融けません。その為、特殊な製造方法で作られています。
石英ガラスの伝統的製造方法は、以下の4つが代表的です。
- 天然石英を電気で溶かし作製。
- 天然石英を圧縮した酸素と水素の混合ガスによる炎で直接加熱し溶かして作製。
- 「シラン化合物」を圧縮した酸素と水素の混合ガスによる炎で熱し、水と反応させ分解。生じたガラスの微粒子を直接積み重ね、固めて作製。(シラン:水酸化ケイ素)
- シラン化合物を分子分解し、生じたガラスの微粒子を積み重ね、固めて作製。(シラン:水酸化ケイ素)
上記の方法によって作成された石英ガラスは性質が違います。その具体的な違いは下記の通りです。
- 金属不純物が比較的多いもの、極めて少ないもの。
- 水があるもの、ほとんど無いもの。
- 光学的に均一なもの、不均一なもの。
- 一定の波長の紫外線を吸収するもの、しないもの。
-
石英ガラスが「ガラスの王様」と呼ばれているのは本当ですか?
石英ガラスは火の中に入れて急激に加熱しても、赤熱状態から水中に入れて急冷しても割れず、バーナーで焙っても形が崩れず、濃酸につけてもなかなか溶けない丈夫なガラスのため、「ガラスの王様」と呼ばれています。 -
着色(カラー)合わせガラスの厚み種類、最大サイズは?
着色合わせガラスの厚み種類、最大サイズは、下記の表の通りです。
ガラスの構成(ミリ) 総厚(ミリ) 製作限界サイズ(ミリ) 発送可能サイズ(ミリ) フロートガラス 3 + 3 6 1800 × 2400 1800 × 1200 強化ガラス 4 + 4 8 2400 × 3000 1800 × 1200 -
着色(カラー)合わせガラスは自分で切れますか?
いいえ、切ることができません。
着色合わせガラスはガラスとガラスの間に特殊フィルムが密着されています。その為片側から切ったのでは切れませんし、両側から切っても切れません。ガラスの切り方は、簡単に説明すると表面にガラスカッターで傷をつけて、傷にそって割るような感じです。
また、合わせガラスは防犯ガラスに使われることが多い為、自分で切る事はできません。
オーダーサイズでのご使用をお勧めいたします。
-
石英ガラスの耐熱温度は何℃ですか?
最高使用温度 常温使用温度 石英ガラス 1000℃ 900℃ ※ 「石英ガラス管」の耐熱温度も同じです。
常用使用温度・最高使用温度とは ?
最高使用温度は、短時間のみ使用できる温度で、一瞬であれば、この温度まで耐えることが出来ます。また、常用使用温度は、連続して使用することが出来る温度で、この温度までであれば、連続して過熱しても大丈夫だといえる温度です。 -
着色(カラー)合わせガラスとは?
着色(カラー)合わせガラスは、普通の透明のガラス(フロートガラス)に間に、着色した特殊フィルムを熱圧着した合わせガラスです。下記の様な特徴があります。
- 万が一割れても、破片が飛び散りにくい。
- 衝撃物が貫通しにくい。
表面にカラーフィルムを貼った場合と異なり、2枚のガラスに挟まれ保護されていますので、フィルムに傷や汚れがついたり、外れたりする恐れが全くありませんので安心してご利用いただけます。
また、現場での職人によるフィルム張りの作業が必要がありませんので、施工コストを抑えることが出来ますし、施工品質が高くなるのもメリットの一つです。
-
バイコールの透過率は?
バイコールの透過率は、下記の図の通りです。
-
泡入りガラスはどんな風に製造されているのですか?
泡入りガラスの作り方は、一度作られた板ガラス(サンド・ソーダ灰・シリケート・アルミナ等でできたガラス)を粉々にします。その粉々になったガラスにカーボンを混ぜ合わせ、その後高温の釜の中に入れ加熱させます、そのガラスを冷やしてできたガラスが泡入りガラスです。
ガラスに泡を入れるなんて?とても不思議でしたが、作り方をしって納得しました。一度砕いたガラスとカーボンを混ぜて釜の中で焼くことによって、反応を起こして気泡が出来るのです。
泡の量を調節出来るのも納得ですね!
この作り方は、サンゴバン社が開発した製法です。
-
バイコールは多孔質ガラスとは違うのですか?
「バイコール」と「多孔質ガラス」は呼び方の違いであり、同じものを指します。 -
バイコールは急な温度変化に耐えられますか?
バイコールは耐熱衝撃性も非常に優れています。
0.3175センチ厚の薄い板状に加工したバイコールを1200℃まで熱し、氷水で急激に冷やしても割れることはありません。
-
バイコールの耐熱温度は何℃ですか?
バイコールの最高使用温度と常温使用温度は以下の通りです。
最高使用温度 常温使用温度 バイコール 1200℃ 900℃ 常用使用温度・最高使用温度とは ?
最高使用温度は、短時間のみ使用できる温度で、一瞬であれば、この温度まで耐えることが出来ます。また、常用使用温度は、連続して使用することが出来る温度で、この温度までであれば、連続して過熱しても大丈夫だといえる温度です。 -
クラックガラスを曲げること(曲げ加工)はできますか?
はい、曲げガラスにできます。
曲げ加工とは

曲げ加工とは、金属製の型の上にのせた板ガラスを電気やガスを使用した加熱炉の中に入れ、ガラスの軟化温度付近(580~600℃)まで、徐々に加熱する加工。
軟化した板ガラスは、ガラス自身の重みにより金属製の型に沿って曲がります。曲がり終えたガラスは、加熱を止め炉内において熱をさまします。その時同時に熱加工によりガラスに発生した歪み・反りを取り除いてくれます。
-
バイコールの厚みの種類や製作できる最大サイズはどのくらいですか?
バイコール(1200℃タイプ)の厚みの種類と最大製作可能サイズは、以下の通りです。
厚み サイズ 3 ミリ 30センチ × 30センチ まで 5.5 ミリ 30センチ × 30センチ まで 8.5 ミリ 30センチ × 30センチ まで 10 ミリ 30センチ × 30センチ まで 12 ミリ 30センチ × 30センチ まで -
クラックガラスの厚みの種類は?
フロートガラス+強化ガラス+フロートガラスの組み合わせでできていますので、組み合わせによっていろんな厚みのサイズを作ることができます。
フロートガラスの厚み:4ミリ、5ミリ、6ミリ、8ミリ、10ミリ、12ミリ、15ミリ、19ミリ
強化ガラスの厚み:4ミリ、5ミリ、 6ミリ、 8ミリ、 10ミリ、 12ミリ、 15ミリ、 19ミリ
お好きな厚みの組み合わせが可能です。
-
バイコールはどこで作られていますか?
バイコールは、アメリカの「コーニング社」で製造されています。メーカーが生産を中止し、おそらく国内には在庫が無い状態です。現在、同じ常温使用温度900℃の石英ガラスに、利用が置き換わっています。 -
パンチングメタルガラスの厚みの種類、最大サイズは?
-
パンチングメタルガラスを使う際の、注意することは?
使用上の注意は下記の通りです。
防火設備用のガラスとしては、ご使用いただけません。
製造上、端の方には少し気泡か発生することがありますが、商品の強度、接着性などに問題はありません。 -
パンチングメタルガラスは、自分でも切ることができますか?
いいえ、残念ながら自分で切ることはできません。
ガラス+特殊フィルム+パンチングメタル+特殊フィルム+ガラスの構造になっています。その為、例えガラスを切ることができたとしても、中間の特殊フィルムやパンチングメタルを自分で切ることができません。
-
チェッカーガラスの別の名前で呼ばれていると聞きました、なんと呼ばれていますか?
ワッフルガラス・モザイクガラス・デザインガラスなどと呼ばれています。 -
チェッカーガラスは、どんな模様(柄)の種類がありますか?

チェッカーガラス(ヒシクロス) 格子特大 格子サイズ 約15ミリ × 15ミリ 
チェッカーガラス(リストラルM) 格子大 格子サイズ 約13ミリ × 13ミリ 
チェッカーガラス(リストラルF) 格子小 格子サイズ 約4ミリ × 4ミリ 
チェッカーガラス(リストラルK) 格子極小 格子サイズ 約1ミリ × 1ミリ -
フッ化マグネシウムガラスの最大サイズは?

加工可能な最大サイズは、φ5ミリ~φ100ミリとなります。
こうして指定サイズに切られたガラスは、紫外線の各種窓材(カバーガラス)、紫外線の波長域の直接偏光器などといった、光学材料としても使われています。
-
フッ化マグネシウム(MgF2)ガラスとは?
フッ化マグネシウムガラスとは、紫外線の透過がフッ化カルシウム(蛍石)より優れたガラスです。また、機械的強度にも優れています。
複屈折があり、レンズにはむいていませんが、紫外線の各種窓材(カバーガラス)、紫外線の波長域の直接偏光器などといった、光学材料としても使われています。
色は無色です。
-
チェッカーガラス(レトロ)の耐熱温度は何℃ですか?
表面に凹凸があるために、ガラスの厚みが部分によって異なります。厚みによって耐熱温度も異なります。急激に温度変化するような場所にはチェッカーガラスを使うことはお勧めしておりません。 -
チェッカーガラス(レトロ)は、外装に使えますか?凸凹の面は家の外側?それとも内側に使うのですか?
チェッカーガラスは外装にも使えます。しかし、大きな開口部での使用はできません。開口部の面積などにもよりますので、ご注意下さい。
風圧や雪荷重等が作用するような場所で単独で使用すると破損の恐れがあります。また、二重窓として外側にガラスがある状態で使用する事もできます。
-
チェッカーガラス(レトロ)の不規則な模様は両面にあるの?
それぞれのガラスにより異なります。
・ チェッカーガラス(カロリー)、チェッカーガラス(リストラルM)
→凹凸が大きい面と小さい面があります。凹凸が大きい面が表になります。
・ チェッカーガラス(リストラルF)、チェッカーガラス(リストラルK)
→表面に凹凸があり、裏面は平滑面となっています。
-
チェッカーガラス(レトロ)の最大サイズは?
チェッカーガラスは全て最大1200ミリ × 1800ミリとなっています。
最小サイズは特に決まっていません。
-
ガラスとガラスの間に和紙の入った合わせガラスは作れますか?

はい、製造可能です。
ガラスとガラスの間に和紙を入れて合わせガラスを作ることは可能です。JRの京都駅の地下にも和紙調の合わせガラスが柱に巻いてあります。
昔は、駅の柱と言えば、コンクリートのむき出しのまま、そこにポスターが貼ってあったりとあまり、柱のデザインや色を気にしたことが無いと思いますが、ガラスを巻いているとそれだけでイメージがすごく変わります。
京都駅には、自然美を表現した物、幾何学模様の柄の描かれた物、エッジングガラスをつかったものなどがあります。 -
チェッカーガラス(レトロ)の厚みの種類はどれだけありますか?
チェッカーガラスの厚みは標準4ミリですが、凹凸の大きな型板ガラスとなるために厚みは均一ではありません。
建具や、窓、家具に使われる場合は飲み込みを多めに取っていただくことをお薦めします。
-
合わせガラスの曲げ加工はできますか?
はい、曲げガラスにすることは可能です。曲げ加工とは?
曲げ加工とは、金属製の型の上に板ガラスをのせて、電気やガスを使用した加熱炉の中に入れ、ガラスの軟化温度付近(580~600度)まで、徐々に加熱します。
軟化した板ガラスは、ガラス自身の重みにより金属製の型に沿って曲がります。曲がり終えたガラスは、加熱を止め炉内において熱をさまします。その時同時に熱加工によりガラスに発生した歪み・反りを取り除いてくれます。
ガラスの曲げ加工について見る > ガラスの加工のことならガラス加工.com
-
合わせガラスに、装飾タイプのものはありますか?
はい、あります。
AGC(株)からででいる、ラミトーンという商品です。
バリエーションが豊富にありますし、適度なプライバシー効果があります。透過性をコントロールできます。
ガラスとガラスの間に特殊フィルムが接着されています。その為、万が一破損しても、破片が飛び散りにくくなります。
-
合わせガラスは、不燃材ですか?
合わせガラスは不燃材として認定されていません。
※フロートガラス(普通のガラス)は平成12年建設省告示第1400号「不燃材料を定める件」により、不燃材とされています。
-
合わせガラスは、紫外線をカットすると聞いたのですが本当ですが?
はい。合わせガラスには2枚のガラスの間に、熱圧着された特殊なフィルムがあります。このフィルムが紫外線を99.9%以上カットしてくれます。
ちなみに、通常の一般的な5ミリ厚のフロートガラスの紫外線カット率は約36%ほどです。
-
合わせガラスに、自分で穴を開ける事はできますか?
いいえ、できません。合わせガラスは自分で穴をあける事ができません。
合わせガラスは、防犯ガラスに使われることが多いため、穴あけはもちろん切ったりもできません。
-
モールガラスに自分で穴を開ける事は出来ますか?
 はい、サークルカッターというものを使って穴を開ける事ができます。
はい、サークルカッターというものを使って穴を開ける事ができます。
穴あけは円切りカッター(サークルカッター)を使うのですが、ただ丸く切るだけでは絶対に失敗します。 正しい順序で、あわてずにコツコツ粉々にしていくのがコツです。ガラスの切り方を動画で紹介 !
ガラスへの穴の開け方を動画で紹介するサイトを作りましたので、一度ご覧ください。
ガラスの切り方の動画はこちら > ガラスのホームセンター「ギヤマン」
はい、サークルカッターというものを使って穴を開ける事ができます。
穴あけは円切りカッター(サークルカッター)を使うのですが、ただ丸く切るだけでは絶対に失敗します。 正しい順序で、あわてずにコツコツ粉々にしていくのがコツです。
ガラスへの穴の開け方を動画で紹介するサイトを作りましたので、一度ご覧ください。
ガラスの切り方を動画で紹介 ガラスのホームセンター「ギヤマン」
モールガラスは、型板ガラスです。
型板ガラスは片面がザラザラ、もう片面がつるつるしていますので、ツルツルした面から穴あけしてください。ザラザラ面から穴あけすると失敗します。
また、小さい穴につきましては、ガラスドリルを使って簡単に穴あけすることができます。
-
フッ化バリウムガラスの光透過率は?
フッ化バリウムガラスの透過率は下記グラフの通り。
波長の単位はマイクロメーターで表されており、1μm=1000nmとなります。

-
フッ化バリウムガラスの特性は?
BaF2の特性は、下記の通りです。
結晶構造 等軸結晶 熱膨張係数 1.8 × 10-5/℃
(20~60℃において)熱伝導度 2.8 × 10-3cal/cm・sec・℃
(13℃において)比重 4.83 融点 1280℃ 硬度
(Knoop No)82 劈開面 {111} -
モールガラスの厚みは、何ミリですか?
モールガラスの厚みは、4ミリのみとなります。 -
フッ化バリウムガラスの最大サイズは?
加工可能な最大サイズは、φ5ミリ~φ100ミリとなります。普通のガラスとちがって、加工サイズも円形になります。
こうして指定サイズに切られたガラスは、フッ化物結晶としては最長の13μmの波長までの広い透過波長領域を持つという特徴をいかして、赤外線を使用した分析機器類や高出力赤外レーザー用(印刷機器の一部、セキュリティ他)の光学材料として利用されています。
-
モールガラスの最大サイズは?
厚み 最大サイズ モールガラス(12ミリ幅) 4ミリ 1200ミリ × 1800ミリ (21.6kg) モールガラス(21ミリ幅) 4ミリ 1200ミリ × 1800ミリ (21.6kg) -
モールガラス(レトロ)の耐熱温度は何℃ですか?
表面に凹凸があるために、ガラスの厚みが部分によって異なります。厚みによって耐熱温度も異なります。急激に温度変化するような場所にはモールガラスを使うことはお勧めしておりません。 -
フッ化バリウムガラスとは何ですか?
読んで字のごとくフッ素とバリウムを含んだガラスの事です。
このガラスの特徴は、赤外線の透過が大変優れていることです。なんとフッ化物結晶としては最長の13μmの波長までの広い透過波長領域をもっています。この特徴をいかして、赤外線を使用した分析機器類や高出力赤外レーザー用(印刷機器の一部、セキュリティ他)の光学材料として利用されています。ただ、温度衝撃には弱いため、急な温度変化は避けて下さい。
色は、無色です。
μmとは?
マイクロメールと読みます。赤外線の波長程度をを表す単位です。1μm=0.001ミリメートルです。 -
ラコベルプリュム とは


商品構造

厚さ2ミリのカラーガラスと、3ミリの発泡樹脂を合わせた部分がラコベルプリュム。壁面や鏡の装飾に使われることが多い製品です。
2017年度グッドデザイン賞を受賞
ラコベルプリュムは、2017年度にグッドデザイン賞を受賞しています。
ラコベルプリュムの前身である「ラコベル」は、AGC(株)が2013年に国内での販売を開始しました。しかし1㎡あたり12kg以上あったため、専門のガラス業者しか取り扱うことができませんでした。
「日本の住宅はお洒落であるべき。そのために高級感を演出できるガラスを内装材として使って欲しい」。このように考えたAGC(株)は、2017年1月、重量を60%軽くすることに成功した「ラコベルプリュム」を発売しました。軽量化したことで、一般の内装施工業者やDIYする人にも扱いやすくなりました。
ラコベルプリュムは軽いだけではなく、安全面にも配慮した商品。壁と接する面には全面に樹脂加工がされており、万が一ガラスが割れても飛び散りにくいです。
こうした機能面、デザイン面が評価されて、グッドデザインの受賞となりました。
-
モールガラス(レトロ)は、ストライプガラスと違うのですか?
はい、そうとも呼ばれています。
モールガラスの表面が、ストライプの柄でとてもおしゃれなガラスです。アンティーク家具などによく使われていますよ。
-
フッ化カルシウムガラスの透過光領域は?
フッ化カルシウムガラスの透過光領域は下記グラフの通り。
波長の単位はマイクロメーターで表されており、1μm=1000nm (ナノメーター)となります。
-
フッ化カルシウムガラスの特性は?
CaF2の特性は、下記の通りです。
結晶構造 等軸結晶 熱膨張係数 2.4 × 10-5/℃
(20~60℃において)熱伝導度 2.32 × 10-2cal/cm・sec・℃
(36℃において)比重 3.18 融点 1360℃ 硬度
(Knoop No)158 劈開面 {111} 溶解度 1.51 × 10-3g/100g
H2O(20℃) -
カラードアンティークを強化ガラスにすることはできますか?
いいえ、残念ながら強化ガラスにすることはできません。
カラードアンティークの厚みは約3ミリですが、強化ガラスにできるガラスの厚みは4ミリからとなります。また、ガラス表面に不規則な模様があり厚みも均一ではないため、強化加工を行うことができません。
-
フッ化カルシウムガラスの最大サイズは?
加工可能な最大サイズは、φ5ミリ~φ200ミリとなります。
こうして指定サイズに切られたガラスは加工されて、アポクロマート(理科の授業で使った顕微鏡の対物レンズの一種)、望遠レンズをはじめ、カメラのズームレンズ、テレビカメラのレンズ、天体望遠鏡のレンズなどの製品に使われています。
円形だけでなく、四角形にも加工できます。お問い合わせ下さい。
-
カラードアンティークを複層ガラスにする事はできますか?
複層ガラスにすることは可能です。複層ガラスにすることによって、窓としてのバリエーションが増えます。 -
カラードアンティークは合わせガラスにすることはできますか?
できますが、下記条件があります。
合わせる板厚の差が4ミリ以内となります。4ミリを超えますと、製造中や、納品後に破損する場合があります。カラードアンティークは3ミリなので、合わせる板厚は5ミリまたは6ミリまでとなります。
-
フッ化カルシウムガラスは、どんな所に使われていますか?
フッ化カルシウムガラスは、優れた透過性を持っています。その上屈折率も低く・分散率も低いといった特性があります。ひずみやぼけが無いためレンズにピッタリです。この優れた特性をいかしてレンズとして使われています。どんなレンズに使われているの?
アポクロマート(理科の授業で使った顕微鏡の対物レンズの一種)、望遠レンズをはじめ、カメラのズームレンズ、テレビカメラのレンズ、天体望遠鏡のレンズなどの製品に使われています。
日本各地の大きな天体望遠鏡のレンズとして使われています。
-
カラードアンティークガラスの耐熱温度は何℃ですか?
温度が一様に上がるのであれば110℃程度まで耐えられます。しかし、一部に金属による抑え等がございますと、そこからガラスが冷やされて温度応力が発生して破損する恐れがあります。 -
カラードアンティークを戸棚のガラスに使いたいのですが、引き手加工は出来ますか?
カラードアンティークは厚みが均一ではありません。よって引き手加工についてはお受けできない状況ですが、取っ手を付けることにより引き戸として使用することは可能です。 -
フッ化カルシウムCaF2とは、何でしょうか?

呼んで字のごとくフッ素とカルシウムからなる有機化合物です。別名、蛍石とも呼ばれています。蛍石の主成分はフッ化カルシウムです。
色は、無色です。
収差なしのガラス
フッ化カルシウムガラスは透過波長領域が広くて、屈折率も低く・分散率も低いという特性をもっています。この特性をいかして(アポクロマート)望遠レンズをはじめ、ズームレンズ、テレビカメラ、天体望遠鏡などの製品に使われています。このレンズ(ガラス)を使えば二次色収差を完全に取り除くことが可能です。収差とは?
物体がレンズや反射鏡によって像を結ぶ場合、元の物体と同じ形状にならず、ひずみやぼけを起こしてしてしまいます。この現象を収差と呼んでいます。 -
カラードアンティークガラスには、穴など加工することは出来ますか?
残念ながらカラードアンティークガラスの穴あけ加工は出来ません。サークルカッターでの穴開け加工は可能です。 -
カラードアンティークは外装に使えますか?凸凹の面は家の外側?それとも内側?
外装に使えます。凸凹面は汚れが付きにくいように家の内側にしてご使用ください。また、風圧や雪荷重等が作用するような場所で使用すると破損の恐れがありますので、ペア加工がオススメです。 -
カラードアンティークには不規則な模様が両面にあるのですか?
いいえ、片面にだけ模様があります。凸凹している模様は片面のみですが、両面から模様が見えます。 -
放射線遮蔽用鉛ガラスは、自分で切れますか?
残念ながら自分で切ることができません。
放射線遮蔽用鉛ガラスは、透明ガラス + 特殊フィルム + 鉛ガラス + 特殊フィルム + 透明ガラスのガラス3枚フィルム2枚の合わせガラスになっています。
ガラスの切り方は、簡単に説明すると表面にガラスカッターで傷をつけて、傷にそって割るような感じです。その為片側から透明ガラスを切ったのでは真ん中の鉛ガラスが切れませんし、両側から透明ガラスを切っても中間の鉛ガラスは切れません。
オーダーサイズでのご使用をお勧めいたします。
-
鉛ガラス(放射線遮蔽ガラス)の鉛当量は?
厚みによって鉛当量(mmPb)が違います。下の表をご覧下さい。
鉛当量(mmPb) 1.5 2.0 2.5 3.0 製品の厚さ(ミリ) 14 16 18 21 厚みが厚くなればなるほど、鉛当量が多くなっています。
X線を防ぐために、同一の条件でX線を照らし、X線遮る能力を鉛の厚さに換算して表す場合に、鉛当量(mmPb)という単位で表現されます。
鉛を使う物としては、身近なところでは鉛筆が代表的です。古代ローマの時代から鉛は、鉛筆として使われていたそうです。
鉛ガラスと言っても、工学レンズに使われている物やクリスタルガラスなどもあります。表の鉛当量は、放射線遮蔽用鉛ガラスの量を表しています。
-
鉛ガラス(放射線遮蔽ガラス)の厚みの種類は?
厚みの種類は、11ミリ、12ミリ、14ミリ、16ミリ、19ミリの4種類です。
フロートガラス+鉛ガラス+フロートガラスの合わせガラスになっています、ただ厚みが厚くなっている訳ではなく、鉛ガラスの弱点とも言われた、ガラス表面のやけ(くもり)を発生させないために、カバーガラスを両面に合わせた構造となっています。その為、厚みが厚くなっているのです。
比較的厚みの厚いガラスになりますので、大きさや厚みによって一人で持ち運びできない場合もありますのでご注意下さい。
ガラスの断面を見ると、黄色みがかったガラスが、透明のガラスにサンドされている様子がわかります。こうして透明ガラスにしっかりと守られているから、普通のガラスと同じように簡単に掃除が可能になっています。
-
鉛ガラス(放射線遮蔽ガラス)の最大サイズは?

鉛ガラス(放射線遮蔽ガラス)の製造可能な面積は、1.6㎡以下となっています。
例えば1000ミリ × 1600ミリ = 1.6㎡ですので製造可能となります。
ただし、厚みによっては、更に大きなサイズでの制作も可能になります。別途ご相談下さい。
-
鉛ガラス(放射線遮蔽ガラス)は、どんな所に使われていますか?
放射線遮蔽用鉛ガラスは、滅菌消毒が必要なX線撮影室の操作室の窓、血管撮影室等の薬品が飛び散りやすい撮影室の窓などに使われています。
このガラスがレントゲン室の操作室の窓として使われる事で病院で働く方の被爆を防いだりと放射線技師さんが働く上でとても重要な働きをしているガラスといえるでしょう。
また、合わせガラスになっていますので、万が一割れても破片が飛び散ることはありませんので、頻繁に人が出入りする、扉の窓などにも使えます。
普通のガラス同様、水拭きやガラスクリーナーなどでのお掃除が可能になりました、従来の鉛ガラスとは違い気軽にお掃除していただけますよ。
-
ネオセラムの比熱は?
ネオセラムの比熱は、下記の図の通りです。
-
ネオセラムの熱伝導率は?
ネオセラムの熱伝導率は、下記の図の通りです。
-
ネオセラムの特性は?
ネオセラムの各特性は、下記の表の通りです。
-
鉛フリー放射線遮蔽ガラスのX線遮蔽性能は?
X線管電圧(kV) LFX-9のX線透過率(%) 鉛当量(mmPb) 50 0.04 0.5 80 1.75 ●IEC1331-1,1994に基づく測定結果
※30kVでのX線透過率の測定も行いましたが、バックグラウンド以下の値しか検出できませんでした。30kVのX線は完全に遮蔽できていると考えられます。
LXX-9というのは、鉛フリー放射線遮蔽ガラスの商品名です。製造メーカは、日本電気硝子株式会社さんになります。原材料に鉛を使用していませんが、鉛に代わるストロンチウム、バリウムなどを使用することでX線遮蔽性能を高めています。
上の表は、鉛フリー放射線遮蔽ガラスを用いた実験結果です。9ミリという厚みで鉛当量0.5mmPbで更にX線管電圧50kv80kvでX線をかなり遮蔽できていることがわかります。
-
鉛フリー放射線遮蔽ガラスを鉛ガラス含鉛アクリルと比べると?
LFX-9 LX-57B 含鉛アクリル モース硬度 6.5 6 3 可視光透過率(%) 85 86 75以上※ 比重 2.7 4.4 1.6 ※板厚12ミリ(鉛当量0.5mmPb)の場合
モース硬度とは?
硬さをあらわしています。あるものでひっかいたときの傷の着きにくさで数字の1~10をつかってあらわします。1に近いほど柔らかく、10に近いほど硬い物質となります。比重とは?
物質の密度をあらわしています。比重1より小さい物は水に浮き、比重1より大きい物は水に沈みます。
上の表からもわかるように、鉛フリー放射線遮蔽ガラスは鉛ガラスや含鉛ガラスに比べて、ガラス表面も硬く傷がつきにくい、さらに比重も軽く可視光線の透過もほぼ鉛ガラスと一緒です。
-
ネオセラムの透過率は?
ネオセラムの透過率は、下記の図の通りです。
-
ガラスのことならオーダーガラス板.COM 鉛フリー放射線遮蔽ガラスとは、どんな所に使われていますか?
比較的放射線の弱いマンモグラフィの機器の側で衝立の一部として使われています。
最近では、乳ガンの早期発見の為マンモグラフィの受診者増えています。法律が改正されて医療従事者が撮影室内で機器を操作することが可能になりました。この改正により作業がしやすく時間の短縮になりました、また痛みを伴う受診者への負担軽減され安心感へつながっています。
しかし、医療従事者にとっては、放射線の被曝の可能性が高くなったともいえます。
そこで日々の診療を行う医療従事者を守るために、放射線の被曝を軽減し、視認性が得られる放射線遮蔽ガラスが使われています。従来の鉛ガラスは黄色でしたが、着色と傷の付きやすさを解消し視認性の高いガラスとなり、作業効率も高くなっています。
-
ネオセラムの熱膨張率は?
ネオセラムの熱膨張率は、下記の図の通りです。
-
ネオセラムの耐熱温度は何℃ですか?
常用使用温度・最高使用温度とは ?
最高使用温度は、短時間のみ使用できる温度で、一瞬であれば、この温度まで耐えることが出来ます。また、常用使用温度は、連続して使用することが出来る温度で、この温度までであれば、連続して過熱しても大丈夫だといえる温度です。 -
ラコベル とは

ラコベルは AGC(株)が販売する、装飾用のカラーガラス(塗装ガラス)です。
欧州の色彩センスを取り入れたカラーバリエーションが展開されています。
高透過ガラス仕様は4種類

AGL-110
ピュアホワイト
AGL-120
パールホワイト
AGL-130
リッチアルミニウム
AGL-150
スターライトブラック透明ガラス仕様は9種類

AGL-160
アンスラサイトオーセンティック
AGL-170
シャドーブルー
AGL-190
ナチュラルブラウン
AGL-200
クラシックブラック
AGL-210
ライトベージュ
AGL-230
ソフトホワイト
AGL-250
クラシックレッド
AGL-260
メタルグレー
AGL-270
アイスホワイト -
ネオセラムの厚みの種類や製作できる最大サイズはどのくらいですか?
ネオセラム(700℃タイプ)の厚みの種類と最大製作可能サイズは、以下の通りです。
厚み サイズ 3ミリ 60センチ × 80センチまで 4ミリ 60センチ × 80センチまで 5ミリ 90センチ × 240センチまで 8ミリ 90センチ × 240センチまで -
高反射カラーガラス(内装用)は自分で加工できる?
はい、ガラスカッターというものを使って簡単に切れます。
厚み10ミリぐらいまでなら簡単に自分でも切断できますので、DIY、日曜大工、 自分で窓ガラスの取替えなどを行う方には扱いやすいガラスと言えます。ガラスの切り方を動画で紹介 !
女性でも簡単に、切ることができます。ステンドグラスなどは、こうしてガラスを切って作られています。ただ、厚みが厚くなるほど切りにくくなります。
ガラスを切った後の切断面で手を切らないように十分ご注意下さい。 ガラスの切り方はとても簡単で、ガラスを切るのを一度見れば、結構すんなりと切れるようになります。
皆さん切り方を知らないだけで、本当に簡単なんです。 ガラスの切り方を動画で紹介するサイトを作りましたので、一度ご覧ください。ガラスの切り方の動画はこちら > ガラスのホームセンター「ギヤマン」
高反射カラーガラスは片面に金属膜がコーティングされています。加工の際は、このコーティングが剥がれてしまわないよう、塗装面ではなくガラス面からカットするのがオススメです。 -
高反射カラーガラス (内装用) とは
ガラスの表面に透明の金属膜をコーティングし、裏面には特殊塗料を焼き付けた内装専用のカラーガラスです。金属膜によるパール調の柔らかな反射効果で、暖かな表情を演出します。
ラインナップ

色は8色 展開されています。
規格
厚み 6ミリのみ 最大サイズ 1829 ミリ × 914 ミリ -
熱移動量(断熱性)はどのくらいですか?
ガラスを通して熱が移動する量 (熱移動量) は、ガラスの熱伝達率に関係します。熱伝達率とは、壁やガラスなどの固体と空気 (気体) の間で、どれくらい熱が伝わるのかということです。
熱伝達率が低ければ熱移動量も少ない、つまり断熱性能が高いということです。
下の図は、室内から室外への熱移動量をガラスの種類別に示したものです。
 フロートガラス単板の場合、熱伝達率が高いため熱移動量大きく、このことから断熱性が低いことが分かります。
フロートガラス単板の場合、熱伝達率が高いため熱移動量大きく、このことから断熱性が低いことが分かります。 ペアガラスは2枚のガラスと中空層によって、熱伝達率が下がります。フロートガラス単板に比べて熱移動量が抑えられ、断熱効果が高くなります。
ペアガラスは2枚のガラスと中空層によって、熱伝達率が下がります。フロートガラス単板に比べて熱移動量が抑えられ、断熱効果が高くなります。 サンバランス (高遮熱断熱タイプ) では、室外側のガラスにLow-E膜をコーティング。これにより熱伝達率が更に抑えられ、高い断熱性能を発揮します。
サンバランス (高遮熱断熱タイプ) では、室外側のガラスにLow-E膜をコーティング。これにより熱伝達率が更に抑えられ、高い断熱性能を発揮します。 サンバランス (高断熱タイプ)は、サンバランス(後者熱断熱タイプ)と違い、室内側のガラスにLow-E膜をコーティングします。断熱効果は高遮熱断熱タイプとほとんど変わりません。
サンバランス (高断熱タイプ)は、サンバランス(後者熱断熱タイプ)と違い、室内側のガラスにLow-E膜をコーティングします。断熱効果は高遮熱断熱タイプとほとんど変わりません。 -
サンバランスにフロートガラス以外を使うことは出来ますか?
はい、可能です。
フロート板ガラスの他に型板ガラスや網入り磨きガラスを使うことができます。
「型板ガラス 霞(かすみ)」は、光を室内に取り込みながら視線を遮ることができます。この型板ガラスは、特に脱衣所やトイレなどに使われることが多いガラスです。ご利用の際は、必ず型板模様の入っている面を水が付着しない側にして下さい。型板模様を室外側にすると汚れが付きやすく、また水の付着によって透けて見えるようになってしまう場合もあります。
網入りガラスは、もし火炎で破損した場合でも、中に封入されている網によって破片の飛び散りを防ぐ効果があります。
サンバランスは、フロート板ガラス以外にも用途に合わせて、ガラスを選ぶことができ便利ですね。
-
サンバランスは家具の色あせを防止できますか?
サンバランスを使うことだけでは、家具の色あせを、なくすことはできません。
家具の色あせの原因は、紫外線だけではありません。可視光線や湿度なども大きく関係があります。しかし、紫外線をカットできれば、色あせの原因も少なくなります。
単板3ミリですと30%しか紫外線をカットしませんが、サンバランスは80%以上の紫外線をカットします。
-
サンバランスが発売されたのはいつですか?
1988年 サンバランス(高断熱タイプ) 発売 1992年 サンバランス(高遮熱断熱タイプ) 発売 その後、複層ガラス用のサッシと共に一般に普及していきました。
-
サンバランスは「エコガラス」ですか?
はい、すべてエコガラスです。 -
サンバランスの代表的な組み合わせは何ですか?
サンバランスを使用した複層ガラスで、代表的な組み合わせは、下記の表の通りです。
住宅用 室外側 中空層 室内側 厚み Low-Eガラス
3ミリ6ミリ フロートガラス
3ミリ12ミリ Low-Eガラス
3ミリ6ミリ 型板ガラス霞
4ミリ13ミリ Low-Eガラス
5ミリ6ミリ 網入りガラス
6.8ミリ15.8ミリ Low-Eガラス
5ミリ6ミリ フロートガラス
5ミリ16ミリ ビル用 室外側 中空層 室内側 厚み Low-Eガラス
6ミリ6ミリ フロートガラス
6ミリ18ミリ Low-Eガラス
6ミリ6ミリ 網入りガラス
6.8ミリ18.8ミリ Low-Eガラス
8ミリ6ミリ フロートガラス
8ミリ22ミリ Low-Eガラス
8ミリ6ミリ 網入りガラス
10ミリ24ミリ -
サンバランスに色バリエーションはありますか?
はい、あります。住宅用、ビル用とそれぞれ紹介いたします。
住宅用 - グリーン
ビル用 - グリーン
- ニュートラルグリーン
- シルバー
- クリア
- ク―ルグリーン
- クールグレー
-
ペアマルチにはにはどんな種類がありますか?
下記の3種です。
- ペアマルチスーパー(高断熱タイプ)
- ペアマルチレイボーグ(遮熱高断熱タイプ)
- ペアマルチLow-E
-
ペアマルチには色のバリエーションがありますか?
はい、あります。
グリーン(熱線吸収板ガラス)
- 反射色調(OUT):グリーン系
- 可視光透過率:67.4%
- 可視光反射率(OUT):11.7%
- 熱貫流率:2.9W/(m2 K)
- 日射熱取得率:0.51

クリア(フロート板ガラス)
- 反射色調(OUT):クリア系
- 可視光透過率:79.1%
- 可視光反射率(OUT):14.5%
- 熱貫流率:2.9W/(m2 K)
- 日射熱取得率:0.74
-
色ガラスには、特殊な性能をもったガラスはありますか?
色ガラスには、デザイン性の優れたカラードアンティークや内装専用カラーガラス 、高反射カラーガラス(内装用) などがあります。色ガラスというと、型板ガラスや塗料を焼き付け加工してあるガラスだけを想像される方もいらっしゃるかもしれませんが、熱線を吸収してくれて、冷暖房コストが抑えられる特殊なガラス「熱線吸収ガラス」もございます。
熱線吸収ガラスとは、熱線の吸収を高める為にガラスの原料に着色をしてあるガラスです。日射を30~40%吸収することによって、冷暖房効果を高め省エネになります。さらに、直射日光を和らげ眩しさを抑えてくれます。色はグリーン、グレー、ブロンスの3種類です。
※原料に着色をしてありますので、厚みが厚くなるほど色が濃くなります。

-
テンパックスの平面度は?
平面度とは、平面の滑らかさを表わす数値の事です。
以下の数値は、テンパックスを3次元測定器を使用して測定した値になります。
(こちらの数値は、実験で行った際に出た参考値で、製品を保証するための数値ではありません。)一片の長さ 平面度 300ミリ 70μm 500ミリ 200μm 1000ミリ 1000μm -
テンパックスの光透過率(全領域)は?
テンパックスの光透過率は下記グラフの通りです。
- 縦軸は透過率 (transmittance:%)
- 横軸は波長 (wavelength:nm)
- グラフ内の数値は板厚 (thickness:mm)を示します。

-
テンパックスの光透過率 (UV領域) は?
テンパックスの紫外線領域(UV領域)の光透過率は下記グラフの通りです。
- 縦軸は透過率 (transmittance:%)
- 横軸は波長 (wavelength:nm)
- グラフ内の数値は板厚 (thickness:mm) を示します。
 「JIS Z 8120」によれば、可視光線として見える範囲は 360nm~400nm の範囲にあるとされており、紫外線はこれよりも小さい波長(短い波長)を指します。
「JIS Z 8120」によれば、可視光線として見える範囲は 360nm~400nm の範囲にあるとされており、紫外線はこれよりも小さい波長(短い波長)を指します。 -
テンパックスの屈折率は?
テンパックスの屈折率は、下記の通りです。
-
テンパックスの波長は?
テンパックス フロートガラスと高透過ガラスの蛍光発光特性の相対強化は、以下の図をご確認ください。
-
テンパックスは特殊ガラスに分類されますか?
-
テンパックスは光学にも使われていますか?
-
テンパックスの厚みの種類や製作できる最大サイズはどのくらいですか?
テンパックスは、厚みにより許容差(公差)と製作可能なサイズが異なります。
※当社の板ガラスの厚みは、JIS規定の範囲内で生産管理されております。厚み 許容差(公差) 製作可能サイズ 0.7ミリ ±0.1ミリ 85センチ×115センチまで 1.1ミリ ±0.1ミリ 85センチ×115センチまで 1.75ミリ ±0.2ミリ 85センチ×115センチまで 2.0ミリ ±0.2ミリ 85センチ×115センチまで 2.75ミリ ±0.2ミリ 85センチ×115センチまで 3.3ミリ ±0.2ミリ 85センチ×115センチまで 3.8ミリ ±0.2ミリ 85センチ×115センチまで 5.0ミリ ±0.2ミリ 170センチ×230センチまで 6.5ミリ ±0.2ミリ 85センチ×115センチまで 8.0ミリ ±0.3ミリ 170センチ×230センチまで 10.2ミリ ±0.3ミリ 85センチ×115センチまで 12.2ミリ ±0.3ミリ 85センチ×115センチまで 13.0ミリ ±0.3ミリ 85センチ×115センチまで 15.0ミリ ±0.3ミリ 85センチ×115センチまで 20.0ミリ ±0.3ミリ 85センチ×115センチまで -
テンパックスはどこで作られていますか?
テンパックスは、ドイツの「ショット社」で製造されています。もちろん、日本にも輸入されていますので国内で購入することも可能です。 -
テンパックスの成分(化学組成)は?
テンパックスの成分(化学組成)は以下の通りです。
- SiO2 (二酸化ケイ素) ……81%
- B2O3 (酸化ホウ酸、無水ホウ酸) ……13%
- Al2O3 (酸化アルミニウム) ……2%
- NA2O および K2O (酸化ナトリウム および 酸化カリウム) ……4%
-
テンパックスの耐熱温度は何℃ですか?
耐熱温度には「最高使用温度」「常陽使用温度」の2種類あります。
テンパックスにおけるそれぞれの値は、以下の表でご確認ください。最高使用温度 常温使用温度 テンパックス 500℃ 450℃ 常用使用温度・最高使用温度とは ?
最高使用温度は、短時間のみ使用できる温度で、一瞬であれば、この温度まで耐えることが出来ます。また、常用使用温度は、連続して使用することが出来る温度で、この温度までであれば、連続して過熱しても大丈夫だといえる温度です。 -
抗菌ガラス(ウイルスクリーン)の最大サイズは?
抗菌ガラス(ウイルスクリーン)の最大サイズは以下の通りです。品種 呼び厚さ 最大寸法 最小寸法 ウイルスクリーン 5ミリ 3,200 × 2,300ミリ - 品種 ガラス構成(ミリ) 呼び厚さ
(ミリ)最大寸法
(ミリ)最小寸法
(ミリ)室外側 中空層 室内側 ウイルスクリーン
(複層ガラスタイプ)FL5 A12 VC5 22ミリ 3,000 × 2,000 350 × 200 FL6 A12 VC5 23ミリ 3,000 × 2,000 PWN A12 VC5 23.8ミリ 3,000 × 2,000 WNA A12 VC5 23.8ミリ 2,415 × 1,729 Low-Eガラス仕様 Low-E5 A12 VC5 22ミリ 3,000 × 2,000 FL……フロートガラス
A……乾燥空気
VC……ウイルスクリーン
PWN……網入りガラス
WNA……網入り型板ガラス
Low-E……Low-Eガラス -
抗菌ガラス(ウイルスクリーン)の使用、メンテナンス上の注意はありますか?
抗菌ガラス(ウイルスクリーン)の使用、メンテナンス上の注意は以下の通りです。
- 清掃する場合、汚れの程度に応じて柔らかいスポンジときれいな水、または中性洗剤で表面の汚れを落とし、きれいな水ですすいでください。
- ウイルスクリーンはカッターナイフ等でコーティング面を擦るとキズが付きますので、ご注意ください。また、スキージーのご使用もお避けください。
- 砥粒を含んだ洗剤や酸、アルカリ度の強い洗剤のご使用はコーティング膜のキズの原因になりますので、絶対にお避けください。
- しっくいやモルタル等は、ガラスの表面に付着し乾燥すると除去が困難になります。薬品を使用して除去しますとコーティング面が侵されますので、付着した場合は乾燥する前に速やかにコーティング面にキズをつけないように中性洗剤でクリーニングしてください。壁面リフォーム等の際にもガラス面の養生は十分に行ってください。
-
抗菌ガラス(ウイルスクリーン)は強化ガラスにすることができますか?
抗菌ガラス(ウイルスクリーン)は強化ガラスにすることができません。 -
抗菌ガラス(ウイルスクリーン)にはどのようなバリエーションがありますか?
抗菌ガラス(ウイルスクリーン)には
- ウイルスクリーン(単板5ミリのみ)
- ウイルスクリーン[複層ガラスタイプ]
- ウイルスクリーン[合わせガラスタイプ]
の3種類があります。
また、合わせガラスタイプには片面のみにウイルスクリーンを使った「片面仕様」と、両面にウイルスクリーンを使った「両面仕様」があります。
-
安全に暮らすために、必要なガラスは?
それはずばり、防犯ガラスです。
一戸建ての家を対象とした空き巣の侵入手段で最も多いのが、ガラスを破って侵入する、ガラス破りです。全体の6割程をしめています。就寝中や留守中の精神的不安を取り除く為には、窓の対策がとても重要になってきます。
ガラス破りは、鍵の周りを破り鍵を開けて窓を開けて侵入すると言われています。
そんな、侵入をあきらめさせるガラスが防犯ガラスです。防犯ガラスは合わせガラスになっています。ガラスとガラスの間に特殊フィルムが圧着されていますので、ガラスが貫通しにくくなっています。
防犯ガラスで高い断熱性と、遮熱性能を兼ね備えているガラス(複層ガラス、Low-e)もあります。是非お問い合わせ下さい。
-
抗菌ガラス(ウイルスクリーン)の透明度は普通のガラスとは違いますか?
 抗菌ガラス(ウイルスクリーン)は普通のガラス(フロート板ガラス)に比べ、透明度はほとんど変わりません。
抗菌ガラス(ウイルスクリーン)は普通のガラス(フロート板ガラス)に比べ、透明度はほとんど変わりません。 -
防犯ガラスは、絶対に割れず、泥棒に入られないですか?
絶対破られない訳ではありませんが、ガラスを切って、手が入る大きさまでガラスを切り開けるのに1枚のガラスよりも時間がかかり、侵入をあきらめさせる効果があります。(ガラスが割れても強靱な特殊中間膜を破るのに時間がかかり、侵入をあきらめさせます。)
また、ガラスをこじ開けようとしてもフィルムに張り付いたガラスとガラスが大きな音をたてます。その為、さらに泥棒に入られにくくなっています。
-
抗菌ガラス(ウイルスクリーン)はどれぐらいウイルス抑制効果がありますか?
抗ウイルス活性試験において、蛍光灯を照射することにより、ウイルスクリーンは60分で活性ウイルス濃度が減少し、優れた抗ウイルス性を発揮することが確認されました。
-
抗菌ガラス(ウイルスクリーン)はどのような菌やウイルスに効果がありますか?
効果のある菌・ウイルス
下記は、実際に効果が確認されている抗菌・抗ウイルスの一例です。
抗菌性 - 大腸菌
- 黄色ブドウ球菌
- 緑膿菌
- レジオネラ
- メチリン耐性黄色ブドウ球菌(MRSA)
- 多剤耐性緑膿菌(MDRP)
- 多剤耐性アシネトバクター(MDRA) など
抗ウイルス性 - インフルエンザウイルス
- ライノウイルス
- ネコカリシウイルス など
抗カビ性 - 黒毬カビ
- カンジタ・アルビカンス など
-
ブラインドグラスの最大サイズは?
ブラインドグラスの最大サイズは、914ミリ × 2438ミリになります。ストライプ模様は、長辺 2438ミリに平行となります。 -
ブラインドグラスの厚みの種類は?
厚みの種類は、5ミリ、8ミリの2種類になります。
両面からフロスト加工をするため、厚みが5ミリからとなっています。
-
ブラインドグラスは、自分で切ることができますか?
 はい、ガラスカッターというものを使って簡単に切れます。
はい、ガラスカッターというものを使って簡単に切れます。
厚み10ミリぐらいまでなら簡単に自分でも切断できますので、DIY、日曜大工、 自分で窓ガラスの取替えなどを行う方には扱いやすいガラスと言えます。ガラスの切り方を動画で紹介 !
女性でも簡単に、切ることができます。ステンドグラスなどは、こうしてガラスを切って作られています。ただ、厚みが厚くなるほど切りにくくなります。
ガラスを切った後の切断面で手を切らないように十分ご注意下さい。 ガラスの切り方はとても簡単で、ガラスを切るのを一度見れば、結構すんなりと切れるようになります。
皆さん切り方を知らないだけで、本当に簡単なんです。 ガラスの切り方を動画で紹介するサイトを作りましたので、一度ご覧ください。ガラスの切り方の動画はこちら > ガラスのホームセンター「ギヤマン」
ブラインドグラスは、両面ストライプ模様になっていますので、どちらの面から切っても大丈夫です。ただし、ストライプ柄に対して平行に切る場合は、フロスト加工されていない箇所を切ってください。また、ストライプ模様に対して垂直に切る場合は、凸凹していますので注意して切って下さい。 -
エコガラスは、自分で切ることができますか?
いいえ、できません。
エコガラスは、Low-eガラスを使った複層ガラスです。複層ガラスと同じように自分では切ったりすることはできません。
乾燥空気が抜けてしまいますし、中のスペーサーのサイズも変わってきます。その為、複層ガラスは、切るのではなくご注文の際に指定サイズをお伝え下さい。
-
エコガラスは、どの位地球温暖化防止に貢献しているのですか?
国内の住宅全ての窓ガラスを全てエコガラスにすると、地球温暖化に影響するCO2排出量を年間約1700万t削減できます。この量は、2003年に日本国内から排出されたCO2の約10%に相当します。
1997年に開かれた、京都議定書にて削減が義務づけられた温室効果ガス(地球温暖化の原因)全体の約23%になります。
-
エコガラスに付いているシールの星の数は、何を意味しますか?
省エネ法第86条に基づいて定められた指針(平成19年経済産業省告示第321号)により、平成20年4月より表示が開始されました。ガラスの省エネ建材等級は、JISの断熱性能区分に基づいて決められています。

省エネ建材等級という区分で等級ごとに、星の数が違っています。
4つ星 : 最高等級
3つ星 : 第2位等級是非、身近な所の複層ガラスを確認して下さい。どこかにこのマークが貼ってあるはずです。
-
電磁波シールドガラスは、自分でも切ることは出来ますか?
いいえ、残念ならできません。電磁波シールドガラスの構造は複層ガラスになています、その為自分で切ったりはできません。中空層の空気が抜けてしまい複層ガラスの機能がなくなってしまうからです。また、中のスペーサーのサイズも変わってきます。その為、電磁波シールガラスは、自分で切るのではなくご注文の際に指定サイズをお伝え下さい。 -
電磁波シールドガラスの厚み種類、最大サイズは?
電磁波シールドガラスは、複層ガラスになっています、ガラスの厚みと、中空層の厚みを選ぶことが可能です。また、製造後の切断はできません、サイズは正確にご注文下さい。
※サッシへのかかりしろは、20ミリ以上確保して下さい。
厚み、サイズは下記の表通りです。ご確認下さい。
厚み(ミリ) ガラスの構成(ミリ) 最大サイズ(ミリ) 18 6 + 中空層6 + 6 2400 × 1700 24 6 + 中空層12 + 6 20 8 + 中空層6 + 6 26 8 + 中空層12 + 6 22 10 + 中空層6 + 6 28 10 + 中空層12 + 6 電磁波をシールドするだけでなく、中空層12ミリの場合、フロートガラスの約4倍、一般的な複層ガラスの約2倍の断熱性能があります。そのためかなり暖房コストが削減でき、エコにつながります。
-
電磁波シールドガラスは、どんな所に使われていますか?
電磁波シールドガラスは、下記のような効果があり、電磁波の通過を制限できます。
- 室内の無線LANの混信防止
- コンピューター室の盗聴防止や誤作動防止
- 病院内のペースメーカー、テレメーター、輸液ポンプなどの医療機器の誤作動防止
-
IHクッキングヒーターのトッププレートに使われている耐熱ガラスはどれ?

主に、ネオセラムが使われています。
ネオセラムは、耐熱衝撃強度、機械的強度に優れているだけでなく、電磁波をよく通すため、IHクッキングヒーターのトッププレートに適しているのです。
-
耐熱ガラスの耐熱温度は?
耐熱温度と言っても、2つの温度があります。最高使用温度・常用使用温度があります。常用使用温度・最高使用温度とは ?
最高使用温度は、短時間のみ使用できる温度で、一瞬であれば、この温度まで耐えることが出来ます。また、常用使用温度は、連続して使用することが出来る温度で、この温度までであれば、連続して過熱しても大丈夫だといえる温度です。最高使用温度 常用使用温度 バイコール 1200℃ 900℃ 石英ガラス 1000℃ 900℃ ネオセラム 800℃ 700℃ パイレックス 490℃ 230℃ テンパックス 500℃ 450℃ -
耐熱強化ガラスは、どんなガラスですか?
耐熱強化ガラスは耐熱性の優れた強化ガラスです。
従来、耐熱強化ガラスには網入りガラスが多く用いられてきましたが、近年網のないワイヤーレスの耐熱強化ガラスも販売されています。
網のないワイヤーレスタイプの耐熱強化ガラスは、開放感のあるすっきりとした視界がえられます。
-
日本板硝子製の耐熱ガラスはある?
日本板硝子は耐熱ガラスを生産していませんが、その他たくさんの種類のガラスを作っている会社です。
-
直火を耐熱ガラスにあてると割れる?
耐熱ガラスでしたら、直火を当てても割れません。しかし、加工してあるものに関しては一概には言えませんので、その商品毎の取り扱い説明書をご覧ください。 -
耐熱ガラスと強化ガラスは違いますか?
-
耐熱ガラスを薪ストーブの窓ガラスに使う場合 500℃タイプでは割れる?
常用使用温度・最高使用温度とは ?
最高使用温度は、短時間のみ使用できる温度で、一瞬であれば、この温度まで耐えることが出来ます。また、常用使用温度は、連続して使用することが出来る温度で、この温度までであれば、連続して過熱しても大丈夫だといえる温度です。 -
耐熱ガラスは通常のガラスと色が違いますか?

普通のガラス 500・1200°Cタイプ 700°Cタイプ 緑がかった透明 ほぼ無色透明 あめ色  耐熱ガラス700℃タイプ(飴色、写真左)と、通常のガラスの色(写真右)を比べてみました。白い紙などの上ではガラスそのものの色が濃く見えてしまいますが、透かしてみればこの程度の違いです。
耐熱ガラス700℃タイプ(飴色、写真左)と、通常のガラスの色(写真右)を比べてみました。白い紙などの上ではガラスそのものの色が濃く見えてしまいますが、透かしてみればこの程度の違いです。 -
耐熱ガラスは強化ガラスにできる?
テンパックスのみ強化加工が可能です。強化加工後は、穴開けや切断などすべての加工が出来なくなりますので、穴あけなどは強化加工前にご依頼下さい。 -
耐熱ガラスがよく利用されているのはどこ?
 薪ストーブのガラスの修理などによく使われます。また、パン釜や工場の釜の覗き窓に使われることも多くあります。
薪ストーブのガラスの修理などによく使われます。また、パン釜や工場の釜の覗き窓に使われることも多くあります。 -
複層ガラスの共鳴透過現象とは何ですか?
複層ガラスにおいては、共鳴透過現象といって低音の遮音率が悪くなります。
簡単に言えば太鼓のような現象です。ガラスが中空層を介して、もう一方のガラスに音を伝えてしまいます。
これは複層ガラスの中空層が乾燥空気(6ミリ)でも、アルゴンガス(12ミリ)でも真空層(0.2ミリ)でも大きな差はないというデータがあります。
音が気になる方は板厚を厚くするのがお薦めです。
断熱も期待される方は、厚いガラスを複層にするのが良いですね。
-
Low-eガラスのLow-eとは、どんな意味ですか?
Low-eガラスのLow-eとは、「Low Emissivity」の略。「Emissivity」は放射率を指し、「Low」と併せて「低放射」という意味になります。
Low-eガラスはペアガラスとして使用され、夏は直射日光による日射熱を緩和して冷房効率を高め、冬は暖房の熱を外部に逃がさないようにして暖房効率を高めることができます。
-
複層ガラスを出入りする熱の割合はどのくらいですか?
窓などの開口部から、どれくらいの熱が出入りするかご存じですか?
壁や天井から熱が逃げ出してしまう事は、快適な家づくりの常識となっていますが、壁や天井よりももっと断熱を必要としている場所があります。その場所は、窓などの開口部です。
開口部の、断熱性を詳しく説明いたしますと。冬に室内から室外へ逃げ出す熱全体の48%、夏に室外から室内へ侵入する日射熱全体の71%が窓などの開口部からの熱となります。この数字は、本当に驚きの数字です。窓を出入りする熱の割合がいかに高いかをあらわしています。
住まいの快適さを向上させ、冷暖房エネルギーとコストの無駄をなくす為には、窓の断熱が非常に大切になります。Low-e ガラスを使った複層ガラスなどといった商品を使う事によって断熱効果が発揮できることと思います。
私も、複層ガラスを自宅に使っていますが、驚きの断熱効果があります。日当たりのよい南側に窓のあるい部屋にはLow-e 複層ガラスを使っています。こうして、部屋によってもガラスを使い分けられます。
-
ペアガラス(複層ガラス)の窓に変えると断熱効果は高まりますか?
窓を複層ガラスに変更することで、断熱効果は高まります。
かつて一般的な窓ガラスによく使われていた「単板ガラス(フロートガラス)」に比べ、かなりの断熱効果があります。ただ、より高い断熱性能を求められる方は、ガラスだけでなくサッシの方も、より断熱性能の高いものを使われることをおすすめします。
サッシも様々で「室内側と室外側のアルミサッシの間に特殊な断熱材を挟んだタイプのもの」や「室内側あるいは室内側と室側側の双方に樹脂を使ったタイプのもの」があります。なかでも樹脂製のものはアルミの1250倍の断熱性能があります。真冬に室内側から樹脂サッシを手で触っても、暖かみを感じることができますよ。
また、より高い断熱性を高めたい場合には、サッシを二重にすることもあります。
複層ガラスをそれらの高断熱サッシと共に使用することで、相乗効果を生むこと間違いなしです。特に冬には暖房効果・保温効果を高めてくれるので大活躍間違いありません。
-
複層ガラス以外の呼称は他にありますか?
複層ガラスには「ペヤグラス」「ペアガラス」「ペヤガラス」などの別名があります。
ペヤグラス、ペアガラス、ペヤガラスは、AGC㈱が商標登録しペアグラスとして商品化されました。現在では、AGC㈱からは、「サンバランス」という商品が、日本板硝子㈱からは、「ペアマルチ」という商品が販売されています。
-
ガラス3枚と中空層2つの複層ガラスは製造可能ですか?

可能です。
ガラス+中空層+ガラス+中空層+ガラスの複層ガラスを作ることができます。
-
複層ガラス(Low-E)の窓の部屋で植物は育ちますか?
はい、問題なく育ちます。
「Low-E複層ガラス」は熱を反射させますが、太陽の光は十分に室内に取り入れることができます。室内の観葉植物の育成などに影響はありません。ご安心ください。
-
ペアガラス(複層ガラス)の「特殊金属膜」とは、何ですか?
「酸化亜鉛(ZnO)」と「銀(Ag)」をコーティングした膜です。
この特殊金属膜によって、夏は板ガラスへ入射した日射エネルギーを室外に反射させ、冬は暖房熱を室内側に反射させています。
このはたらきが、夏は涼しく、冬は暖かい快適な環境をつくります。 -
ペアガラス(複層ガラス)のラベル「エコガラス」とは、何ですか?
エコガラスとは、優れた断熱性能と遮熱性能のある窓ガラスを指し、熱の出入りを防ぎ、室内を快適に保ち、さらに暖冷房の効率をアップ。暖冷房によって発生するCO2排出量を結果的に減らすことができる、ガラスの事です。
エコガラスは、快適な暮らしと環境保護の為にも役立ちます。さらに省エネでお財布にもやさしい、優れたガラスと言えるでしょう。
また、エコガラスは、板硝子協会の会員のAGC㈱、日本板硝子㈱、セントラル硝子㈱の3社が製造するLow-E複層ガラスの共通呼称でもあります。ロゴマークのラベルは、3社のエコガラス商品に貼られています。
-
色ガラスでペアガラス(複層ガラス)は作れますか?
-
デザインガラスでペアガラス(複層ガラス)は作れますか?
-
ペアガラス(複層ガラス)は自分で加工できますか?
残念ながら、ご自身での加工はできません。
複層ガラスへ穴あけなどを行いますと、空気層に封入された乾燥空気や特殊なガスが逃げてしまい、複層ガラスとしての特性を発揮できなくなってしまいます。
穴あけ以外の加工の場合も、複層ガラスの特性を損なう恐れがありますので、ご自身での加工はお控えください。
-
ペアガラス(複層ガラス)は自分で切ることができますか?
ペアガラスをご自身でカットすることはできません。
乾燥空気が抜けてしまいますし、中のスペーサーのサイズも変わってきます。複層ガラスご購入の際は、あらかじめご希望のサイズをご指定の上でご注文下さい。
-
ペアガラス(複層ガラス)の断熱性は普通のガラスよりも高いですか?
ペアガラスは、2枚のガラスの間に断熱性の高い気体(乾燥空気、アルゴンガス他)を閉じ込め断熱層としているため、断熱性においては普通のガラス(フロートガラス)よりも高くなっています。 -
複層ガラスは結露対策になるって本当ですか?
ペアガラスは、窓ガラスの結露対策として非常に効果的です。
さらに、複層ガラス窓のサッシの材質に、アルミ等の金属ではなく、熱を通しにくい木材や樹脂を用いることで、窓全体の対結露効果が上がりますのでオススメです。
-
Low-E複層ガラスと低放射複層ガラスは同じものですか?
Low-E複層ガラスと低放射複層ガラスは同じものです。
Low-E (Low Emissivity)は「低放射」を意味します。
-
Low-e複層ガラスってどんなガラスですか?
Low-eとは、低放射という意味です。
熱は、伝導(熱はガラス内を移動する)や対流、放射(四方八方へ熱が広がる)というかたちで伝わります。伝導、対流は熱の移動を防ぐペアガラスの中間層が受け持っています。
Low-eガラスは、熱の伝わり方の中で最も厄介な放射を押さえます。複層ガラスにすることによってより効果的になります。
-
複層ガラスに合わせガラスを使うと防犯になりますか?
はい、ペアガラスに合わせガラスを使用すると、防犯性能が高くなります。
空き巣の侵入方法で最も多いのが、ガラス破りによるものです。空き巣対策としても合わせ複層ガラスを使うのが効果的です。合わせ複層ガラスは、割ろうと思ってもなかなか割れず、時間がかかるため、侵入をあきらめてしまうのです。
防犯ガラスとして合わせガラスを使った複層ガラスに設置される際は、合わせガラスになっている面を必ず外側(外気面)になるように設置してください。
-
ペアガラス(複層ガラス)はどんな所で使われていますか?
ペアガラスは主に、窓に使われることが多いガラスです。
住宅やビルの窓ガラスの使われ、断熱性がよくなり暖房エネルギーの節約になります。
また、合わせガラスにすることで、遮音効果や防犯効果も付加することができます。
-
ニューステンドの模様のサイズを拡大できますか?
模様の拡大は可能です。ただし、縦横同じ比率で拡大するとは限りません、一度ご確認下さい。
※縦横同倍率も縦横変倍率も可能です。
-
ステンドグラス風装飾ガラス(ニューステンド)の素板に網入り型板ガラスを使うことは可能ですか?
はい、製造可能です。
ニューステンドは内装専用です。外装や高温多湿の場所では使用できません。
-
ステンドグラス風装飾ガラス(ニューステンド)を複層ガラスにすることはできますか?
はい、作れます。
複層ガラス(ペアガラス)にすれば、断熱性を向上させ、部屋の内外の温度差が原因となる結露などを減少させます。
-
ニューステンド(ステンドグラス風装飾ガラス)の表面の、描線を裏面に加工することはできますか?
はい、可能です。ただ、オーダーになります。
ご注文の際に、描線両面とお申し付け下さい。
-
ステンドグラス風装飾ガラス(ニューステンド)は、どんなガラスに装飾してあるのですか?
主に、型板ガラスの霞やミストロンエース、フロートガラスが使われています。
その片側に特殊樹脂で線を描き、カラー樹脂を焼き付けています。
-
ステンドグラス風装飾ガラス(ニューステンド)は、どんな柄があるのですか?
-
ステンドグラス風装飾ガラス(ニューステンド)を 窓ガラスや玄関ドアに使いたいのですが、描画面は家の外側?それとも内側?

基本的に、ニューステンドは内装用のガラスです。
日光に長くあたると、色の劣化を早めることになりますので、外装に使われる際は、描画面を家の内側にすることをオススメします。
ただ、写真のように、日光が直接当たらない場所であれば、大きな影響はありません。
-
ステンドグラス風装飾ガラス(ニューステンド)は、両面とも柄が描いてあるの?
-
ステンドグラス風装飾ガラス(ニューステンド)は、どんなところに使われているのですか?
装飾用の内装の光壁、室内の間仕切り、お店や美容室の店舗、教会やチャペル、住宅の玄関ドアや窓などに使われることが多いです。 -
家のお風呂によく使われるガラスは?

一般的にお風呂の窓や、出入り口のガラスに使われたりするガラスは、右の写真のように、ガラスの片面に模様の入ったガラスが多く使われます。
このガラスは、型板ガラスと言って、ガラスの表面に型の模様があります。このガラスは、特殊性能を持っています。普通のガラスは、透明ですのでもちろん、ガラスの向こうの物が透き通って見えます。この型板ガラスは、普通のガラスと同じくらい光を通しますが、視線は遮ることが出来ます。
お風呂は、視線を遮る必要があります。その為にも、このガラスを使われるお客様が多いです。
-
型板ガラスを曲げること(曲げ加工)はできますか?
はい、曲げガラスにできます。
曲げ加工とは

曲げ加工とは、金属製の型の上にのせた板ガラスを電気やガスを使用した加熱炉の中に入れ、ガラスの軟化温度付近(580~600℃)まで、徐々に加熱する加工。
軟化した板ガラスは、ガラス自身の重みにより金属製の型に沿って曲がります。曲がり終えたガラスは、加熱を止め炉内において熱をさまします。その時同時に熱加工によりガラスに発生した歪み・反りを取り除いてくれます。
-
型板ガラスの各厚みの、最大サイズは?
AGCの製品
品種 厚み(ミリ) 規格最大サイズ(ミリ) 梨地 2 914 × 813 霞 4 2438 × 1829 6 3000 × 2390 日本板硝子(株)
品種 厚み(ミリ) 規格最大サイズ(ミリ) 梨地 2 914 × 813 霞 4 1829 × 1219
1829 × 9146 2438 × 1829 -
サンゴバンマスターガラスとは?

サンゴバンのマスターガラスは、マット調のベースに異なるシンプルで飽きのこない5つの表情をもたせたモダン調のデザインを施したヨーロッパ製のパターンガラスで、9種類あります。
半透明ガラスでありながら、スタイリッシュな模様がデザインされており光をやわらかくコントロールし、表面に加工を施さずに使用できる新しい光の素材です。

-
型板ガラスを脱衣所の窓に使いたいのですか、模様の入っている面は室内側?室外側?
型板模様の入っている面を室内側(水が付着しない側)にして下さい。型板模様を室外側にすると汚れが付きやすく、また水の付着によって透けて見える場合もあります。 -
型板ガラスの模様は、どんなものがありますか?
-
型板ガラスとは

型板ガラスはロールアウト製法によってガラスの片面に型模様をつけたガラスです。
光を通しながら視線を遮りますが、日射透過率などは表面がフラットのガラスとあまり変わりません。
ロールアウト製法とは?
模様付きのロールと模様なしのロールの間にガラスの溶解生地を通して模様をつける製法です。ローラーとローラーの間をガラスが通る為、ガラスに模様がつきます。 -
IMAGIN(イマジン)とは
-
ヨーロピアンガラスとは

-
ラチスグラスとは
-
ステンドグラスは切れますか?

OOKABE GLASSでは「ステンドグラスをカットして、2つのデザインとして使うことはできるのか」というご質問に答えています。ラインアートの他、ニューステンド製品を検討している方は、参考にしてください。
-
ラインアートとは
描線だけで表現する装飾ガラス「ラインアート」
ラインアートは OOKABE GLASS が販売する、ステンドグラス風装飾ガラスです。描線のみで表現されるデザインは、シンプルな手法であるからこその美しさがあります。
特性
- デザイン効果
- 視線制御
ラインアートの利用シーン
- 戸建住宅
- 集合住宅
- オフィスビル
- 店舗・商業施設
-
「マテラック」は、どんなガラスですか?
「マテラック」はAGC(株)から製造・販売されているカラーガラスです。ガラス特有の青みを極限まで抑えた高透過ガラスを使用しており、フロスト加工を施すことであえてツヤを消し、サラリとした高級感を演出します。
ツヤのある通常の磨きガラスと違い、指紋が付きにくい点も特徴的です。
-
「ラコベル ピュアホワイト」は、どんなガラスですか?
-
高透過カラーガラス(内装用)は、自分で加工できる?
はい、ガラスカッターというものを使って簡単に切れます。
厚み10ミリぐらいまでなら簡単に自分でも切断できますので、DIY、日曜大工、 自分で窓ガラスの取替えなどを行う方には扱いやすいガラスと言えます。ガラスの切り方を動画で紹介 !
女性でも簡単に、切ることができます。ステンドグラスなどは、こうしてガラスを切って作られています。ただ、厚みが厚くなるほど切りにくくなります。
ガラスを切った後の切断面で手を切らないように十分ご注意下さい。 ガラスの切り方はとても簡単で、ガラスを切るのを一度見れば、結構すんなりと切れるようになります。
皆さん切り方を知らないだけで、本当に簡単なんです。 ガラスの切り方を動画で紹介するサイトを作りましたので、一度ご覧ください。ガラスの切り方の動画について見る > ガラスのホームセンター「ギヤマン」
高透過カラーガラスは片面が金属膜をコーティングしてあります、反対の面からカットしてください。 -
高透過カラーガラス (内装用)とは

「高透過カラーガラス(内装用)」は、「高透過ガラス」を使用して作られた「カラーガラス」です。AGC(株)から製造・販売されているホワイトガラスなどがあります。
ガラス本来の青みを取り除いた、クリアで透明感あふれる純白のガラスは、この高透過カラーガラスならではと言えるでしょう。
塗装面を内側(室内側)にすれば外装でもご使用いただけますが、その場合ですと内側から塗装面が見えてしまうためおすすめ出来ません。壁面など、塗装面が目に触れないような場面での使用が主流です。
※高透過フロストガラス「マテラックス」は塗装面がない(塗料が塗られていない)為、外装でもご使用いただけます。
「ホワイトガラス」バリエーション

「高透過カラーガラス(内装用)」のラインナップは現在3種。それぞれの特徴は以下の通りです。
商品名 表面 特徴 ラコベル ツヤあり 高透過ガラスにホワイトの塗装 マテラック マット調(ツヤなし) 高透過フロストガラスにホワイトの塗装 マテラックス マット調(ツヤなし) 高透過フロストガラスに塗装なし 規格
商品名 呼び厚さ(ミリ) 規格寸法(ミリ) ラコベル
(ピュアホワイト)5 2438 ×1 829 マテラック 4 2250 × 3210(有効寸法:2190 × 3210) マテラックス 4 廃盤 -
装飾合わせガラスは、どんな所に使われていますか?
装飾合わせガラスは、住宅や店舗の内装や外装、玄関ドアなどに使われています。
装飾フィルムを挟み込んであるため、豊富なバリエーションから選ぶことができます。また、透過性のコントロールもできますので、適度なプライバシー効果もあります。
-
装飾合わせガラスは、自分で切れますか?
いいえ、切れません。
装飾合わせガラスはガラスとガラスの間に特殊フィルムが密着されています。その為片側から切ったのでは切れませんし、両側から切っても切れません。ガラスの切り方は、簡単に説明すると表面にガラスカッターで傷をつけて、傷にそって割るような感じです。
また、合わせガラスは防犯ガラスに使われることが多い為、自分で切る事はできません。
オーダーサイズでのご使用をお勧めいたします。
-
装飾合わせガラスとは、どんなガラスですか?
装飾合わせガラスとは、ガラスとガラスの間に装飾した特殊フィルムを挟んで熱圧着したガラスです。
透過性もコントロールできます。
下記のような特性があります。
- プライバシー効果がある。
- ガラスとガラスの間の特殊フィルムが熱圧着してあるため、万が一割れても破片が飛び散りにくく、破片が脱落しにくくなっています。
- ガラスとガラスの間の柔軟で強靱な特殊フィルムが、衝撃物が貫通しにくくなっています。
※シルバーとゴールドは内装専用となっています。
枠の種類は、16種類になります。

-
カラーラミセーフの厚み種類、最大サイズは?
カラーラミセーフの厚み種類、最大サイズは、下記の表の通りです。
品種(商品名) 素板の呼び厚さの合計(ミリ) 構成素板 ガラスの種類(ミリ) 最大寸法(ミリ) 最小寸法(ミリ) カラーラミセーフ ブラウン
カラーラミセーフ 乳白6 3 + 3 1800 × 1200 300 × 200 8 4 + 4 1800 × 1200 10 5 + 5 2800 × 1200 12 6 + 6 2800 × 1200 16 8 + 8 3500 × 1200 20 10 + 10 3500 × 1200 24 12 + 12 3500 × 1200 30 15 + 15 3500 × 1200 強化カラーラミセーフ ブラウン
強化カラーラミセーフ 乳白8 4 + 4 1800 × 1200 10 5 + 5 2400 × 1200 12 6 + 6 2400 × 1200 16 8 + 8 2400 × 1200 20 10 + 10 3000 × 1200 24 12 + 12 3400 × 1200 30 15 + 15 3400 × 1200 -
カラーラミセーフは、自分で切れますか?
いいえ、切れません。
カラーラミセーフはガラスとガラスの間に特殊フィルムが密着されています。その為片側から切ったのでは切れませんし、両側から切っても切れません。ガラスの切り方は、簡単に説明すると表面にガラスカッターで傷をつけて、傷にそって割るような感じです。
また、合わせガラスは防犯ガラスに使われることが多い為、自分で切る事はできません。
オーダーサイズでのご使用をお勧めいたします。
-
カラーラミセーフとは
カラーラミセーフは、普通の透明のガラス(フロートガラス)に間に、着色した特殊フィルムを熱圧着した合わせガラスです。
色の種類はは、ブラウン:透視タイプ、乳白色:非透視タイプの2色です。
下記の様な特徴があります。
- 万が一割れても、破片が飛び散りにくい。
- 衝撃物が貫通しにくい。
- 紫外線を99%以上カットします。

-
ラミシャットは、どのようなガラスですか?

「ラミシャット」は、AGCが製造・販売する防音ガラスです。2枚のガラスの間に、防音性能のある特殊フィルムを挟んであります。この防音特殊フィルムにより、外からの騒音や室内の音が漏れる量を減らせます。
特性
- 防音対策
- 安全対策
- 防犯対策
- 紫外線遮蔽
主な使用場所
- 集合住宅
- 病院
バリエーション
ラミシャットには、「ラミシャット30」と「ラミシャット35」の2種類があります。それぞれ厚さや防音効果に違いがあります。
・規格
品種(商品名) 室外側 室内側 呼び厚さ(ミリ) ラミシャット30 FL3 FL3 6 FL3 F3K 6 ラミシャット35 FL4 FL4 8 FL5 PHW6.8 11.8 (表中の表記)
FL:フロートガラス、F3K:型板ガラス霞、PHW:網入り磨き板ガラス・防音効果
ラミシャットの防音効果は「遮音等級」という基準で表されます。これはJIS A 4706-2000に示されたもので、「T-1」から「T-4」の4段階あります。「T-4」が最も防音効果が高いです。ラミシャット30は「T-2」で、ラミシャット35は「T-3」相当の効果があります。
騒音レベルとラミシャットの防音効果

上の図は「ラミシャット30」と「ラミシャット35」が、何デシベルの音を遮断できるのかを示したものです。「30」は約30デシベル、「35」は約35デシベルの音を遮断します。これは大通りに面した家でも、うるささが気にならなくなるレベルと言えます。ただしこれは、ガラスのみ (ラミシャット単体) での数値です。サッシを含めた窓の防音性能を保証するものではありません。
参考:一般社団法人日本サッシ協会「窓の性能とJIS基準について」
最大サイズと最小サイズ
品種(商品名) 最大サイズ(ミリ) 最小サイズ(ミリ) ラミシャット30 2400 × 1580 300 × 200 ラミシャット35 3600 × 1580 -
Premin DC(プレミン ディーシー)とは
「Premin DC (プレミン ディーシー)」は、AGCがニューステンドで培った技術を基に製造する、内装専用装飾ガラスです。ステンドグラスと遜色ないデザインで、室内空間を彩ります。安全性に優れた合わせガラスのタイプもあります。
Premin DCには「片面描線」と「両面描線」があります。片面描線は鉛の描線がガラスの片面のみ、両面描線は両面に引かれていることを意味します。片面描線だと、ガラスを裏側から見たときに少しぼやけた両面描線の場合、ガラスの表面も裏面も同じように見えます。
特性
- デザイン効果
Premin DC(プレミン ディーシー)の利用シーン
- 戸建住宅
- 集合住宅
- オフィスビル
- 店舗・商業施設
-
セラミックプリントガラスを円形加工することはできますか?
はい可能です。セラミックスプリントガラス(セラプリ、セラシルエ)において、円形加工ができます。
但し、φ360以上からの加工となります。
-
セラミックプリントガラスに穴を開けることはできますか?
セラミックスプリントガラスに製造後の穴あけ加工はできません。
但し、熱処理前に加工することは可能ですのです、加工前の発注の際穴あけがあることをお伝えいただければ、穴あけ加工できます。セラミックプリントガラスは、熱強化ガラスの為熱処理後の穴あけをするとガラスが割れてしまいます。
-
セラミックプリントガラス越しに、リモコンを使いたいのですがリモコンの電波を通しますか?
はい、ただプレーン柄(全面ベタ)の場合ですとリモコンからの赤外線を遮ります。ほかの柄ですとリモコン使用可能です。 -
セラミックプリントガラスの耐熱温度は何℃ですか?
常用使用温度・最高使用温度とは ?
最高使用温度は、短時間のみ使用できる温度で、一瞬であれば、この温度まで耐えることが出来ます。また、常用使用温度は、連続して使用することが出来る温度で、この温度までであれば、連続して過熱しても大丈夫だといえる温度です。 -
セラミックプリントガラスは水周り(お風呂やキッチン等)で使えますか?
乾湿を繰り返す場所には使用いただけませんが、合わせガラスにすることにより水回りにも使用できます。ただし、プリントは片面しかしてありませんので、プリント面に水が掛からない状態であればご使用いただけます。 -
セラミックプリントガラスは自分でも切れますか?
セラミックプリントガラスはプリントする際に、熱を加えることで強化され、強化ガラスと同じ性能を持ちます。ガラスカッターでは切ることが出来ません。プリント前に切断することでオーダーサイズを可能にしています。 -
セラミックプリントガラスは強化ガラスだというのは本当ですか?
はい本当です。強化ガラスは普通のガラスに熱処理をすることにより、強化されます。セラミックプリントガラスも、セラミック塗料を定着させるさいに熱処理をするので、同じように強化されます。 -
セラミックプリントガラスを窓ガラスなどの外装に使いたいのですが大丈夫ですか?
プリント面は片側のみですので、プリント面を屋内側にすれば、外装にもご使用いただけます。 -
セラミックプリントガラスのストライプ柄は縦ですか横ですか?指定できますか?
はい、指定できます。
ストライプの柄で長方形のガラスを注文される場合は、ストライプ柄を縦に使うか、横に使うか必ずご指定ください。
-
セラミックプリントは爪などで引っかいたりすると剥がれますか?
セラミックプリントは、とても強固な塗料です。爪で引っかいた程度では剥がれません。鋭利なもので、傷を付けると剥がれるというより、ガラスに傷がついたというイメージになります。ガラスの破損の恐れがありますので、通常のガラス同様取り扱いにはご注意下さい。 -
セラミックプリントはガラスの両面にしてあるのですか?
 片面のみプリントしてあります。テーブルトップ(ガラス天板)などに使う場合は、プリント面を下にして使う場合が多いです。外装に使われる場合は、プリント面を室内側にしてご使用下さい。
片面のみプリントしてあります。テーブルトップ(ガラス天板)などに使う場合は、プリント面を下にして使う場合が多いです。外装に使われる場合は、プリント面を室内側にしてご使用下さい。 -
セラミックプリントガラスを使う際の良い点・注意点は?
塗料を定着させる場合に熱処理を加えることによって、強化ガラスと同等の性能を持ちます。
同じ厚さの普通のガラスと比べて、耐風圧強度、衝撃強度、熱割れ強度に優れます。ただ、常に水があたるようなところには使用できません。注意してください。
-
セラミックプリントガラスの厚みの種類と最大サイズは?
日本では、日本板硝子(株)、AGC(株)の2社が製造しています。
それぞれの明細は下記の通りです。
日本板硝子(株)
製品名 品種 ・構成 色 ・パターン 呼び厚さ (ミリ) 最大受注寸法 (ミリ) 注記 セラシルエ HSタイプ ミストホワイト
サテンホワイト
ホワイト
ブラック
6 3600 × 2000 最小寸法:300 ×2 00
標準パターン(各色)- プレーン
- ライン
※HSタイプはブラック 色を除く3 色とな り ます 。
8 4500 × 2400 10 4500 × 2500 12 強化ガラスタイプ 4 2000 × 1200 5 2400 × 1800 6 3600 × 2000 8 4500 × 2400 10 5000 × 2500 12 15 19 AGC(株)
品種(商品名) 呼び厚さ(ミリ) 最大サイズ 最小サイズ セラプリライト テンパライトタイプ 5 2400 × 1800 350 × 300 6 3000 × 1800 8 3500 × 1800 10 12 15 19 HSライトタイプ 6 3000 × 1800 8 3500 × 1800 10 12 -
フロストガラスを曲げること(曲げ加工)はできますか?
はい、曲げガラスにできます。
曲げ加工とは

曲げ加工とは、金属製の型の上にのせた板ガラスを電気やガスを使用した加熱炉の中に入れ、ガラスの軟化温度付近(580~600℃)まで、徐々に加熱する加工。
軟化した板ガラスは、ガラス自身の重みにより金属製の型に沿って曲がります。曲がり終えたガラスは、加熱を止め炉内において熱をさまします。その時同時に熱加工によりガラスに発生した歪み・反りを取り除いてくれます。
-
フロストガラスの厚みごとの最大サイズは?
AGC(株)の製品
品種 厚み(ミリ) 規格最大サイズ(ミリ) ソフト 5 2438 × 1829 8 プレーン 5 6 8 10 12 日本板硝子(株)
品種 厚み(ミリ) 規格最大サイズ マット 3 1829 × 1219 -
両面にフロスト加工されたガラスはありますか?
はい、あります。
日本板硝子(株)のハイシルエダブルです。模様が描かれている、ガラスになります。チェックアンドチェック、スティッチ、スコット、ボスネット、バイライン、ターミット、モザイクの7種類があります。
-
フロスト加工とタペストリー加工って違うのですか?
いいえ、同じ事です。
サンドブラストしたガラスの表面をフッ酸によって半透明に加工する方法を、フロスト加工またタペストリー加工と呼んでいます。
-
フロストガラスの透過性を下げる為には、どのようにしたらいいですか?
方法としては、サンドブラストを粗めに加工する、サンドブラストを両面に加工する、フィルムを貼るなどがあります。 -
模様の入ったフロストガラスはありますか?
はい、あります。 -
フロストガラスに自分で穴を開けることができますか?
はい、ガラスカッターというものを使って簡単に切れます。
厚み10ミリぐらいまでなら簡単に自分でも切断できますので、DIY、日曜大工、 自分で窓ガラスの取替えなどを行う方には扱いやすいガラスと言えます。
ガラスの切り方を動画で紹介 !
女性でも簡単に、切ることができます。ステンドグラスなどは、こうしてガラスを切って作られています。ただ、厚みが厚くなるほど切りにくくなります。
ガラスを切った後の切断面で手を切らないように十分ご注意下さい。 ガラスの切り方はとても簡単で、ガラスを切るのを一度見れば、結構すんなりと切れるようになります。
皆さん切り方を知らないだけで、本当に簡単なんです。 ガラスの切り方を動画で紹介するサイトを作りましたので、一度ご覧ください。ガラスの切り方の動画はこちら > ガラスのホームセンター「ギヤマン」
-
フロストガラスのフロスト加工をストライプ模様にすることはできますか?
はい、ストライプ模様にできます。
真正面から見ると視線をカットします。斜めから見るとスリット幅とガラス厚の関係からガラスの向こうが透けて見えて、とても開放的です。間仕切り、スクリーンなどに使われています。
-
フロストガラスを強化ガラスにする事はできますか?
-
フロストガラスをダイニングテーブルの上に引くことはできますか?
はい、よくダイニングテーブルの天板として使われています。
ただ、万が一割れたときの事を考えて、割れる危険性のある場所には強化ガラスをお勧めいたします。フロート強化ガラスにすることによって、デザイン性に加えて安全性の両方を持ち合わせています。
-
フロストガラスとすりガラスはどこが違うのですか?
 すりガラスとの見た目は、ほとんど同じですが、右の写真の通り若干フロストガラスのほうが透け具合が多いです。
すりガラスとの見た目は、ほとんど同じですが、右の写真の通り若干フロストガラスのほうが透け具合が多いです。すりガラスとフロストガラスの最大の違いは、手垢がつくか付かないかの違いです。すりガラス(磨りガラス)は、手で触ると手垢がついて、拭いても手垢がとれずとても汚くなるということが弱点でした。
フロストガラスは、磨りガラスのようにサンドブラストすることで、乳白色にするのですが、すりガラスと違い、表面をさらにフッ化水素で化学処理し滑らかにすることで、手垢が付きにくくしたもので、手垢の付きにくいすりガラスと思っていただければいいと思います。
フロストガラスとすりガラスの見分け方は簡単、すりガラスは、水で濡らすと左の写真のように透けるようになります。写真で見てもすりガラスは水垢が酷いのがお分かりいただけると思います。
-
フロストガラスは急激な温度変化に弱いのですか?
-
フロストガラスで、20ミリ以上の厚いガラスは作れないのですか?
19ミリ以上の厚みを必要とする場合、ガラスとガラスを張り合わせる、合わせガラスにすることで、より厚いガラスにすることも可能です。ただし、つるつる面とつるつる面を合わせるため両方の面がザラザラ面になります。(最大の厚みは 19ミリ + 19ミリの38ミリ) -
フロストガラスの厚みの種類はどれだけありますか?
-
フロストガラスで、もっと大きなガラスを作りたいのですが、どうすればいいですか?
特寸(とくすん)と言って、特別なサイズで製作することも可能(工場による)ですので、問い合わせてみてください。分割することでコストを抑えることが出来ます !
ほとんどの方が、ガラスを分割して製作しています。半分ずつ製作して並べて使っています。分割することで、運賃、ガラスの料金などのコストも抑えることが出来ます。
もし大きなガラスを、大きなまま商品をお客様の元へお届けする事となりますと、商品を鉄のパレットにのせて、そのパレットを大型トラックに積み込みし、荷下ろしの際も天井クレーンやフォークリフトでの荷下ろしが必要になります。また、ユニック装備付きの大型トラックでも運搬は可能ですが、いずれにしてもチャーター便となります。 その為、運送コストを減らす為にガラスを分割して購入される方もいらっしゃいます。 -
デザインガラスのフロストガラスはどんな大きさまで作れるのですか?
-
クラッケルとはどんなガラスですか?
クラッケルと呼ばれるガラスは、一般的にアンティーククラックガラスのことを指します。
このガラスは、ガラス職人が製作する手吹きガラスです。その製作の過程でガラスにクラック(ヒビ)をいれ、焼き直して1枚のガラスとしています。ガラスに光が当たったときに、クラックに反射してとてもきれいに輝きます。
-
サンゴバン(saint-goban)とは?
1665年にルイ14世からの特許状によって鏡を作り始めたのが起源という、歴史あるフランスの会社です。
この頃の日本は、徳川家康の没後約50年で、やっと平和が取り戻された頃。サンゴバンの歴史の重さに敬服します。
サンゴバンでは数多くのデザインガラスが作られています。

-
木のテーブルの上にデザインガラスをひくことはできますか?
-
窓ガラスをデザインガラスにすることはできますか?
デザインガラスと言っても、デザイン合わせガラスやステンド風装飾ガラス、フロストガラス、セラミックプリントガラスなどがあります。
しかし、窓にすると言うことは、雨などが直接あたるっことになります。その為外装には、使えないものがあります。デザインあわせガラスやステンド風装飾ガラス、セラミックプリントガラスは、加工してある面を必ず内装としてお使いください。
-
合わせガラスで、デザインガラスを作ることができますか?
はい。合せガラスは2枚のガラスの間に中間膜をくっつけた製品です。その中間膜にいろいろなプリントをしたものがデザイン合わせガラスです。
-
ファイアライトの厚みの種類、最大サイズは?
-
アトッチ とは


「アトッチ」は、既存の窓にLow-Eガラスをそのまま貼り付けることで、Low-Eペアガラスと同等の効果を発揮する後付けガラスです。AGC㈱ が製造・販売し、専門の施工業者によって取り付けが行われます。
このアトッチの登場で、これまで困難だった「ビル窓のペアガラス化」を、短期間で行うことが可能になりました。手軽に断熱性を高め、省エネ効果も獲得した商品です。

アトッチを設置することで、単板ガラスに比べて遮熱性能が2倍弱、断熱性能が4倍近くになります。
バリエーション
アトッチは
- クラシック
- クリア
- クール
の3タイプが展開されています。
-
グレーチングチャンネルとは
「グレーチングチャンネル」は、ガラスをサッシに固定させるゴム性の部材です。略して「グレチャン」と呼ばれます。ガラスの縁にグレチャンを取り付け、それからサッシにはめ込みます。もしグレチャンが無ければ、ガラスとサッシに隙間が空いてガラスが揺れ動いてしまうのです。
ホームペヤEGは、ペアガラスに初めからグレチャンが装着された製品。そのため施工時間が短縮され、かつ安全に作業できます。
さらに、通常ペアガラスは結露で内部に水が溜まることがありますが、ホームペヤEGのグレチャンには水抜き穴があるため、水が溜まっても排水することができます。
下図はホームペアEGに装着される特殊グレチャンの断面図です。

-
ホームペヤEG とは

「ホームペヤEG」は、ガラスの4辺に、PVC (ポリ塩化ビニル) を成形した特殊なグレチャン (グレーチングチャンネル) を使用したペアガラスです。
あらかじめグレチャンが巻かれているので、作業時間が短縮され、運搬・作業中の安全も確保。接合方式のコーナー部で、気密性も高く、グレチャンの下部には水抜き穴もあるため、排水性も良くなっています。
規格
グレチャンの色 ペアガラス層の厚み ブロンズ 12 ~ 30 ミリ ブラック ホワイト シャイングレー ピュアシルバー ナチュラルシルバー -
デューカットⅡS とは

デューカットⅡS(ツーエス)は、特殊なスペーサーを使ったペアガラスです。スペーサーとは、ガラスとガラスの間 (中空層) に設置する部材です (上図参照)。
デューカットⅡSは、北陸や東北、北海道などの寒冷地に対応。断熱性が高く、結露の発生を抑える効果があります。
規格
- 8ミリ
- 10ミリ
- 12ミリ
- 14ミリ
- 15ミリ
- 16ミリ
-
ペアスマート とは

「ペアスマート」は、マンション向けのリフォーム用ペアガラスです。AGC㈱が製造・販売しています。ペアガラスでありながら、単板用のサッシにも取り付けることができるスリムさが特徴です。防火タイプと非防火タイプがあります。
規格
防火タイプ
品種 構成 (ミリ) 呼び厚さ 室外側 中空層 室内側 耐熱強化Low-E仕様 透明 SBQFRA3 Kr4 FR3 10ミリ 不透明 FRMX3 非防火タイプ
品種 構成 (ミリ) 呼び厚さ 室外側 中空層 室内側 熱処理Low-E仕様 透明 SBQPTA3 Kr4 FR3B 10ミリ 不透明 FRMX3B 普通Low-E仕様 透明 SBQ3 FL3 不透明 MX3 SBQFRA…耐熱強化Low-E(アクアグリーン)
SBQPTA…強化Low-E(アクアグリーン)
SBQ…Low-E(アクアグリーン)
Kr…クリプトンガス(気体)
FR…耐熱強化ガラス
FRMX…耐熱強化ガラス(不透明)
FR3B…耐熱強化ガラス(FGマークなし) 3ミリ
FRMX3B…耐熱強化ガラス(不透視、FGマークなし) 3ミリ
FL…フロート板ガラス
MX…不透視ガラス価格
ペアスマートは、グレイジングチャンネル(グレチャン)を付けるかどうかが選べます。あらかじめグレチャンを付けることで、施工時間が短縮されます。なお、価格は2018年4月現在のものです。
※グレイジングチャンネル…ガラスを挿し込む際、サッシに取り付けるゴム状のパーツ。パッキン。
防火タイプ
製品仕様 タイプ グレチャンの有無 参考設計価格
(円/㎡、税抜)耐熱強化Low-E仕様 透明 有 64,000 不透明 無 59,000 透明 有 71,500 不透明 無 66,500 非防火タイプ
製品仕様 タイプ グレチャンの有無 参考設計価格
(円/㎡、税抜)熱処理Low-E仕様 透明 有 56,700 無 51,700 不透明 有 64,200 無 59,200 普通Low-E仕様 透明 有 38,000 無 33,000 不透明 有 45,500 無 40,500 -
真空ガラスに交換する場合サッシ交換も必要?
真空ガラス スペーシアに交換する際、サッシの交換は不要です。現在お使いのサッシにそのままはめ込むことができます。 真空ガラス スペーシア よりも薄いガラスから交換された場合には、ガラスの厚さが増した分、窓の総重量も増加するため、交換前と比べてサッシの動きが重く感じられたり、網戸の開閉が困難になる場合があります。サッシの構造や戸車等が、交換後のガラス重量に耐えられるかどうかを事前にご確認ください。また、現在使用中のサッシや建物の状況によって、スペーシアが装着できない場合もありますので、ご注意ください。
真空ガラス スペーシア よりも薄いガラスから交換された場合には、ガラスの厚さが増した分、窓の総重量も増加するため、交換前と比べてサッシの動きが重く感じられたり、網戸の開閉が困難になる場合があります。サッシの構造や戸車等が、交換後のガラス重量に耐えられるかどうかを事前にご確認ください。また、現在使用中のサッシや建物の状況によって、スペーシアが装着できない場合もありますので、ご注意ください。 -
真空ガラス スペーシア とは
真空ガラス(スペーシア)は、ガラスとガラスの間に真空層を作ることで、単板のフロートガラスの約4倍、一般的な複層ガラスの約2倍の断熱性能を実現した複層ガラス(ペアガラス)です。「日本板硝子株式会社」で製作・販売されています。
-
ペアマルチホームEAとは

「ペヤマルチホームEA」は、元々1枚板だった窓ガラスを、サッシはそのままに「ペアガラス」に変更することができる、アタッチメント付きのガラスです。販売元は「日本板硝子㈱」
冬の暖房効果、夏の冷房効果を高めて快適に過ごすことができる「低放射複層ガラス ペアマルチEA」に、リフォーム専用のアタッチメントが装着されています。これにより、窓枠から交換しなければペアガラスに出来ないと思われている方でも、簡単にペアガラスに変更することが出来るのです。
(2012年12月販売終了)
-
高性能熱線反射ガラスを曲げること(曲げ加工)はできますか?
できません。
「高性能熱線反射ガラス」は、表面にコーティングがしてあります。ガラスを曲げる為には、加熱処理が必要になります。表面のコーティングが熱で溶けてしまいますので曲げる加工はできません。
-
高性能反射ガラスの最大サイズは?
高性能反射ガラスの最大サイズは、下記の表の通りです。
厚み(ミリ) 最大サイズ(ミリ) 6 3600 × 2350 8 3580 × 2350 10 3540 × 2350 12 3540 × 2350 15 3450 × 2250 19 3450 × 2200 -
高性能熱線反射ガラスの、厚みの種類は?
6ミリ、8ミリ、10ミリ、12ミリ、15ミリ、19ミリの6種類になります。 -
高性能熱線反射ガラスは、自分で切ることができますか?
はい、ガラスカッターというものを使って簡単に切れます。
高性能熱線反射ガラスは片面に金属膜加工してあります。もう片面は加工されていません、加工されていない面をカットしてください。金属膜の加工面をカットすると失敗します。※熱線反射ガラスは、輸送中の傷を防ぐために金属膜の加工面に傷防止のフィルムがはってありますので、切断する際はフィルムの貼っていない面からガラスカッターを使って切って下さい。
※フィルムは、ガラスが完全に切れてからカッターを使って切って下さい。
※切断後、傷防止フィルムをはがしてお使い下さい。
※金属膜の加工してある面は、傷が付かないように注意して下さい。 -
ペアプラスの断熱性能は?
 ※熱貫流率(熱伝達率)……熱の逃げやすさ、通しやすさを示す値。熱貫流率の数値が低いほど熱を通しにくい、つまり「断熱性能が高い」ことを意味します。
※熱貫流率(熱伝達率)……熱の逃げやすさ、通しやすさを示す値。熱貫流率の数値が低いほど熱を通しにくい、つまり「断熱性能が高い」ことを意味します。 -
ペヤプラスとは
「ペヤプラス」は、AGCが製造・販売している単板ガラス用のサッシに嵌めることができるペアガラスです。
単板ガラスからペアガラスに交換する場合、通常のペアガラスは幅が広いため既存のサッシに入りません。ペヤプラスはガラスの周辺部にアタッチメントが付いており、これにより既存サッシに嵌めることができます。

単板ガラスからペヤプラスへの交換は
- 単板ガラスをサッシから外す
- ペヤプラスをサッシに嵌める
上記の手順で交換が完了します。
ペヤプラスは、窓をペアガラスに交換したいときに使える、リフォーム用の製品です。
特性
- 遮熱
- 断熱
- 結露対策
- 紫外線遮蔽
- リフォーム対応
主な使用場所
- 戸建住宅
- 集合住宅
- オフィスビル
- 病院・高齢者施設
- 学校
- 幼稚園・保育園
- 工場
-
寒冷地専用複層ガラスは自分で切れますか?
寒冷地専用複層ガラスは残念ながら、自分で切ることはできません。理由は、ガラスとガラスの間の空気層の乾燥空気が抜けてしまいますし、中のスペーサーのサイズも変わってきます。その為、複層ガラスは、切るのではなくご注文の際に指定サイズをお伝え下さい。オーダーサイズで製造可能です。
複層ガラスの全てが切ったり穴を開けたりと加工が出来ません。複層ガラスへの穴あけをしてしまと、空気層の意味がなくなります。また、複層ガラスの特性を損なう恐れがある為、加工はお勧めできません。
オーダーサイズでのご使用をお勧めいたします。
-
防音複層ガラスの防音性能は?
複層ガラスには元々高い遮音性能がありますが、幹線道路、電車、航空機の音などの低音域(周波数125Hz~500Hz程度)の騒音に対しては防音効果を発揮できません。
防音複層ガラスはこの現象を防ぐため開発されたレゾネーターが内蔵されているため、一般的な複層ガラスよりも高い防音性能が期待できます。
-
防音複層ガラス は どんな所に使われていますか?
防音複層ガラスは、高い防音性能、断熱性を持つことからマンションやホテル、特別養護老人ホームの窓などに使われています。
近年、幹線道路や路線に隣接したマンションが増加していて、窓への遮音性能に対するニーズも高まっています。
-
防音複層ガラスとは

防音複層ガラスは、ガラスとガラスの間 (中空層) に「低温域共鳴透過現象」を防止する装置「レゾネーター」が取り付けられている複層ガラスです。
複層ガラスなので断熱性はもちろん、遮音性にも優れています。
低温域共鳴透過現象とは?
複層ガラスはガラスが2枚ある為、中高音域では遮音性が高くなります。
一方、騒音の聞こえやすい低音域では「共鳴透過現象」を起こすため、同じ厚みの単板(1枚ガラス)よりも遮音効果が下がる傾向があります。これを「低音域共鳴透過現象」と呼びます。こうした「低音域共鳴透過現象」は、2枚のガラス同士が中間にある空気層をバネのように介してお互いに共振し、音のエネルギーが伝わりやすくなるために起こります。
「レゾネーター」は、この現象を抑える装置です。
-
寒冷地専用複層ガラスの中空層に、白い粉があります。ゴミですか?
いいえ、ゴミではありません。
中空層の空気の感想を維持するために、スペーサーの中に乾燥剤がはいっています。その乾燥剤の粉です。外部からのチリやホコリではありません。
乾燥剤の粉は、複層ガラスの性能には全く問題ありません。安心してお使い下さい。
-
寒冷地専用複層ガラスとは

寒冷地専用複層ガラスは、寒冷地用に高機能樹脂に乾燥剤を練り込んだ、熱伝導率約1000分の1のスペーサーを使用し製作された 複層ガラスです。
通常の複層ガラスよりも断熱性能が向上しています。それだけでなく、結露のしにくさも特徴的なガラスです。
-
サンバランス トリプルガラスとは

サンバランス トリプルガラスは、サンバランスシリーズのひとつで、Low-Eガラスを2枚、通常のガラスを1枚使用した、トリプル仕様の複層ガラスです。2つの中空層にアルゴンガスを充填することにより、断熱効果を大幅に高めています。
特性
- 遮熱
- 断熱
- 結露対策
- 紫外線遮蔽
主な使用場所
- 戸建住宅
- 集合住宅
規格 (代表例)
品種 室外側 中空層(ミリ) 中間 中空層(ミリ) 室内側 呼び厚さ(ミリ) 遮熱タイプ SBQ3 Ar11 FL3 Ar11 LQ3 31 断熱タイプ SBP3 Ar11 FL3 Ar11 LP3 31 FL : フロート板ガラス Ar : アルゴンガス
SBQ : Low-E (アクアグリーン) LP : Low-E (ピュアクリア) -
サンバランス Eシリーズとは

「サンバランス Eシリーズ」は、AGC㈱から販売されている、中空層の幅が広いペアガラスです。最大で16ミリのスペーサーを採用しています。
また、中空層はアルゴンガス(Ar)で満たしており、より高い断熱・遮熱性能を持ちます。Low-E膜を使用しているので紫外線を遮る効果もあります。
戸建住宅や集合住宅でよく使用されています。
特性
- 遮熱
- 断熱
- 結露対策
- 紫外線対策
主な使用場所
- 戸建住宅
- 集合住宅
規格 (代表例)
品種 室外側 中空層(ミリ) 室内側 呼び厚さ(ミリ) 遮熱タイプ アクアグリーンE SBQ3 Ar16 FL3 22 SBQ4 Ar14 FL4 22 SBQ5 Ar12 FL5 22 断熱タイプ ピュアクリアE FL3 Ar16 LP3 22 FL4 Ar14 LP4 22 FL5 Ar12 LP5 22 FL : フロート板ガラス Ar : アルゴンガス
SBQ : Low-E (アクアグリーン) LP : Low-E (ピュアクリア) -
炉内観察用耐熱ガラスの参考価格は?
炉内観察用耐熱ガラスは、炉内を観察する専用のガラスです。耐熱性が優れているだけでなく、高温の炉内をのぞいても目への疲労が少ない、赤外線(熱線)を90%遮断して、その赤外線の多くを反射するなど、放熱までも軽減してくれる特殊なガラスです。
その為、耐熱ガラスや網入りガラス、防火ガラスなどと比べるとお値段は高くなります。
サイズなどによっても金額は変動しますので、一度お見積もりをご依頼ください。
-
炉内観察用耐熱ガラスの透過率は?
遮光度番号に対する仕様標準値 ( JIS T8141 )
遮光度番号 紫外線透過率(%) 可視光
透過率(%)赤外線透過率(%) 313nm 365nm 最大 ~ 最小 780 ~ 1300nm 1300 ~ 2000nm 2.5 0.0003 6.4 29.1 ~17.8 15 9.6 3 0.0003 2.8 17.8 ~ 8.5 12 8.5 4 0.0003 0.95 ~ 6.4 5.4 5 0.0003 0.3 ~ 3.2 3.2 炉内観察用ガラス「ファイアソフト」の透過率
遮光度番号 紫外線透過率(%) 可視光
透過率(%)赤外線透過率(%) 313nm 365nm 780 ~ 1300nm 1300 ~ 2000nm TYPEⅠ 0.0003 未満 0.57 3.19 2.87 0.02 TYPEⅡ 0.0003 未満 0.75 3.82 10.14 8.73 -
炉内観察用耐熱ガラスとは
 炉内観察用耐熱ガラスは、優れた遮熱性と遮光性を持ち、高温の炉内を肉眼で観察できるように作られた特殊な耐熱ガラスです。ガラスの表面には特殊膜が加工されています。
炉内観察用耐熱ガラスは、優れた遮熱性と遮光性を持ち、高温の炉内を肉眼で観察できるように作られた特殊な耐熱ガラスです。ガラスの表面には特殊膜が加工されています。特徴
- 耐熱ガラスですので、高温での使用が可能です。(300℃・500℃タイプ)
- 可視光線の95%以上を遮断するので、肉眼では見にくい炉内の観察を可能にして、さらに目の疲労も軽減してくれます。
- 赤外線(熱線)の約90%以上を遮断し、その多くを反射させる為ガラスからの放熱を軽減してくれます。
炉内観察用耐熱ガラスの利用シーン
炉内観察用耐熱ガラスは、内部を観察出来るように焼却炉や工業炉などの「のぞき窓」に使われています。
一般的には、通常の 耐熱ガラス を取り付けることが多くあるのぞき穴ですが、その場合、遮光メガネなどで目を保護しなければなりません。また、内部の様子が十分に確認できないなど作業性も悪く、改善が求められていました。
そこで、開発された商品が、炉内観察用耐熱ガラスです。
炉内観察用耐熱ガラスの表面の温度が、300℃のタイプ1、500℃のタイプ2の2種類ありますので、使用場所の温度に合わせたタイプをお選びいただけます。
厚みの種類
厚みの種類は、5ミリのみとなります。
最大サイズ
最大サイズは、420ミリ × 560ミリとなっています。
ガラスを売るときは、規格のサイズ(作り置きガラス)から切り出して販売します。 規格サイズの最大寸法はで、420ミリ × 560ミリ この範囲内であればどんな大きさでも可能です。
-
パイレックスの熱的特性は?
パイレックスの熱的特性は、下記の通りです。
-
パイレックスの紫外線透過率は?
パイレックスの紫外線透過率は、下記の図の通りです。
-
パイレックスの赤外線透過率は?
-
パイレックスは強化ガラスにできますか?
パイレックスは強化ガラスにすることが可能なガラスです。
強化加工を行う事によって、通常のパイレックスより強度(耐圧)、耐熱性(熱衝撃)が2倍程度になります。
最高使用温度 常温使用温度 パイレックス 290℃ 260℃ 常用使用温度・最高使用温度とは ?
最高使用温度は、短時間のみ使用できる温度で、一瞬であれば、この温度まで耐えることが出来ます。また、常用使用温度は、連続して使用することが出来る温度で、この温度までであれば、連続して過熱しても大丈夫だといえる温度です。 -
パイレックスは自分で切ることができますか?
はい、ガラスカッターというものを使って簡単に切れます。
厚み10ミリぐらいまでなら簡単に自分でも切断できますので、DIY、日曜大工、 自分で窓ガラスの取替えなどを行う方には扱いやすいガラスと言えます。ガラスの切り方を動画で紹介 !
女性でも簡単に、切ることができます。ステンドグラスなどは、こうしてガラスを切って作られています。ただ、厚みが厚くなるほど切りにくくなります。
ガラスを切った後の切断面で手を切らないように十分ご注意下さい。 ガラスの切り方はとても簡単で、ガラスを切るのを一度見れば、結構すんなりと切れるようになります。
皆さん切り方を知らないだけで、本当に簡単なんです。 ガラスの切り方を動画で紹介するサイトを作りましたので、一度ご覧ください。ガラスの切り方の動画について見る> ガラスのホームセンター「ギヤマン」
-
パイレックス(耐熱ガラス)とは
パイレックスは、最高使用温度490度の耐熱ガラスです。アメリカのコーニング社で生産・販売されていましたが、現在はメーカー廃盤となっています。
石英ガラスが変形・軟化を起こし始める温度を下げ、なるべく膨張を小さく保つため、酸化ホウ素を加えたものを「珪ホウ酸ガラス」と呼び、その代表が「パイレックスガラス」です。軟化する温度が低いため、ガラス細工が容易なガラスでもあります。
主な使用場所
急加熱、急冷却にも耐えるので理科や化学の実験用の容器・道具として非常に優れています。
実際、パイレックスは理科の実験用のビーカーや、ガラス製理化学機器、ガラスポットなどの耐熱調理器具の材料などに広く用いられています。
-
サンバランスセキュリティーとは
「サンバランス セキュリティー」は、AGC㈱の人気複層ガラス「サンバランス」シリーズのひとつです。遮熱・断熱性能を持つLow-Eガラスと、防犯性能を持つ合わせガラス (ラミセーフセキュリティー) をペアにして、中空層には乾燥空気が封入されています。主に住宅の窓に使われます。
また、サンバランス セキュリティーに使われている合わせガラス「ラミセーフセキュリティー」は、官民合同会議が定める「防犯性能の高い建物部品目録」に該当する製品です。
特性
- 遮熱
- 断熱
- 結露対策
- 紫外線遮蔽
- 安全対策
- 防犯対策
主な使用場所
- 戸建住宅
- 集合住宅
規格 (代表例)
室外側 中空層 室内側合わせガラス 呼び厚さ 中空層側 特殊フィルム 室内側 SBQ3 12ミリ FL3 0.8ミリ FL3 21.8ミリ SBQ3 12ミリ FL3 0.8ミリ FL3 23.8ミリ SBQ3 12ミリ PHW6.8 0.8ミリ FL3 25.6ミリ SBQ…Low-Eガラス
FL…フロートガラス
PHW…網入りガラス -
サンバランス トリプルクールとは

「サンバランス トリプルクール」は、AGC㈱が製造・販売しているLow-Eペアガラスで、主にオフィスビルで使われている製品です。Low-E膜に含まれる銀 (Ag) の層を3層にすることで、通常のLow-Eペアガラスよりも更に高い断熱性と遮熱性を持ちます。
特性
- 遮熱
- 断熱
- 結露対策
- 紫外線遮蔽
主な使用場所
- オフィスビル
規格
室外側 中空層 室内側 呼び厚さ SBN 6ミリ 6ミリ フロートガラス 6ミリ 18ミリ SBN 8ミリ 6ミリ フロートガラス 8ミリ 22ミリ SBN 10ミリ 6ミリ フロートガラス 10ミリ 26ミリ SBN 12ミリ 6ミリ フロートガラス 12ミリ 30ミリ SBN 6ミリ 12ミリ フロートガラス 6ミリ 24ミリ SBN 8ミリ 12ミリ フロートガラス 8ミリ 28ミリ SBN 10ミリ 12ミリ フロートガラス 10ミリ 32ミリ SBN 12ミリ 12ミリ フロートガラス 12ミリ 36ミリ SBN:Low-Eガラス(トリプルクール仕様)
-
すりガラスを曲げること(曲げ加工)はできますか?
はい、曲げガラスにできます。
曲げ加工とは

曲げ加工とは、金属製の型の上にのせた板ガラスを電気やガスを使用した加熱炉の中に入れ、ガラスの軟化温度付近(580~600℃)まで、徐々に加熱する加工。
軟化した板ガラスは、ガラス自身の重みにより金属製の型に沿って曲がります。曲がり終えたガラスは、加熱を止め炉内において熱をさまします。その時同時に熱加工によりガラスに発生した歪み・反りを取り除いてくれます。
-
ぼかし加工したすりガラスはありますか?

はいあります。
ガラスの全面にすり加工してあるのではなく、加工したい部分まで加工をし、加工されていない部分との境目をうっすらぼかしてあるガラスです。レトロなイメージですよ。
和室の冊子にピッタリですし、光を取り入れ、視線をやさしく遮ることができます。ぼかし加工やぼかし山水といって模様を描くこともできます。
和のイメージで、和紙ガラス(和風ガラス)といった商品もあります。
-
すり板ガラスの厚みごとの最大サイズは?
品種 厚み 最大サイズ すり板ガラス 2ミリ 800ミリ × 900ミリ (4kg) 3ミリ 900ミリ × 1800ミリ (12kg) 5ミリ 1200ミリ × 2300ミリ (48kg) -
すりガラスに、シート(フィルム)を貼って破片の飛び散りを防ぐことはできますか?
はい、可能です。
すりガラス専用の飛散防止フィルムを貼ることで、地震対策にもなりガラスの破片の飛び散りを防ぎます。
-
窓にガラスを入れたいのですが、すりガラスを使うことはできますか?
はい、すりガラスを使うことは可能です。外からの視線を優しく遮り、光を採り入れます。
ただ、すり加工された面が水で濡れると透明度が増します。汚れが付着すると取り除きにくい為、浴室や台所での使用は避けてください。 すり加工された面を、室内側にしてお使い下さい。
-
すりガラスの耐熱温度は何℃ですか?
すりガラスの耐熱温度は110℃となっています。
沸騰したお湯(100℃)をかけても割れないということになります。
ただし、110℃以下でも、急激に冷やしたり、冷えたガラスに熱湯をかけるような急激な温度変化では割れてしまいます。
常用使用温度・最高使用温度とは ?
最高使用温度は、短時間のみ使用できる温度で、一瞬であれば、この温度まで耐えることが出来ます。また、常用使用温度は、連続して使用することが出来る温度で、この温度までであれば、連続して過熱しても大丈夫だといえる温度です。
-
すりガラスの厚みは、どんなものがありますか?
はい、ガラスカッターというものを使って簡単に切れます。
厚み10ミリぐらいまでなら簡単に自分でも切断できますので、DIY、日曜大工、 自分で窓ガラスの取替えなどを行う方には扱いやすいガラスと言えます。ガラスの切り方を動画で紹介 !
女性でも簡単に、切ることができます。ステンドグラスなどは、こうしてガラスを切って作られています。ただ、厚みが厚くなるほど切りにくくなります。
ガラスを切った後の切断面で手を切らないように十分ご注意下さい。 ガラスの切り方はとても簡単で、ガラスを切るのを一度見れば、結構すんなりと切れるようになります。
皆さん切り方を知らないだけで、本当に簡単なんです。 ガラスの切り方を動画で紹介するサイトを作りましたので、一度ご覧ください。ガラスの切り方の動画はこちら > ガラスのホームセンター「ギヤマン」
-
すり板ガラスの透過率は、普通のガラス(フロートガラス)に比べて低いのですか?
-
すりガラスとフロストガラス、型板ガラスは違うものですか?
-
すりガラスを使用する際の注意点はありますか?
 すり加工された面が水で濡れると透明度が増します。汚れが付着すると取り除きにくい為、浴室や台所での使用は避けてください。
すり加工された面が水で濡れると透明度が増します。汚れが付着すると取り除きにくい為、浴室や台所での使用は避けてください。 -
すりガラスは、何に使われていますか?
すりガラスは家の中の間仕切りや、建具に使われています。 -
すりガラス(くもりガラス)とは
-
昭和レトロガラスは、自分で切ることができますか?
はい、ガラスカッターというものを使って簡単に切れます。
厚み10ミリぐらいまでなら簡単に自分でも切断できますので、DIY、日曜大工、 自分で窓ガラスの取替えなどを行う方には扱いやすいガラスと言えます。ガラスの切り方を動画で紹介 !
女性でも簡単に、切ることができます。ステンドグラスなどは、こうしてガラスを切って作られています。ただ、厚みが厚くなるほど切りにくくなります。
ガラスを切った後の切断面で手を切らないように十分ご注意下さい。 ガラスの切り方はとても簡単で、ガラスを切るのを一度見れば、結構すんなりと切れるようになります。
皆さん切り方を知らないだけで、本当に簡単なんです。 ガラスの切り方を動画で紹介するサイトを作りましたので、一度ご覧ください。ガラスの切り方の動画について見る > ガラスのホームセンター「ギヤマン」
-
昭和レトロガラスとは

昭和レトロガラスとは、昔ながらの建造物や、建具、家具などに使われているようなガラスのことです。
現在のガラスと違って、手作りのために映像がゆらいで見えます。
ガラス自体にゆらぎのあるガラスで、昔風の建築物や家具にお勧めのガラスです。
-
サンバランス 高断熱タイプとは

室内から屋外への熱移動を抑えた、住宅用の高断熱ペアガラスです。室内側ガラスの中空層に接する面が、Low-E膜でコーティングされています。
夏は日射しが室内に入ることを抑え、冬は暖房の熱が外に出ることを防ぐため、冷暖房の効率が上がります。
またLow-E膜は紫外線も大幅にカットでき、家具や内装の色あせ、劣化の進行をやわらげる効果があります。断熱性も高く、冬場の結露も防止することができます。
特性
- 遮熱
- 断熱
- 結露対策
- 紫外線遮蔽
主な使用場所
- 戸建住宅
- 集合住宅
-
ファイアライトには、どんな種類がありますか?
ファイアライトには、通常のクリアタイプの「ファイアライト ネオ」、型板タイプの「ファイアライト カスミ」、「ファイアライト 梨地」、そして、合わせガラスの「ファイアライトプラス」があります。
-
網がない防火ガラスはありますか?
-
耐火遮熱積層ガラスの厚み、最大サイズは?
厚みは、他のガラスににはない25ミリの一種類です。25ミリの内訳は下記の通りです。
ガラス3ミリ+樹脂+ガラス3ミリ+樹脂+ガラス8ミリ+樹脂+ガラス3ミリ+樹脂+ガラス3ミリの合計25ミリです。何層にも重ねられたガラスと樹脂からも、普通のガラスにはない耐火性、遮熱性を兼ね備えることが、目で見てもわかりますね。
最大サイズは、2570ミリ × 1370ミリとなります。
大きな開口部にも使えそうです。ただし、特殊樹脂を使っていますので、紫外線やや水分の影響で細かい気泡が発生する場合があるますので、屋内で使用して下さい。また、屋内でも40℃を超えないようにして下さい。
ガラスを販売するときは、規格のサイズ (作り置きガラス)から切り出して販売します。規格サイズの最大寸法は2570ミリ × 1370ミリで、この範囲内であればどんな大きさでも可能です。
-
耐火遮熱積層ガラスを曲げたり、穴あけは出来ますか?
いいえ、残念ながら曲げたり、穴あけの加工はできません。
厚みも大変厚く、合わせガラスになっている為穴は開けることができません。また加熱処理を行えませんので、曲げ加工もできなくなっています。(表面温度が40℃を超える場所では、気泡が発生してしまいます。)
-
屋外で耐火遮熱積層ガラスを使うことはできますか?
いいえ、できません。
紫外線や水分の影響で細かい気泡が発生する場合があります、屋内でのみお使い下さい。屋内であっても、使用温度が40度以上を超えないように注意して下さい。
-
耐火遮熱積層ガラスは、自分で切る事ができますか?
いいえ、自分で切ることはできません。
ガラス(3ミリ) +樹脂+ガラス(3ミリ) +樹脂+ガラス(8ミリ) +樹脂+ガラス(3ミリ)+樹脂+ガラス(3ミリ)=総厚25ミリのとても厚みの厚いガラスの構造になっています。何層にも重なり合った、樹脂とガラスを自分で切ることはできません。
ご希望のサイズがお決まりの場合、オーダーサイズでのご注文をお勧めいたします。
-
低膨張防火ガラスのエッジ(縁)の部分の加工は何ですか?
低膨張防火ガラスのエッジ(縁)の部分には、特殊な面取りがしてあります。
また、傷防止用のエッジ保護テープが巻いてあります、はがさずにそのままお使い下さい。エッジに傷がつきますと、防火性が維持できない場合もありますので、傷にご注意下さい。
一度加熱処理されていますので、強化ガラスと同じように傷や、ヒビが入りますと全体が粉々に割れてしまいます。ただ、強化ガラスの用に、破片が細かくはまりません。フロート板ガラスのような破片になります。
-
低膨張防火ガラスに熱線反射タイプはありますか?
熱線反射タイプのご用意が可能です。素板に熱線反射ガラス、高性能熱線反射ガラスを使うことで熱線反射が可能になります。
低膨張防火ガラスの特性でもある、高い耐熱性と透明で網のないガラスと言うことだけではなく、熱線反射ガラスの特性もあわせもったガラスです。表面に金属膜加工されているため、適度な遮光効果と日射による温度の上昇をコントロールしてくれるほか、明るいまま快適な室内環境をつくる事が可能です。日射温度の上昇をおさえられれば、室内の急な温度の上昇を抑えてくれますね。(冷房のコストを抑えることが可能です。)
熱線反射ガラスを使う場合は、クリア色のみとなります。
高性能の熱線反射ガラスは、日中明るい室外から室内がみえにくいハーフミラー効果があります。
-
低膨張防火ガラスの厚みの種類、最大サイズは?
低膨張防火ガラスの厚みは、6ミリ,5ミリのみとなります。
ガラスを販売するときは、規格のサイズ(作り置きガラス)から切り出して販売します。 規格サイズの最大寸法内であればどんな大きさでも可能です。
最大サイズは、下の表の通りです。ご確認下さい。
品種
厚み(ミリ)
最大サイズ(ミリ)
ピラン (特定防火設備用)
6.5 3000 × 2000 ピラン (特定防火設備用) 透明タイプ
6.5 3000 × 2000 ピラン (防火設備用) 熱線反射タイプ
6.5 2400 × 1200 ピラン (防火設備用) 高性能熱線反射タイプ
6.5 2400 × 1200 特定防火設備用には、熱線反射ガラス、高性能熱線反射ガラスを使うことはできませんのでご注意下さい。
-
低膨張防火ガラスに穴あけはできる?
いいえ、できません。
強化ガラスと同じように一度熱処理されているガラスですので穴を開けることはできません。穴を開けると全体にひびがはいって割れてしまいます。
-
低膨張防火ガラスは、自分で切ることができる?
いいえ、できません。
低膨張防火ガラスは、強化ガラスのように一度熱処理されています。その為、穴を開けたり、切ったりすることはできません。切ったり、穴あけするとガラスが割れてしまいます。ご希望のサイズがある場合は、オーダーサイズでの製作をお勧めいたします。
-
ゴリラガラスの板厚、サイズは?
ゴリラガラス1
0.7ミリ〜2ミリまで生産する事が出来ます。
コーニング社が公開している現行標準サイズは、405ミリ × 460ミリになりますが、要望に応じて供給サイズは変更可能となっております。→ 現在メーカー廃盤です。
ゴリラガラス2
0.55ミリ〜2ミリまで生産する事が出来ます。
→ オーダーガラス板.COMでは、0.55ミリと0.7ミリのゴリラガラス2の購入が可能です。供給サイズは要望に応じて変更可能となっております。
→ オーダーガラス板.comでは、10ミリ × 10ミリ~370ミリ × 470ミリのゴリラガラス2の購入が可能です。ゴリラガラス3
オーダーガラス板.COMでは、0.55ミリと0.7ミリのゴリラガラス3の購入が可能です。
供給サイズは要望に応じて変更可能となっております。
→ オーダーガラス板.comでは、10ミリ × 10ミリ~370ミリ × 470ミリのゴリラガラス3の購入が可能です。 -
ゴリラガラスのバージョンとは?
ゴリラガラスのバージョンは1〜3のバージョンがありますが、特に指定がない場合は価格もお手頃で高機能のゴリラガラス3をお勧めいたします。
バージョン名 商品の特徴 ゴリラガラス1 ゴリラガラスの初期型です。現在メーカー廃盤です。 ゴリラガラス2 ゴリラガラス1と同じ強度のままで更に20%薄くなり、触れた際の応答性が改善されました。 ゴリラガラス3 ケミカル強化加工後の加工(カットなど)がしやすくなった。
傷を受けるときにその衝撃を吸収することで損傷部にひびが発生せず、局所的な強度低下を防げる。 -
Dragontrail(ドラゴントレイル)の強さは?
Dragontrailは化学強化加工後、フロートガラス(ソーダライムガラス)の6倍の強度があります。 -
Dragontrail(ドラゴントレイル)の板厚、サイズは?
ドラゴントレイルは0.5ミリ~5ミリまで生産することができます。
ただし、AGCが公開している現行の標準板厚は、0.8ミリ / 1.1ミリになります。(それ以外は特注品扱いとなります。)
→ オーダーガラス板.comでは、0.55ミリ / 0.7ミリ / 0.8ミリ / 1.1ミリ のドラゴントレイルの販売が可能です。
AGCが公開している現行標準最大サイズは、29インチ × 48インチ(736ミリ × 1219ミリ)になりますが、要望に応じて供給サイズは変更可能となっております。
→ オーダーガラス板.comでは、20ミリ × 20ミリ~700ミリ × 700ミリ のドラゴントレイルの販売が可能です。
-
化学強化ガラスのDOL、CSとは何ですか?
化学強化ガラスのDOLとは、ガラスの表面からイオン交換によって化学強化がかかった層の深さを指す値になります。
単位はμm(ミクロン)になります。
化学強化ガラスのCSとは、圧縮応力値(外部から圧縮した際に物体内部で釣り合いを保つために生じる力)になります。
単位はMPa(メガパスカル)になります。
化学強化ガラスは、このDOL、CSの値が共に大きい程、強度が強いとみなされます。 -
ガラスに印刷するにはどんな方法がありますか?
まず一つ目の方法は、ガラス表面にセラミック塗料を印刷し、熱処理して加工します。印刷した模様は熱などで剥がれる心配はありません。
二つ目の方法として、2枚の合わせガラスの間に印刷したものを中間膜として挟み入れます。ガラスの間に模様が入れてあるため、こちらも剥がれたりすることはありません。
-
化学強化ガラスは、自分で穴あけすることが可能ですか?

はい、サークルカッターというものを使って穴を開ける事が出来ます。
ただ、丸く切るだけでは絶対に失敗します。正しい順序で、あわてずにコツコツ粉々にしていくのがコツです。小さい穴につきましては、ガラスドリルを使って簡単に穴あけすることができます。
ガラスの切り方を動画で紹介 !
普通の強化ガラス(一度熱処理されて冷風強化されたガラス)は、強化加工後は切ることも、穴を開けることも出来ませんでしたが、化学強化ガラスは穴開け、切断とも可能なガラスです。
ガラスの切り方の動画はこちら > ガラスのホームセンター「ギヤマン」
-
化学強化されたガラスの割れ方は?
化学強化されたガラスは、なんと普通のガラスと同じように放射状に割れます。これは、本当にビックリです。
普通の強化ガラス(一度熱処理されて冷風強化されたガラス)は、粒状に細かく割れ安全性もたかいのですが、化学強化されたガラスは普通のガラス戸同じように放射状に割れます。手が切れてしまうほど、鋭く割れてしまいますので、ご注意下さい。
強度は、普通の強化ガラス(一度熱処理され、冷風強化されたガラス)に比べて、2倍になります。万が一割れたときの事を考えてしまえば、破片は心配ですが強度は非常に優れたガラスと呼べます。
-
ケミカル強化ガラスは、自分で切ることができますか?
はい、ケミカル強化ガラスはガラスカッターで、切ることができます。 ただし、通常のガラスに比べ切りにくいため、個人での切断はお勧め致しません。また、切断面は強化ガラスでは無くなりますのでご注意下さい! -
化学強化可能なガラスの厚み、最大サイズは?
ケミカル強化加工できるガラスの厚みは、0.5ミリ~となります。しかし、ケミカル強化ガラスは、使用用途からもあまり厚みの厚い物はあまり作られません。
最大サイズは、厚みによりますが、1000ミリ × 1200ミリです。大きな強化ガラスを作ることができますね!
ほとんど歪みもなく反りもなく仕上がります。一度熱処理されて、冷風強化されたガラスよりも、2倍の強度があります。
その特徴から複写機用原稿台のガラス、スキャナー用ガラス、航空機用の風防ガラス、電子レンジ用ドアのガラス、タッチパネル、電磁調理器用のガラスなどとして使われています。
-
倍強度ガラスの厚みの種類、最大サイズは?
ガラスを販売するときは、規格のサイズ(作り置きガラス)から切り出して販売します。 規格サイズの最大寸法内あればどんな大きさでも可能です。
倍強度ガラスは、フロート板ガラス、熱線吸収板ガラス、熱線反射板ガラス、高性能熱線反射板ガラスを素板に作ることが可能です。
それぞれの厚み、最大サイズを表にしました、ご確認下さい。
基板 厚み(ミリ) 最大サイズ(ミリ) フロート板ガラス 6 3000 × 2440 8 3600 × 2440 10 12 熱線吸収板ガラス 6 3000 × 2200 8 3600 × 2200 12 熱線反射板ガラス 6 3600 × 2500 8 3580 × 2460 10 3540 × 2420 12 3540 × 2420 高性能熱線反射板ガラス 6 3500 × 2350 8 10 12 -
倍強度ガラスは、どんなガラスからでも作れるの?
ゆがみについての注意
倍強度ガラスは、製造過程で熱処理加工していますので、その為どうしても反りが発生してしまいます、反射映像はフロート板ガラスと同じようにはならず、ゆがみが大きくなってしまいます。また、合わせガラスにもできますが、ガラスごしに透けて見える像はゆがんでみえることもあります。製造不可なガラス(素板)もあります!
製造できないガラスは、網入り板ガラス、線入り板ガラス、型板ガラスは倍強度ガラスにすることはできませんのでご注意下さい。 -
倍強度ガラスは、自分で切ることができますか?
いいえ、できません。
倍強度ガラスは切れません。工場でも切断してから強化に加工しています。(普通のガラスを切断し、熱して倍強度ガラスにしています)
強化ガラスと同じように、一度熱処理加工されたガラスです。その為、工場でも切ることはできません。傷が入ると全体が割れてしまいます。その為、切ったり、穴あけしたりすることはできません。
熱処理前に、オーダーサイズにカットしてその後熱処理加工しています。
-
倍強度ガラスは、同じ厚みの強化ガラスの倍の強度があるのですか?
いいえ、違います。
同じ厚さのフロートガラスに比べて耐風圧強度、熱割れ強度が約2倍程度優れたガラスです。
熱割れの可能性の高いガラス壁材として使われる場合もあります。
-
テンパライトの各厚みの最大サイズは?
一般名 品種(商品名) 呼び厚さ(ミリ) 最大サイズ(ミリ) 最小サイズ(ミリ) 強化ガラス テンパライト(透明) 4 2000 × 1200 250 × 100 5 2400 × 1800 6 3600 × 2440 8 4500 × 2440 10 12 15 19 熱線吸収テンパライト 5 2400 × 1800 6 3600 × 2200 8 サンカットΣテンパライト(クリア) 6 3600 × 2400 900 × 600 7 3580 × 2400 10 3540 × 2400 サンカットΣテンパライト(ユーログレー、ユーロブロンズ、グリーン) 6 3600 × 2082 8 3580 × 2082 サンルックステンパライト 6 3600 × 2400 8 3580 × 2400 型板強化ガラス ミストロンエース 4 2000 × 1200 250 × 100 -
強化ガラスを曲げること(曲げ加工)はできますか?
強化ガラスへの曲げ加工は可能です。
曲げ加工とは?

曲げ加工とは、金属製の型の上に板ガラスをのせて、電気やガスを使用した加熱炉の中に入れ、ガラスの軟化温度付近(580~600℃)まで、徐々に加熱します。
軟化した板ガラスは、ガラス自身の重みにより金属製の型に沿って曲がります。曲がり終えたガラスは、加熱を止め炉内において熱をさまします。その時同時に熱加工によりガラスに発生した歪み・反りを取り除いてくれます。
-
強化ガラスに「フロスト加工」はできますか?
できません。強化ガラスにフロスト加工をすると割れてしまうためです。厚み5ミリ以上のフロストガラスを強化ガラスにすることは可能です。
フロスト加工は、フロートガラスの片面をサンドブラストとし、さらに化学処理した半透明にする加工です。見た目はすりガラスのような乳白色のガラスになります。
強化ガラスは、熱処理をして冷風でガラスを冷やして作られる過程で、表面に圧縮応力、内部にはそれに見合う引っ張り応力を持ち合わせます。これらの力で衝撃に対する強度を増しています。内部と外部の応力のバランス・均衡がとれているため、ガラス自身の強度が高くなっています。
強化ガラスにフロスト加工(傷をつけて割る)をすると、応力のバランスを崩してしまうことになり、一瞬にしてガラス全体が粒状に割れてしまいます。強化ガラスを切ることができないのと同じ原理です。
強化ガラスに加工をするのではなく、もともとのガラスに強化加工をするのがポイントです。
-
防犯には「強化ガラス」「合わせガラス」のどちらが良いですか?
防犯目的であれば「強化ガラス」ではなく「防犯ガラス」を使ってください。これらの2つのガラスは全く違う性質を持っているので、使用用途も異なります。
強化ガラスは、自動車の脱出用のハンマーなど尖ったもので叩くと割れる特徴があるので、防犯性はないと思ってください。泥棒が尖ったものを持っていれば簡単に侵入できてしまいますし、強化ガラスは通常のガラスと違い、割れたときに鋭利な破片が出ずに粉々になり安全なので、ケガすることなく安心して侵入させてしまいます。
一方の「防犯ガラス」は、ガラスとガラスの間に特殊フィルムが挟み込んである「合わせガラス」と呼ばれるガラスの一種です。特殊フィルムには防犯に特化したものがあり、防犯ガラスのほうが格段と泥棒の侵入を防げます。
ガラスの種類 特徴 強化ガラス 1枚の単板ガラス
尖ったもので叩くと割れるため防犯効果はない防犯ガラス 2枚のガラスを、その間に「中間膜」という透明のフィルムを挟んだ「合わせガラス」の一種
防犯に特化したフィルムで防犯性能に優れる -
強化ガラスで、白板はできますか?
可能です。ただし、気泡が多い商品ですので、用途によっては使えない場合があります。
※ 白板は、材料の化学的純度を高めて透明性を増したガラス。一般的には、大型の液晶パネル、測量計、コピー機のカバーガラスなどに使われています。
-
室内の扉でよく見るガラス製の扉は「強化ガラス」ですか?
見た目では強化ガラスか通常のガラスかは、判断しにくいですが、強化ガラスのほうが安全面で断然優れていて、扉には適しています。ガラス扉を検討されている場合には、当社は強化ガラスが推しです。
-
パイレックス強化ガラスとは、どんなガラスですか?
通常の、パイレックスガラス(耐熱ガラス)に熱処理をし、強化したガラスです。
強化板にすることによって、パイレックス板ガラスの強度(耐圧)及び耐熱性(熱衝撃)が2倍程度あります。
最高使用温度 : 290℃
常用使用温度 : 260℃ になります。常用使用温度・最高使用温度とは ?
最高使用温度は、短時間のみ使用できる温度で、一瞬であれば、この温度まで耐えることが出来ます。また、常用使用温度は、連続して使用することが出来る温度で、この温度までであれば、連続して過熱しても大丈夫だといえる温度です。 -
強化ガラスは、どのように作られていますか?
簡単に言うと、板ガラスを熱処理加工し、強化したガラスです。
板ガラスを強化炉にいれ、ガラスの軟らかくなる温度(軟化温度650~700℃)まで加熱した後、ガラス両面に常温の空気をひととおり吹き付けて急冷し、できたガラスです。
軟化温度まで過熱したガラスを急冷する効果は?
急冷することにより、表面が内部より先に固まり、安定した圧縮応力層(→←表面は縮まり)、内部にはそれに釣り合う引張応力層(←→内部は膨張しようとする)が作られ、これらの応力は互いにバランスがつり合った状態に、保たれています
強化ガラスは、表面の圧縮応力の効果でガラスを破損しようとする、外力に耐え、同じ厚さのフロート板ガラスに比べて、3倍以上の強度を持っています。
-
購入したダイニングテーブルの寸法に合わせて強化ガラスのテーブルトップを作ることはできますか?

可能です。楕円形、円形、正方形、四角形など、強化ガラスはテーブルの形状に合わせて縦・横のサイズをミリ単位で調整して製作できる製品です。
テーブルの天板のうえにガラスを敷くことで、机に傷がつきにくくなります。ガラスの下に薄い物を挟みこんで、テーブルをオシャレに飾ることもできます。
強化ガラスがテーブルにオススメな理由は、万が一割れたとしても粒状に割れますので安全なためです。
-
強化ガラスの窓が突然「自爆」したのですが「PL法」の対象になりますか?
PL法の対象になります。ただし、責任の保証期間があります。
PL法(製造物責任法)とは
製造物の欠陥により人の生命、身体または財産に被害が生じた場合に、製造業者等が被害者に対して負う損害賠償責任について定めた民事特別法で、全六条からなります。1994年7月公布、1995年7月1日から施行されています。製造業者が出荷してから10年間を超えないこと。ただし、製品自体の欠陥でなく、施工やメンテナンス等サービス行為による場合は従来の「民法」により責任追及がされ、責任期間は20年となっています。
-
木製のダイニングテーブルの上に強化ガラスを敷きたいのですが、ガラスは滑りませんか?

はい、ガラスは重量があるので、めったに滑ることはありません。目安として、例えば1300 × 800ミリ 厚み5ミリのガラスの重さは、約13kgです。
-
ガラスの庇に使われているのは「強化ガラス」ですか?
はい、「強化合わせガラス」です。玄関やショーウィンドウ用などがあります。また、LED内蔵の商品もあり、明るい玄関や店舗、空が見えて空間が広く感じる効果があります。
-
ラックに使われているガラスは「強化ガラス」ですか?

はい、強化ガラスはラック、商品陳列棚などに使われています。
強化ガラスの強度は、通常のガラス(フロートガラス)に比べて3~4倍の強度があり、耐荷重を要するラックや棚などに適しています。万が一割れたとしても、通常のガラスのように鋭利な破片が出るわけではなく、ガラス全体が粒状にわれますので、安全です。
-
強化ガラスは、通常のガラス(フロートガラス)に比べて重いですか?
ガラスの重さはほぼ変わりません。強化ガラスは元々は通常の板ガラス。通常のガラスに熱処理、または化学処理して製造されるので、重量がさほど変わらないです。
-
自宅にガラス扉をつけたい場合は、強化ガラスが良いですか?
はい、万が一に割れたときのことを考えて、扉には強化ガラスをご利用ください。よく見かける場所としては、自動ドア、病院施設などで使われているイメージですか、自宅やその室内でも使用できる製品です。
-
ガラスの表面に型板模様が入った強化ガラスはありますか?
あります。
プライバシーを守る観点から一般の住宅の浴室の窓などに使われることが多く、強化ガラスの特徴の1つである「耐風圧強度」も、同じ厚さのガラスで比較したときに、フロートガラスの約3.5倍、型板ガラスの約5.8倍です。
-
強化合わせガラスとは、どんなガラスですか?
強化合わせガラスは、2枚の強化ガラスの中間に特殊フィルムや、特殊樹脂を接着したガラスのことです。強化ガラスを合わせガラスにすることで、強度が増すだけでなく、万が一割れたとしても、破片が飛び散りにくくなります。 -
ビルや病院などで見るガラスの手摺は「強化ガラス」ですか?

はい、「強化ガラス」または「強化合わせガラス」でできています。
ガラスですので、透明で圧迫感のない視界が開放的です。ガラスとガラスの間に支えが無くても自立できますので、連続してガラスの手摺を設置できます。
-
強化ガラスは自爆(破損)しますか?
稀にガラスの中に存在する不純物や傷が原因となり、不意の破損などを起こすことがあります。
万が一割れるときには、ガラスの表面の力とガラス内部の力のバランスが崩れ、一瞬にしてガラスの全面が細かく粒状に破損します。通常のガラスのように手が切れるような鋭利な破片は出ないので安全です。
不意の破損がおきないような工夫
強化ガラスの製造段階で、「ヒートソーク処理」という、不純物が含まれている強化ガラスを人工的に破壊させる処理を行っています。強化加工後に再加熱処理を実施し、強化ガラスに存在する非常に細かい不純物が含まれていた場合、強制的に破損させる仕組みです。
-
ガラスの棚板を作りたい場合は、強化ガラスが良いですか?

はい、強化ガラスがオススメです。通常のガラス(フロートガラス)でも作れますが、強化ガラスで作ると、厚みの薄いガラスでも重みに耐えられるのがメリットです。
-
ガラスドアに使われているのは「強化ガラス」ですか?

はい、ガラスドアには強化ガラスが使われています。
強化ガラスは、同じ厚みの通常のガラス(フロートガラス)よりも、3.5~4倍の耐風強度を持っています。万が一ガラスが割れたとしても、ガラス全体が粒状に割れますので安全です。特に店舗やオフィスの出入り口などでは、強化ガラスをお使いください。
-
強化ガラスかそうではないか、見分け方はありますか?

「偏光板」を使って見分けることができます。
強化ガラスはガラスの表面に薄い膜があります。この膜に太陽光などが当たると、光が屈折します。偏光版ならこの光の屈折を見ることができるので、強化ガラスと通常のガラスを見分けられます。
強化ガラスかどうかを見分ける手順
太陽が出ている日に、屋外に強化ガラスを持ち、偏光板を通してガラスの角(4箇所)を見ます。
ガラスの4隅の角の見え方 ガラス 虹色 強化ガラス 虹色でない 強化ガラスでない この虹色は非常に見にくいですので、強化ガラスと普通のガラスを偏光板でみて練習してみると良いです。厚みのあるガラスほど光の屈折が多いので、虹色が見やすいです。また、釣りやゴルフなどのレジャーで使われる偏光グラスを使っても同じような効果が得られます。

ちなみに、AGC、日本板硝子、セントラル硝子の強化ガラスのほとんどには、ガラスにシールが貼ってあります。たとえば車のガラス(特にフロントガラス)はメーカーの強化ガラスなので、1度シールを見ていただければ、強化ガラスにはどのようなシールが貼ってあるのか、お分かりいただけます。
-
強化ガラスの耐熱温度は何℃ですか?
強化ガラスの耐熱温度はこちらです。耐熱温度を見るときは「熱にどれくらいさらされるか」で変わってくるので、いくつか温度の指標があります。
常温温度 200℃
短時間のみ使用できる温度(一瞬であれば耐えられる温度)
最高使用温度 200℃
連続して使用することができる温度
熱衝撃強度 約170℃
※ 厚みが5ミリの場合水をかけて急激に冷やしても割れない温度
※ 環境により多少耐熱温度が上下する場合があります
-
ガラスに熱を加えるとどうして強化ガラスになるのですか?
ガラスに熱処理をしてから冷風で冷やすと、ガラスの表面には「圧縮応力」、ガラスの内部にはそれに見合う「引張応力(ひっぱりおうりょく)」が生じます。これらの2つ力が、ガラスの内部・外部とのバランスでガラス自身の強度が高くなる仕組みです。
一方で、ガラスの内部と外部との応力のバランスが崩れてしまうと、一瞬にして粉々に割れる特徴があります。ただし、万が一割れたとしても鋭利な破片は出ず、粉々に砕けるのでケガのリスクが通常のガラスに比べて低いのがメリットです。
-
強化加工とは?
強化加工とは、熱処理をして冷風でガラスを冷やして、表面に圧縮応力が発生します、内部にはそれに見合う引っ張り応力を持ちます。結果として衝撃に対する強度を増しています。内部と外部の応力のバランスがとれているから、ガラス自身の強度が高くなっているのです。ガラスを切る(傷をつけて割る)と言うことは、その応力のバランスを崩してしまうことになり、一瞬にしてガラス全体が粒状に割れてしまうのです!
強化加工前であれば、穴あけ、切断も可能ですので、問い合わせてみてください。
-
20ミリ以上の厚めの強化ガラスは作れますか?
1枚のガラスだけでは、19ミリを超えるガラスは製造できないので、ガラスとガラスを張り合わせる「合わせガラス」という手法で厚みのあるガラスを作り出します。
ガラス同士はフィルムで貼り合わせますが、そのフィルムの性能をこだわれば、防犯性能、防音性能といった機能性も付加できます。
-
強化ガラスの最大サイズ、厚みの種類は?
-
フロートガラスの平面度はどれくらいですか?
以下の数値は、フロートガラスを3次元測定器を使用して測定した値です。一片の長さ 平面度 300ミリ 70μm 500ミリ 200μm 1000ミリ 1000μm ※ 実験で行った際に出た参考値で、製品を保証するための数値ではありません
平面度とは、平面の滑らかさを表わす数値です。
-
フロートガラスの線膨張率はどれくらいですか?
フロートガラスの線膨張率(常温~350℃)は、8.5~9.0×10-6 1/℃です。
線膨張率とは、温度の上昇によって物体の長さが変化する割合のことです。
-
フロートガラスの熱膨張率はどれくらいですか?
フロートガラスの熱膨張率(20-300℃)は、90×10-7 1/℃です。
熱膨張率とは、温度の上昇によって物体の長さや体積が膨張する割合のことです。「熱膨張係数」ともいいます。
-
フロート板ガラスの熱伝達係数とは?
例えば、冬の寒い時期に部屋の中で暖房をつけると、窓ガラスと窓ガラスに接している空気との間で、熱の伝わり方は、一点から四方八方に広がったり、また空気の一部があたためられるとその空気は膨張し、軽くなって上に昇り、温度の低い空気と入れかわります。
このような運動のくり返しで、熱がガラス全体に広く伝わる現象をまとめて「熱伝達」といいます。また、単位温度(1℃)、単位面積(1㎡)ごとに熱伝達する熱量を「熱伝達係数」と呼びます。
-
フロートガラスの誘電率はどれくらいですか?
フロートガラスの周波数が1MHzで測定内温度が20℃の場合の誘電率は、7~7.5Fm−1です。
誘電率とは、物質内で電荷とそれによって与えられる力との関係を示す係数です。
-
フロートガラスの密度はどれくらいですか?
代表的なガラスの密度は下記の通りです。ガラスの種類 ガラスの密度 フロートガラス 2.5t/m3
(2.5g/cm3)耐熱ガラス
(テンパックス)2.2t/m3
(2.2g/cm3)ネオセラム
(N-0)2.51t/m3
(2.51g/cm3)石英ガラス 2.2t/m3
(2.2g/cm3) -
常用使用温度・最高使用温度とは ?
最高使用温度は、短時間のみ使用できる温度で、一瞬であれば、この温度まで耐えることが出来ます。また、常用使用温度は、連続して使用することが出来る温度で、この温度までであれば、連続して過熱しても大丈夫だといえる温度です。 -
フロートガラスの強度は?
フロートガラスは引張りに弱い?

引張りなどに対して、割れにくいガラスはありますが、割れないガラスというものはまだ開発されていません。 ガラスの弱点は破損(割れ)るということです。ただ、割れると言っても引張られる力(引張応力)だけではありません、縮まる力(圧縮応力)が加わりガラスが破損してしまうのです。
安全性を考え、万が一割れた時でも安全なガラスは強化ガラスです。また、耐風圧強度も普通のガラスの約3.5倍~4倍あります。
ガラスの割れ方は図を見て頂くとよくわかると思います。
-
フロートガラスにフィルムを貼ることはできる?
はい、可能です。
例えば、「普通のガラスでは物足りない。窓を曇ったガラスにしたい。」といった場合には「フロストフィルム(乳白)」。また、万一ガラスが割れたときに破片の飛び散りを防ぐ「飛散防止フィルム(透明)」というものもあります。
-
フロートガラスは、自分でも切れる?
はい、ガラスカッターというものを使って簡単に切れます。
厚み10ミリぐらいまでなら簡単に自分でも切断できますので、DIY、日曜大工、 自分で窓ガラスの取替えなどを行う方には扱いやすいガラスと言えます。ガラスの切り方を動画で紹介 !
女性でも簡単に、切ることができます。ステンドグラスなどは、こうしてガラスを切って作られています。ただ、厚みが厚くなるほど切りにくくなります。
ガラスを切った後の切断面で手を切らないように十分ご注意下さい。 ガラスの切り方はとても簡単で、ガラスを切るのを一度見れば、結構すんなりと切れるようになります。
皆さん切り方を知らないだけで、本当に簡単なんです。 ガラスの切り方を動画で紹介するサイトを作りましたので、一度ご覧ください。ガラスの切り方の動画はこちら > ガラスのホームセンター「ギヤマン」
-
合わせガラスとは?

合わせガラスは、ガラス板とガラス板の間に特殊中間膜をはさんで圧着させたガラスです。
この中間膜の効果で、割れても破片が飛び散ることがほとんどないため、一般ガラスと比べて非常に安全性が高くなります。合わせガラスでは、19ミリ+ 19ミリ= 38ミリや15ミリ+15ミリ+ 15ミリ= 45ミリなど組み合わせによって、色々な厚みが製作可能です。
-
フロートガラスで20ミリ以上の厚いガラスは作れる?
-
フロートガラスの厚みの種類は?

一般的によく使用されるガラスなので、厚みの種類は豊富にあります。その規格はJIS R 3202により定められていて、下記の10種類となります。
2ミリ 3ミリ 4ミリ 5ミリ 6ミリ 8ミリ 10ミリ 12ミリ 15ミリ 19ミリ
ガラスの中でも最も基礎となるガラスです。そのため、他の種類のガラスにはこれだけ厚みがたくさんあるものはありません。
-
フロートガラスの各厚みの最大サイズは?
フロートガラスはどんな大きさまで作れる?
最大サイズ(最大寸法)は、ガラス工場の機械の大きさによって変わってきます。 また、厚みが2ミリや3ミリなど薄いガラスは割れやすいため、あまり大きなガラスは作れません。
AGC(株)のフロート板ガラスの最大寸法
厚み
(ミリ)最大サイズ
(ミリ)2 914 × 813 3 3637 × 2520 4 3780 × 2510 5 3780 × 3018 6 6056 × 3008 8 6046 × 2998 10 6046 × 2998 12 6046 × 2948 15 5996 × 2948 19 5946 × 2898 日本板硝子(株)のフロート板ガラスの最大寸法
厚み
(ミリ)最大サイズ
(ミリ)2 914 × 813
1219 × 6103 2540 × 1905 5 3810 × 2540 6 8 7420 × 2720 10 12 8690 × 2720 15 9960 × 2720 19 ガラスを売るときは、規格のサイズ(作り置きガラス)から切り出して販売します。「特寸(とくすん)」といい、特別なサイズで製作することも可能です。
※ どれほどの特寸で製作できるかは工場によります
-
錫(すず)の上に溶かしたガラスをのせて、ガラスは平らにできあがるの?
はい、溶けた錫は完全に滑らかな平面です。その上に熔融ガラスを流しこむと、溶けた錫と熔融ガラスが接する面、熔融ガラスが空気に触れている面ともに凹凸のない完全に平面のガラスができあがります。皆さんも窓ガラスなど触ったことがあると思いますが、歪みのない平らなガラスはこの製法で造られたものです。 -
ガラスの製造方法「フロート方式」とは、何ですか?
現在の板ガラスの代表的な製造方法は、「フロート方式」です。1952年イギリスのピルキントン社が開発し、今では世界中のガラスメーカーに普及しています。
溶かしたガラスをガラスよりも比重の重い錫(すず)の上に浮かべて、ガラスを板状にする方式。様々なガラスが、この製造方法で作られています。
昔のガラス
今から数十年前は、電車のガラスなどにも表面に凹凸のうねりのあるガラスが使われていました。このガラスごしに景色を見ると歪んで見えていました。ガラスの歪みはまだ我慢できますが、当時一番困ったのは、鏡を作るときです。鏡にする為に、わざわざガラスの表面を磨いていたのです。平面のガラスが出来て、ガラスの表面を磨かずに鏡をつくることができたんですね。 -
ガラスの組成(原料)は?
ガラスの代表的な原料は下記の通りです。
原料 割合 ケイ酸 70~74% 石灰 6~12% ソーダ 6~12% マグネシア 0~4% アルミナ 0~2% -
白板とは?
材慮野科学的純度を高めて透明性を増したガラスです。一般的には、大型の液晶パネル、測量計、コピー機のカバーガラスなどに使われています。 -
「フロートガラス」「フロート板ガラス」「青板ガラス」は、違うガラスですか?
同じものです。ガラスは、別名「透明ガラス」「フロート板ガラス」「白板ガラス」「青板ガラス」と呼ばれます。
透明ガラスといっても、1枚だけ見れば透明に見えますが、上の写真のように、重ねたり、厚みのあるものを見ると緑色に見えます。フロートガラスの中に含まれる金属成分が発色し緑色に見えることが「青板ガラス」とも呼ばれる所以です。
本当に透明なガラスは「高透過ガラス」です。
-
火鉢の上にのせるガラスは取り扱っていますか?

はい、火鉢に使えるガラス天板を取り揃えております。
当店では、スタッフがお客様のご用途を伺ってアドバイスしておりますが、これまでのお客様ですと「強化ガラス」でご成約いただくことが多いです。
はい、火鉢に使えるガラス天板を取り揃えております。
当店では、スタッフがお客様のご用途を伺ってアドバイスしておりますが、これまでのお客様ですと「強化ガラス」でご成約いただくことが多いです。

火鉢用にガラス天板を注文されたお客様事例
当店で火鉢用のガラスを注文されたお客様からのお写真です。円形でのご注文が多いですが、四角形のご注文もございます。





-
石臼の上にのせるガラスは取り扱っていますか?

はい、石臼に使えるガラス天板を取り揃えております。これまでのお客様ですと、「強化ガラス」でご成約いただくことが多いです。
形状が似ているものとして、火鉢のガラス天板のご用意もできます。
はい、石臼に使えるガラス天板を取り揃えております。これまでのお客様ですと、「強化ガラス」でご成約いただくことが多いです。
形状が似ているものとして、火鉢のガラス天板のご用意もできます。

-
お店の陳列テーブル用のテーブルマット・テーブルトップのガラス天板はありますか?

はい、ございます。
店舗の商品陳列棚・テーブルにあわせた寸法でガラス天板をご用意できます。
「透明」といっても、「クリア」と、ガラス本来の青みが無い「ハイクリア」の2つございます。
はい、ございます。
店舗の商品陳列棚・テーブルにあわせた寸法でガラス天板をご用意できます。
「透明」といっても、「クリア」と、ガラス本来の青みが無い「ハイクリア」の2つございます。

-
天板を落とし込む円形の机のテーブルマット・テーブルトップのガラス天板はありますか?

はい、ございます。お客様のコーヒーテーブルの寸法に合わせてサイズオーダーできます。
透明のものであれば、当店では「強化ガラス」を推奨しております。
はい、ございます。お客様のコーヒーテーブルの寸法に合わせてサイズオーダーできます。
透明のものであれば、当店では「強化ガラス」を推奨しております。

-
会社の応接室の机のテーブルマット・テーブルトップのガラス天板はありますか?

はい、ございます。お使いの応接室の机の寸法や形状に合わせてオーダーメイドできます。
透明「強化ガラス」が特によく売れています。
はい、ございます。お使いの応接室の机の寸法や形状に合わせてオーダーメイドできます。
透明「強化ガラス」が特によく売れています。

-
コーヒーテーブル用のテーブルマット・テーブルトップのガラス天板はありますか?

はい、ございます。お客様のコーヒーテーブルの寸法に合わせてサイズオーダーできます。
透明のものであれば、当店では「強化ガラス」を推奨しております。
はい、ございます。お客様のコーヒーテーブルの寸法に合わせてサイズオーダーできます。
透明のものであれば、当店では「強化ガラス」を推奨しております。

-
レストランのテーブル用のテーブルマット・テーブルトップのガラス天板はありますか?

はい、ございます。店舗の食事用のテーブルマット・テーブルトップのガラス天板も、当店でご注文が多い用途の1つです。
透明のものであれば、当店では「強化ガラス」を推奨しております。
はい、ございます。店舗の食事用のテーブルマット・テーブルトップのガラス天板も、当店でご注文が多い用途の1つです。
透明のものであれば、当店では「強化ガラス」を推奨しております。

-
テーブルマットのガラス天板は「強化ガラス」が一般的ですか?
通常の透明ガラス「フロートガラス」を注文されるお客様もいらっしゃいますのが、当店でご注文が多いのが、ダイニングテーブルでのご使用。

強化ガラスは、表面の強度だけでなく、耐熱温度が高いガラスです。200℃まで耐えられるため、ガラスの上に鍋を直接置いても割れません。
※ アクリルやビニール、木材では、熱によって傷んでしまうことがあります。

強化ガラスは、表面の強度だけでなく、耐熱温度が高いガラスです。200℃まで耐えられるため、ガラスの上に鍋を直接置いても割れません。
※ アクリルやビニール、木材では、熱によって傷んでしまうことがあります。
-
テーブルマット用のガラスで、「クリア」「ハイクリア」の違いは大きいですか?

ガラスは、完全な透明ではなく、本来少しばかり青みがかっています。
「クリア」は、本来のガラスそのもので、少々青みがあります。
「ハイクリア」は、高透過ガラスが使われており、ガラスが持っている青みを極限にまで無くしたものです。
ガラスは、完全な透明ではなく、本来少しばかり青みがかっています。
「クリア」は、本来のガラスそのもので、少々青みがあります。
「ハイクリア」は、高透過ガラスが使われており、ガラスが持っている青みを極限にまで無くしたものです。

特に、白いテーブルにテーブル天板としてガラスを使いたいお客様にはよく選ばれております。ハイクリアですと、白い机でも青みがない点、喜んでくださるお客様が多いです。
-
型紙を取るときは、模造紙でないとダメですか?
模造紙以外でも、「新聞紙」「カレンダー」など、伸び縮みしない紙を繋ぎ合わせたものでも大丈夫です。
-
テーブルの角が段になっている場合は、型紙をどのように取れば良いですか?

テーブルの角が図のように段になっていて、机の外周よりもひと回り小さいガラステーブルトップを作りたい方には、角を避けて平面になっている範囲で型を取るようにアドバイスしております。
テーブルの角が図のように段になっていて、机の外周よりもひと回り小さいガラステーブルトップを作りたい方には、角を避けて平面になっている範囲で型を取るようにアドバイスしております。

-
「型紙製作セット」は、どのように注文すれば良いですか?
お電話、またはお見積りフォームから「型紙製作セットを注文したいです」とお伝えください。
- お電話:0120-12-4466
- お見積りフォーム
-
テーブルに使う強化ガラスは強度がありそうなので、厚みを5ミリよりも薄くしても大丈夫ですか?
「強化ガラス」は、たしかに強度がありますが、その強度は「耐衝撃」に対するものです。「荷重」に対しては、通常のガラスと同じようにたわむので、推奨するガラスの厚みは、一般的なガラスの考え方と同じで、5ミリ以上推奨です。
-
テーブルトップのガラス天板の厚みの相談をしても良いですか?
もちろんです。使用用途(大体置くもの)やガラスの置き方、サイズなどからオススメのガラスの厚みを計算させていただきます。
「こういう机にこれくらいのサイズのテーブルトップのガラスを検討しているけれど、これくらいの厚みで大丈夫?」といったご相談、お待ちしております。
- お電話:0120-12-4466
- お見積りフォーム
-
ニトリやIKEAのテーブルの天板や、ガラステーブルにはどんなガラスを選べば良いですか?
お客様から当店に非常にご相談が多いお問合せです。
- 「NITORI(株式会社ニトリ)で買ったこの机のテーブルトップのガラスを交換したいのですが、どれを選べば良いですか?」
- 「IKEAのガラステーブルにヒビが入ったのですが、どのガラスか分からないです…」
当店では、透明なガラスであれば、当店では「強化ガラス」を推奨しております。
-
寺院の経机用のガラス天板はありますか?

はい、ございます。ガラスを注文される方、アクリルを注文されるお客様、どちらもおります。
経机用の天板/お客様のご注文例
天板の種類 アクリル(ガラス色) 形状 四角形 サイズ 1200 × 750ミリ
+0ミリ指定で製作厚み 5ミリ 切断面の処理 磨き加工ミガキ「ランクS」 その他の加工 ガラスの角にR100ミリ
4コーナー -
テーブル用のガラス天板に「飛散防止フィルム」を貼る場合の料金はいくらですか?
通常のガラス代金に加えて下記のフィルム代がかかります。
~45
センチ~60
センチ~90
センチ~90
センチ通常13,944円
〜8,400 円
8,400 円通常13,944円
〜8,400 円
8,400 円通常16,384円
〜9,526 円
9,526 円~120
センチ通常13,944円
〜8,400 円
8,400 円通常14,740円
〜8,670 円
8,670 円通常20,655円
〜11,871 円
11,871 円~180
センチ通常13,944円
〜8,400 円
8,400 円通常20,655円
〜11,871 円
11,871 円通常28,000円
〜15,555 円
15,555 円 -
ガラス天板を交換しても、また割れないか、割れたときに破片が飛び散らないか心配です。

強化ガラスの場合は、万が一割れたとしてもガラスの破片が粉々になるため、手を切る心配はありません。
強化ガラス以外のガラスを検討されているお客様には、下記の2つの方法を提案しております。
- 「飛散防止フィルム」を貼ってガラス破片が飛び散らないようにする
- 見た目はガラスで割れない「アクリル」にする
当店の「強化ガラス」の特徴当店の強化ガラスは、ガラスを約300℃まで加熱して不純物を取り除く「ヒートソーク加工」という処理で製造されているので、割れにくい強化ガラスに仕上がっています。
-
どんな形のガラス管や、どんな加工ができますか?

ガラス管を U字型、L字型、T字型に曲げたり、口の部分に丸みをつけることもできます。
用途によって形状や仕上がりのご希望があると思いますので、「ガラス管をこんな形にできないか?」「ガラス管をこういう用途に使いたいんだけど」とご相談ください。
- お電話:0120-12-4466
- お見積りフォーム
-
太いガラス管(ガラスの筒)もありますか?

一般的な仕様のガラス管「CTE33(旧パイレックス管)」、耐熱温度が高い「石英管」ともに太いガラスパイプもご用意しております。
建材などで使われるガラスの筒は、価格の安いCTE33がオススメです。
ガラス管の
種類外径の最大寸法 CTE33
(旧パイレックス管)外径:φ400ミリまで
(内径:φ386ミリまで)石英管 外径:φ230ミリまで
(内径:φ220ミリまで) -
どれくらいの厚みのガラス管を選べば良いか分からないので、アドバイスをもらえませんか?
はい、可能です!お客様がどういった用途でガラス管を検討されているか教えてください。その用途に合ったガラス管がございますので、ガラス管の種類、厚み、長さ、必要な加工をお答えします。
- お電話:0120-12-4466
- お見積りフォーム
-
ガラス管の見積もりをしてほしいのですが、どのように連絡すれば良いですか?
お電話、お見積フォームからご相談を受け付けております。ガラスの料金や加工費を含めた全額をすぐにお見積できますので、お気軽にご連絡ください。
「どういった場所に」「どんな用途で」「どういった寸法」のガラス管を検討しているか、ざっくりで構いませんので、お伝えくださりますとスムーズです。
- お電話:0120-12-4466
- お見積りフォーム
-
ガラス管を切断しただけの場合、手が切れないように面取りはしてありますか?
 ガラス管を切断するのみの場合、切断面がまっすぐになるように「アラズリ加工」という処理をしております。手が切れることはない仕上がりなので、ご安心ください。
ガラス管を切断するのみの場合、切断面がまっすぐになるように「アラズリ加工」という処理をしております。手が切れることはない仕上がりなので、ご安心ください。 -
ガラス管を自分で切ることはできますか?

姉妹店の「ガラスのホームセンター ギヤマン」で販売している「ガラス切断ノコギリ」という工具を使うとカットできます。姉妹店でカート販売しており、砥石や替え刃も購入できます。
-
ガラスの「U字管」「T字管」の溶着部は、どのように見えますか?

まず、「U字管」の接着部分の見え方がこちら。
まず、「U字管」の接着部分の見え方がこちら。


続いて、「T字管」の接着部分の見え方がこちらです。
続いて、「T字管」の接着部分の見え方がこちらです。


2本のガラス管をつなぎ合わせるので、多少つなぎ目が見えますが、お客様にご説明すると、気にされない方が多いです。
- お電話:0120-12-4466
- お見積りフォーム
-
ミニチュアサイズのガラス管に「丸底封じ加工」をすると、どのような見た目になりますか?

管径が5ミリほどの小さな寸法のガラス管で「丸底封じ加工」を行うと、ガラス管の内部は平底に仕上がります。
管径が5ミリほどの小さな寸法のガラス管で「丸底封じ加工」を行うと、ガラス管の内部は平底に仕上がります。


外側 丸く仕上がる 内側 平らになる 外側 丸く仕上がる 内側 平らになる  「丸底封じ加工」について
「丸底封じ加工」について丸底封じ加工は、断面を半球状に閉じる加工です。理化学ガラス用器具としてもよく利用されており、底が丸い形状のため、熱するのに適しており試験管などに使用されることが多い加工です。

ガラス管の底を丸底にしようと検討していて「こんな小さいガラス管でも、丸く仕上がるのかな…」と不安でしたら、ぜひ一度ご連絡くださいね。
- お電話:0120-12-4466
- お見積りフォーム
-
テーブル天板にはフロートガラスよりも強化ガラスの方が良いですか?
割れたときの安全面、表面の強度面から「強化ガラス」を推奨しております。特にお子様がいらっしゃるお客様には、強化ガラスを選んでいただいています。 強化ガラスは、フロートガラスの3、4倍の強度。万が一割れたとしても、フロートガラスが破片状に鋭利に割れるのと違い、全面に粒状に割れるので、怪我しにくい面で安全です。強化ガラスは、フロートガラスの3、4倍の強度。万が一割れたとしても、フロートガラスが破片状に鋭利に割れるのと違い、全面に粒状に割れるので、怪我しにくい面で安全です。
強化ガラスは、フロートガラスの3、4倍の強度。万が一割れたとしても、フロートガラスが破片状に鋭利に割れるのと違い、全面に粒状に割れるので、怪我しにくい面で安全です。強化ガラスは、フロートガラスの3、4倍の強度。万が一割れたとしても、フロートガラスが破片状に鋭利に割れるのと違い、全面に粒状に割れるので、怪我しにくい面で安全です。
-
作業テーブルの保護ガラスは「合わせガラス」にした方が良いですか?

机の上でカッターを使用する程度でしたら、「合わせガラス」ではなく、「フロートガラス」の強度で問題ありません。
-
机が大きい場合は、テーブルトップのガラスは何枚かに分けたほうが良いですか?
当店では、テーブルトップは分割せずに「1枚ガラス」を推奨しています。
テーブルトップのガラスを数枚に分けた場合、持ち運びに軽くなるメリットはありますが、ガラス天板の上で水などをこぼしたとき、ガラス同士の繋ぎ合わせの隙間から水が侵入し、お手入れが大変になるためです。
-
テーブル天板のガラス等のサンプルを送ってもらうことは可能ですか?
サンプルを専門に掲載している当店姉妹店「e-sample.jp」にてサンプルを取り扱っております。
種類 サンプルの有無 フロートガラス ○ 強化ガラス ✕ アクリル ○ -
テーブルトップに「滑り止めシール」を使用すると、どのような見た目になりますか?

滑り止めシールは、直径1センチほどで厚みがなく薄いので、目立ちません。ご安心ください。
「滑り止めシール」を使用したテーブルのお写真がこちら。


横から見るとこのような感じ。ほとんど浮かず、ベタ置きの状態になります。
滑り止めシールなし 滑り止めシールあり 

曇り止めシールなし 
曇り止めシールあり 
-
テーブルトップに複数のガラスを繋ぎ合わせると、見た目はどんな感じになりますか?
通常のガラスは無色・透明に見えて、含有成分により少し緑がかって見えます。ガラスの断面では、緑色がより濃く見えます。当店でオススメしているオーソドックスな「強化ガラス」の見た目を2つご覧ください。
① 濃い色の机の場合/テーブルトップガラスのつなぎ目

② 明るい色の机の場合/テーブルトップガラスのつなぎ目

-
テーブルの傷や汚れを隠したい場合は、どのガラスがオススメですか?
当店では、不透明なカラーガラスをオススメしております。机の傷の上に「フロートガラス」「フロストガラス」「セラミックプリントガラス」を置いてみた写真をお見せしますね。フロートガラス フロストガラス セラミックプリントガラス ミストホワイト
(プレーン)ホワイト
(プレーン)ブラック
(プレーン)









① フロートガラス

透明なフロートガラスだと、当然ながらテーブルの傷を隠しきれません。
② フロストガラス

フロストガラスはザラザラ感があるので、透明なフロートガラスよりは傷が目立たなくなりましたが、まだ傷がハッキリと見えます。
③ セラミックプリントガラス
セラプリは「ミストホワイト(プレーン)」「ホワイト(プレーン)」「ブラック(プレーン)」の3色を、テーブルトップとして置いてみました。



「ミストホワイト」だと、フロストガラスよりもさらに傷が目立たなくなり、小さな傷が隠れる程度であれば十分です。さらに「ホワイト」「ブラック」だと、完全に傷が隠れるので、傷がひどい場合にはこの2色がオススメです。
他にも、お好みの色のカラーガラスで机の傷が隠せるかどうか分からない場合は、写真例をお送りできます。また、サンプルをご用意している商品もあります。「このカラーガラスでこの程度の傷は隠れますか?」「このガラスをテーブルトップに考えていますが、サンプルは無いですか?」とご相談ください。
-
テーブルトップ用の「滑り止めシール」はどのような商品ですか?

テーブルの滑り止めシールは、指先に載るほどの小さくて丸いシール。4~6枚で1セットです。ご注文されたガラスのサイズによって、必要な枚数が異なります。

滑り止めシールの大きさや形は、指先に載るほどの小さくて丸いものとなります。

このシールをガラス天板に貼り付けると、写真のような仕上がりになります。
-
ガラスの「片面研磨」「両面研磨」は、それぞれどのような場合に向いていますか?
液晶用のガラスであれば、「片面研磨」でも大丈夫です。光学系のフォトマスク、フィルターなど両面に精度を持たせる際には、「両面研磨」をご提案しています。
-
何のためにガラスの表面を磨くのですが?
ガラスは一見、平面に見えますが、ミクロ単位では平面ではありません。
液晶ガラスや光学ガラスとして使用する場合、その少しの表面の粗さが液晶の映りや透過などに影響するため、表面の平行度、平面性を上げる必要があります。
また、ガラスの元板が製造されていない厚みのガラスが必要な場合、厚みが近いガラス板を研磨することで、厚みを調整します。
-
キッチン油はねガードのスタンド部分の詳細な寸法を教えてください
スタンドの寸法図はこちらからご覧いただけます。
-
ガラスの「OG加工」のサンプルはありますか?
貸し出しにてOG加工のサンプルをご覧いただけます。サンプルご希望の方は、お電話、またはフォームから「ガラスのOG加工のサンプルが見たいです」とお伝えください。
- お電話:0120-12-4466
- お見積りフォーム
-
厚みが15ミリ以外のガラスに「OG加工」はできませんか?
型(砥石)が専用のため、OG加工は15ミリ厚のガラスのみとなります。
-
図面を送れば、図面通りの「丁番加工」に仕上がりますか?
ご希望の形状で丁番加工ができるかどうか確認するために、まずは1度図面をお送りください。
- お見積りフォーム
- FAX番号:0776-54-4566
-
強化加工できるガラスの種類を教えてください
ほとんどのガラスが強化加工可能ですが、ガラスの中に泡(空気)の入ったガラスなどは強化加工できません。お問い合わせ頂ければ、強化加工可能か判断致しますので、お気軽にお問い合わせください。
-
強化加工出来るガラスの最大サイズは?
3000 × 6000ミリ (19ミリ厚)までのガラスが強化可能ですが、重量が800kgを越えるために、現実的には1219 × 2438ミリぐらいが最大サイズとなります。
-
「飛散防止(透明)」「フロスト(乳白)」以外のフィルムはありますか?
在庫のあるフィルムは、透明の飛散防止フィルム、乳白色のフロスト調フィルムのみですが、メーカー型番をいただけましたら、対応できるフィルムもございます。
「こんなフィルムを貼ってほしい」とお気軽にご連絡ください。
- お電話:0120-12-4466
- お見積りフォーム
-
「フロスト加工」したガラスに「飛散防止フィルム」を貼ることは可能ですか?
可能です。飛散防止フィルムを貼る面は、フロスト加工をした面と逆のツルツルの面になります。
-
すり加工したガラスに飛散防止フィルムを貼れますか?
可能です。飛散防止フィルムを貼る面は、すり加工をした面と逆のツルツルの面になります。
-
ゴリラガラスのような強度を持ったガラスは作れますか?
「ゴリラガラス」の取り扱いもございますので、ゴリラガラスに加工をすることで可能です。
-
どのような空気層のペアガラスを作れますか?
「乾燥空気層」「アルゴンガラス」「クリプトンガラス」といった空気層で複層ガラスを製作できます。
また、空気層が真空の「クリアFit」「 スペーシア」といった既製品の真空ガラスもございます。
-
「ペア加工」できるガラスの最大サイズを教えてください
3ミリ + 空気層 + 3ミリ のペアガラスで 1500ミリ × 2205ミリ が製造可能な最大サイズとなります。
-
ガラスの「Vカット加工」で曲線加工は可能ですか?

可能です。こちらのような複雑な曲線に仕上げることもできます。
DXF形式のCADデータ、または加工位置が分かる寸法を書き入れた図面が必要です。
-
加工可能な「Vカット」の幅はどれくらいですか?
製作可能なVカットの幅は以下の通りになります。
厚み8ミリ未満
のガラス4、6、8、10、12、15ミリ幅 厚み8ミリ以上
のガラス〜17ミリ幅も可能 -
ガラスの「Vカット加工」のデザインデータは、どのように準備すれば良いですか?
DXF形式のCADデータ、または加工位置が分かる寸法を書き入れた図面が必要です。
- お電話:0120-12-4466
- お見積りフォーム
-
人が乗っても大丈夫な「床用の合わせガラス」は作れますか?

可能です。写真のように、滑り止めに凸凹処理をすることもできます。
-
強化ガラスやデザインガラスの「合わせガラス」は作れますか?
強化仕様、デザインガラスを使った合せガラス、いずれも製作可能です。
-
円形や異形の「合わせガラス」は作れますか?
円形、複雑な形の合わせガラス、いずれも製作可能です。
-
手持ちのフィルム、生地、和紙で「合わせガラス」のサンプルを作ってもらうことはできますか?
可能です。合わせガラスにする生地や和紙を送っていただき、4,000円
4,000円でサンプルの合わせガラスを製作する流れとなります。合わせガラスにできるかどうかのご確認にご利用ください。- お電話:0120-12-4466
- お見積りフォーム
-
どんな生地、和紙などの素材だと「合わせガラス」に使えますか?
ポリエステルや綿などほとんどの物が合わせガラスに使えますが、稀に合わせガラスに使えない素材があります。サンプルを送っていただければ、判断が可能です。まずはお問い合わせください。
- お電話:0120-12-4466
- お見積りフォーム
-
ガラスに塗装した塗料は剥がれませんか?
セラミック塗料を使ったり、塗装後に焼き付けすることで、剥離に強い塗装ガラスを作ることができます。
-
「強化ガラス」を円形にカットできますか?
円形の強化ガラスを作る際は、まず「フロートガラス(透明ガラス)」を円形にカットしてから、そのガラスを強化炉で強化加工して仕上げます。
-
円形ガラスの最大サイズを教えてください
フロートガラス(普通透明ガラス)や強化ガラスの円形ガラスの最大サイズはφ1800ミリとなります。
-
型紙製作セットはどうやって注文すればいいですか?
型紙製作セットのご注文は、お電話0120-12-4466でご注文ください。
-
ガラス板の隣り合う2辺を「斜面取り」すると、どのようになりますか?

写真のような仕上がりになります。
-
斜面取りしたガラス板の角は尖っていますか?
斜面取りした角は鋭く危険ですので、糸面加工で角を若干落としてあります。
-
角度が45度以外のガラスの斜面取りも可能ですか?
可能です。30度、60度など、45度以外の斜面取りもできますので、お気軽にその旨お問合せください。お見積できます。
- お電話:0120-12-4466
- お見積りフォーム
-
ガラスの接着が乾燥するまで、どれくらい時間が掛かりますか?
感光性接着で接着した場合は、紫外線効果のため15分ほどで乾燥して接着されますが、酢酸系シリコーンは、夏冬で変わりますが、乾燥するまでに2日~1週間かかります。
-
強化ガラスに「ウォータージェット加工」できますか?
強化ガラスの場合は、まず「フロートガラス(透明ガラス)」にウォータージェット加工してから、そのガラスを強化炉で強化加工する仕上げ方になります。
-
複雑な形状の加工の場合、データはどのように作ればいいですか?
イラストレーター形式でお願いします。
-
文字の形でガラスをくり抜くことはできますか?
可能です。ただし英文字の「O」や「A」のように、くり抜くと中が残らない文字は加工できません。
「ステンシルフォント」のように、繋がった字体でデザインを作るようにご提案しております。
-
デザインガラスに引き手加工はできますか?
ほとんどのデザインガラスが引き手加工可能です。お問い合わせ頂ければ、引き手加工が可能なガラスかどうかお答えいたします。
-
引き手加工のサイズはどれくらいですか?
ガラスの
板厚引き手加工の
サイズ3ミリ W 約10~13ミリ × H 28~37ミリ 5、6ミリ W 約10~13ミリ × H 33~42ミリ ※ 上記サイズ以外に指定いただくこともできます。
-
薄いガラスに引き手加工はできますか?
3ミリ厚のガラスから引き手加工は可能になります。
-
引き手の位置は指定できますか?
可能です。お客様からご相談をもらった際に、手描きなどの図面をお送りいただいています。まずはお気軽にご相談ください。
- お電話:0120-12-4466
- お見積りフォーム
-
ガラスを固定する金具は販売していますか?
姉妹店の「ガラスのホームセンター ギヤマン」で パネルアタッチメントを販売しています。
-
カラーガラスにもエッチング加工(エッチング印刷)できますか?
カラーガラスの裏面からエッチング加工することで可能です。ただ、フルカラー印刷で一面をカラー印刷したほうが価格が安くなります。 ※カラーガラスは当社のカラーガラス.comでご用意が可能です。 ※フルカラー印刷した場合もカラーガラスにエッチングした場合も表からみると同じように見えますが、フルカラー印刷は若干透けて見えます。
※カラーガラスは当社のカラーガラス.comでご用意が可能です。 ※フルカラー印刷した場合もカラーガラスにエッチングした場合も表からみると同じように見えますが、フルカラー印刷は若干透けて見えます。 -
塗装なしエッチング加工の仕上がり、色はどのようになりますか?
ホワイトとミストからお選びいただけます。エッチング加工の色は通常、薬品処理をするため、ミスト(フロスト)色ですが、薬品処理をしないことで、下の写真のようにホワイト(白)色にすることが可能です。どちらも料金は同じです。
-
エッチング加工したガラスは、外装や水回りで使えますか?
外装や水周りで使う場合は、裏側から「反転文字」でエッチング印刷し、印刷した部分に水が直接当たらないように使うことで可能です。 ※裏側から反転印刷することで、表からみるとフラットに見えます
※裏側から反転印刷することで、表からみるとフラットに見えます -
送った記録メディアは返してもらえますか?
ご希望の方のみメール便で返却しております。返却の必要な方は、「送ったDVDは返してほしいです」等、お気軽にご連絡ください。 -
ラウンドエッジ加工のRの大きさは指定できますか?
ラウンドエッジ加工のRの大きさはガラスの厚みごとに決まっています。
-
円形や異形のガラスに「広幅面取り」はできますか?
可能です。形状が複雑な場合はできない場合もございますので、一度お問い合わせください。
- お電話:0120-12-4466
- お見積りフォーム
-
R加工したガラスに「広幅面取り」はできますか?

可能です。R加工に広幅面取りをすると、こちらの写真のような仕上がりになります。
-
広幅面取りの幅の最大サイズは?
ガラスの厚みごとに広幅の最大サイズが異なります。例えば、4ミリ厚のガラスですと広幅の最大サイズは21ミリ、5ミリ厚のガラスは24ミリとなります。
ガラスの厚み4ミリ 最大サイズ:21ミリ ガラスの厚み5ミリ 最大サイズ:24ミリ -
ガラスの「広幅面取り加工」の角度は変更できますか?
変更可能です。小口(側面)の見え幅を指定いただけます。
-
「すり加工」したガラスに「飛散防止フィルム」を貼ることは可能ですか?
はい、飛散防止フィルムを貼ることは可能です。
飛散防止フィルムを貼る面は、加工面と逆の面(ツルツルの面)にフィルムを貼ります。
-
障子用ガラス(ぼかし山水)のサイズは?
障子用ガラス(ぼかし山水)のサイズは、914ミリ × 610ミリになります。周りをカットすることは可能です。
-
障子用ガラス(ぼかし山水)の厚みは?
基本は2ミリ厚のガラスに加工しますが、その他の厚みのガラスにも加工は可能です。
-
アクリル (泡入り) とガラスとの違いは?
アクリル (泡入り) とガラスの性質をそれぞれ下記の表でご確認下さい。
アクリル (泡入り) とガラスの性質
単位 アクリル
(泡入り)ガラス 比重 1.13 2.5 曲げ強度 MPa 108 43 曲げ弾性率 GPa 3.7 41 シャルピー衝撃試験 kj/㎡ 16 1 全光線透過率 % 92 87 アクリル (泡入り) とガラスの性質をそれぞれ下記の表でご確認下さい。
アクリル (泡入り) とガラスの性質
アクリル
(泡入り)ガラス 比重 1.13 2.5 曲げ強度
(MPa)108 43 曲げ弾性率
(GPa)3.7 41 シャルピー衝撃試験
(kj/㎡)16 1 全光線透過率
(%)92 87 -
アクリルチェッカーとガラスとの違いは?
アクリルチェッカーとガラスの性質をそれぞれ下記の表でご確認下さい。
アクリルチェッカーとガラスの性質
単位 アクリル
チェッカーガラス 比重 1.04 2.5 重量 kg/㎡ 4.2 10 曲げ強度 MPa 78 43 曲げ弾性率 GPa 2.8 41 シャルピー衝撃試験 kj/㎡ 9 1 落球試験(1kg) mm 210 50 全光線透過率 % 92 87 アクリルチェッカーとガラスの性質をそれぞれ下記の表でご確認下さい。
アクリルチェッカーとガラスの性質
アクリル
チェッカーガラス 比重 1.04 2.5 重量
(kg/㎡)4.2 10 曲げ強度
(MPa)78 43 曲げ弾性率
(GPa)2.8 41 シャルピー
衝撃試験
(kj/㎡)9 1 1kg
落球試験
(mm)210 50 全光線透過率
(%)92 87 -
アクリルモールとガラスとの違いは?
アクリルモールとガラスの性質をそれぞれ下記の表でご確認下さい。
アクリルモールとガラスの性質
単位 アクリル
モールガラス 比重 1.07 2.5 重量 kg/㎡ 4.3 10 曲げ強度 MPa 86 43 曲げ弾性率 GPa 3.4 41 シャルピー衝撃試験 kj/㎡ 10 1 落球試験(1kg) mm 250 50 全光線透過率 % 92 87 アクリルモールとガラスの性質をそれぞれ下記の表でご確認下さい。
アクリルモールとガラスの性質
アクリル
モールガラス 比重 1.07 2.5 重量
(kg/㎡)4.3 10 曲げ強度
(MPa)86 43 曲げ弾性率
(GPa)3.4 41 シャルピー
衝撃試験
(kj/㎡)10 1 1kg
落球試験
(mm)250 50 全光線透過率
(%)92 87 -
研磨可能なガラスの厚み、サイズを教えて下さい。
片面研磨の場合
対応板厚 0.4ミリ ~ 5ミリ 製作可能サイズ 200 × 200ミリ ~ 730 × 920ミリ 両面研磨の場合
対応板厚 0.3ミリ ~ 5ミリ 製作可能サイズ 10 × 10ミリ ~ 300 × 400ミリ -
表面研磨の精度は?
最高品質の場合の参考値となりますが以下の通りです。
フロートガラス (サイズ: 幅200ミリ × 高さ200ミリ 厚み: 0.7ミリ)
研磨の種類 両面平面研磨 平坦度(TTV) 1μm 面精度 30μm前後 表面粗さ 約10Å前後 -
1枚ですが研磨していただくことはできますか?
単価が若干高くなりますが、可能です。お気軽にお問い合わせください。
-
有機塗料印刷したガラスは、屋外や水回りで使っても良いですか?
屋外や水回り、地下などの湿気の多い場所での使用は、印刷のひび割れや剥がれの原因となりますので推奨しておりません。
直接水が当たる場所での使用は避け、コーキングをしたり、印刷面を室内側に向けたりしてご使用ください。
-
オンデマンドフルカラー印刷したガラスは、シンナーで拭いても大丈夫ですか?
印刷が剥がれてしまう恐れがありますので、シンナー等の溶剤のご使用は避けてください。シンナー等を使われる場合は、溶剤に強い「セラミック印刷」をオススメしております。
-
オンデマンドフルカラー印刷は、ガラスの表面・裏面どちらへの印刷ですか?
表面のみ、裏面のみ、表面・裏面の両面も可能です。通常は、ご指定がなければ裏面に印刷します。印刷面を保護するためです。


-
オンデマンドフルカラー印刷は、ガラスの裏側から見るとどのような感じですか?
色を載りやすくするため、写真のような白のべた塗りがあります。
※ 白べたの部分が複雑な形状の場合、印刷機用に特別にデータを作る必要があるため、別途データ作成料が掛かる場合がございます


-
「下地あり」「下地なし」の違いを教えてください。
「下地あり」は色がはっきり見え、「下地なし」は透けて見える仕上がりになります。
下地あり 下地なし はっきりとした色味で仕上がる

ガラスの透け感を出したい場合におすすめ

「下地あり」は色がはっきり見え、「下地なし」は透けて見える仕上がりになります。
下地あり 下地なし はっきりとした色味で仕上がる

ガラスの透け感を出したい場合におすすめ

一部のみに下地を付けることも可能です。
黒くなっているカ所に下地が付くと、ねこの色味がはっきりと印刷され、背景はぼかされている印象に仕上がります。
-
強化ガラスやペアガラス等、違う種類のガラスに印刷は可能ですか?
-
セラミックプリント印刷ガラスは屋外や水周りで使用できますか?
直接水が当たるご使用はお避けください。コーキングをしたり、窓なら印刷面が室内側になるようにしてご使用ください。 -
セラミックプリント印刷部分は爪などで引っ掻くと剥がれますか?
セラミックプリント印刷は、とても強固な塗料です。爪で引っかいた程度では剥がれません。 鋭利なもので、傷を付けると剥がれるというより、ガラスに傷がついたというイメージになります。 ガラスの破損の恐れがありますので、通常のガラス同様取り扱いにはご注意ください。 -
セラミックプリント印刷は自分で切断できますか?
セラミックプリントガラスは、印刷する際に熱処理を加えるため、強化ガラスと同等の性質を持ちます。 よってセラミックプリント印刷ガラスはガラスカッターでは切断することができません。 ガラス切断後に印刷することになります。当社ではオーダーサイズでセラミックプリント印刷することが可能です。 -
ガラス印刷の入稿データの作成は、どうすればいいですか?
「イラストレーター形式(.ai)」「フォトショップ形式(.psd)」、いずれかの形式で入稿を承っております。
どちらのソフトもお持ちではない場合は、まず1度お電話ください。
- お電話で相談する:0120-12-4466
- フォームで相談する:お問い合わせ・お見積フォーム
-
「セラミック印刷」は、ガラスの表面・裏面どちらへの印刷ですか?

通常は、ご指定がなければ裏面に印刷します。印刷面を保護するためです。表面の印刷も可能です。
-
ガラスに印刷をすると少し青みがかると聞きましたが、そうなのでしょうか?
通常のガラスは完全な透明ではなく、少し青みがあり、この青みが印刷の色を多少ばかり青色に見せます。
※ ガラスの厚みが増せば青みが強くなり、薄いと青みが少ない
通常はガラスの裏面に印刷しますが、表面に印刷することで防ぐことも可能ですので、青みを気にされる場合は1度ご相談ください。
-
他のガラス印刷屋さんよりもなぜ安く印刷できるのですか?
当店はガラス屋なので、ガラス自体が安いです。
通常の印刷屋と印刷代は同じかもしれませんが、他店の場合はガラス屋からガラスを仕入れることになります。そのため、印刷代とガラス代を合わせた金額でみると、当店の方が安くなるというわけです。
-
強化ガラスやデザインガラス等、他のガラスに加工可能ですか?
-
ガラスへの印刷サンプルを見せてもらうことは可能ですか?
貸し出しにて可能です。ガラス印刷のサンプルをご覧になりたい場合は、こちらからお気軽にご連絡ください。
- お電話でサンプルを依頼する:0120-12-4466
- フォームでサンプルを依頼する:お問い合わせ・お見積フォーム
-
「有機塗料印刷」の入稿データの作成は、どうすればいいですか?
「有機塗料印刷」は、ガラスの外周を印刷したり、一定間隔でストライプで印刷したりと、パソコンで作られたデータからの印刷ではなく、マスキングしての印刷になります。
「外周を20ミリの幅で黒で印刷する」「10ミリ間隔で20ミリ幅のストライプ」などの単純印刷に限られますので、データは必要ありません。簡単な図面などいただければ、そのように印刷します。
データを必要とする複雑な印刷は、「セラミックプリント印刷」や「オンデマンド印刷」の印刷機を使ったプリントをオススメしています。
-
1枚のガラスに「R加工とC加工を混ぜて加工」することはできますか?
可能です。「2箇所をR加工、残りの2箇所をC加工」のように1枚のガラスにR加工とC加工を混ぜて加工することは可能です。
-
ガラス印刷の入稿データを作るときのPhotoshopのバージョンが古くても大丈夫ですか?
Photoshop形式(.psd)であれば、どのバージョンでも大丈夫です。
-
ガラス印刷の入稿データを作るときのIllustratorのバージョンが古くても大丈夫ですか?
Illustrator形式(.ai)であれば、どのバージョンでも大丈夫です。
-
ガラス印刷データを作るための、IllustratorもPhotoshopも持っていないのですが、どのようにデータ入稿すれば良いですか?
お電話「0120-12-4466」もしくはフォームから、その旨ご連絡ください。お客様の状況にあわせてデータが作成できるように、当店スタッフがアドバイスもしくはデータ制作いたします。 -
どれくらいのサイズの曲げガラスの加工ができますか?

写真のような、建具や家具などに使われる小型の曲げガラスの加工が得意です。ショーウィンドウや大型のショーケースなどの曲げガラスは対応できないものもございます。
-
支柱の詳細な寸法を教えてください
詳細な寸法は図のようになります。
-
地震などで落下することはありませんか?
当社で販売しているガラス棚受けには、安全ロックが付いていますので地震などで外れて落下しにくくなっています。また、ガラス滑り止めゴムが付いていますので、ガラスも落ちにくくなっています。 -
ホームページ掲載以外のサイズのブラケットはありませんか?
在庫のあるブラケットはホームページ掲載のものだけですが、探してみますので是非ご連絡ください。 -
ブラケットの厚みは?
ガラス棚ブラケットの厚みは全サイズ共通で「2.6ミリ」です。 -
ブラケットの詳細な寸法を教えてください
詳細な寸法は図のようになります。
-
取り付け方法を教えてください
動画で取付けの説明を作りましたので、御覧ください。動画はこちら -
既存で使っているブラケットを、御社の支柱に使えますか?
まずはお使いのブラケットに写真のようなAAのマークがないかご確認ください。AAのマークがあれば当社の支柱に間違いなく合います。
AAのマークがない場合は、図面で寸法をご確認ください。
-
支柱は自分で切断することはできますか?
当社の棚受け支柱はスチール製ですので、金ノコ等で簡単に切断することができます。 -
強化加工(強化ガラス)になると何が違うのですか?
強化加工をすると、ガラスゆがみに対するガラスの強度が増します。つまり、耐加重が増します。 ゆがみを少なくされたい方は、厚みを厚くすると、ゆがみが少なく、耐加重も増します。 他にも強化ガラスは、ガラスが割れた際に粉々になるため、安全だと言われています。通常のガラスは割れると破片が包丁のように鋭く、とても危険です。 -
ガラスの角を丸くするR加工のサイズを変更することはできますか?
できます。当社ではR加工をお客様がご希望の場合、特に指定がなければ、長辺の前方を2カ所R13で加工しています。 R13は500円玉のR(R13.25)と同じぐらいですのでイメージしやすいと思います。Rの位置、数、サイズに変更がある場合も対応できますので、お見積もりやお知らせください。
-
オーディオラック、TVラック用のガラス天板・棚板はありますか?

はい、ございます。
お客様の棚の形状に合わせた寸法で、ガラス天板・棚板をお作りできますし、角に丸みをつける等も可能です。
はい、ございます。
お客様の棚の形状に合わせた寸法で、ガラス天板・棚板をお作りできますし、角に丸みをつける等も可能です。

-
ガスコンロを上に敷いても大丈夫な テーブルマット・テーブルトップのガラス天板はありますか?

はい、ございます。
熱を伴う用途であれば、当店で推奨している「強化ガラス」は200℃まで大丈夫です。
はい、ございます。
熱を伴う用途であれば、当店で推奨している「強化ガラス」は200℃まで大丈夫です。

-
キッチンカウンターに敷くガラス天板はありますか?

はい、ございます。
キッチン周りで使うガラス天板は、特に「強化ガラス」を推奨しております。耐熱温度が200℃ありますし、万が一割れたとしても、破片が粉々になるので、手を切る心配がありません。
はい、ございます。
キッチン周りで使うガラス天板は、特に「強化ガラス」を推奨しております。耐熱温度が200℃ありますし、万が一割れたとしても、破片が粉々になるので、手を切る心配がありません。

-
テーブルの縁が丸くなっている場合は、ガラス天板をどのような寸法にすると良いですか?

図のようにテーブルの縁が丸くなっている場合は、外周よりもひと回り小さいガラステーブルトップを作るのがオススメです。
-
ビニールマットのお手入れ方法を教えてください
水やぬるま湯を含んだ布で拭き取ってください。水をかけて丸洗いも可能ですが、水滴が残らないよう布で拭き取って乾かしてください。アルコール含まれた除菌剤、ウェットティッシュで拭かないでください。 表面が痛んで変形する恐れがあります。
-
ビニールマットの素材は何ですか?
当店で取り扱っているテーブルトップ用のビニールマットは、塩化ビニール製です。
-
ガラスにどんな曲げ加工ができますか?形状を教えてください
お客様からは、下記の形状でガラス曲げのご相談が多くあります。







-
鏡(ミラー)の曲げはできませんか?
通常の鏡の曲げはできませんが、曲げの出来る鏡を用意することは可能です。
-
曲げガラスには穴開け加工は可能ですか?
もちろん可能です。ただし強化ガラスの場合は製造後の穴開けはできませんので、穴あけをしてから強化ガラスにすることになります。穴あけがある場合は注文前にお知らせください。
※ 板厚より小さな穴は開けれません。また、ガラスの端に近い穴開けは割れる恐れがあるため、穴開け不可です。(ガラスから穴まで、板厚み2倍以上穴が離れていればOK)
例. 10ミリのガラスなら、ガラスの縁から20ミリ以上穴が離れていればOK
-
梱包はどのようになって配達されるのですか?

基本的には木箱での梱包となります。右のような感じの梱包で、これにさらにストレッチフィルムというものでぐるぐる巻きにして運送屋さんがガラスに触ることを防ぎます。
-
曲げのRの指定は、外側Rと内側Rのどちらを指定すればいいのですか?

どちらでも結構です。ただし、どちら側のRか分かるようにしていただくと助かります。ちなみに、右の図のような10ミリ厚の曲げガラスの場合、外側のRが30ミリなら内側のRは厚み10ミリを引いた20ミリということになります。
-
曲げ加工の「R」を、どれくらいに指定すれば良いのか分かりません

実際作るものがないと、正確なRってわかりませんよね。 希望する曲げガラスの大体の絵を送っていただければ、当社で図面にしてRのイメージをお伝えすることもできますので、どのくらいのRにしてよいか分からない方は、 「50Rぐらい?」とか「約30R?」のように、あいまいな数字を絵に描いておいてください。型紙を送っていただいての曲げガラス製作も可能です。
-
同じ曲げガラスを2枚購入するとお安くなりますか?
曲げガラスは完全手作りですので、一枚一枚曲げるために型を作ります。1枚だけの注文ですとどうして単価が高くなってしまいます。同じ曲げガラス2枚以上ですと同じ型で複数枚製作することが可能なりますので、多少お安くすることができます。見積でも複数枚製作の可能性のある場合は、1枚の場合、2枚の場合など枚数の違う場合のお見積もとってみてください。
-
曲げるガラスの元板のメーカー指定はできますか?
指定可能です。 国内メーカー「AGC旭硝子」「日本板硝子」「セントラル硝子」の3社からお選び頂けます。
-
曲げることができるガラスの種類を教えてください
当社ではよく曲げに利用される、フロートガラス(普通ガラス)やショーケースに使われる高透過ガラス、フロストガラス、強化ガラスなどほとんどのガラスを扱っていますので、変わったガラスの曲げでも是非お問い合わせください。
※ 塗装したガラス、耐熱ガラスは曲げることができません。
-
エッチング加工したガラスのサンプルを見せてもらうことは可能ですか?
貸し出しにて可能です。お気軽にその旨ご連絡ください。
- お電話:0120-12-4466
-
ガラスのエッチング加工「平彫り」の「番手」を教えてください
100番になります。
-
ガラスの「エッチング印刷」の入稿データの作成は、どうすればいいですか?
「イラストレーター形式(.ai)」「フォトショップ形式(.psd)」、いずれかの形式で入稿を承っております。
どちらのソフトもお持ちではない場合は、まず1度お電話ください。
- お電話で相談する:0120-12-4466
- フォームで相談する:お問い合わせ・お見積フォーム
-
ガラスの「エッチング加工」で「ゴールド」「シルバー」の塗装は可能ですか?
可能です。
但し、通常キラキラしているような感じには仕上がりません。 キラキラしている感じをお客さまが希望の場合は、できる場合がございますので、一度お気軽にお問い合わせください。 -
ガラスの「エッチング加工」で色を付けると、ガラスの裏側はどのように見えますか?

表面は段ができていますが、裏側から見ると、写真のように平面になります。反転させてデザインすることで、裏側をメイン(表)に使われる方もいらっしゃいます。
-
ガラスの「エッチング加工」で色を付ける場合、どのような加工が可能ですか?

写真のように、2段、3段と段を作ることで複数の色を使うことが可能です。また、塗装なしのエッチング加工で、写真のような影(ドロップシャドウ)を演出することも可能です。
-
見積が欲しいのですが、図面を送ってもいいですか?
曲げ加工の場合、電話など口頭やメールなどの文章でガラスの形状を伝えるのは難しいかと思います。FAXで図面を送っていただいてのお見積りも可能です。 FAX番号:0776-54-4566までお送りください。
-
曲げ強化ガラスは作れますか?
もちろん可能です。耐風圧強度が強く、破損時に粉々になる安全性の高い強化曲げガラスが製作可能です。
-
「強化ガラス」に「切り欠き加工」はできますか?
強化ガラスに切り欠き加工をする場合は、まず「フロートガラス(透明ガラス)」に切り欠き加工をしてから、強化加工にて仕上げる流れになります。
-
1枚のガラスの複数箇所に、切り欠き加工はできますか?
可能です。1枚のガラスに数カ所の切り欠き加工をすることは可能です。お気軽にお問い合わせください。
-
「フロスト加工」したガラスに「飛散防止フィルム」を貼れますか?
はい、飛散防止フィルムを貼ることは可能です。
飛散防止フィルムを貼る面は、加工面と逆の面(ツルツルの面)にフィルムを貼ります。 -
ガラスの一部分だけに「フロスト加工」はできますか?
可能です。ガラスの一部分をマスキングすることによって、一部分をフロスト加工することも可能です。
-
切断できるガラスの最小サイズを教えてください
切断できるガラスの最小サイズはガラスごとに異なります。手加工であれば10ミリ×10ミリのガラスも製作が可能です。各ガラスの最小サイズは 0120-12-4466 までお問い合わせください。
-
切断できるガラスの最大サイズを教えてください
切断できるガラスの最大サイズはガラスごとに異なります。一番大きなものはフロートガラス(普通透明ガラス)の6ミリ厚で6056ミリ×3008ミリが最大サイズになります。各ガラスの最大サイズは 0120-12-4466 までお問い合わせください。
-
どんな梱包で発送されますか?
ガラスによって異なります。段ボール梱包や木箱梱包、大きなものになりますと鉄パレットと呼ばれるガラス専用のパレットですることもございます。ご注文やお見積もり時に梱包方法はお伝えいたします。
-
同業者(ガラス屋)ですが利用できますか?
もちろん可能です。自社でできない加工でお困りの場合もあると思います。お気軽にご利用ください。
-
加工したいガラスが大量にある場合は、安くなりますか?
加工によりますが、大量に発注された場合、価格をお安くすることが可能です。まずはお見積り致しますので、お気軽にお問い合わせください。
-
サイトに掲載されていないガラス加工の相談はできますか?
掲載されていない加工でも、できる場合がございますので、一度お気軽にお問い合わせください。
-
法人ではないのですが、ガラス加工をしてもらうことは可能ですか?
個人の方でもガラス1枚の加工からご利用いただけます。お気軽にご利用ください。
-
ガラスを支給して加工してもらうことは可能ですか?
可能です。当店にお送りいただく場合は、お客様のほうで運送費がかかりますので、基本的に、当店でガラスを調達されたほうがお安くなります。
-
ガラスの注文と一緒に加工もお願いしたいのですが、可能ですか?
可能です。当店ご利用のお客様のみなさんは、ガラスのご注文やお見積りのご依頼の際に「穴あけもしてほしい」「引き手を付けてほしい」等のご要望も一緒に添えてくださっております。ご希望の仕上がりがありましたら、スタッフにお伝えください。
-
ガラス加工の見積をしてほしいのですが、どうすれば良いですか?
お電話、またはお見積りフォームからその旨、お伝えください。特にお急ぎの場合は、お電話がスムーズです。お気軽にご相談くださいませ。
- お電話:0120-12-4466
- お見積りフォーム
-
手持ちのガラスに穴あけ加工してもらえますか?
可能ではありますが、送っていただく送料等を考えると、当社でガラスをご用意したほうがトータル価格はやすくなる場合がほとんどでございます。価格はすぐにお見積できますので、0120-12-4466 まで、お気軽にお問い合わせください。
-
ガラスの「穴あけ加工」に、出張で来てもらうことは可能ですか?
据え置きの機械を使ってコアドリルで加工する為、出張でガラスに穴を開けることはできませんが、穴を開けたガラスを購入する方が、すでにあるガラスに穴を開けるより安くなる可能性が高いです。価格はすぐにお見積できますので、0120-12-4466 まで、お気軽にお問い合わせください。
-
ガラスの「穴あけ加工」の、穴の「最小サイズ」を教えてください
基本的にはガラスの厚みより小さい穴は開けれません。特殊ガラスなどを使うことで小さな穴を開けることができる場合もございます。0120-12-4466 まで、お気軽にお問い合わせください。
-
ガラスの「穴あけ加工」の、穴の「最大サイズ」を教えてください
ウォータジェット等で穴あけ加工をすれば、サイズは無制限に大きくすることが可能です。
-
ガラスの切断面はどうなっていますか?
とくに指定が無い場合は切りっぱなしの状態になっています。詳しくは切断面についてをご覧下さい。 -
バイコールがメーカー生産中止とのことですが、もう手に入りませんか?
メーカーでの生産が終了し、現在は代替品として「石英ガラス」が使われています。
-
耐熱ガラス「バイコール」は、水で急激に冷やしても割れませんか?
どのくらいの温度変化なら大丈夫か示す温度に「耐熱衝撃温度」という指標があります。耐熱衝撃温度の数値は、その数値から0℃に急冷した場合に割れないとされています。ガラスは熱伝導率が低い(熱が伝わりにくい)ため、板厚が熱くなるほど、表面と内部の温度差が生じて割れやすくなります。
「バイコール」はメーカー生産中止しておりますが、代わりに当店でオススメしている「石英ガラス」は耐熱衝撃温度が900℃なので、900℃から0℃に一気に冷やされても割れません。
-
透過率の高い「合成石英ガラス」は取り扱っていますか?
はい、取り扱っております。透過率を重視するお客様に「合成石英ガラス」をご提案しています。
合成石英ガラスの価格
合成石英ガラスの参考価格/厚み5ミリ
... -
耐熱ガラス「石英ガラス」は、水で急激に冷やしても割れませんか?
どのくらいの温度変化なら大丈夫か示す温度に「耐熱衝撃温度」という指標があります。耐熱衝撃温度の数値は、その数値から0℃に急冷した場合に割れないとされています。ガラスは熱伝導率が低い(熱が伝わりにくい)ため、板厚が熱くなるほど、表面と内部の温度差が生じて割れやすくなります。
「石英ガラス」は耐熱衝撃温度が900℃なので、900℃から0℃に一気に冷やされても割れません。
-
耐熱ガラス「石英ガラス」は、何色ですか?

通常のガラスは青み(緑)がかった透明ですが、石英ガラスは、写真のように無色透明です。
-
耐熱ガラス「ファイアライト」の「熱膨張係数」を教えてください
通常の透明ガラス「フロートガラス(クリアガラス)」と、耐熱ガラス「ファイアライト」の熱膨張係数を比較したものがこちらです。
熱特性 耐熱ガラス
ファイアライトフロートガラス
(クリアガラス)熱膨張係数
(×10-6K)
30~750℃-0.3 8.5 比熱
(J/kg・K)
25℃710 753 熱伝導率
(W/m・K)
25℃1.5 1 -
耐熱ガラス「ファイアライト」は、水で急激に冷やしても割れませんか?
どのくらいの温度変化なら大丈夫か示す温度に「耐熱衝撃温度」という指標があります。耐熱衝撃温度の数値は、その数値から0℃に急冷した場合に割れないとされています。ガラスは熱伝導率が低い(熱が伝わりにくい)ため、板厚が熱くなるほど、表面と内部の温度差が生じて割れやすくなります。
「ファイアライト」は耐熱衝撃温度が800℃なので、800℃から0℃に一気に冷やされても割れません。
-
耐熱ガラス「ファイアライト」は、自分で切断できますか?
「ファイアライト」も「ガラスカッター」という道具を使って、ご自身で切断できます。ガラスの切断方法は、当店姉妹店の「ガラスのホームセンター ギヤマン」で動画でご覧いただけます。
ファイアライトは高価なので、ご自身で切断するよりも、オーダーサイズでご注文いただくことをオススメしております。
-
耐熱ガラス「ネオセラム」は、水で急激に冷やしても割れませんか?
どのくらいの温度変化なら大丈夫か示す温度に「耐熱衝撃温度」という指標があります。耐熱衝撃温度は、その温度から0℃に急冷した場合に割れないとされている数値です。
「ネオセラム」の耐熱衝撃温度は800℃なので、800℃から急激に0℃になっても割れません。熱衝撃による割れに非常に強いです。
一方で、ネオセラムの「最高使用温度」は800℃なので、800℃を超える箇所で使い続けるとガラスが変質してきます。
※ 最高使用温度800℃は、短時間のみ800℃でも使用できるという意味
※ 耐熱衝撃温度800℃は、800℃から0℃に急激に冷却しても割れないという意味 -
耐熱ガラス「ネオセラム」は、自分で切断できますか?
「ネオセラム」も「ガラスカッター」という道具を使って、ご自身で切断できます。ガラスの切断方法は、当店姉妹店の「ガラスのホームセンター ギヤマン」で動画でご覧いただけます。
ネオセラムは高価なので、ご自身で切断するよりも、オーダーサイズでご注文いただくことをオススメしております。
-
耐熱ガラス「テンパックス強化」は、水で急激に冷やしても割れませんか?
どのくらいの温度変化なら大丈夫か示す温度に「耐熱衝撃温度」という指標があります。耐熱衝撃温度の数値は、その数値から0℃に急冷した場合に割れないとされています。ガラスは熱伝導率が低い(熱が伝わりにくい)ため、板厚が熱くなるほど、表面と内部の温度差が生じて割れやすくなります。
「テンパックス強化」は耐熱衝撃温度が290℃なので、290℃から0℃に一気に冷やされても割れません。
-
耐熱ガラス「テンパックス強化」は、薪ストーブの覗き窓に使えますか?
テンパックス強化は最高使用温度が290℃のため、薪ストーブに向かないです。薪ストーブの覗き窓に使われる場合は、耐熱温度が800℃の「ネオセラム」が良いです。
-
耐熱ガラス「テンパックス強化」は、自分で切断できますか?
「テンパックス強化」は、強化ガラスのため切断できません。「テンパックス」をオーダーサイズでお作りし、強化加工可能です。
-
耐熱ガラス「テンパックス強化」は、何色ですか?

通常のガラスは、青み(緑)がかった透明ですが、「テンパックス強化」は、ほぼ無色透明です。
-
耐熱ガラス「テンパックス」は、強化加工できますか?
「テンパックス」を強化加工した「テンパックス強化ガラス」という耐熱ガラスがございます。
最高使用温度は「テンパックス」の500℃から290℃と下がりますが、耐熱衝撃温度は175℃から250℃に上がるため、急激な温度変化に強いガラスです。
最高使用温度 短い時間に限り使用できる温度
- テンパックス:500℃
- テンパックス強化:290℃
耐熱衝撃温度 その温度から一気に0℃に冷やしても割れない温度
- テンパックス:175℃
- テンパックス強化:250℃
「テンパックス強化」は、強化ガラスのため切断できません。サイズオーダーをご希望の場合は「テンパックス」をオーダーサイズでお作りし、強化加工にて可能です。
-
耐熱ガラス「テンパックス」は、水で急激に冷やしても割れませんか?
「テンパックス」でも急激な温度変化には耐えることが出来ません。
どのくらいの温度変化なら大丈夫か示す温度に「耐熱衝撃温度」という指標があります。耐熱衝撃温度の数値は、その数値から0℃に急冷した場合に割れないとされています。ガラスは熱伝導率が低い(熱が伝わりにくい)ため、板厚が熱くなるほど、表面と内部の温度差が生じて割れやすくなります。
ネオセラムは熱膨張係数が限りなく0に近いため、熱衝撃による割れに非常に強いです。
※最高使用温度が800℃なので、800℃を越えて使い続けると、ガラスが変質してきます。
-
耐熱ガラス「テンパックス」は、薪ストーブの覗き窓に使えますか?
薪ストーブに「テンパックス」を使われる方もいらっしゃますが、当店では耐熱温度800℃の「ネオセラム」をオススメしております。
薪ストーブは、空気を送る量や薪の状況などで激しく温度が変化しますので、耐熱温度500℃の「テンパックス」だと熱割れする可能性がございます。
-
耐熱ガラス「テンパックス」は、自分で切断できますか?
テンパックスはガラスカッターという道具を使って、ご自分で切断することが可能ですが、たいへん高価なガラスです。オーダーメードで購入されることをお勧めいたします。 -
耐熱ガラス「テンパックス」は、何色ですか?

通常のガラスは青み(緑)がかった透明ですが、「テンパックス」は、ほぼ無色透明です。
-
「最高使用温度」「常用使用温度」の違いは何ですか?
それぞれの耐熱温度で、下記の意味の違いがございます。
最高使用温度 短い時間に限り使用できる温度 常用使用温度 長時間連続して使用できる温度 -
「強化ガラス」は、水で急激に冷やしても絶対に割れませんか?
「強化ガラス」も急激な温度変化には耐えることができません。
どのくらいの温度変化なら大丈夫か示す温度に「耐熱衝撃温度」という指標があります。耐熱衝撃温度の数値は、その数値から0℃に急冷した場合に割れないとされています。ガラスは熱伝導率が低い(熱が伝わりにくい)ため、板厚が熱くなるほど、表面と内部の温度差が生じて割れやすくなります。
当店で取り扱っている耐熱ガラスの中では「ネオセラム」が800℃と、熱衝撃による割れに非常に強いです。
※ 最高使用温度が800℃なので、800℃を越えて使い続けると、ガラスが変質してきます。 -
キッチンに油はねガードにガラスパネルを立てたいのですが、金物はありませんか?
当店の姉妹サイト「ガラスのホームセンター ギヤマン」にて、キッチンの油はね防止用 ガラス間仕切りの商品、金物を取り扱っております。

当店、姉妹サイトのギヤマンともに、同じスタッフが対応しておりますので、お気軽にご相談くださいね。
-
強化ガラスは、どのような色をしていますか?

「強化ガラス」の色は、通常のガラスと同様の青み(緑)がかった透明です。
-
防火ガラスは扱っていませんか?
-
耐熱ガラスの梱包はどうなるのですか?
小さいサイズですと段ボール梱包、大きなガラスや薄くて割れやすいものは木箱梱包になります。 -
引き戸枠は付属していますか?

引き戸枠やレールは付属していません。
お客様にて、鴨居に3mm、敷居にVレールの溝堀加工をお願いします。
-
テンパードアに使用するガラスのサイズの決め方は?
ドアのガラスサイズは、間口から上3ミリ、下10ミリ、戸尻3ミリ、戸先(ハンドル側)3ミリの隙間ができる寸法で作るのがオススメです。開口のサイズを教えていただければ、当社でサイズを計算いたします。

-
テンパードアの開閉スピードはどのように調整できますか?
ドアの軸下の地中に埋まっている「フロアヒンジ」の「調整バルブ」で開閉スピードを調整します。
こちらの画像は、「E-1300」「E-1400」にある「調整バルブ」の例です。
 フロアヒンジにいくつか種類があり、種類によって造りが違いますので、ご不明な点は遠慮なくお問合せください。
フロアヒンジにいくつか種類があり、種類によって造りが違いますので、ご不明な点は遠慮なくお問合せください。 -
フロアヒンジを取り付ける際、注意することはありますか?
注意点は大きく分けて3つです。
本体の水平を出す

※ トップピポットの取付の際も必ず平衡を保ってください。

本体を竪枠と平行にする
ドア幅方向の平行をだしてください。

本体を固定する
本体をモルタルにて固定する前に、プレート取付ネジの頭にモルタルが詰まらないようテープにて養生してください。

※ OAフロアの場合は、フロアヒンジ本体の固定用台座(別売)を設置してください。
-
ドアを閉めた際に、ガラス戸が行き過ぎた状態で停止してしまいます。
一方開き用フロアヒンジには押し代がついています。この場合、ドアを閉めた際に反対側へ約5°行き過ぎて停止してしまいますので、必ず戸当り(別売)を設置してください。
-
ドアを開け閉めする際の、音鳴りやガタつきを抑えたいです。
しっかりとアームが締め付けられているかを確認してください。締め付けが弱いと、音鳴り・ガタつきの原因になります。

-
ガラスが割れた場合、上框(ガラスを固定している金具)が落下することはありませんか?
強化ガラスドアは、ガラスが割れると上框が落下する恐れがあります。
取付の際にしっかりと吊込むことで、落下の可能性が低くなりますので、下記手順でドアを吊込み、安全を確認してください。吊込みの方法は2つあります。
中心吊り
1.上部チリ寸法が3ミリになるようにドアを吊込み、トップピポット上枠側のトップ軸をドア側の軸受けに挿入してください。この時、挿入がきちんとされているか確認をしてください。(下図:挿入確認方法)

2.上框の上部サイド穴(10φ)から、プラスドライバーで下図トップ軸の溝にネジがはまりこむように上框落下防止ネジを締め込んでください。

3.上框落下防止ネジを締め込み後、トップ軸操作ネジでトップ軸を上下させ、上へ抜けないか確認してください。
持出吊り

1.上部チリ寸法が3ミリになるようにドアを吊込み、トップ軸を軸受に挿入し締め込んでください。
2.トップ軸抜止めセットネジをしっかりと締め込んでください。
3.挿入したトップ軸の先端部にねじ込まれている上框落下防止ネジを、5ミリほど引き出してください。
-
ポリカーボネートは防火地域・法22条指定地域でも使用可能ですか?
可能です。防火地域、準防火地域または法22条区域における屋根用途(不燃性の物品を保管する倉庫等)に使用できます。一部使用できない場合があるため適用一覧表をご確認ください。
-
すりガラス風のアクリル板は製作できますか?
当店では、すりガラス風のアクリル板は扱っておりません。
すりガラスの見た目に近い、「両面マットホワイト」「両面マットクリア」のアクリルは取り扱っていますので、ご希望の方はお問い合わせください。

両面マットホワイト
両面マットクリア -
フロスト調のアクリルはありますか?

取り扱い可能です。厚みは 3ミリと 5ミリがございます。
厚み 3ミリ 寸法 1000ミリ × 2000ミリ 参考価格 18,900円
18,900円
取り扱い可能です。厚みは 3ミリと 5ミリがございます。
厚み 3ミリ 寸法 1000ミリ × 2000ミリ 参考価格 18,900円
18,900円 -
アクリル板に文字入れ・名入れはできますか?
はい、可能です。
カッティングシートを貼り付けることで、アクリル板に文字入れ・名入れをすることができます。
当店ではカッティングシートの貼り付けを行っていますので、ご希望の方はお問い合わせください。

-
アクリルも広幅面取り加工は出来ますか?
アクリルは広幅面取り加工が出来ません。ガラス専用の加工になります。
-
アクリルでガラスケース用のガラスは作れますか?
可能です!当店で取り扱っているアクリルには「無色透明」はもちろん「ガラス色」という色がございます。
ガラス色のアクリルだと、一見ガラスと見分けがつかないので、こちらを選ばれるお客様もいらっしゃいます。色の比較は、こちらをご覧ください。

透明

ガラス色
また、当店ではアクリルを使ったケースの製作も承っています。ご注文方法をわかりやすくまとめたページがありますので、アクリルケースのお求めの方はこちらをご覧ください。
-
アクリルパイプ(アクリル管・アクリル筒)はありますか?
-
円形(円盤)のアクリル板の製作はできますか?
はい、製作可能です。ご希望のサイズに合わせて、1ミリ単位で円形にカットして製作いたします。


-
アクリルの球、半球(ドーム状)は製作できますか?
アクリル球は対応いたしかねますが、半球(ドーム状)のアクリルは製作可能な場合がございます。
半球(ドーム状)のアクリルをご希望の方は外径・厚みをお伝えください。
-
円柱・角柱のアクリルの製作はできますか?
当店では、円柱・角柱のアクリルの製作は行っておりません。ご了承ください。
-
アクリル板は、引き戸やスライド扉に使えますか?
はい、使用いただけます。
アクリル板はガラスと同等の透明度のため、引き戸にご使用いただくことで開放感のある明るい室内になります。
また、耐衝撃性に優れており破損しにくいため、強くぶつかったりしても怪我をする危険性が低く、安心です。

-
アクリル板は、窓に使えますか?
はい、可能です。
当店では室内窓での使用をおすすめしております。アクリルはガラスと違い反りが出てしまうため、大きな面積での使用はおすすめしていません。小さい窓に使用する場合は、枠で固定することで安全にご使用いただけます。
外窓に使用いただくことは可能ですが、以下のような理由で当店ではあまりおすすめしておりません。
- アクリルはガラスに比べて、紫外線で劣化する
- 風が当たるとたわみによる音がでやすい
- ガラスと比べて柔らかいため、傷が付きやすい
- ガラスと比べて、火事の際に延焼しやすい
屋外に面する窓に、割れない透明な素材を希望される場合はポリカーボネートの使用をおすすめしております。
-
キッチンの油はねガードにアクリル板を使っても大丈夫ですか?
アクリルは耐熱温度が80℃とガラスと比べて低いため、熱で変形、変色する可能性があります。油はねガードとしての使用はおすすめしておりません。
シンクまわりなど、水はねをガードするためであれば、問題なくご使用いただけます。
こちらのページでキッチン油はねガードにおすすめのガラスをご紹介しています。油はねガードをお求めの方は、ぜひこちらをご覧ください。
-
アクリル板は、カーポートの屋根などに使えますか?
ご使用いただけますが、劣化するため長期使用は見込めません。
カーポートなどの屋根に、割れない透明な素材を希望される場合はポリカーボネートの使用をおすすめしております。
-
アクリル板は、床材に使えますか?
-
室内ドア・扉には「ガラス」「アクリル」のどちらが良いですか?
当店では、基本的にガラスをおすすめしております。
アクリル板は、割れてほしくない場所に採用いただくことが多いです。例えば、浴室などの肌を露出する場所は、破損して鋭い破片が飛び散ると特に怪我の危険性が高いため、アクリル扉が多く使用されます。
-
テーブル天板に使用する場合、厚みは何ミリが良いですか?
… -
テレビボードの扉としてアクリルを使用する際、リモコンの赤外線は透過しますか?
アクリルは赤外線を透過するため、テレビボードの扉にも使用していただけます。
-
アクリル板の重さはどれくらいですか?
アクリル板は、ガラス板の約半分の重さです。
アクリルの比重は1.19のため、幅・高さ・厚みがわかれば、以下の計算式で重さを求めることができます。
幅(メートル) × 高さ(メートル) × 厚み(ミリ) × 1.19=重量(kg)

例:幅900ミリ、高さ1800ミリ、厚み5ミリの場合
0.9メートル × 1.8メートル × 5ミリ × 1.19 ≒ 9.6(kg) -
ガラスよりアクリルが「傷が付きやすい」といいますがどの位ですか?
実験してみました。ガラスとアクリルを100円玉やカッターなどでひっかいてみた場合の傷の付き具合を動画で撮影しました。
-
ガラス色アクリルとガラスの見え方の違いは?

ガラスとガラス色アクリル「割れないガラス」を横に置いて比べてみました。
ここにクリックして拡大していただくとわかりやすいと思いますが、ほぼ同じように見えます。

ガラスとガラス色アクリル「割れないガラス」を横に置いて比べてみました。
ここにクリックして拡大していただくとわかりやすいと思いますが、ほぼ同じように見えます。
-
アクリルのサンプルはありますか?
当店の姉妹店「e-sample.jp」からサンプルを請求いただけます。
-
アクリル板の作り方の違いで「押出板」と「キャスト板」があると知りました。こちらで販売しているアクリル板はどちらですか?
当店では、「押出板」と「キャスト板」両方を取り扱っております。
お客様のご希望に合わせてご用意いたしますので、製法をご指定ください。
-
なぜアクリルよりガラスの方が価格が安いのですか?
アクリルはホームセンターなどでも売られているため、安いイメージがありますが、同じ厚みや同じサイズにした場合に、ガラスの方が安くなります。ただ、一般的なガラス屋さんでガラスを購入すると、問屋さんなどの中間マージンや輸送コストが発生する為、高くなる可能性がありますが、当店はガラス工場直送ですので、価格を安くご提供することが可能なのです。
-
アクリルのお手入れの仕方を教えてください
アクリルは傷がつきやすいため、水で薄めた中性洗剤を使用し柔らかい布で優しく拭き取ってください。シンナーやアルコールなどの溶剤を含む薬品等で拭かないでください。細かいヒビが入ったり、白く変色する恐れがあります。
-
アクリルパイプがどれくらい耐えられるのか「耐圧」を知りたいです
「耐圧」は下記の式で計算できます。「外径」や「肉厚」の単位が「cm(センチ)」であることに注意して計算してください。

計算例:
外径 2000ミリ (200センチ) 肉厚 15ミリ (1.5センチ) 長さ 1000ミリ (100センチ) 計算式から求められる耐圧は、0.055125MPaとなる。
-
アクリルパイプのお手入れ方法は?
アクリルは傷がつきやすいため、水で薄めた中性洗剤を使用し柔らかい布で優しく拭き取ってください。
※シンナーやアルコールなどの薬品等では拭かないでください。細かいヒビが入ったり、白く変色する恐れがあります。
-
アクリルパイプを屋外で使っても大丈夫ですか?
強い紫外線を受け続けると劣化が早まるため、屋外・屋内ともに、できる限り直射日光にさらされない場所で使用してください。
-
ガラスドアに使用するガラスのサイズの決め方は?
ドアのガラスサイズは、間口から上5ミリ、下10ミリ、戸尻8ミリ、戸先(ハンドル側)5ミリの隙間ができる寸法で作るのがオススメです。開口のサイズを教えていただければ、当社でサイズを計算いたします。
-
ペアガラスは紫外線カット(UVカット)できますか?

ペアガラスに使うガラスを「Low-Eガラス」にすると、65~75%ほど紫外線カット(UVカット)できます。
※ 遮熱効果のある特殊金属膜(Low-E膜)をコーディングしたガラス
「スペーシア」という商品ですと、紫外線を99%カットします。通常のペアガラスよりも薄いのに、窓サッシの交換がいらず、夏場・冬場に使えるのでオススメしています。
紫外線カットだけが目的ではないと思いますので、断熱・遮熱を兼ね備えたペアガラスのご提案もできます。当店の見積依頼フォーム、またはお電話「0120-12-4466」からお気軽にご相談ください。
-
網入りペアガラス(複層ガラス)はできますか?

「網入り複層ガラス(網入りペアガラス)」のご用意、お見積りも可能です。オーダーメイドになりますので、当社の見積依頼フォーム、またはお電話からお気軽にお申し付けください。
-
すりガラスのペアガラス(複層ガラス)はできますか?
はい、すりガラスのペアガラスのご用意・お見積りもできます。
目隠し用途でしたら、他のガラスが良い場合もありますので、まずは当店の見積依頼フォーム、またはお電話「0120-12-4466」からお気軽にお申し付けくださいね。
-
外から見えない目隠しできるペアガラス(複層ガラス)はできますか?
はい、できます。
目隠し用途に使えるガラスの種類、たくさんご用意しておりますので、どういったところでお使いになるか教えて下さい。アドバイスできます!
当店の当店の見積依頼フォーム、またはお電話「0120-12-4466」からご相談、お待ちしております。
-
型板ガラスのペアガラス(複層ガラス)、デザイン複層ガラスはできますか?

はい、型板ガラスのペアガラスのご用意・お見積りもできます。
当店は、デザイン柄の入った型板ガラスの取扱点数は圧倒的に多く、選べるガラスの選択肢がたくさんあります。
どんな柄があるのか、どんなガラスが適しているか、アドバイスできますので、まずは当店の見積依頼フォーム、またはお電話「0120-12-4466」にご相談ください。
はい、型板ガラスのペアガラスのご用意・お見積りもできます。
当店は、デザイン柄の入った型板ガラスの取扱点数は圧倒的に多く、選べるガラスの選択肢がたくさんあります。
どんな柄があるのか、どんなガラスが適しているか、アドバイスできますので、まずは当店の見積依頼フォーム、またはお電話「0120-12-4466」にご相談ください。
-
合わせガラスを使ったペアガラス(複層ガラス)はできますか?

はい、合わせガラスのペアガラスも当店からよく出ています。防犯性が気になる方には、合わせガラスの一種である「防犯ガラス」を組み合わせにご提案しております。
どういった目的で合わせガラスをお使いになるかでオススメが変わりますので、よかったらアドバイスさせてくださいね。当店の見積依頼フォーム、またはお電話「0120-12-4466」にお気軽にご相談ください。
-
合わせガラスとペアガラス(複層ガラス)の違いを教えてください。
どちらもガラスを2枚使っていますが、全くの別物。違いは「ガラスとガラスの間に何があるか」です。
合わせガラス ペアガラス(複層ガラス) 

ガラスとガラスの間にフィルムが入っている ガラスとガラスの間に隙間があり、乾燥空気などが入っている
※真空のものもある合わせガラス ペアガラス(複層ガラス) 

ガラスとガラスの間にフィルムが入っている ガラスとガラスの間に隙間があり、乾燥空気などが入っている
※真空のものもある -
ペアガラスからトリプルガラスに交換できますか?
交換可能です。
ですが、ペアガラスはガラスが2枚、トリプルガラスはガラスが3枚の複層ガラスなので、厚みが増した分、サッシもあわせて交換が必要です。
サッシの交換が伴う場合は、施工の心配などあると思いますので、まずは当店の見積依頼フォーム、またはお電話「0120-12-4466」にご相談ください。
-
ペアガラス(複層ガラス)に防犯性能はありますか?
フロートガラスのような単板ガラスが2枚で構成されるオーソドックスな複層ガラスだと防犯性能は無いです。単板のガラスにはもともと防犯性能はなく、それらを2枚並べたところで急に防犯性能が備わることはありません。
防犯性能のある複層ガラスはこの2つ

もともとは防犯性能が無い複層ガラスでも、防犯性能を高めるフィルムをガラスに貼ると防犯できるガラスになります。また、そもそも元から防犯性能に長けた商品に交換する手もあります。
- 今の複層ガラスに「防犯フィルム」を貼る
- 今の複層ガラスを「防犯ペアガラス」に交換する
当社の推しは「防犯ペアガラス」

防犯ペアガラスは、2枚のガラスの間に特殊フィルムを挟み、耐貫通性能を高めた防犯ガラスをペア加工したガラスです。泥棒の侵入でのガラス破りや台風での飛来物でガラスが割れるのを防ぎます。
-
防犯ガラスのペアガラス(複層ガラス)はできますか?
はい、できます。
防犯ガラスは合わせガラスの一種ですが、ガラスとガラスの間の特殊フィルムの厚みによって、「レベル1」「レベル2」「レベル3」のご用意があります。
型板仕様の防犯ガラスなどもできますので、組み合わせパターンのご提案もお任せください。
例.片面のガラス 防犯ガラス(レベル2) 型板ガラス 中空層 空気層 8ミリ もう片面のガラス 透明ガラス 5ミリ ご相談やお見積りは、当店の見積依頼フォーム、またはお電話「0120-12-4466」からお気軽にご連絡ください。
-
ペアガラス(複層ガラス)には、防音・遮音性能があるのですか?
物理的にガラスが2枚あるので、通常の1枚ガラスに比べて、防音・遮音性能は高いです。
ただし、騒音の聞こえやすい低音域では、ペアガラスの構造が起因して「低音域共鳴透過現象」が起きる場合があります。
2枚のガラス同士が中間にある空気層をバネのように介してお互いに共振する現象で、これが起きると、同じ厚みの単板(1枚)のガラスよりも遮音効果が下がってしまいます。

当社では、2枚のガラスの間に特殊フィルムを挟みこんだ防音ガラスをペア加工した「防音ペアガラス」も販売しております。
断熱性や防音性のあるガラスを探している方は、ぜひお電話・見積フォームからご相談ください。
-
アタッチメント付きのペアガラス(複層ガラス)はありますか?

はい、あります。
「アタッチメント付きペアガラス」は、ペアガラスを通常の窓サッシの溝幅9ミリにも取り付けができるように「アタッチメント」を付けたものです。アタッチメントは小さいため目立ちません。
※ ペアガラスはガラスが物理的に2枚になり、分厚くなるため、通常は窓サッシごとの交換が必要です。
アタッチメント付きペアガラスのお見積やご相談は、当店の見積依頼フォーム、またはお電話「0120-12-4466」からお気軽にご連絡くださいね。

はい、あります。
「アタッチメント付きペアガラス」は、ペアガラスを通常の窓サッシの溝幅9ミリにも取り付けができるように「アタッチメント」を付けたものです。アタッチメントは小さいため目立ちません。
※ ペアガラスはガラスが物理的に2枚になり、分厚くなるため、通常は窓サッシごとの交換が必要です。
アタッチメント付きペアガラスのお見積やご相談は、当店の見積依頼フォーム、またはお電話「0120-12-4466」からお気軽にご連絡くださいね。
-
アルゴンガス入りのペアガラス(複層ガラス)はありますか?

はい、あります。Low-E膜でコーティングされているので、遮熱効果も高めてあるペアガラスです。
アルゴンガス入りのペアガラスのお見積やご相談は、当店の見積依頼フォーム、またはお電話「0120-12-4466」で受け付けております。

はい、あります。Low-E膜でコーティングされているので、遮熱効果も高めてあるペアガラスです。
アルゴンガス入りのペアガラスのお見積やご相談は、当店の見積依頼フォーム、またはお電話「0120-12-4466」で受け付けております。
-
ペアガラス(複層ガラス)は、台風で割れることはありますか?
あります。大きな風によって物が倒れるなど、強い衝撃がガラスに加わると割れます。
ただし、万一割れても、ガラスが飛散しにくい「合わせガラス」を片面に使ったり、割れたガラスの破片が細かい粒状になりケガしにくい「強化ガラス」で安全性を高められます。
どういうガラスの組み合わせが安全になるかアドバイスできますので、万一の割れのことを考えてガラス選びに迷われましたら、当店の見積依頼フォーム、またはお電話「0120-12-4466」にてご相談ください。
-
窓をペアガラス(複層ガラス)に交換・リフォームしてもらうと、費用はどれくらい掛かりますか?
サイズによりますが、目安は22,000円(税込)~になります。
詳しい金額は、お見積が必要になりますので、当店の見積依頼フォーム、またはお電話「0120-12-4466」にてご相談ください。
-
窓に取り付ける際、どれくらいの幅(スペース)があれば、取り付けられますか?
70ミリ必要です。
70ミリ以下の場合は、幅を広くする「ふかし枠」を使用することで、取り付けられます。
-
波板ポリカを屋根に敷き詰めます。施工の際、上に人が乗っても大丈夫ですか?
問題ありません。
波板ポリカを屋根に直接敷き、たわまない状況であれば、乗っても問題ありません。 カーポートのように波板ポリカの下に支えがない場合は危険ですので乗らないでください。
-
アイアン窓の設置に来てくれませんか?
東京や大阪など一部の地域で可能です。価格は地域や設置するアイアン窓の枚数によって異なりますので、ご希望の方はお見積り致しますので、お気軽にお問い合わせください。 -
Low-E複層ガラスのLow-Eガラスは、室内・室外のどちらに設置すれば良いですか?
地域によって、オススメの向きが異なります。
Low-Eガラスは、温かい熱を跳ね返す効果があるガラスです。
東北地方や北海道であれば、LoW-Eガラスの効果を高めるため、室内側に向けます。それ以外の地域であれば、太陽の熱を跳ね返せるよう、室外側へ設置をおすすめします。
-
回収料はどのように支払いますか?
銀行振込またはクレジットカードでのお支払いに対応しています。
-
ガラスを注文せず、回収だけしてほしいのですが可能ですか?
ガラスの回収のみの場合も対応が可能です。
-
カラーガラスや複層ガラスなど、普通透明ガラス以外も回収してもらえますか?
普通透明ガラス以外の特殊なガラスも回収が可能です。回収を希望するガラスがある方は、一度お問い合わせください。
-
タッチ用ガラスとしても使用できますか?
タッチパネルの保護にお使いいただけます。ガラス越しの静電タッチの感度にも問題ありません。
-
耐熱ガラスの「溶融石英ガラス」「合成石英ガラス」は、何が違いますか?
「溶融石英ガラス」と「合成石英ガラス」の大きな違いは「透過率」です。
石英ガラスは不純物が少ないですが、「合成石英ガラス」は「溶融石英ガラス」に比べてさらに不純物が少なく高純度、透過度が高い石英ガラスです。
2つの耐熱ガラスに、波長の光(UV域)を当てたときの比較表がこちらです。

-
耐熱ガラス「石英ガラス」のガラス管はありますか?

石英ガラスを使った「石英ガラス管」は、当店姉妹店のガラス管の専門店「ガラス管.com」で取り扱っております。 サイズオーダーはもちろん、曲げ加工や接着、口封じなどの特殊加工もできます。
-
内窓にした場合、防音効果はどれくらい変わりますか?
外窓のみの場合と内窓をつけた場合の防音効果のグラフです。内窓に防音ガラスを使用することで防音効果がより高まります。

-
納期はどれぐらいですか?
9日~14日程度でのお届けになります。
-
ガラスの施工を依頼する方法を教えて。

無料お見積りフォームにて、お問い合わせを受け付けています。
施工を希望する商品の詳細と、備考欄に「施工希望」と入力してお送りください。
-
窓枠の幅が狭いのですが、二重窓を取り付けできますか?
ふかし枠を取り付けることにより可能になります。
内窓(二重窓)を取り付けるには、窓枠の幅が70ミリ必要です。
窓枠の幅が狭い(70ミリ以内)の場合、ふかし枠と呼ばれる枠を取り付け、枠の幅を増やします。ふかし枠は二重窓と同じカラーですので、見た目も綺麗になります。枠をふかすことで中間空気層が増え、防音効果が高まりますので、枠の幅が70ミリ以上あっても、ふかし枠を付けられるケースもあります。
-
窓枠の内側にカーテンレールが付いていますが、内窓は取り付けできますか?
はい。できます。
窓枠の内側にカーテンレールが付いている場合、内窓をつける為に移設が必要になります。※当社でも移設は可能ですが、若干の移設料が掛かります。
-
内窓の遮音性能はどの程度ありますか?
内窓のガラスが一番薄い3ミリ(mm)だとしても、約40dBもの音をさえぎることが可能です。
二重窓(内窓)の遮音性能のイメージ
騒音のレベル 感覚 具体例 80dB以上 極めてうるさい
(会話が聞き取れない)自動車の警笛
ガード下の電車の音
建設工事現場
電車の中80〜70dB うるさい
(集中力の低下)幹線道路の交差点
犬の吠え声70〜50dB やや気になる
(睡眠妨害)車の走行音程度
掃除機・洗濯機50〜40dB 静か 静かな事務所
図書館40dB以下 かなり静か 深夜の郊外 -
細長い窓に内窓を付けられますか?
開き窓最小サイズは横270ミリ、FIXの最小サイズは横200ミリとなっています。
-
お風呂の窓が内窓(引き違い)を付けられない形状ですが、設置は可能ですか?
浴室用は引き違いタイプしかご用意ができませんが、設置時にコーキングをすることで開き窓でも取り付け可能です。
この場合、個人での設置は難しいためご相談ください。 -
楽器の音を外に漏らしたくありません。オススメのガラスはありますか?
防音合わせガラスがオススメです。
-
内窓・防音合わせでデザインガラスを使用することはできますか?
可能です。こちらからご注文ください。
デザインガラス内窓について -
グリーン住宅ポイントの使用は出来ますか?
内窓設置(一部真空ガラス)は対象となっております。
-
ガスコンロの横など温度が高い場所に内窓をつけられますか?
窓枠が樹脂製のため、高温になるところはお勧めできません。
キッチンなど高温になる箇所にはペアガラスがオススメです。 -
内窓の組み立て方・取り付け方の説明書はありますか?
こちらの説明書をご覧ください。
内窓取り扱い説明書●組み立て説明書
・テラスドア
・開き窓
・FIX窓
・引き違い窓●取り付け説明書
・開き窓
・ふかし枠 20・50ミリ
・FIX窓
・テラスドア
・引き違い窓
・ふかし枠70ミリ
・連窓方立・コーナー方立・段窓無目
・ふかし枠(カーテンレール仕様)
・連窓方立・段窓無目(ふかし枠同時使用時)
・ふかし枠下部補強部材 -
アイアンフレームに裏表はありますか?
ビス穴がある面が裏です。メインの部屋に表側が見えるように施工してください。

-
自分でアイアンフレームにガラスを取り付ける場合の方法は?
フレームにマスキングテープで養生していただき、コーキングを行なってください。

-
納期はどれくらいですか?
納期は20〜25日です。
-
波板のサイズを教えてください
ピッチ32ミリ、谷深さ9ミリになります。

-
希望サイズぴったりに製作は可能ですか?
縦方向のカットの場合、山の頭でカットを行うため多少の寸法公差がでます。 あらかじめご了承ください。

-
波板を重ねて取り付けする際はどれくらい重ねますか?
2.5山以上重ねることが多いです。有効幅576ミリ (mm) と計算します。
重ねることで雨や風などの侵入を防ぎ、バタつきも抑えられます。(例)
5m分の幅に波板を使う場合
5000mm÷576=8.68なので切り上げて9枚必要となります。
-
流れ(縦)方向に重ねて取り付ける際はどれくらい重ねますか?
設置する場所の勾配によって異なります。

※雨漏り防止のため、水下(風下)側から葺いてください。
-
波板ポリカに雪などの荷重がかかるとどうなりますか?
大きな荷重を受けた場合、ガラスのように割れることはありませんが、たわむ可能性があります。カーポートや屋根材に使用する場合は、傾斜をつけたり、骨組みを増やすなどして対策を行なってください。
-
穴あけ加工は可能ですか?
可能です。当店で穴あけも可能ですが、施工時にお客様で穴あけを行うことをお勧めしています。
-
ポリカーボネートのお手入れ方法を教えてください
ポリカーボネートの表面には、細かな凹凸があり傷つきやすいため注意が必要です。お手入れの際は、中性洗剤(1~2%)を溶かしたぬるま湯に柔らかい布をつけて優しく拭いてください。シンナー、除光液、漂白剤などが付着すると、割れや変色の原因になりますのでご注意ください。
-
断面に違いはありますか?
「タフネス クリア」のみ他の中空ポリカと断面の構造が異なります。

-
中空ポリカのお手入れは?
中空ポリカは傷つきやすいため注意が必要です。
お手入れの際は、柔らかいスポンジや布を水に浸し表面の汚れを落としてください。汚れが落ちない場合は、中性洗剤(1~2%)を水に混ぜていただくと汚れが落ちやすくなります。※ シンナー、除光液、漂白剤などが付着すると、割れや変色の原因になりますのでご注意ください。
-
ポリカーボネートと中空ポリカの違いは?
軽量な点と見た目が違いです。中空ポリカはポリカーボネートを使用した二重構造の板材のため、強度や耐熱性などに違いはありません。
-
中空ポリカの欠点は?
中空ポリカはガラスに比べて傷がつきやすい点がデメリットです。
また、水平に施工する場合リブ内にゴミが溜まりやすいため、「端部カバー ツインカバー」のご使用をお勧めします。 -
中空ポリカに雪などの荷重がかかるとどうなりますか?
大きな荷重を受けた場合、ガラスのように割れることはありませんが、たわむ可能性があります。カーポートや屋根材に使用する場合は、傾斜をつけたり、骨組みを増やすなどして対策を行なってください。
-
ポリカーボネートの欠点はありますか?
ポリカーボネートは、ガラスに比べて傷がつきやすく、薬品が付着することで変色する恐れがあります。
-
ポリカーボネートのお手入れ方法を教えてください
ポリカーボネートの表面には、細かな凹凸があり傷つきやすいため注意が必要です。お手入れの際は、中性洗剤(1~2%)を溶かしたぬるま湯に柔らかい布をつけて優しく拭いてください。シンナー、除光液、漂白剤などが付着すると、割れや変色の原因になりますのでご注意ください。 -
しばらく注文をしていないと会員ランクはどうなりますか?
会員ランクは累計期間は、現時点から3年前までを見ます。3年間の累計購入回数、お買上累計金額で会員ランクは変動します。 -
今「会員ランク」がどうなっているか、どこで確認できますか?
マイページの現在のランクをご覧ください。購入回数や購入金額もご確認いただけます。


-
「ブロンズ」から一気に「ゴールド」「プラチナ」にランクアップする ことはありますか?
お客様のご注文の条件を満たすと、一気に飛び級で会員ランクが上がることがあります。ご注文をいただくほど次回からのご購入がお得になっていきますので、ぜひ会員特典を存分にご活用ください。 -
ダクト穴付き断熱パネルの厚みについて教えてください。
断熱パネルの厚みは18ミリです。配管キャップを付けた厚みは31ミリです。


配管キャップのサイズは、右側の図の様になっております。ご不明な点がありましたら、お気軽にお問い合わせください!
配管キャップのサイズは、下記の図の様になっております。
 ご不明な点がありましたら、お気軽にお問い合わせください!
ご不明な点がありましたら、お気軽にお問い合わせください! -
単板のサッシに入れることができますか?
単板のサッシは一般的に開口が9ミリのものが多いため、ダクト穴付き断熱パネルを入れることができません。
断熱パネルの厚みが18ミリありますので、18ミリ以上のサッシ開口が必要です。
-
ダクト穴付き断熱パネルは自分で切断して調整できますか?
-
穴の位置を指定することはできますか?
穴あけ位置の指定は可能です。
穴あけをご指定いただく場合は図面か簡単な図をFAXかスマートフォンなどで撮影して送っていただけると幸いです。
FAX 0776-54-4566 か、見積フォームからお送りください。 -
ビスは付属していますか?
付属しております。
「M3 x 12ミリ のステンレス皿ビス」、「M4 x 20ミリ のステンレス皿ビス」の2種類をご用意しております。 -
コの字チャンネルを「ビスを使わず」取り付けできますか?
コの字チャンネルをビスを使わず取り付けるには、建築用の強力両面テープとシリコーンを使って取り付けて下さい。


上の図のように、コの字チャンネルの裏面に両面テープを貼り、取り付け位置に取り付けます。最後に取り付け位置とコの字チャンネルの間をシリコーンで固定すれば完成です。
-
緩衝材は何を使えばいいですか?

設置の際には、セッティングブロックを使用します。
-
コーキングは何を使えばいいですか?

ガラスを固定して、アングルに水や油が侵入するのを抑える為には、シリコーンでコーキング(シーリング)する必要があります。使うシリコーンは耐水性や耐熱性があり、ホルムアルデヒド等の有害物質を含まないシリコーンの使用をお勧めいたします。
-
ステンレスとアルミ、どちらがオススメですか?
お使いいただく場所によって、オススメな材質は異なります。
下記の表をご覧ください。ステンレス アルミ 価 格 高い 安い 重 さ 重い 軽い 腐食性 腐食しづらい 腐食する 熱特性 熱くなりづらく、冷めづらい 熱くなりやすく、冷めやすい 傷付き 付きにくい 付きやすい ご利用シーン キッチン周り・水周り・浴室 室内間仕切り -
ガラスの大きさの決め方は?
間口と行う工法によってガラスサイズを確定していきます。
厚み 間口の縦幅が 750ミリ以下 厚み 5ミリ 間口の縦幅が 751~1500ミリ 厚み 8ミリ 横幅 間口(横幅)の寸法 - 2ミリ
※余裕を見てレールより左右1ミリずつ(計2ミリ)小さくします縦幅(高さ) スライド工法 縦幅の寸法 - 10ミリ ケンドン工法(厚み 5ミリ) 縦幅の寸法 - 13ミリ ケンドン工法(厚み 8ミリ) 縦幅の寸法 - 14ミリ 間口と行う工法によってガラスサイズを確定していきます。
厚み 間口の縦幅が
750ミリ以下厚み 5ミリ 間口の縦幅が
751~1500ミリ厚み 8ミリ 横幅 間口(横幅)の寸法 - 2ミリ
※余裕を見てレールより左右1ミリずつ(計2ミリ)小さくします縦幅(高さ) スライド工法 縦幅の寸法 - 10ミリ ケンドン工法
(厚み 5ミリ)縦幅の寸法 - 13ミリ ケンドン工法
(厚み 8ミリ)縦幅の寸法 - 14ミリ ガラスを横から滑らせる形でコの字チャンネルにはめ込む工法です。設置する幅の横にガラスが入る空間が必要となります。
上のアングルにいったんガラスを上げて下のレールに落とし込む工法です。ケンドン工法の施工方法はこちらで紹介しています。
スライド工法って?
 ガラスを横から滑らせる形でコの字チャンネルにはめ込む工法です。 設置する幅の横にガラスが入る空間が必要となります。
ガラスを横から滑らせる形でコの字チャンネルにはめ込む工法です。 設置する幅の横にガラスが入る空間が必要となります。ケンドン工法って?
 上のアングルにいったんガラスを上げて下のレールに落とし込む工法です。 ケンドン工法の施工方法はこちらで紹介しています。
上のアングルにいったんガラスを上げて下のレールに落とし込む工法です。 ケンドン工法の施工方法はこちらで紹介しています。 -
ホームページに載っている以外の形はできませんか?
できます。
ヨの字やカウンター型などさまざまご対応することができます。希望の形がありましたら、ご相談ください。 -
高さは、50センチから変更できませんか?
50センチから小さくしたり、大きくすることもできます。ご希望のサイズを教えていただきましたら、お見積りいたしますので、お申し付けください。
-
強化ガラス仕様にできませんか?
強化ガラスでのご用意もさせていただきます。
-
ガラスで手を切ることはありませんか?
ガラスの断面をキレイに磨いておりますので手が切れる心配はございません。
-
ガラス以外のご用意がありませんか?
「ツインカーボ (ポリカーボネート)」のご用意もできます。
ツインカーボは、AGC社製のポリカーボネート。ガラスに比べ、軽くて割れない素材です。グッドデザイン賞も受賞している優れもの。金具を使うことなく飛沫防止ができます。
価格やサイズなど、詳しくはお問い合わせください。
-
焼き場近くでも使えますか?
使えます。
強化ガラスに変更することで、200℃(度)まで耐えます。焼き場周りのガラスがご希望でしたら、0120-12-4466までお問い合わせください。
-
和紙ガラス(和風ガラス)は自分で切断できますか?
和紙ガラス(和風ガラス)は2枚のガラスを使用していますので、切断することが出来ません。オーダーメードでの制作になります。
-
和紙ガラス(和風ガラス)に自分で穴を開けることは出来ますか?
和紙ガラス(和風ガラス)はご自分で穴を開けることは出来ません。穴あけが必要な場合は、注文の際に穴あけをご指示下さい。
-
外装にも使えますか?
もちろん屋外でも使用可能です。
外装に使用する場合は外装仕様にて製造させていただきますので、ご注文時に指定して下さい。 -
ぼかし山水ガラスは自分で切断できますか?
ぼかし山水ガラスもガラスカッターという道具を使って、ご自分で簡単に切断することが可能です。切断する場合は、ツルツル面の方をガラスカッターで傷をつけて切断してください。
ガラスの切断方法はガラスのホームセンター「ギヤマン」で動画でご覧いただけます。 -
障子用ガラス(ぼかし山水)のサイズオーダーは可能ですか?
障子用ガラス(ぼかしガラス)は版のサイズが決まっているため、サイズの縮小、拡大は出来ません。周りをカットするサイズオーダーは可能ですので、お気軽にお問い合わせください。0120-12-4466
-
オリジナルの柄の障子用ガラスは作れますか?
条件付きですが、可能です。よく自宅の障子用のガラスが割れたので、同じような柄のガラスを作ってほしいという方がいらっしゃいます。

ただ、柄のような、複雑な柄は版を作る必要がありますので、製作することが出来ません。写真のような単純な柄は製作が可能です。
柄の写真等を送っていただければ、製作可能か判断致しますので、お気軽にお問い合わせください。
-
障子用ガラス(すりガラス)が汚れた場合の掃除方法は?
すりガラスの掃除方法は、下記の通りです。
- 水で2〜3倍に希釈した市販のガラス用洗剤をすりガラスに吹き付けます。
- スポンジでガラスを磨きます。
- タオル等で乾拭きして、乾燥させます。
こちらの動画で手順をご覧いただけます。
-
泡入りガラスはいつ入荷しますか?代替品はありませんか?

泡入りガラスは輸入ガラスで、価格の高騰が続いており、輸入の目処が立たない為、入荷時期も未定となっています。
代わりに、アルトドイッチェKというガラスが、程よく泡が入っており、価格もお安く人気のガラスで、代替え品として購入されるお客様も多くなっています。
-
泡入りガラスは自分で切断できますか?
このガラスもガラスカッターという道具を使って、ご自分で簡単に切断することが可能ですが、オーダーガラス板.comでは、ご希望のサイズでカット販売しておりますので、失敗のないオーダーメードをお勧めいたします。
ガラスの切断方法はガラスのホームセンター「ギヤマン」で動画でご覧いただけます。 -
泡入りガラスのサンプルはありますか?
約50×70ミリの無料サンプルを用意しました。無料サンプルをご希望の方は電話にてお申し付けください。
-
外装にも使えますか?
はい使用可能です。
ただ厚みのあるガラスではありませんので、強風や落雪のあるような場所ではご使用にならないようお勧めいたします。 -
泡入りガラスをペアガラス(複層ガラス)に出来ますか?
可能です。泡入りガラスをペアガラス(複層ガラス)にすることで、断熱効果や結露防止効果を高める事ができます。
0120-12-4466まで、お気軽にお問い合わせください。 -
昭和型板ガラスは凸凹していますが、自分で切断できますか?
はい、ガラスカッターというものを使えば切れます。
昭和型板ガラスは片面が凸凹していますので、凸凹した面ではなく、まっすぐな面をカットするようにしてください。
ガラスの切断方法はガラスのホームセンター「ギヤマン」で動画でご覧いただけます。
※型板ガラスは切断時に失敗の多いガラスです。自分で切断するよりも、オーダーサイズでの注文をおススメします。 -
昭和型板ガラスには、穴開けなど加工することは出来ますか?
不可能ではありませんが、表面が凸凹している為、失敗が多いので穴開けは不可だと思ってください。
-
昭和型板ガラスをペアガラス(複層ガラス)に出来ますか?
可能です。アンティークガラスをペアガラス(複層ガラス)にすることで、断熱効果や結露防止効果を高める事ができます。
0120-12-4466まで、お気軽にお問い合わせください。 -
昭和型板ガラスのサンプルはありますか?
当店の姉妹店の建材サンプルサイト「e-sample.jp」で請求いただけます。
-
昭和レトロガラスは自分で切断できますか?
ガラスカッターを使って切断することは可能ですが、昭和レトロガラスは切断面から塗料が剥がれるおそれがあります。
(当社は切断後に塗料加工)昭和レトロガラス レトロンは高価なガラスですので失敗の可能性がありますのでご自分で切断されることはおすすめできません。
-
昭和レトロガラスの歪みはどんな感じですか?サンプルはありますか?
当店の姉妹店の建材サンプルサイト「e-sample.jp」で請求いただけます。
-
外装にも使えますか?
はい使用可能です。
ただ厚みのあるガラスではありませんので、強風や落雪のあるような場所ではご使用にならないようお勧めいたします。塗料を使った昭和レトロ風ガラスは塗装面を室内側に向けてお使いください。 -
昭和レトロガラスをペアガラス(複層ガラス)に出来ますか?
可能です。昭和レトロガラスをペアガラス(複層ガラス)にすることで、断熱効果や結露防止効果を高める事ができます。
0120-12-4466まで、お気軽にお問い合わせください。 -
昭和レトロガラスの強化加工は出来ますか?
強化加工が出来る場合と出来ない場合がございます。
品名 厚さ 加工可否 SRG-002
昭和レトロ風ガラス5ミリ ○ 3ミリ × SRG-003
昭和レトロガラス
(レトロン)5ミリ × 3ミリ × -
以前販売されていた昭和レトロガラス フルートはもうありませんか?
以前販売していた縦方向にゆがみの強い昭和レトロガラス(スペクトラム フルート)は、メーカーの生産が終了しましたので、販売を終了させて頂きました。
-
フローラガラスは自分で切断できますか?
このガラスもガラスカッターを使って自分で切断することも可能ですが、デコボコが多いため、切断の失敗の可能性があります。高価なガラスですので、自分でお切りにならずに、当社でオーダーサイズでご注文されることをお勧めいたします。
ガラスの切断方法はガラスのホームセンター「ギヤマン」で動画でご覧いただけます。 -
フローラガラスの柄が少し伸びて見えるのですが?
フローラガラスは製法上、ロットごとに、写真のように柄が若干縦に伸びたり、横に伸びたりするガラスです。 並べて使われる場合は同時期にご購入されることをおすすめいたします。また、縦横をご注意頂く必要がございますので、注文時にスタッフにお問い合わせください。
-
フローラガラスのサンプルはありますか?
無料サンプルのご用意も可能です。姉妹店「e-sample.jp」で請求できますので、ご覧ください。
-
外装にも使えますか?
はい、使用可能です。
ただ厚みのあるガラスではありませんので、強風や落雪のあるような場所ではご使用にならないようお勧めいたします。 -
フローラガラスをペアガラス(複層ガラス)に出来ますか?
可能です。フローラガラスをペアガラス(複層ガラス)にすることで、断熱効果や結露防止効果を高める事ができます。
0120-12-4466まで、お気軽にお問い合わせください。 -
モールガラスは自分で切断できますか?
モールガラスもガラスカッターという道具を使って、ご自分で簡単に切断することが出来るのですが、縦にラインが入っていますので、そのラインに沿ってガラスが割れてしまうことがあります。大変失敗の多いガラスですので、オーダーサイズで購入されることをお勧めします。ご自分でカットされる場合は、デコボコ面ではなく、ツルツル面をカットしてください。
ガラスの切断方法はガラスのホームセンター「ギヤマン」で動画でご覧いただけます。 -
もっとストライプの幅の狭い(広い)モールガラスはありませんか?
モールガラスではありませんが、似たようなストライプのガラスがあります。アンティークガラスコーナーで紹介していますのでそちらをご覧ください。
-
モールガラスをペアガラス(複層ガラス)に出来ますか?
可能です。モールガラスをペアガラス(複層ガラス)にすることで、断熱効果や結露防止効果を高める事ができます。
0120-12-4466まで、お気軽にお問い合わせください。 -
チェッカーガラスは自分で切断できますか?
チェッカーガラスはガラスカッターで切断することが出来るのですが、チェックラインがある為、切断の失敗の多いガラスです。当社ではオーダーメードでチェッカーガラスを制作することが出来ますので自分でお切りになることはお勧めしません。もし自分で切られる場合はデコボコ面の裏を切断してください。
ガラスの切断方法はガラスのホームセンター「ギヤマン」で動画でご覧いただけます。 -
チェッカーガラスに引き手加工をすることは出来ますか?
チェッカーガラスを食器用の戸棚にする場合に、ガラスを少し削って、指が入るようにする「引き手加工」という加工があります。チェッカーガラスもこの加工が出来ますので、戸棚の扉として使うことができます。
-
チェッカーガラスに穴あけは出来ますか?
穴径によっては可能です。一度お問い合わせください。
-
チェッカーガラスをペアガラス(複層ガラス)にできますか?

「チェッカーガラス(リストラルM)」と「透明ガラス」のペア加工でご用意が可能です。柄入りのペアガラス(複層ガラス)にしつつ、結露防止、断熱効果を高めたいお客様から喜んでいただいております。

柄入りのペアガラスは「リストラルM」以外のデザインガラスでもご用意可能です。

規格品として、デザインガラスとLow-Eガラスの複層ガラス「デザートペア」という商品もあり、人気のガラスで全20種類ご用意しておりますので、ご覧ください。
-
チェッカーガラスのデコボコ面両方にあるのですか?
それぞれのガラスにより異なります。
チェッカーガラス(リストラルM)
→ 凹凸が大きい面と小さい面があります。凹凸が大きい面が表になります。チェッカーガラス(リストラルF・リストラルD・リストラルK)
→ 表面に凹凸があり、裏面は平滑面となっています。 -
2枚のガラスの「柄の目合わせ」をしていただくことは可能ですか?

チェッカーガラスは、柄の目合わせが可能です。 右の写真のように建具等のガラスが2枚、横に並ぶ場合に、柄の目を揃えたいという方がいらっしゃいます。 柄の目合わせは一枚のガラスから連続して同じ大きさのガラスが2枚取れる場合のみ可能です。在庫のガラスの大きさによっては、目合わせがぴったり合わない場合がございますが、出来る限り合わせるよう致します。
必要な方は 0120-12-4466 までお問い合わせください。

-
柄の目合わせは「縦・横両方」可能ですか?
目合わせ加工は、縦方向・横方向のどちらか一方のみとなります。
目合わせ加工は、縦方向・横方向のどちらか一方のみとなります。

柄を横方向で目合わせした場合
縦方向の目合わせは出来ません
柄を縦方向で目合わせした場合
横方向の目合わせは出来ません -
目合わせをすべきか悩んでいます
設置される場所、ご使用シーン、シチュエーションによって目合わせをすべきかどうかが変わります。 食器棚のような2枚のガラスを横や縦に並べて使用する場合は、目合せ加工をすることをオススメします。 ドアのように2枚のガラスを離して設置する場合は、目合わせが無くても問題ありません。
どのようにガラスを入れるかを教えていただければ、ご提案させていただきます。

-
窓ガラスにしたいですが、凸凹の面は家の外側?それとも内側?
汚れが付きにくいように家の内側を凸凹面にするように使います。
食器棚も同じように内側(食器側)を凸凹面にします。また引き手加工をすることが多いので、引き手加工の出来るまっすぐな面を外側に向けるように使います。 -
アンティークガラスは凸凹していますが、自分で切断できますか?
はい、ガラスカッターというものを使えば切れます。
アンティークガラスは片面が凸凹していますので、凸凹した面ではなく、まっすぐな面をカットするようにしてください。キャセドラルはステンドグラスでよく利用されるガラスです。数あるガラスの中でも切りやすいガラスと評判です。ガラスの切断方法はガラスのホームセンター「ギヤマン」で動画でご覧いただけます。
※型板ガラスは切断時に失敗の多いガラスです。自分で切断するよりも、オーダーサイズでの注文をおススメします。
-
アンティークガラスには、穴開けなど加工することは出来ますか?
不可能ではありませんが、表面が凸凹している為、失敗が多いので穴開けは不可だと思ってください。
-
アンティークガラスをペアガラス(複層ガラス)に出来ますか?

可能です。アンティークガラスをペアガラス(複層ガラス)にすることで、断熱効果や結露防止効果を高める事ができます。
0120-12-4466まで、お気軽にお問い合わせください。 -
カラー合わせガラスは外装で使用できますか?
状況によりますので、0120-12-4466まで一度お問い合わせ下さい。
-
カラー合わせガラスは自分で切断できますか?
カラー合わせガラスは2枚のガラスを使用した合わせガラスですので、切断することが出来ません。オーダーメードでの制作になります。
-
カラー合わせガラスに穴あけは可能ですか?
カラー合わせガラスはご自分で穴を開けることは出来ません。穴あけが必要な場合は、注文の際に穴あけをご指示下さい。
-
カラー合わせガラスを強化ガラスに加工することは出来ますか?
カラー合わせガラスを強化ガラスに加工することは可能です。
強化ガラスをご希望の場合はお気軽にお問合せください。 お電話 0120-12-4466 -
カラー合わせガラスのサンプルはありますか?
当店の姉妹店の建材サンプルサイト「e-sample.jp」で請求いただけます。
-
カラーのオーダーは可能ですか?
テスト的にカラーのオーダーを始めてみました。 カラーサンプルをお届けし、その中から色をお選び頂く形になります。
お見積、お問い合わせは0120-12-4466までお気軽にどうぞ。 -
ガラスに色ムラや小さなホコリがあるそうですが、どの程度ですか?
確実にムラがでたりホコリが混じったりする訳ではありません、ガラスの大きさが大きくなればなるほど、可能性は高くなって来ます。あまりにも大きなホコリの混入や色ムラはこちらで取り除きますが、品質の価値観の違いが、お客様と当社で異なる可能性もございます。人の目に触れない場所で使用されるか、品質の高いカラー合わせガラスをご利用ください。
-
カラークリアガラスは自分で切断できますか?
ガラスカッターというものを使って自分で切断することも可能ですが塗料が剥がれる恐れがありますので、 自分でお切りにならずに、当社でオーダーサイズでご注文されることをお勧めいたします。
ガラスの切断方法はガラスのホームセンター「ギヤマン」で動画でご覧いただけます。 -
カラークリアガラスに穴あけは可能ですか?
カラークリアガラスに穴を開けることは可能です。穴あけが必要な場合は、注文の際に穴あけをご指示下さい。
-
カラークリアガラスを強化ガラスに加工することは出来ますか?
カラークリアガラスを強化ガラスに加工することは可能です。実際にはオーダーサイズの強化ガラスに塗装をするのでいろいろな加工が可能です。
-
カラークリアガラスは外装で使用できますか?
直接外装や水周りに使うことは出来ませんが、シーリング等しっかりしていただければ可能かと思います。ペアガラスにすることで外装に使うことも可能です。
状況によりますので、0120-12-4466まで一度お問い合わせ下さい。 -
ペアガラスにすることは可能ですか?
可能です。ペアガラスに加工することで、外装で使うことも可能になります。カラークリアガラスのペアガラスについてはお気軽にお問合せください。 お電話 0120-12-4466
-
カラークリアガラスのサンプルはありますか?
カラークリアガラスは、サンプルガラスをレンタルでお貸しすることができます。お電話でお申し付けください。
-
塗装カラーガラス「彩」は自分で切断できますか?
ガラスカッターというものを使って自分で切断することも可能です。
高価なガラスですので、自分でお切りにならずに、当社でオーダーサイズでご注文されることをお勧めいたします。
ガラスの切断方法はガラスのホームセンター「ギヤマン」で動画でご覧いただけます。 -
接着剤は何を使えばよいですか?
接着剤はPOSシール(グレー色)を使用してください。また、ミラーマットもグレー色をおすすめ致します。
-
塗装カラーガラスを取り付ける下地の色はなにがよいですか?
白色系の下地はミラーマットや接着剤の影が映る可能性があるので避けてください。下地の色と接着剤の色によっては透ける場合がありますので、濃いグレー色の下地をおすすめします。また、光が裏面に回るなど照明環境も影響します。できれば下地材色、接着剤色、カラーガラスの組み合わせを事前に確認する事をおすすめします。
-
塗装カラーガラス「彩」に穴あけは可能ですか?
塗装カラーガラス「彩」に穴を開けることは可能です。穴あけが必要な場合は、注文の際に穴あけをご指示下さい。
-
カラーガラス「彩」を強化ガラスに加工することは出来ますか?
塗装カラーガラス「彩」を強化ガラスに加工することは可能です。実際にはオーダーサイズの強化ガラスに塗装をするのでいろいろな加工が可能です。
-
塗装カラーガラス「彩」を外装や水周りに使うことは出来ますか?
塗装カラーガラス「彩」は外装や水周りに使うことことは出来ません。水周りで使われる場合はシーリング等で水が裏面に侵入しないようにご使用ください。
-
塗装カラーガラス「彩」のサンプルはありますか?
当店の姉妹店の建材サンプルサイト「e-sample.jp」で請求いただけます。
-
カラーのオーダーは可能ですか?
テスト的にカラーのオーダーを始めてみました。電話やメールでのやり取りで色を打ち合わせする為、実際思われているの色と若干異なる可能性がございますことをご了承下さい。
お見積、お問い合わせは 0120-12-4466までお気軽にどうぞ。 -
カラーガラス ラコベルプリュムは自分で切断できますか?
カラーガラス ラコベルプリュムはガラスカッターという道具を使って、ご自分で簡単に切断することが可能です。ガラス面からカットしてください。
当社が運営するサイトにて「DIYにもオススメ!カラーガラス「ラコベルプリュム」のカット方法」で、画像と動画でわかりやすく説明していますので、ご覧ください。
-
カラーガラス ラコベルプリュムに穴あけは可能ですか?
残念ながら、このガラスにはドリルでの穴あけをすることができません。ガラスサークルカッターのみ穴あけは可能です。
-
カラーガラス ラコベルプリュムを強化ガラスに加工することはできますか?
カラーガラス ラコベルプリュムはガラスの厚みが薄いため、強化ガラスに加工することはできません。
-
カラーガラス ラコベルプリュムを外装や水周りに使うことはできますか?
カラーガラス ラコベルプリュムを水周りで使われる場合はシーリング等で水が裏面に侵入しないようにご使用ください。
-
カラーガラス ラコベルは自分で切断できますか?
カラーガラス ラコベルはガラスカッターという道具を使って、ご自分で簡単に切断することが可能です。片面のみ凸凹していますので、まっすぐな面をカットしてください。
ガラスの切断方法はガラスのホームセンター「ギヤマン」で動画でご覧いただけます。 -
カラーガラス ラコベルに穴あけは可能ですか?
残念ながら、このガラスにはドリルでの穴あけをすることが出来ません。ガラスサークルカッターのみ穴あけは可能です。
-
カラーガラス ラコベルを強化ガラスに加工することは出来ますか?
カラーガラス ラコベルは塗装面を熱すると、色が変わってしまうため、強化ガラスに加工することは出来ません。
-
カラーガラス「ラコベル」のサンプルはありますか?
当店の姉妹店の建材サンプルサイト「e-sample.jp」で請求いただけます。
-
カラーガラス ラコベルを外装や水周りに使うことは出来ますか?
カラーガラス ラコベルを水周りで使われる場合はシーリング等で水が裏面に侵入しないようにご使用ください。
-
ビトロカラーガラスは自分で切断できますか?
ビトロカラーガラスはガラスカッターという道具を使って、ご自分で簡単に切断することが可能です。片面のみ凸凹していますので、まっすぐな面をカットしてください。
ガラスの切断方法はガラスのホームセンター「ギヤマン」で動画でご覧いただけます。 -
ビトロカラーガラスに穴あけは可能ですか?
残念ながら、このガラスにはドリルでの穴あけをすることができません。ガラスサークルカッターのみ穴あけは可能です。
-
ビトロカラーガラスを強化ガラスに加工することはできますか?
ビトロカラーガラスは塗装面を熱すると、色が変わってしまうため、強化ガラスに加工することはできません。
-
ビトロカラーガラスのサンプルはありますか?
ビトロカラーガラスは、A6サイズのサンプルガラスをレンタルでお貸しすることができます。お電話でお申し付けください。
-
ビトロカラーガラスを外装や水周りに使うことはできますか?
ビトロカラーガラスを水周りで使われる場合はシーリング等で水が裏面に侵入しないようにご使用ください。
-
ホワイトガラスは自分でカット出来ますか?
はい、ガラスカッターというものを使って切断が可能です。ただ失敗の危険性がございます。ホワイトガラスは高価なガラスですので、オーダーサイズでご注文されることをお勧めいたします。
ガラスの切断方法はガラスのホームセンター「ギヤマン」で動画でご覧いただけます。 -
ホワイトガラスは屋外で使えますか?
塗装面を内側(室内側)にすれば使用出来ますが、塗装面は内側から見えてしまう為にお勧め出来ません。壁面などに使われるケースが多いです。高透過フロストガラス「マテラックス」は塗装面がない為、ご使用頂けます。
-
ホワイトガラスに穴あけは可能ですか?
可能です。高価なガラスの為、穴あけ加工したものをご注文されることをお勧めいたします。
-
セラミックプリントガラスは自分で切断できますか?
セラミックプリントガラスは、プリントする際に熱処理を加える為、強化ガラスと同等の性質を持ちます。よってセラミックプリントガラスはガラスカッターでは切断することが出来ません。ガラス切断後にプリント加工することになります。当社ではオーダーサイズでセラミックプリントガラスを製作することが可能です。
-
セラミックプリントはガラスの両面に印刷してあるのですか?
片面のみプリントしてあります。テーブルトップ(ガラス天板)などに使う場合は、プリント面を下にして使う場合が多いです。外装に使われる場合は、プリント面を室内側にしてご使用下さい。
-
プリント部分は爪などで引っ掻くと剥がれますか?
セラミックプリントは、とても強固な塗料です。爪で引っかいた程度では剥がれません。鋭利なもので、傷を付けると剥がれるというより、ガラスに傷がついたというイメージになります。ガラスの破損の恐れがありますので、通常のガラス同様取り扱いにはご注意下さい。
-
ストライプ柄を横向き(ボーダー柄)として使えますか?
ストライプ柄の場合は必ず、縦向きに使うのか横向きに使うのかご指定ください。
-
セラミックプリントガラスを外装や水周りに使うことは出来ますか?
繰り返し乾湿を繰り返す場所には使用いただけませんが、合わせガラスにすることにより水回りにも使用できます。ただし、プリントは片面しかしてありませんので、プリント面に水が掛からない状態であればご使用いただけます。
-
セラミックプリントガラスは水に濡れると色落ちしますか?
水に濡れても色落ちはしません。
セラミックプリントガラスは、セラミック塗料を焼き付けているため、退色・劣化しにくいガラスです。 -
カラードアンティークは自分で切断できますか?
カラードアンティークはガラスカッターという道具を使って、ご自分で簡単に切断することが可能です。片面のみ凸凹していますので、まっすぐな面をカットしてください。
ガラスの切断方法はガラスのホームセンター「ギヤマン」で動画でご覧いただけます。 -
カラードアンティークに穴あけは可能ですか?
残念ながら、このガラスにはドリルでの穴あけをすることが出来ません。ガラスサークルカッターのみ穴あけは可能です。
-
カラードアンティークの製作可能な最大サイズは?
商品によって異なります。
ほとんどのカラーは 1000ミリ × 1500ミリ ですが、クリア/0189、ライトアンバー/7086、イエロー/7172は 1400ミリ × 1600ミリ の大きさまで可能です。クリアの 6ミリ は、2100ミリ×1500ミリ まで可能です。 -
カラードアンティークのサンプルはありますか?
当店の姉妹店の建材サンプルサイト「e-sample.jp」で請求いただけます。
-
カラードアンティークは外装にも使えますか?
外装に使えます。しかし、風圧や雪荷重等が作用するような場所で単独で使用すると破損の恐れがあります。
凸凹面は汚れが付きにくいように家の内側にするように使います。 -
カラードアンティークをペアガラス(複層ガラス)に出来ますか?
可能です。カラードアンティークをペアガラス(複層ガラス)にすることで、断熱効果や結露防止効果を高める事ができます。
0120-12-4466まで、お気軽にお問い合わせください。 -
熱線吸収ガラスは自分で切断できますか?
熱線吸収ガラスもガラスカッターという道具を使って、ご自分で簡単に切断することが可能です。
ガラスの切断方法はガラスのホームセンター「ギヤマン」で動画でご覧いただけます。 -
熱線吸収ガラスに穴あけは可能ですか?
熱線吸収ガラスも通常のガラスと同じで、穴あけなどの加工が可能です。
-
熱線吸収ガラスを強化ガラスにすることは出来ますか?
熱線吸収ガラスも強化ガラス(強化色ガラス)にすることが可能です。強化加工後は切断や穴あけなどの加工をすることが出来なくなるため、加工がある場合は、前もって加工してから強化加工することになります。
-
熱線吸収ガラスをテーブルの天板として使えますか?
よく店舗のカウンターのガラスなどで、グレーやブロンズのカウンターを見かけると思いますが、この熱線吸収ガラスを利用して作られています。
テーブルトップ(テーブル天板)としても、使えますので、使う場合は厚みの厚い(5ミリ~12ミリ)ぐらいのガラスをお勧めします。 -
サンゴバン型板ガラスは自分で切れますか?
ガラスカッターというものを使って自分で切断することも可能ですが、デコボコが多いため、切断の失敗の可能性があります。高価なガラスですので、自分でお切りにならずに、当社でオーダーサイズでご注文されることをお勧めいたします。
ガラスの切断方法はガラスのホームセンター「ギヤマン」で動画でご覧いただけます。 -
ヨーロッパデザインガラスのサンプルはありますか?
大変高価なガラスなので、サンプル代金をいただいてお出ししております。当社に端材がある場合は、無償でお出しできますので、サンプルをご希望の方はお電話でお申し付けください。
-
デザインガラスには、穴開けなど加工することは出来ますか?
不可能ではありませんが、表面が凸凹している為、失敗が多いので穴開けは不可だと思ってください。
-
お風呂の窓に使いたいのですが、耐熱温度は何℃ですか?
熱温度はフロートガラスと同じで、常用温度110℃(度)、最高使用温度380℃(度)です。お湯の温度は沸騰しても100℃(度)ですので、お風呂の窓ガラスに使われても、温度で割れることはありません。ご安心ください。
-
デザインガラスをペアガラス(複層ガラス)にできますか?
可能です。デザインガラスをペアガラス(複層ガラス)にすることで、断熱効果や結露防止効果を高める事ができます。
※ デザインガラスによってはペア加工できないものもございますが、商品ごとにペア加工の製造可否が記載してあります。
-
ミストガラスは自分で切断できますか?
ミストガラスもガラスカッターという道具を使って、ご自分で簡単に切断することが可能です。型板ガラスは、片面が凸凹、もう片面がつるつるしていますので、つるつるした面をガラスカッターで傷をつけて切断してください。
強化ガラスタイプのミストロンは切断できませんのでご使用のサイズでご注文ください。
ガラスの切断方法はガラスのホームセンター「ギヤマン」で動画でご覧いただけます。 -
型板ガラスの耐熱温度は?お風呂でも使えますか?
ガラスの耐熱温度は『常用温度』と『最高使用温度』という2つのあらわし方があります。 簡単に言いますと、急激に熱した場合と、連続で熱した場合では割れる温度が違うと言うことです。
型板ガラスの耐熱温度は常用温度110℃(度)、最高使用温度380℃と言われています。
110℃(度)までなら大丈夫(110℃(度)以下なら急激な温度変化でもわれることは少ない)ですので、40℃(度)ぐらいのお風呂のお湯なら全く問題ありません。
ちなみに型板ガラスは視界を遮る為、お風呂ではよく利用されるガラスです。安心してお使いください。 -
ミストガラスを合わせガラスに出来ますか?
可能です。
ミストガラスを合わせガラスにすることで、防犯性能や、耐荷重、耐風圧など強度を高める事ができます。
フロートガラス3ミリ+ミストガラス3ミリの合わせガラスがおすすめです。
0120-12-4466まで、お気軽にお問い合わせください。 -
もっとオシャレな型板ガラスはありませんか?
普通の型板ガラスはデザインが古いので、おしゃれな型板ガラスを探されている方が多くいらっしゃいます。
当社ではヨーロッパから取り寄せた型板ガラス、ヨーロッパデザインガラスやチェックガラスの型板ガラス、チェッカーガラスなど取り扱っています。
デザイン性が高く、とても人気のあるガラスです。一度ご覧になってみてください。 -
抗菌ガラスはペアガラスに出来ますか?
もちろん可能です。抗菌ガラスをペアガラスしてお使いいただく場合は、内面のガラスをバイオクリーン、外面のガラスを通常ガラスにしてお使いください。
ご質問等ございましたら、0120-12-4466までお気軽にお問合せ下さい。 -
抗菌効果のある面は、片面ですか?両面ですか?
ウィルスクリーンの抗菌効果は片面になります。合わせガラスにした両面仕様にすることで、両面に抗菌効果をもたらすことが可能です。
両面仕様のお問い合わせは0120-12-4466までお気軽にお問合せ下さい。 -
抗菌ガラスは合わせガラスに出来ますか?
もちろん可能です。片面のみにウイルスクリーンを使った「片面仕様」と、両面にウイルスクリーンを使った「両面仕様」があります。
ご質問等ございましたら、0120-12-4466までお気軽にお問合せ下さい。 -
メンテナンス上の注意はありますか?
- 汚れの程度に応じてウイルスクリーンを清掃する場合、柔らかいスポンジときれいな水、または中性洗剤で表面の汚れを落とし、きれいな水ですすいでください。
- ウイルスクリーンはカッターナイフ等でコーティング面を擦るとキズが付きますので、ご注意ください。また、スキージーのご使用もお避けください。
- 砥粒を含んだ洗剤や酸、アルカリ度の強い洗剤のご使用はコーティング膜のキズの原因になりますので、絶対にお避けください。
- しっくいやモルタル等がガラス表面に付着し、乾燥すると除去が困難になります。薬品を使用して除去しますとコーティング面が侵されますので、付着した場合は乾燥する前に速やかにコーティング面にキズをつけないように中性洗剤でクリーニングしてください 。壁面リフォーム等の際にもガラス面の養生は十分に行なってください。
-
抗菌ガラスを「まな板」として使えますか?
抗菌ガラスを「まな板」として使いたいという方がいらっしゃいます。包丁などでコーティング面に傷がつくと、抗菌効果が薄れますので、包丁等の使用はお避け下さい。
-
カタログはありませんか?
下記のボウタンをクリックしてPDFでご覧いただけます。
-
光触媒ガラスを強化ガラスに出来ますか?
可能です。光触媒ガラスは強化ガラスに加工することが可能です。
トップライト等に使用する際にお勧めです。
ご希望の方は0120-12-4466までお気軽にお問合せ下さい。 -
光触媒ガラスはペアガラスに出来ますか?
もちろん可能です。光触媒ガラスをペアガラスしてお使いいただく場合は、外面のガラスをバイオクリーン、内面のガラスを通常ガラスにしてお使いください。
ご質問等ございましたら、0120-12-4466までお気軽にお問合せ下さい。 -
光触媒ガラスは合わせガラスに出来ますか?

もちろん可能です。通常のガラスはもちろん、強化ガラス等と合せることで、強度や耐風圧性能を高めることが可能です。また飛散防止効果も高い為、トップライトで光触媒ガラス+強化ガラスの合せガラスをご注文されるお客様が多いです。
ご質問等ございましたら、0120-12-4466までお気軽にお問合せ下さい。 -
光触媒ガラス(バイオクリーンガラス)は自分で切断できますか?
光触媒ガラスはガラスカッターという道具を使って、ご自分で簡単に切断することが可能です。
ガラスの切断方法はガラスのホームセンター「ギヤマン」で動画でご覧いただけます。 -
遮光ガラスで皆既日食など、太陽を観ることは出来ますか?

オーレクトロガラスは皆既日食などの太陽をみる為のガラスとしても使われています。保護レベルは14をお選びください。
-
溶接で使う場合、光の色は何色に見えますか?

グリーンになります。遮光ガラスにはオレンジに見えるものとグリーンに見えるものがあるのですが、グリーンはオレンジよりも目の疲れが少ないと、溶接工の方に大変好まれているカラーです。
-
遮光ガラスはどのような溶接に向いていますか?
遮光ガラスの溶接作業時の推奨適応保護レベルは以下のグラフの通りで、溶接の種類及びアンペア数により、推奨される保護レベルがことなります。溶接に遮光ガラス(オーレクトロガラス)を使われる場合、最高保護レベルの14をお選び頂くケースが殆どです。

-
プロタンというガラスは取り扱っていますか?
プロタンはメーカー廃盤になっています。変わりにオーレクトロガラスが使われています。
-
遮光ガラスの伝導性、吸収性能を教えて下さい
遮光ガラスの伝導性、吸収性能は以下のグラフの通りです。
- Spectral transmission degree:分光伝導率
- Wavelength:波長[nm]
- グラフ内数値:保護レベル

-
鉛ガラスの色が「黄色」に見えますが透明ではないのですか?

鉛ガラスは一般的なガラスの色と違って、鉛成分が入っている為「やや黄色の透明」の色になります。
-
鉛ガラス(放射線遮蔽ガラス)は、自分で切ることができますか?
カットは出来ますが、高価なガラスの為、自分でカットすることはお薦めしません。
オーダーサイズでの製作をお勧め致します。ご希望の場合は0120-12-4466までお気軽にお問合せ下さい。 -
鉛ガラス(放射線遮蔽ガラス)は穴を開ける事ができますか?
鉛ガラス、合わせ鉛ガラス、どちらも弊社で穴明け加工をする事は可能ですので、ご希望の場合は0120-12-4466までお気軽にお問合せ下さい。
-
鉛ガラス(放射線遮蔽ガラス)の厚さと鉛当量を教えて下さい
鉛ガラス(放射線遮蔽ガラス)の厚さと鉛当量は下記の表をご確認下さい。
製品の厚さは、X線では減衰能力が、γ線では実効線量透過率が等しい厚さ(鉛当量)を保証する厚さとなっています。鉛ガラス(放射線遮蔽ガラス)
厚さ
(ミリ)公差 鉛当量
(mmPb)備考 6.0 ±0.5 1.1 鉛当量はX線管電圧 60〜150kV、
γ線は 0.511MeV において保証7.0 ±0.5 1.5 9.0 ±0.5 2.0 11.0 ±0.5 2.5 14.0 ±0.5 3.0 鉛当量はX線管電圧 60〜200kV、
γ線は 0.511MeV において保証鉛ガラス 合わせタイプ(放射線遮蔽合わせガラス)
厚さ
(ミリ)公差 鉛当量
(mmPb)備考 11 ±1.2 1.1 鉛当量はX線管電圧 60〜150kV、
γ線は 0.511MeV において保証12 ±1.2 1.5 14 ±1.4 2.0 16 ±1.4 2.5 19 ±1.4 3.0 鉛当量はX線管電圧 60〜200kV、
γ線は 0.511MeV において保証鉛ガラス
(放射線遮蔽ガラス)厚さ
(ミリ)公差 鉛当量
(mmPb)備考 6.0 ±0.5 1.1 鉛当量はX線管電圧 60〜150kV、 γ線は 0.511MeV において保証 7.0 ±0.5 1.5 9.0 ±0.5 2.0 11.0 ±0.5 2.5 14.0 ±0.5 3.0 鉛当量はX線管電圧 60〜200kV、 γ線は 0.511MeV において保証 鉛ガラス 合わせタイプ
(放射線遮蔽合わせガラス)厚さ
(ミリ)公差 鉛当量
(mmPb)備考 11 ±1.2 1.1 鉛当量はX線管電圧 60〜150kV、 γ線は 0.511MeV において保証 12 ±1.2 1.5 14 ±1.4 2.0 16 ±1.4 2.5 19 ±1.4 3.0 鉛当量はX線管電圧 60〜200kV、 γ線は 0.511MeV において保証 -
鉛ガラス(放射線遮蔽ガラス)の性質は?
鉛ガラス(放射線遮蔽ガラス)の性質は下記の表をご確認下さい。
熱的特性 熱線膨張係数 (/℃) 80 ×10-7 (30〜380℃) 軟化点 (℃) 585 機械的特性 曲げ強度 (MPa) 25 ヤング率 (GPa) 63 ポワソン比 0.24 ヌープ硬度 370 光学的特性 屈折率 (Na-D線) 1.71 透過率 (波長550nm、%) ※185 ※1合わせタイプの透過率は88になります
鉛ガラス(放射線遮蔽ガラス)の性質は下記の表をご確認下さい。
熱的特性 熱線膨張係数
(/℃)80 ×10-7
(30〜380℃)軟化点 (℃) 585 機械的特性 曲げ強度 (MPa) 25 ヤング率 (GPa) 63 ポワソン比 0.24 ヌープ硬度 370 光学的特性 屈折率 (Na-D線) 1.71 透過率
(波長550nm、%)※185 ※1合わせタイプの透過率は88になります
-
鉛ガラス(放射線遮蔽ガラス)の透過率は、どれくらいですか?

透過率とは、光全体に対して、ガラスを透す(透過)光の率のことをいいます。
右図は、各、波長の光を当てた際に、通常の板ガラス(フロートガラス)と鉛ガラス(放射線遮蔽ガラス)がどれだけ光を透過したかを表した表です。 -
鉛ガラスはどのように捨てればいいですか?
地方自治体の許可を得た産業廃棄物収集運搬業者および産業廃棄物処分業者に、鉛成分を含むガラスくずとして管理型処分場への処分を委託してください。
または弊社までお送り頂ければ、廃棄処分をさせていただきます。
※弊社までの送料はお客様にてご負担をお願いいたします。 -
円形よりも四角形の方が高いのはなぜですか?

サファイヤガラスは、右のような円柱状のサファイアインゴットから切り出すために、円形のサファイアガラスよりも四角形のサファイアガラスの方が高価になります。
-
耐熱温度が高いようですが、耐熱ガラスとして使えますか?
サファイアガラスは耐熱温度が 2000℃(度)と高いですが、熱衝撃に弱い為、急激な温度変化に耐えることができません。ゆっくり 2000℃(度)にあがるような場所(高圧タンクの覗き窓や、高温装置のガラス)には使われています。
-
サファイアガラスの物理的特性は?
サファイアガラスと石英ガラスの物理性能の比較表です。
サファイア 石英 密度 3.98 g/cm3 2.20 g/cm3 硬度 (ビッカース) 22.5 Gpa (HV1(荷重=9.807N)) 8.9 Gpa 硬度 (モース) 9 (ダイヤモンド:10) 7 (ダイヤモンド:10) 曲げ強度 690 MPa 94.3 MPa 引張強度 2250 MPa 49 MPa 圧縮強度 2950 MPa 1130 MPa 溶融点 2053 ℃ 1720 ℃ 熱伝導率 42 w/m・k (20℃) 1.38 w/m・k (20℃) 25 w/m・k (100℃) 1.93 w/m・k (500℃) 比熱 750 J/(kg・℃) (25℃) 749 J/(kg・℃) (20℃) ※ ビッカース硬度(ビッカース硬さ):主に工業材料の硬さを表す尺度の一つ。押込み圧力に対する強度を示す。
※ モース硬度:主に宝石・鉱物の硬さを表す尺度の一つ。引っかき傷のつきにくさを示す。サファイアガラスと石英ガラスの物理性能の比較表です。
サファイア 石英 密度 3.98 g/cm3 2.20 g/cm3 硬度
(ビッカース)22.5 Gpa
(HV1(荷重=9.807N))8.9 Gpa 硬度
(モース)9
(ダイヤモンド:10)7
(ダイヤモンド:10)曲げ強度 690 MPa 94.3 MPa 引張強度 2250 MPa 49 MPa 圧縮強度 2950 MPa 1130 MPa 溶融点 2053 ℃ 1720 ℃ 熱伝導率 42 w/m・k
(20℃)1.38 w/m・k
(20℃)25 w/m・k
(100℃)1.93 w/m・k
(500℃)比熱 750 J/(kg・℃)
(25℃)749 J/(kg・℃)
(20℃)※ ビッカース硬度(ビッカース硬さ):主に工業材料の硬さを表す尺度の一つ。押込み圧力に対する強度を示す。
※ モース硬度:主に宝石・鉱物の硬さを表す尺度の一つ。引っかき傷のつきにくさを示す。 -
腕時計に使われるサファイアガラスのサイズと厚みは?
腕時計に使われるサファイアガラスのサイズと厚みは次のようになります。
ガラスサイズ(直径) ガラスの厚み Φ20ミリ 0.8ミリ Φ30ミリ 1.0ミリ Φ40ミリ 2.0ミリ -
サファイアガラスにできる加工は?
サファイヤガラスにできる加工は、切断加工、切削加工、円形加工、穴あけ、ネジ加工、面取り、曲面研削、段付加工になります。
-
ジェムカラーは自分で切断できますか?
丸ノコやジグソーで切断可能です。
-
樹脂ガラスは自分で切断できますか?
アクリルカッターで切断可能です。

アクリルカッター
720円(税別)ガラスと一緒にご注文が可能ですので、お気軽にお問い合わせください。
-
樹脂ガラスと型板ガラス(梨地)に見え方の違いはありますか?

樹脂ガラスの方が柄の凹凸が細かくなっています。
樹脂ガラスと型板ガラス(梨地)の見え方に大きな違いはありませんが、樹脂ガラスの方が柄が細かいためより目隠し効果が高いです。
-
切断面はどのようになりますか?
切断面は切りっぱなしとなりますが、ガラスのように手が切れたりはしません。
-
温度変化で伸縮しますか?
温度変化により伸縮しますので枠、ビス穴等は余裕を見てください。1メートルの長さのものが 10℃(度)の温度変化に対し 0.8ミリ程度
-
耐熱温度はどれくらいですか?
70℃(度)以上に温度が上がると変形する場合がございます。
-
レオフレックスはどの様な加工処理が出来ますか?
可能な加工処理は以下の通りです。
切り欠き、穴あけ加工 △ 加工制約があります 継ぎ目のない円筒形造作 × 曲げ加工 △ 加工制約があります 切断加工 △ 加工制約があります 合わせガラス加工 ◯ 鏡面加工 ◯ フィルム貼付 ◯ 片面・両面可能 可能な加工処理は以下の通りです。
切り欠き、 穴あけ加工 △ 加工制約があります 継ぎ目のない円筒形造作 × 曲げ加工 △ 加工制約があります 切断加工 △ 加工制約があります 合わせガラス加工 ◯ 鏡面加工 ◯ フィルム貼付 ◯ 片面・両面可能 -
レオフレックスの特性は?(その他の化学強化ガラスとの比較)
レオフレックスの特性と、その他の化学強化ガラスとの比較は以下の通りです。
ガラス名 化学強化ガラス ドラゴントレイル ゴリラガラス3 レオフレックス 最大サイズ 600×1000ミリ 700×700ミリ 370×470ミリ 700×1200ミリ 厚みの種類 - 0.5ミリ
- 0.55ミリ
- 0.7ミリ
- 1.1ミリ
- 0.55ミリ
- 0.7ミリ
- 0.8ミリ
- 1.1ミリ
- 0.55ミリ
- 0.7ミリ
- 0.85ミリ
- 1.1ミリ
- 1.3ミリ
主な用途 - タッチパネル用ガラス基板
- 光ディスク用ガラス基板
- センサー用カバーガラス
- スマートフォンやタブレットPC
- テレビのディスプレーガラス
- スマートフォンやタブレットPC
- テレビのディスプレーガラス
- 太陽電池モジュールのカバーガラス
- らせん階段のガラス手摺
- 建築や照明など
備考 ドラゴントレイルの建築用と言われている レオフレックスの特性と、その他の化学強化ガラスとの比較は以下の通りです。
ガラス名 化学強化ガラス ドラゴントレイル 最大
サイズ600×1000ミリ 700×700ミリ 厚みの
種類- 0.5ミリ
- 0.55ミリ
- 0.7ミリ
- 1.1ミリ
- 0.55ミリ
- 0.7ミリ
- 0.8ミリ
- 1.1ミリ
主な用途 - タッチパネル用ガラス基板
- 光ディスク用ガラス基板
- センサー用カバーガラス
- スマートフォンやタブレットPC
- テレビのディスプレーガラス
ガラス名 ゴリラガラス3 レオフレックス 最大
サイズ370×470ミリ 700×1200ミリ 厚みの
種類- 0.55ミリ
- 0.7ミリ
- 0.85ミリ
- 1.1ミリ
- 1.3ミリ
主な用途 - スマートフォンやタブレットPC
- テレビのディスプレーガラス
- 太陽電池モジュールのカバーガラス
- らせん階段のガラス手摺
- 建築や照明など
備考 ドラゴントレイルの建築用と言われている ガラス名 化学強化ガラス ドラゴントレイル
・レオフレックスゴリラガラス3 機
械
的
特
性密度 (g/cm3) 2.5 2.48 2.39 ヤング率 (GPa) 73 74 69.3 剛性率 (GPa) 30 30 28.5 ポアッソン比 0.21 0.23 0.22 ビッカース硬度(強化後) 580 673 649 熱
的
特
性熱膨張係数
(50-350℃×10-7/℃)85 98 75.8 軟化点 (℃) 733 831 900 徐冷点 (℃) 554 606 628 歪点 (℃) 511 556 574 光
学
的
特
性光弾性定数
(nm/cm Mpa)25.6 28.3 31.9 -
レオフレックスを大量に欲しいのですが、価格を教えてください
量産時ご発注ロットが 100枚/ロット 程度が目安で、5,000~10,000円/m²(平方メートル)となります。
-
Dragontrail(ドラゴントレイル)は、自分で切ることができますか?
Dragontrail(ドラゴントレイル)をガラスカッターで切断テストしてみましたが、切れるというより割れるという感じで、サイズが正確になりません。
切断にはかなりの熟練が必要だと感じます。また、切断面は強化ガラスでは無くなりますので、オーダーサイズで注文されることをお薦めします。オーダー品は、切断後に化学強化加工しています。
-
Dragontrail(ドラゴントレイル)は穴を開ける事ができますか?
Dragontrail(ドラゴントレイル)は自分で穴あけすることはできません。
弊社で穴明け加工をする事は可能ですので、ご希望の場合は0120-12-4466までお気軽にお問合せ下さい。 -
Dragontrail(ドラゴントレイル)の透過率は、どれくらいですか?

透過率とは、光全体に対して、ガラスを透す(透過)光の率のことを いいます。
右図は、各、波長の光を当てた際に、ソーダライムガラス(フロートガラス)とDragontrail(ドラゴントレイル)がどれだけ光を透過したかを表した表です。
-
Dragontrail(ドラゴントレイル)の性質は?
Dragontrail(ドラゴントレイル)の機械的、熱的、電気的性質をそれぞれ下記の表でご確認下さい。
Dragontrail(ドラゴントレイル)とSoda-lime(フロートガラス)の性質
特性 Dragontrail Soda-lime 機械的特性 密度 (g/cm3) 2.48 2.5 ヤング率 (Gpa) 74 73 剛性率 (Gpa) 30 30 ボアソン比 0.23 0.21 ビッカース硬度(強化前) 595 533 ビッカース硬度(強化後) 673 580 熱的特性 熱線膨張係数 (×10-7℃) 98 85 軟化点 (℃) 831 733 除冷点 (℃) 606 554 歪点 (℃) 556 511 光学特性 屈折率 (Nd) 1.51 1.52 光弾性定数 (nm/cm Mpa) 28.3 25.6 電気的特性 体積抵抗率 (Ω・cm) 8.4 8.5 Dragontrail(ドラゴントレイル)の機械的、熱的、電気的性質をそれぞれ下記の表でご確認下さい。
Dragontrail(ドラゴントレイル)とSoda-lime(フロートガラス)の性質
特性 Dragontrail Soda-lime 機
械
的
特
性密度 (g/cm3) 2.48 2.5 ヤング率 (Gpa) 74 73 剛性率 (Gpa) 30 30 ボアソン比 0.23 0.21 ビッカース硬度
(強化前)595 533 ビッカース硬度
(強化後)673 580 熱
的
特
性熱線膨張係数
(×10-7℃)98 85 軟化点 (℃) 831 733 除冷点 (℃) 606 554 歪点 (℃) 556 511 光
学
特
性屈折率 (Nd) 1.51 1.52 光弾性定数
(nm/cm Mpa)28.3 25.6 電
気
的
特
性体積抵抗率
(Ω・cm)8.4 8.5 -
ゴリラガラスの「未強化品」はありますか?
ゴリラガラスを強化加工する前の「未強化ガラス」の販売も可能です。
通常のガラスに比べて、化学強化加工が入りやすいガラスです。価格は数量によりますが、10枚ロッドで1枚単価1,700円程度になります。お気軽にお問い合わせください。 -
ゴリラガラス3は、自分で切ることはできますか?
ゴリラガラス3をガラスカッターで切断テストしてみましたが、切れるというより割れるという感じで、サイズが正確になりません。
切断にはかなりの熟練が必要だと感じます。また、切断面は強化ガラスでは無くなりますので、オーダーサイズで注文されることをお薦めします。オーダー品は、切断後に化学強化加工しています。 -
ゴリラガラス3に、穴を開けることはできますか?
ゴリラガラス3は自分で穴あけすることはできません。
弊社で穴明け加工をする事は可能ですので、ご希望の場合は0120-12-4466までお気軽にお問合せ下さい。 -
ゴリラガラス3の透過率は、どれくらいですか?
透過率とは、光全体に対してガラスを透す(透過)光の率のことをいいます。
図は、各波長の光を当てた際に、ゴリラガラス3がどれだけ光を透過したかを表した表です。
-
ゴリラガラス3の性質は?
ゴリラガラス3の機械的、熱的、光学的性質をそれぞれ下記の表でご確認下さい。
機械的特性 密度 (g/cm3) 2.39 ヤング率 (GPa) 69.3 剛性率 (GPa) 28.5 ポアッソン比 0.22 ビッカース硬度(強化前) 534 ビッカース硬度(強化後) 649 熱的特性 熱膨張係数 (0-300℃×10-7/℃) 75.8 軟化点 (℃) 900 徐冷点 (℃) 628 歪点 (℃) 574 光学的特性 光弾性定数 (nm/cm Mpa) 31.9 ゴリラガラス3の機械的、熱的、光学的性質をそれぞれ下記の表でご確認下さい。
機械的特性 密度 (g/cm3) 2.39 ヤング率 (GPa) 69.3 剛性率 (GPa) 28.5 ポアッソン比 0.22 ビッカース硬度
(強化前)534 ビッカース硬度
(強化後)649 熱的特性 熱膨張係数
(0-300℃×10-7/℃)75.8 軟化点 (℃) 900 徐冷点 (℃) 628 歪点 (℃) 574 光学的特性 光弾性定数
(nm/cm Mpa)31.9 -
ゴリラガラス3の電気特性は?
ゴリラガラス3の電気的性質を下記の表でご確認下さい。
周波数 (MHz) 比誘電率 誘電正接 54 7.59 0.22 163 7.48 0.22 272 7.44 0.21 381 7.42 0.22 490 7.38 0.21 599 7.37 0.22 912 7.30 0.23 1499 7.26 0.23 1977 7.23 0.23 2466 7.20 0.24 2986 7.19 0.25 -
化学強化ガラスは、自分で切ることができますか?
化学強化ガラスをガラスカッターで切断テストしてみましたが、切れるというより割れるという感じで、サイズが正確になりません。
切断にはかなりの熟練が必要だと感じます。また、切断面は強化ガラスでは無くなりますので、オーダーサイズで注文されることをお薦めします。オーダー品は、切断後に化学強化加工しています。 -
化学強化ガラスは穴を開ける事ができますか?
化学強化ガラスは自分で穴あけすることはできません。
弊社で穴明け加工をする事は可能ですので、ご希望の場合は0120-12-4466までお気軽にお問合せ下さい。 -
化学強化ガラス特性は?(ドラゴントレイル、ゴリラガラスとの比較)
特性 化学強化ガラス ドラゴントレイル ゴリラガラス3 機
械
的
特
性密度 (g/cm3) 2.5 2.48 2.39 ヤング率 (GPa) 73 74 69.3 剛性率 (GPa) 30 30 28.5 ポアッソン比 0.21 0.23 0.22 ビッカース硬度(強化後) 580 673 649 熱
的
特
性熱膨張係数 (50-350℃×10-7/℃) 85 98 75.8 軟化点 (℃) 733 831 900 徐冷点 (℃) 554 606 628 歪点 (℃) 511 556 574 光
学
的
特
性光弾性定数
(nm/cm Mpa)25.6 28.3 31.9 特性 化学強化ガラス ドラゴントレイル ゴリラガラス3 機
械
的
特
性密度 (g/cm3) 2.5 2.48 2.39 ヤング率 (GPa) 73 74 69.3 剛性率 (GPa) 30 30 28.5 ポアッソン比 0.21 0.23 0.22 ビッカース
硬度(強化後)580 673 649 熱
的
特
性熱膨張係数
(50-350℃×10-7/℃)85 98 75.8 軟化点 (℃) 733 831 900 徐冷点 (℃) 554 606 628 歪点 (℃) 511 556 574 光
学
的
特
性光弾性定数
(nm/cm Mpa)25.6 28.3 31.9 -
イーグルXGの光学特性を教えてください
イーグルXGの光学的特性は以下の通りです。

光学波長 nm(ナノメートル) 屈折率 435.8 nm 1.5198 467.8 nm 1.5169 480 nm 1.5160 508.6 nm 1.5141 546.1 nm 1.5119 589.3 nm 1.5099 643.8 nm 1.5078 -
イーグルXGの力学的、機械的特性は?
イーグルXGの力学的、機械的特性は下記の表をご確認下さい。
メートル法 ヤードポンド法 密度・比重 (20℃,68ºF) 2.38 g/cc 148.5 lb/ft3 ヤング率 73.6 GPa 10.7 ×106 psi 剛性率 30.1 GPa 4.4 ×106 psi ポアソン比 0.23 ビッカーズ硬度 640 イーグルXGの力学的、機械的特性は下記の表をご確認下さい。
メートル法 ヤードポンド法 密度・比重
(20℃,68ºF)2.38 g/cc 148.5 lb/ft3 ヤング率 73.6 GPa 10.7 ×106 psi 剛性率 30.1 GPa 4.4 ×106 psi ポアソン比 0.23 ビッカーズ硬度 640 -
イーグルXGの熱的特性を教えて下さい
イーグルXGの熱的特性は以下の通りです。
0-300℃ 31.7 ×10-7/℃ (0-300 ℃) 17.7 ×10-7/ºF (32-572 ºF) 室温 35.5 ×10-7/℃ 19.7×10-7/ºF 凝固点 25-675 ℃ 77-1247 ºF 0-300 ℃ 31.7 ×10-7/℃
(0-300 ℃)17.7 ×10-7/ºF
(32-572 ºF)室温 35.5 ×10-7/℃ 19.7 ×10-7/ºF 凝固点 25-675 ℃ 77-1247 ºF Temp (℃) 比熱 (J/gm-ºK) 熱拡散率 (cm2/sec) 熱伝導率 (W/cm-ºK) 23 0.768 0.00601 0.0109 100 0.896 0.00572 0.0122 200 0.998 0.00546 0.0129 300 1.067 0.00530 0.0134 400 1.110 0.00522 0.0137 500 1.154 0.00518 0.0142 Temp
(℃)比熱
(J/gm-ºK)熱拡散率
(cm2/sec)熱伝導率
(W/cm-ºK)23 0.768 0.00601 0.0109 100 0.896 0.00572 0.0122 200 0.998 0.00546 0.0129 300 1.067 0.00530 0.0134 400 1.110 0.00522 0.0137 500 1.154 0.00518 0.0142 作用点 (104po ise) 1293 軟化点 (107.6po ise) 971 焼鈍点 (1013po ise) 722 歪み点 (1014.5po ise) 669 -
薄板ガラスは表面研磨はできますか?
可能です。研磨することで厚みを調整したり、透過率や平面性をあげることができます。両面研磨・片面研磨も可能です。
-
更に薄いガラスはありませんか?
薄板ガラスは研磨することで更に薄くすることが可能です。
他に、「無アルカリガラス」では 0.3ミリや 0.4ミリのガラスが製作可能です。 -
薄板ガラスの価格の見方がわかりません
薄板ガラスは長辺の長さで価格が決まります。
例えば:90ミリ × 50ミリの長方形のガラスは長い 90ミリの辺が長辺、短い 50ミリの辺が短辺となります。
つまり、90ミリ × 50ミリの薄板ガラスと 90ミリ × 80ミリの薄板ガラスは同じ価格になります。 -
薄板ガラスは強化加工することが出来ますか?
可能です。薄板ガラスはケミカル強化加工という化学薬品による強化加工が可能です。ケミカル強化加工は、スマートフォンのガラスなどに使われる加工です。
-
耐熱ガラス「石英ガラス」は自分で切断できますか?
「石英ガラス」も「ガラスカッター」という道具を使って、ご自身で切断できます。切断する場合は、ツルツル面の方をガラスカッターで傷をつけて切断します。ガラスの切断方法は、当店姉妹店の「ガラスのホームセンター ギヤマン」で動画でご覧いただけます。
石英ガラスは高価なので、ご自身で切断するよりも、オーダーサイズでご注文いただくことをオススメしております。
-
耐熱ガラス「石英ガラス」のサイズオーダー注文はできますか?
石英ガラスはブロック状の塊から切り出すため、ブロックサイズ以内であれば、お好きなサイズでのオーダーは可能です。
お気軽にお問い合わせください。 -
耐熱ガラス「溶融石英ガラス」「合成石英ガラス」の透過率の違いは?
各、波長の光を当てた際に、石英ガラスがどれだけ光を透過したかを表した表になります。

-
溶融石英ガラスと合成石英ガラスの純度の違いは?
合成石英ガラスは溶融石英ガラスに比べ不純物が少ないのが特徴です。
溶融石英と合成石英の純度
溶融石英ガラス 合成石英ガラス Al 8 <0.01 Ca 0.6 <0.01 Cu <0.01 <0.01 Fe 0.2 <0.01 Na 0.6 <0.01 K 0.1 <0.01 Li <0.07 <0.01 Mg 0.04 <0.01 OH 200 1000 ※代表的分析値、単位:ppm
-
溶融石英ガラスと合成石英ガラスの性質の違いは?
合成石英ガラスは溶融石英ガラスの機械的、熱的、電気的性質をそれぞれ下記の表でご確認下さい。
溶融石英と合成石英の性質
溶融石英ガラス 合成石英ガラス 密度 g cm-3 2.2 2.2 機械的性質 ビッカース硬度 Mpa 8,900 8,900 ヤング率 Gpa 74 74 剛性率 Gpa 31 31 ボアソン比 0.17 0.18 曲げ強度 Mpa 94.3 94.3 圧縮強度 Mpa 1,130 1,130 引っ張り強度 Mpa 49 49 ねじり強度 Mpa 29 29 熱的性質 歪点 ℃ 1,070 970 除冷点 ℃ 1,180 1,080 軟化点 ℃ 1,720 1,720 平均熱線膨張率 ×10-7℃-1 5.9 4.7 比熱 20℃ J kg-1K-1 749 749 熱拡散率 19℃ ×10-7m2s-1 8.3 8.5 熱伝導率 19℃ W m-1K-1 1.38 1.38 粘度 (log η,1200℃) Pa s 11.72 10.6 電気的性質 誘電率ε1 500MHz 3.9 3.9 誘電体損失(tan δ) 500MHz <1 <1 体積抵抗 (25℃) Ω 3 × 10-15 5 × 10-15 体積抵抗率 (25℃) Ω・cm 5 × 10-16 1 × 10-17 合成石英ガラスは溶融石英ガラスの機械的、熱的、電気的性質をそれぞれ下記の表でご確認下さい。
溶融石英と合成石英の性質
溶融石英ガラス 合成石英ガラス 密度 g cm-3 2.2 2.2 機械的性質 ビッカース硬度 Mpa 8,900 8,900 ヤング率 Gpa 74 74 剛性率 Gpa 31 31 ボアソン比 0.17 0.18 曲げ強度 Mpa 94.3 94.3 圧縮強度 Mpa 1,130 1,130 引っ張り強度 Mpa 49 49 ねじり強度 Mpa 29 29 熱的性質 歪点 ℃ 1,070 970 除冷点 ℃ 1,180 1,080 軟化点 ℃ 1,720 1,720 平均熱線膨張率 ×10-7℃-1 5.9 4.7 比熱 20℃ J kg-1K-1 749 749 熱拡散率 19℃ ×10-7m2s-1 8.3 8.5 熱伝導率 19℃ W m-1K-1 1.38 1.38 粘度 (log η,1200℃) Pa s 11.72 10.6 電気的性質 誘電率ε1 500MHz 3.9 3.9 誘電体損失(tan δ) 500MHz <1 <1 体積抵抗 (25℃) Ω 3 × 10-15 5 × 10-15 体積抵抗率 (25℃) Ω・cm 5 × 10-16 1 × 10-17 -
耐熱性を重視する場合、どちらの石英ガラスがおススメですか?
耐熱性を重視する場合、溶融石英ガラスがおススメです。
熱膨張率も合成石英ガラスよりも若干高くなります。
また、価格も合成石英ガラスに比べ安価です。 -
薪ストーブの覗き窓は、耐熱温度500℃の「テンパックス」だと割れませんか?
薪ストーブは通常200℃(度)ぐらいで使われる方もいらっしゃるかもしれませんが、空気を送る量や、薪の状況などで激しく温度が変化します。
まれに、テンパックス(500℃タイプ)を薪ストーブに使われた方が熱割れしたケースがありますので、薪ストーブの覗き窓に使われる場合はネオセラム800℃(度)タイプをお薦めします。 -
耐熱ガラスのガラスの色は?
耐熱ガラスは種類ごとにガラスの色が違います。

通常のガラス
緑がかった透明
500℃タイプ
1000℃タイプ
ほぼ無色透明
800℃タイプ
あめ色(茶色)
耐熱ガラス800℃タイプ(あめ色)(写真左)と、通常のガラスの色を比べてみました。
白い紙上では、色が濃く見えますが、透かしてみてみればこのぐらいの違いです。 -
耐熱ガラスは、水で急激に冷やしても割れませんか?
耐熱ガラスは、水などで急激に冷やすと割れてしまうことがあります。
どのくらいの温度変化なら大丈夫か示す温度に「耐熱衝撃温度」という指標があります。耐熱衝撃温度の数値は、その数値から0℃に急冷した場合に割れないとされています。ガラスは熱伝導率が低い(熱が伝わりにくい)ため、板厚が熱くなるほど、表面と内部の温度差が生じて割れやすくなります。
例えば「ネオセラム」は耐熱衝撃温度が700℃なので、700℃から0℃に一気に冷やされても割れません。各耐熱ガラスの耐熱衝撃温度は下記の通りです。
ガラス 厚み 耐熱衝撃温度
普通ガラス
2 / 3ミリ 65℃ 4 / 5 / 6 ミリ 50℃ 8 ミリ 35℃ テンパックス 0.7 / 1.1 / 1.75 / 2 / 2.75 / 3.3 / 3.8 ミリ 175℃ 5 / 6.5 / 8 / 10.2 / 12.2 / 13 / 15 ミリ 150℃-160℃ 20ミリ 125℃ テンパックス強化 3 / 3.8 / 5 / 6.5 / 8 / 10.2 / 12.2 / 13 / 15 / 20 ミリ 250℃ ネオセラム 3 / 4 / 5 ミリ 800℃ ファイアライト 5 / 8ミリ 800℃ 石英ガラス 1~20ミリ 900℃ バイコール 3 / 6 / 9 ミリ 800℃ -
耐熱ガラスは強化ガラスに出来ますか?
テンパックス(500℃タイプ)のみ強化加工することが可能です。
但し、厚みが3.3ミリ以上必要になります。
テンパックスは、強化加工することで最高使用温度が500℃(度)から290℃(度)と下がりますが、耐熱衝撃温度は若干上がりますので急激な温度変化などに強くなります。 -
耐熱ガラス「テンパックス」の透過率は、どれくらいですか?

こちらの図は、各波長の光(UV域)を当てた際に「テンパックス」がどれだけ光を透過したかを表しています。
※ 「透過率」とは、光がガラスに当たったときに光を通す割合 -
防音ガラスをペアガラスにすることは出来ますか?
可能です。ペアガラスにすることで、空気層が増え、断熱効果や結露防止効果はもちろん、更に防音性能が高まりまる効果があります。
-
夜景専用ガラス TEIEN(庭園)は自分で切断できますか?
夜景専用ガラス TEIEN(庭園)はガラスカッターという道具を使って、ご自分で簡単に切断することが可能ですが、たいへん高価なガラスです。オーダーメードで購入されることをお勧めいたします。
ガラスの切断方法はガラスのホームセンター「ギヤマン」で動画でご覧いただけます。 -
夜景専用ガラス TEIEN(庭園)を強化ガラスにすることは出来ますか?
夜景専用ガラス TEIEN(庭園)は特殊なコーティングを施してある為、強化加工をすることが出来ません。
-
夜景専用ガラス TEIEN(庭園)に穴あけなどの加工は出来ますか?
夜景専用ガラス TEIEN(庭園)には表面に特殊なコーティングを施してある為、加工時にコーティングに傷をつけてしまいます。穴あけなどの加工が出来ませんのでご了承ください。
-
見えないガラスは外装で使えますか?
使えませんので、屋外用の低反射ガラスをご利用ください。
見えないガラスは、反射率を抑える為のコーティングを両面に施してあります。 このコーティングは、アルカリ性に弱く、屋外で使うと低反射性を維持することができません。
屋外用の低反射ガラス「クリアサイトⅡ」は、アルカリ性に強いコーティングを施してありますので、屋外で使われる場合は、屋外用低反射ガラス「クリアサイトⅡ」をご利用下さい。 -
見えないガラスと低反射ガラスの違いは?
「反射率」と「屋外での使用出来るか、出来ないか」が違います。
低反射ガラス(クリアサイトⅡ)は普通のガラスに比べて反射率が5分の1になりますが、見えないガラスは13分の1の0.6%になります。
ただし、低反射ガラス「クリアサイト」は屋外で利用できるのに対して、見えないガラスは屋外利用が出来ません。見えないガラス 低反射ガラス「クリアサイトⅡ」 元板 高透過ガラス フロートガラス・高透過ガラス 反射率 0.6% 1.5% 屋外使用 使用できない 使用できる 価格 小さいサイズが安い 大きいサイズが安い 見えないガラス 低反射ガラス
「クリアサイトⅡ」元板 高透過ガラス フロートガラス
・高透過ガラス反射率 0.6% 1.5% 屋外使用 使用できない 使用できる 価格 小さいサイズが安い 大きいサイズが安い -
見えないガラスの反射率は?
通常のガラスの反射率8%(片面4%)に対して、見えないガラスはわずか0.6%(片面0.3%)と極限まで低下させてあります。

-
見えないガラスのサンプルはありますか?
大変高価なガラスなので、サンプル代金をいただいてお出ししております。サンプルをご希望の方はお電話でお申し付けください。
-
見えないガラスは自分で切断出来ますか?
見えないガラスもガラスカッターという道具を使って、ご自分で簡単に切断することが可能です。ただ、大変高価なガラスです。ご自分で切断されて失敗されると大変ですので、工場で切断されたほうが安全です。
オーダーガラス板.comでは見えないガラスのオーダーメード販売をしています。端材もでませんので、無駄がありません。安全のためにもオーダーメード購入をお勧めいたします。ガラスの切断方法はガラスのホームセンター「ギヤマン」で動画でご覧いただけます。
-
見えないガラスのクリーニング方法は?
メガネ拭きのような柔らかい生地の布で乾拭きをしてください。汚れが取れにくい場合は、水拭きをした後に乾拭きで充分に水分を拭きとってください。水滴などがガラスに残ったまま乾くと水滴の跡になり、拭いても跡が取れなくなる場合がありますのでご注意ください。
-
クリアサイトⅡは自分で切断できますか?
クリアサイトⅡはガラスカッターという道具を使って、ご自分で簡単に切断することが可能ですが、たいへん高価なガラスです。オーダーメードで購入されることをお勧めいたします。
ガラスの切断方法はガラスのホームセンター「ギヤマン」で動画でご覧いただけます。 -
額縁に使いたいのですがクリアサイトⅡを使えばいいですか?
クリアサイトⅡ(低反射ガラス)はたいへん高価なガラスです。額縁用のガラスとして低反射ガラスを使われる場合は、価格が安価な無反射ガラス(シルクサイト)を使われることをお勧めします。
-
クリアサイトⅡを強化ガラスにすることは出来ますか?
クリアサイトⅡは特殊なコーティングを施してある為、強化加工をすることが出来ません。
-
クリアサイトⅡに穴あけなどの加工は出来ますか?
クリアサイトⅡには表面に特殊なコーティングを施してある為、加工時にコーティングに傷をつけてしまいます。クリアサイトⅡは穴あけなどの加工が出来ませんのでご了承ください。 -
写真撮影や映像の撮影時の反射を抑えることが出来ますか?
ガラスの上に商品をのせて、デジタルカメラで撮影される方で、写りこみがないように反射防止ガラスをお探しの方がいらっしゃいます。反射防止ガラスは、絵にぴったりくっつけると、透明に見えるのですが、通常はスリガラスのようなマット調のガラスです。撮影にガラスを使われる場合は、通常のガラスのようで、反射を抑えたガラスで他に低反射ガラスがありますので、そちらをお勧めいたします。当社でも取り扱っています。低反射ガラスはこちら
-
自分で交換できますか?
可能です。
小さい窓ガラスは結構ご自分で交換される方が多いです。
交換方法の動画を撮影しましたので、動画をご覧下さい。 -
既存の窓ガラスのサイズの測り方は?
①サッシからサッシまでの長さを測る

窓ガラスを分解しなくても、ガラスのサイズの採寸は可能です。
まずは、図のようにサッシからサッシまでの長さを採寸してください。このとき、 ゴムパッキンまでではなく、サッシまでの長さを採寸するようご注意ください。
②①で出した寸法に「サッシに入っているガラス分」をプラス
①で出した寸法に「サッシに入っているガラス分」をプラスします。単板ガラスの場合は「12ミリ」をペアガラス・スリムペアガラスの場合は「24ミリ」を真空ガラスの場合は「11ミリ」をプラスしたサイズでご注文ください。
例えば、①で測ったサイズが、縦500ミリ、横400ミリの場合、以下の表のようになります。
単板ガラスなら ペア・スリムペアガラスなら 真空ガラスなら 縦 512ミリ
(500+12ミリ)524ミリ
(500+24ミリ)511ミリ
(500+11ミリ)横 412ミリ
(400+12ミリ)424ミリ
(400+24ミリ)411ミリ
(400+11ミリ)間違いない採寸をするために、上下左右4カ所の計測がおすすめ

正確な数値を出すために、図のように上下左右4カ所を計測することをおすすめしています。同じ大きさの窓が2枚ある場合でも、必ず両方のサイズを計測してください。
また、1人で測ると、勘違いや目盛りの見間違い等の可能性があるため、2人以上で採寸をしサイズが一致するかご確認いただくとより正確です。
-
「シルバーのキャップ」みたいな物がついていますが何ですか?

ガラスの中間層を真空にする時に必要な穴を塞いでいるものです。キャップを外すと真空状態が保てませんので、キャップは絶対に外さないでください。
※直径15ミリぐらいの小さなキャップです。
-
真空ガラスに、ゴム(グレチャン)は付いていますか?
 価格表は、9ミリ開口用のゴム(グレチャン)込みの価格になっています。その他の開口のグレチャンが必要な方は0120-12-4466まで、お気軽にお問い合わせください。
価格表は、9ミリ開口用のゴム(グレチャン)込みの価格になっています。その他の開口のグレチャンが必要な方は0120-12-4466まで、お気軽にお問い合わせください。 -
自分で交換できますか?
可能です。
小さい窓ガラスは結構ご自分で交換される方が多いです。
交換方法の動画を撮影しましたので、動画をご覧下さい。 -
既存の窓ガラスのサイズの測り方は?
①サッシからサッシまでの長さを測る

窓ガラスを分解しなくても、ガラスのサイズの採寸は可能です。
まずは、図のようにサッシからサッシまでの長さを採寸してください。このとき、 ゴムパッキンまでではなく、サッシまでの長さを採寸するようご注意ください。
②①で出した寸法に「サッシに入っているガラス分」をプラス

①で出した寸法に「サッシに入っているガラス分」をプラスします。単板ガラスの場合は「12ミリ」をペアガラスの場合は「24ミリ」をプラスしたサイズでご注文ください。
例えば、①で測ったサイズが、縦500ミリ、横400ミリの場合、以下の表のようになります。
単板ガラスなら ペアガラスなら 縦 512ミリ
(500+12ミリ)524ミリ
(500+24ミリ)横 412ミリ
(400+12ミリ)424ミリ
(400+24ミリ)間違いない採寸をするために、上下左右4カ所の計測がおすすめ

正確な数値を出すために、図のように上下左右4カ所を計測することをおすすめしています。同じ大きさの窓が2枚ある場合でも、必ず両方のサイズを計測してください。
また、1人で測ると、勘違いや目盛りの見間違い等の可能性があるため、2人以上で採寸をしサイズが一致するかご確認いただくとより正確です。
-
サッシの開口サイズが(9ミリなのか、11ミリなのか)分かりませんが、どうすればいいですか?
基本、サッシの上の方に写真のような品番とメーカー名の入ったシールが貼ってあります。メーカーと品番を見れば、開口を調べることが可能です。
品番をお伝えいただければ、当社で開口のサイズをお調べいたしますので、0120-12-4466まで、お気軽にご連絡ください。基本、サッシの上の方に写真のような品番とメーカー名の入ったシールが貼ってあります。メーカーと品番を見れば、開口を調べることが可能です。
品番をお伝えいただければ、当社で開口のサイズをお調べいたしますので、0120-12-4466まで、お気軽にご連絡ください。
-
ガラスにゴムパッキン(グレチャン)は付いていますか?

当店のペアガラス(スリムタイプ)は、ゴムパッキン(グレチャン)付きの商品になっていますので、別途購入する必要はございません。
サッシの開口サイズによって取り付けるグレチャンが異なりますので、サッシの開口サイズをご確認の上、ご注文ください。▼ グレチャン(グレイジングチャンネル)の取り付け動画はこちら
サッシの開口サイズが「11ミリ」の場合の注意点
サッシの開口サイズが「11ミリ」の場合、ゴムパッキン(グレチャン)だけで設置ができる場合と、できない場合がございます。ゴムパッキンの付いた状態で設置できない場合、ゴムパッキンを外してコーキング+セッティングブロック(高さを補うためのゴム部材)で対応した事例などもございます。サッシの開口サイズが11ミリの場合は、以上の点にご注意ください。
-
ペアガラス(スリムタイプ)に遮熱効果はありますか?
「Low-Eペアガラス(スリムタイプ)」は、遮熱効果があります。Low-Eペアガラスは特殊なコーティングの効果により、夏の熱線を反射し、夏のエアコン効果を高めます。
-
Low-eってどう読めばいいのですか?
Low-eは(ローイー)と読みます。
Low-eペアガラス(ローイーペアガラス)、Low-e複層ガラス(ローイーフクソウガラス)という言い方をします。 -
ステンドグラスやデザインガラスをペアガラスに出来ますか?

ペアガラスは透明以外にいろんなガラスをペアガラスにすることが出来ますので是非お問い合わせください。 ステンドグラスのペアガラスやデザインガラスのペアガラス等は、姉妹店を御覧ください。
● ステンドグラス窓COM
● デザインガラスCOMご質問等ございましたら、0120-12-4466まで、お気軽にお問い合わせください。
-
異形の(形が変わった)ペアガラスは作れますか?
可能です。下記の図のような、角を落としたようなペアガラスや、円形、三角形のペアガラスの製作が可能です。形状により価格が異なります。価格はお見積り出来ますので、0120-12-4466まで、お気軽にお問い合わせください。
-
穴の開いたペアガラスは製作できますか?

可能です。
煙突通すために、窓ガラス(ペアガラス)に穴を開けたいという方がいらっしゃいます。ペアガラスに穴あけは出来ませんが、穴の開いたペアガラスは製作可能です。
穴あきペアガラスのお見積りは、0120-12-4466までお気軽にお問い合わせください。 -
ペアガラスは自分で切断できますか?
ペアガラスはご自分で切断することが出来ません。
当社では切断後、ペアガラスに加工することによって、お客様のご要望に合わせたサイズのペアガラスをお作りしています。 -
複層ガラス(ペアガラス)と防犯ガラスは同じですか?
違います。防犯ガラスは、中間膜という厚い透明のフィルムを2枚のガラスで挟み込んでおり、「合わせガラス」の1種。一方の複層ガラス(ペアガラス)は、ガラス同士の間に「中空層」という空間を隔ててガラスをペアにしたもので、断熱、結露防止を目的としたガラスです。

複層ガラスの構造

防犯ガラス、防犯ペアガラスの構造

ペアガラスも合わせガラスも、どちらも2枚のガラスを使っていますが、構造が違うために複層ガラスには防犯効果はありません。防犯ガラスを複層ガラスに使った「防犯ペアガラス」という商品ですと、防犯性能を期待できます。
ペアガラス・複層ガラスの基礎知識
防犯ガラスをお探しの方はこちら
-
床用ガラスは自分で切断できますか?
床用ガラスは強化ガラスを使用していますので、切断することが出来ません。
-
ガラスの上でジャンプしても割れませんか?
人がジャンプするぐらいでは割れないぐらいの安全な強度で計算していますので、大丈夫です。とはいっても万が一割れた場合はとても危険ですので、ジャンプはしないでください。
ジャンプした動画を載せておきましたので、強度をご確認ください。
人がジャンプするぐらいでは割れないぐらいの安全な強度で計算していますので、大丈夫です。とはいっても万が一割れた場合はとても危険ですので、ジャンプはしないでください。
ジャンプした動画を載せておきましたので、強度をご確認ください。
-
床用ガラスの透け具合はどんな感じですか?
床用ガラスは、透明と乳白の2色がありますが、透明は右の写真(クリックで拡大)のように通常のガラスのように透けています。滑り止めタイプも同じように透明です。乳白は写真のように透けませんが、ライト(照明)を当てたりすることで光は通します。
床用ガラスは、透明と乳白の2色がありますが、透明は右の写真(クリックで拡大)のように通常のガラスのように透けています。滑り止めタイプも同じように透明です。乳白は写真のように透けませんが、ライト(照明)を当てたりすることで光は通します。
-
床ガラスの施工の詳細を教えてください

クリックして、詳細図(PDF)をご確認ください。鉄骨下地と木造下地の場合の詳細図です。ご不明な点は、「0120-12-4466」までお気軽にお問合せください。
-
床ガラスを支える「受け」は、どれくらい必要ですか?
床ガラスを支える場合、ガラスの厚みの2倍以上支えてください。
例えば16ミリの床ガラスの場合は、32ミリ以上必要になります。
※ 必ず四方支えること
-
保険付き防犯ガラス保証内容を教えて下さい
万が一、防犯ガラスを割られて盗難にあった場合にお見舞金と新しい防犯ガラスの無償提供があります。また、台風で防犯ガラスが割れた場合もお見舞金と防犯ガラスの無償提供を受けることが出来ます。お見舞金の金額は、ご購入頂いた防犯ガラスの防犯レベルによって異なります。
保険付き「防犯ガラス」の保証内容
グレード レベル1 防犯レベル2 防犯レベル3 特殊フィルムの厚さ 30mil (0.8ミリ) 60mil (1.5ミリ) 90mil (2.3ミリ) 盗難に関するお見舞金 上限10万円
ただし未遂の場合は1万円 及び
防犯ガラス無償提供上限20万円
ただし未遂の場合は1万円 及び
防犯ガラス無償提供上限30万円
ただし未遂の場合は1万円 及び
防犯ガラス無償提供台風に関するお見舞金 1万円 及び
防犯ガラス無償提供1万円 及び
防犯ガラス無償提供1万円 及び
防犯ガラス無償提供- 未遂とは、ガラス破壊のみで盗難被害なしの場合
- 防犯ガラス無償提供に、施工料金は含まれません
- 有効期限:購入後5年間
保険付き「防犯ガラス」の保証内容
グレード レベル1 防犯レベル2 防犯レベル3 特殊フィルムの厚さ 30mil (0.8ミリ) 60mil (1.5ミリ) 90mil (2.3ミリ) 盗難に関するお見舞金 上限10万円
ただし未遂の場合は1万円 及び
防犯ガラス無償提供上限20万円
ただし未遂の場合は1万円 及び
防犯ガラス無償提供上限30万円
ただし未遂の場合は1万円 及び
防犯ガラス無償提供台風に関するお見舞金 1万円 及び
防犯ガラス無償提供1万円 及び
防犯ガラス無償提供1万円 及び
防犯ガラス無償提供- 未遂とは、ガラス破壊のみで盗難被害なしの場合
- 防犯ガラス無償提供に、施工料金は含まれません
- 有効期限:購入後5年間
保険付き防犯ガラスに関するお問い合わせは、0120-12-4466まで、お気軽にお問い合わせください。
-
フロストガラスなど違うガラスを防犯・防音ガラスに出来ますか?
もちろん可能です。フロストガラスのみならず、いろいろなガラスを防犯・防音ガラスにすることができます。ぜひお問い合わせください。
防犯・防音ガラスに関するご質問は、0120-12-4466まで、お気軽にお問い合わせください。 -
防犯ガラスをペアガラス(複層ガラス)に出来ますか?
可能です。防犯ガラスをペアガラス(複層ガラス)にすることで、断熱効果や結露防止効果を高める事ができます。
0120-12-4466まで、お気軽にお問い合わせください。 -
防犯ガラスを床に使う事はできますか?
滑り止め機能の付いた、床専用の合わせガラス、床用ガラスがありますので、そちらをご利用ください。
ご不明な点などございましたら、0120-12-4466まで、お気軽にお問い合わせください。 -
防犯ガラスは自分で切断できますか?
防犯ガラスはガラスとガラスの間に特殊フィルムを挟み込んでいますので、切断することが出来ません。オーダーメードでの制作になります。
-
防犯ガラスは屋外でも使用できますか?
フィルムは屋外用と屋内用の2種類がありますが、防犯ガラスは基本サッシに入れることが前提で、サッシに入れた場合はガラスの小口(横面)が隠れますので、屋内用フィルムを使用しています。小口が隠れない場合は、水に強いフィルムに変えることも可能ですので、お問い合わせ下さい。
-
合わせガラスは自分で切断できますか?
合わせガラスはガラスとガラスの間に特殊フィルムを挟み込んでいますので、切断することが出来ません。オーダーメードでの制作になります。
-
合わせガラスは屋外でも使用できますか?
合わせガラスには屋内用の他に屋外用も用意しております。ガラス同士を貼り合わせるための中間膜に水に強いものを使用しています。屋外や水回りで使用される場合は必ず、屋外用をご使用ください。
-
フロストガラスなど違うガラスを合わせることは出来ますか?
もちろん可能です。フロストガラスのみならず、いろいろなガラスを合わせガラスにすることができます。ぜひお問い合わせください。
合わせガラスに関するご質問は、0120-12-4466まで、お気軽にお問い合わせください。 -
合わせガラスを床に使う事はできますか?
滑り止め機能の付いた、床専用の合わせガラス、床用ガラスがありますので、そちらをご利用ください。
ご不明な点などございましたら0120-12-4466まで、お気軽にお問い合わせください。 -
ミラーガラス(プライバシーガラス)は裏と表があるって本当ですか?
ミラーガラス(プライバシーガラス)は片面にコーティング(金属の反射膜面)がつけられています。
反射膜面はを室内側にしてご使用下さい。
出荷されたガラスに「非膜面表示シール」が貼られています。この面が屋外側になるように設置して下さい。 -
遮熱ガラス(熱線反射ガラス)は裏と表があるって本当ですか?
遮熱ガラスは片面にコーティング(金属の反射膜面)がつけられています。
反射膜面はを室内側にしてご使用下さい。
出荷されたガラスに「非膜面表示シール」が貼られています。この面が屋外側になるように設置して下さい。 -
ミラーガラス(プライバシーガラス)は自分で切断できますか?
ミラーガラス(プライバシーガラス)は、ガラスカッターという道具を使って、ご自分で簡単に切断することが可能です。片面がコーティングされていますので、コーティングのない方をガラスカッターで切断してください。ガラスの切断方法はガラスのホームセンター「ギヤマン」で動画でご覧いただけます。
-
遮熱ガラス(熱線反射ガラス)は自分で切断できますか?
ミラーガラス(プライバシーガラス)は、ガラスカッターという道具を使って、ご自分で簡単に切断することが可能です。片面がコーティングされていますので、コーティングのない方をガラスカッターで切断してください。ガラスの切断方法はガラスのホームセンター「ギヤマン」で動画でご覧いただけます。
-
透過率の「8%」「20%」で、どれくらい違いますか?

実際の窓に本商品の透過率8%と20%を入れてみました。左の写真の左の窓が、透過率8%、右の窓が20%になります。20%のほうは、若干室内が見えているのがお分かりいただけると思います。
8%の方は、透過率がひくく反射率が高いので本当に鏡のように見えるガラスです。 -
プライバシー効果は昼夜逆転するって本当?

試しに、夜に外から明かりのついた室内を撮影してみました。本商品はマジックミラーと同じ原理ですので、暗い場所から明るい場所を見た場合、普通のガラスのように見えます。夜はブラインドやカーテンなどを使って隠れるようにしてください。
-
ミラーガラス(プライバシーガラス)をペアガラス(複層ガラス)に出来ますか?
可能です。ミラーガラスをペアガラス(複層ガラス)にすることで、断熱効果や結露防止効果を高める事ができます。 0120-12-4466まで、お気軽にお問い合わせください。
-
遮熱ガラスに断熱効果はありますか?
-
高透過ガラスは自分で切断できますか?
高透過ガラスも「ガラスカッター」という道具を使って、ご自分で簡単に切断することが可能です。ただ、大変高価なガラスです。ご自分で切断されて失敗されると大変ですので、工場で切断されたほうが安全です。オーダーガラス板.comでは高透過ガラスのオーダーメード販売をしています。端材もでませんので、無駄がありません。安全のためにもオーダーメード購入をお勧めいたします。
ガラスの切断方法は、姉妹店のガラスのホームセンター「ギヤマン」で動画でご覧いただけます。
-
高透過ガラスを曲げガラスにすることは可能ですか?
高透過ガラスをつかってショーケースを作りたいのですが、曲げれますか?という質問をよくいただきます。高透過ガラスも曲げることが可能ですので、こちらの「曲げガラス/ガラスの曲げ加工」ページをご覧ください。
-
高透明ガラスとは高透過ガラスのことですか?
高透過ガラスのことを高透明ガラスと呼ばれる方もいらっしゃいます。同じ商品ですのでご安心ください。
-
フロストガラスは自分で切断できますか?
フロストガラスもガラスカッターという道具を使って、ご自分で簡単に切断することが可能です。 切断する場合は、ツルツル面の方をガラスカッターで傷をつけて切断してください。
ガラスの切断方法はガラスのホームセンター「ギヤマン」で動画でご覧いただけます。 -
「すりガラス」「フロストガラス」は、どのように違いますか?

フロストガラスとすりガラスは見た目はほとんど同じですが、比較写真の通り、フロストガラスのほうが若干、透け具合が大きくなります。すりガラスとフロストガラスの最大の違いは、手垢がつくか付かないかです。
すりガラス(磨りガラス)は、ざらざらした面を触ると手垢がついてしまい、拭いても完全には取れず、汚れが残ってしまうことが弱点でした。

フロストガラスは、磨りガラスと同様に、ガラス表面にサンドブラストすることで乳白色にしてから、更にざらざらになった表面にフッ化水素化学スリガラス処理を施すことで滑らかにし、手垢が付きにくくしてあります。「手垢の付きにくい摺りガラス」だと思っていただければいいと思います。

フロストガラスとすりガラスの見分け方は簡単です。すりガラスは、ざらざらした面を水で濡らすと、左の写真のように透けるようになります。しかし、フロストガラスは水で濡れても透けません。この写真からも、すりガラスに水垢が付きやすいことがお分かりいただけると思います。
-
フロストガラスをペアガラス(複層ガラス)に出来ますか?
可能です。フロストガラスをペアガラス(複層ガラス)にすることで、断熱効果や結露防止効果を高める事ができます。
0120-12-4466まで、お気軽にお問い合わせください。 -
フロストガラスの耐熱温度は?
ガラスの耐熱温度は『常用温度』と『最高使用温度』という2つのあらわし方があります。
簡単に言いますと、急激に熱した場合と、連続で熱した場合では割れる温度が違うと言うことです。
フロストガラスの耐熱温度は、常用温度110℃(度) 最高使用温度380℃(度)となっています。
沸騰したお湯100℃(度)をかけても割れないということになります。 -
すりガラスは自分で切断できますか?
すりガラスもガラスカッターという道具を使って、ご自分で簡単に切断することが可能です。切断する場合は、ツルツル面の方をガラスカッターで傷をつけて切断してください。
ガラスの切断方法はガラスカッター.comで動画でご覧いただけます。 -
すりガラスを強化ガラスにすることはできますか?
「すりガラス」を「強化ガラス」にすることはできません。すりガラスと似た加工で「フロスト加工」というものがございます。すりガラス風の強化ガラスをご希望のお客様には「フロスト強化ガラス」をオススメしております。スタッフにお気軽にその旨をお申し付けください。
-
すりガラスを外装にも使えますか?
可能です。ただ厚みのあるガラスではありませんので、強風や落雪のあるような場所ではご使用にならないようお勧めいたします。
-
すりガラスが汚れた場合の掃除方法は?
すりガラスの掃除方法は:
- 水で2〜3倍に希釈した市販のガラス用洗剤をすりガラスに吹き付けます。
- スポンジでガラスを磨きます。
- タオル等で乾拭きして、乾燥させます。
動画も撮影しましたので、是非ご覧下さい。
-
すり加工の「グラデーション幅」を指定することは可能ですか?
可能です。「すりガラス幅」を指定いただけます。
「ガラスの下から、すりガラス幅を○○ミリ」とご指定ください。


-
網入りガラスはワイヤーが入っていますが、自分でも切れますか?

「ガラスカッター」を使って簡単に切れます。厚み10ミリぐらいまでなら簡単に自分でも切断できますので、DIY、日曜大工、 自分で窓ガラスの取替えなどを行う方には扱いやすいガラスといえます。
-
網入りガラスを「強化ガラス」にできますか?
強化ガラスにするには熱処理を加えるのですが、網入りガラスは、網とガラスの膨脹係数が違う為、熱処理を加えると割れてしまいますので、強化ガラスにすることが出来ません。
-
網入りガラスをペアガラス(複層ガラス)にできますか?
可能です。網入りガラスをペアガラス(複層ガラス)にすることで、断熱効果や結露防止効果を高める事ができます。
0120-12-4466まで、お気軽にお問い合わせください。 -
型板ガラスは自分で切断できますか?
型板ガラスもガラスカッターという道具を使って、ご自分で簡単に切断することが可能です。型板ガラスは、片面が凸凹、もう片面がつるつるしていますので、つるつるした面をガラスカッターで傷をつけて切断してください。
ガラスの切断方法はガラスのホームセンター「ギヤマン」で動画でご覧いただけます。 -
型板ガラスの耐熱温度は?お風呂でも使えますか?
型板ガラスの耐熱温度は110℃(度)と言われています。
110℃(度)までなら大丈夫(110℃(度)以下なら急激な温度変化でもわれることは少ない)ですので、40℃(度)ぐらいのお風呂のお湯なら全く問題ありません。
ちなみに型板ガラスは視界を遮る為、お風呂ではよく利用されるガラスです。安心してお使いください。 -
型板ガラスをペアガラス(複層ガラス)に出来ますか?
可能です。型板ガラスをペアガラス(複層ガラス)にすることで、断熱効果や結露防止効果を高める事ができます。
0120-12-4466まで、お気軽にお問い合わせください。 -
オシャレな型板ガラスはありませんか?
普通の型板ガラスはデザインが古いので、おしゃれな型板ガラスを探されている方が多くいらっしゃいます。
当社ではヨーロッパから取り寄せた型板ガラス、ヨーロッパデザインガラスやチェックガラスの型板ガラス、チェッカーガラスなど取り扱っています。
デザイン性が高く、とても人気のあるガラスです。一度ご覧になってみてください。 -
型板ガラスを強化ガラスにすることは出来ますか?
梨地は2ミリと薄いため、強化ガラスにすることはできませんが、霞(かすみ)は厚みがある為強化ガラスにすることが可能です。ご希望の方はオーダーガラス板.comまで、お問い合わせ下さい。
-
「強化ガラス」は自分で切断できますか?
強化ガラスは、ご自身で切断できません。表面が硬く保護されていると「ガラスカッター」では切断できないためです。
当社では、透明ガラスを切断後に強化加工することによって、お客様のご要望に合わせたサイズの強化ガラスをお作りしています。ですので、購入後にご自身で切るのではなく、ご希望のサイズで購入されるようにお客様にご案内しております。
-
強化ガラスに穴あけなどの加工は出来ますか?
切断同様、強化ガラスに穴あけは出来ません。ただし、穴をあけてから強化加工することは出来ますので、ガラスを注文する前に穴あけの意図をお伝えください。強化加工した後に穴あけをすると、ガラスが粉々に割れてしまいます。
-
「強化ガラス」と「防犯ガラス」は同じですか?
違います。強化ガラスは鋭利なもので叩くと割れて防犯効果はないので、防犯性能をお求めの方は「防犯ガラス」がオススメです。
ガラスの種類 特徴 強化ガラス 1枚の単板ガラス
尖ったもので叩くと割れるため防犯効果はない防犯ガラス 2枚のガラスを、その間に「中間膜」という透明のフィルムを挟んだ「合わせガラス」の一種
防犯に特化したフィルムで防犯性能に優れる -
強化ガラスと普通のガラスを割らずに見分ける方法を教えて

メーカー(AGC、日本板硝子、セントラル硝子)の強化ガラスであれば、ほとんどの商品に製品シールが貼られていますのでそちらをご確認ください。
メーカー商品でない場合は、「偏光板」を使用すると、強化ガラスと透明ガラスを見分けることが可能です。
太陽が出ている日に、ガラスを屋外に持ちだし、偏光板を通してガラスの4隅を確認してください。強化ガラスの場合、ガラスの4隅が虹色っぽく見えます。
これは、強化ガラスの表面にある薄い膜に太陽光が当たることによって光が屈折することで生まれるもので、強化ガラスの特徴のひとつでもあります。
※薄いガラスや円形のガラスなどは虹色が見えずらい場合があります。
※偏光板の代わりに釣りやゴルフなどで使われるレジャー用の偏光グラスでも同じような効果が得られます。 -
フロートガラスの耐熱温度は?
-
20ミリ以上の厚みの厚いガラスは作れますか?
フロートガラスの最大厚みは19ミリですが、合わせガラス(2枚のガラスを貼り合わせる)にすれば、さらに厚みのあるガラスを作ることが可能です。
-
フロートガラスの透過率は、どれくらいですか?

透過率とは、光全体に対して、ガラスを透す(透過)光の率のことをいいます。
右図は、各、波長の光を当てた際に、フロートガラスがどれだけ光を透過したかを表した表です。 -
「確認用の図面」を作ってもらえますか?
複雑な形状や、穴あけ、コーナー加工など、注文する前にできるガラスを確認したいと思います。当社では、注文前の確認用の作図サービスも行っておりますので、安心してガラスをご注文いただけます。作図をご希望の方はお気軽にお問い合わせください。
-
「キリのよいサイズ」で注文したほうが価格は安くなりますか?
501ミリとかキリの悪いサイズで注文すると価格が極端に高くなるとご心配の方が多くいらっしゃいますが、当社は面積により価格を決定している為、500ミリが501ミリになったとしても極端に高くなることはありませんのでご安心ください。ご希望のサイズでご注文されることをお勧めいたします。
-
「寸法公差」によってガラスサイズの仕上がりはどれくらい変わりますか?
ご指定が無い場合、ガラスや鏡のサイズには ±1ミリ以内の誤差が生じます。
ガラスの切断や加工の際に機械や人の手では寸法にどうしても若干の誤差が生じてしまいます。指定されたサイズよりも-1ミリ〜+1ミリ以内の間で、小さくなったり大きくなってしまうということです。このサイズの差を寸法公差と呼びます。

例えば、ガラスの幅を500ミリでご注文いただいた場合、製作されるガラスの幅は 499ミリ~501ミリ(±1ミリ) の間で仕上がります。
指定されたガラス幅 実際に仕上がるサイズ 500ミリ 499ミリ~501ミリ(±1ミリ) 指定した寸法より大きくなると困る場合は「プラス0ミリ指定」1ミリでもガラスが大きくなると困るという方は「プラス0ミリ指定」がオススメです。プラス0ミリ指定とは、ガラスのサイズを、指定した寸法から大きくならないようにする寸法公差指定のことです。
例えば、500ミリ幅のガラスを「プラス0ミリ」指定でご注文頂くと、498ミリ~500ミリ(+0ミリ)の間で製作を行います。
指定されたガラス幅 実際に仕上がるサイズ 500ミリ 498ミリ~500ミリ(+0ミリ) ガラスや鏡を枠にぴったり収めてお使いになる場合など、指定したサイズから少しでも大きくなると設置ができないという方は、こちらを指定ください。
指定した寸法より小さくなると困る場合は「マイナス0ミリ指定」1ミリでもガラスが小さくなると困るという方は「マイナス0ミリ指定」がオススメです。マイナス0ミリ指定とは、ガラスのサイズを、指定した寸法から小さくならないようにする寸法公差指定のことです。

例えば、500ミリ幅のガラスを「マイナス0ミリ」指定でご注文頂くと、500ミリ~502ミリ(+2ミリ)の間で製作を行います。
指定されたガラス幅 実際に仕上がるサイズ 500ミリ 500ミリ~502ミリ(+2ミリ) お客様のご希望に合わせて、最適なガラスサイズをご提案いたします。他にもガラスのことでご不明な点がある方はこちら(0120-12-4466)までお気軽にご相談ください。専門スタッフが丁寧に対応いたします。
-
処分したいガラスを引き取ってもらう方法を教えて。
引き取ってほしいガラスがある際は、お電話(0120-12-4466)またはガラス回収申込フォームからご連絡ください。
-
テーブルのガラスをずれないようにできませんか?

テーブルトップをご注文いただいたお客様でご希望の方には「滑り止めシール」をプレゼントしております。ご注文時に「滑り止めシール希望」とお伝えください。
お渡ししている「滑り止めシール」は、ガラス天板のサイズにより4~6枚となります。シールは透明の薄いもので、ほとんど目立ちません。ガラスの裏側に貼ってテーブルの上に載せることで滑り止め効果を発揮します。
-
商品の見積りをする方法を教えて。
商品のお見積りのご依頼は、無料お見積りフォームからお送りください。
-
注文したいのですがどうすればいいですか?
お電話での注文がオススメです。その他注文方法は、注文についてをご覧ください。
電話での注文やお見積もり・ご相談は0120-12-4466までお気軽にお電話ください。 -
「厚み」をどう決めればいいのかわかりません
ご使用の状況に合わせて、最適な厚みをご提案させていただきます。
0120-12-4466まで、お気軽にお問い合わせください。 -
施工や交換・採寸に出張で来てもらうことはできますか?
可能です。ガラスの施工や交換・採寸に出張で行くことが可能です。
お電話いただければお見積もりや出張可能な地域かお伝えできますので、0120-12-4466まで、お気軽にお問い合わせください。※一部、対象外の商品、出張できない地域もございます。
-
工具は販売していますか?
取り扱っています。ガラスと一緒にご注文が可能ですので、お気軽にお問い合わせください。
…取り扱っています。ガラスと一緒にご注文が可能ですので、お気軽にお問い合わせください。
… -
「L字アングル」や「コの字チャンネル」は販売していますか?

取り扱っております。破損どめやレール、ガラス間仕切りの固定によく使用されています。
「コの字チャンネル・L字アングル金物」コーナーで紹介していますので、ご覧ください。ガラスと一緒にご注文が可能ですので、お気軽にお問い合わせください。 -
ペアガラスってなんですか?
断熱性能を高めるために、ガラスとガラスの間に空気の層をもった複層ガラスです。穴あけは出来ませんが、穴の空いた複層ガラスをお作りすることが可能です。
-
ガラスに「四角形の穴」をあけることは可能ですか?
可能ですが、円形に比べて割れる可能性が高いので、円形をオススメしております。
ガラスに四角形の穴あけをしてほしいご相談は、ペットドアに検討されているお客様からが多いです。まだペットドアを購入されていない場合には、当店からは円形のガラスを推奨しています。
-
特殊なガラスなのですが穴を開けることは出来ますか?
当社では、あらゆるガラスを取り揃えておりますので、ほとんどのガラスをご用意が可能です。穴の開いたガラスにできるかどうかはガラスごとに製作可能かどうか判断いたしますので、とりあえず一度お問い合わせください。
-
自分でガラスを交換したいのですがやり方はどうすれば良いですか?
ガラスの交換方法の動画をご用意しました。小さな窓で紹介していますが、大きな掃き出し窓も基本的にガラスの交換方法は同じです。注文前に一度ガラスを外して戻してみると練習になりますので安心です。
-
ガラスの「取り付け・交換」に来てもらえませんか?
東京や大阪など都市部などほとんどの地域の出張交換は可能ですが、一部出張できない地域もございます。お気軽にお問い合わせ下さい。 -
サッシの周りにゴムみたいな物がありますがどこを測ればいいですか?

サッシからグレチャンと呼ばれるゴムがはみ出ているサッシも多くあります。サッシの周りにゴムが見えている場合は、ゴムまでではなく、必ずサッシの面まで採寸してください。
-
「サッシに隠れている部分」のガラスサイズはどうすればいいですか?

ガラスがサッシの中に隠れている部分を「飲み込み部分」といいます。通常、飲み込み部分は上下左右 6ミリ ~ 13ミリ ほどあり、採寸した寸法に飲み込み部分をプラスする必要があります。
飲み込み部分はガラスによって違いますので、下に表でまとめました。ご注文や見積もり時に「飲み込み部分は足したよ!」とか「飲み込み部分は足してないよ!」と言っていただけると助かります。ガラス別飲み込みサイズ一覧
ガラスの種類 飲み込みのサイズ 透明ガラス・型板ガラス 約6ミリ 網入りガラス 約10ミリ ペアガラス 約13ミリ ※その他のガラスや、ガラスの種類が合っているか心配な方はお気軽にお問合せください。
-
無反射ガラスは自分で切断できますか?
無反射ガラスもガラスカッターという道具を使って、ご自分で簡単に切断することが可能です。 ガラスの切断方法はガラスのホームセンター「ギヤマン」で動画でご覧いただけます。
-
反射防止ガラスは「額縁の反射防止ガラス」としても使えますか?

反射防止ガラスはもともと、額縁などの反射防止を目的に作られたガラスですので、もちろん額縁の反射防止としてお使いいただけます。
-
ガラスと写真がくっつくことはありませんか?
仕上がったばかりの写真ですと、ガラスに写真がくっつくことがあります。少し時間をおいてから、額縁に入れていただきますようお願いします。
-
素人ですが交換は出来ますか?
もちろん可能です。
ガラスの交換はプラスドライバー一本あれば簡単に交換することが可能です。難しいのは、掃き出し窓のような大きなガラスを交換する場合です。一人で行わずに二人以上で行う事と必ず手袋(軍手)をすることが大事です。 -
どの商品を選べばいいのか迷いますが相談していいですか?
当社では、お客様の使用用途に合わせた商品をご提案しています。お気軽にご相談ください。
-
側面を丸くしたり、装飾したりすることは可能ですか?

「ラウンドエッジ加工」とよばれる側面を丸くする加工や、「OG加工」とよばれる側面を装飾する加工ができます。加工のことでご不明な点は、お気軽に「0120-12-4466」までお問い合わせください。
※ ガラスの種類によって加工ができないものもございます
-
楕円形やオーバル(小判形)など複雑な形状に加工できますか?

可能です。
型紙や図面などを頂ければ、複雑な形状も可能です。ただ、ガラスの種類によっては、出来ない加工もございますので、お気軽にご相談ください。
-
ガラスの送料、梱包の料金が知りたいです
当社のガラスは全てサイズオーダーメードということもあり、ガラスの厚みやサイズ、ご注文の枚数によって梱包の方法や、配送する運送会社を変更する必要があります。送料や梱包費用の表はかなり膨大になり掲載することが出来ません。 ガラスの価格をお見積もり頂く際に、送料や梱包の費用も一緒にお見積もり致しますのでお気軽にお問い合わせください。
-
保証期間を過ぎるとどうなりますか?
保証期間を過ぎた場合には、運送会社を含めた責任の所在の特定が困難となり、返品・交換対応しかねます。商品到着後、出来る限り早く商品をご確認いただけることをお願い申し上げます。
-
ガラスを支給して加工してもらうことは可能ですか?
不可能ではありませんが、運送費が掛かりますので、当社でガラスを調達された方がお安くなる場合がほとんどです。
-
ガラスを固定する金具は販売していますか?
-
「グラデーション幅」を指定することは可能ですか?
可能です。「すりガラス幅」と「グラデーション幅」を指定することが出来ます。「下からすりガラス幅を○○ミリ、グラデーション幅を○○ミリ」といった感じでご指定ください。


※グラデーション幅の最大は200ミリになります。
-
飛散防止フィルムは、何℃まで耐えられますか?
50℃まで耐えることができます。
-
子供がいるのですが手を切ったりしないか心配です
切りっぱなし【ランクG】は、鋭く危険ですが、糸面取り【ランクC】以上の加工をすれば、手を切るような心配はありません。
糸面取り【ランクC】の切断面に手をこすってみましたが、全く問題ありませんでした。動画を撮影してみましたので、ご心配の方はご覧ください。 -
1辺だけ違う加工(切断面の処理)にすることできますか?

可能です。
図のように3辺をミガキ(ランクS)、残りの1辺を糸面(ランクC)のように辺ごとに、切断面の加工を変更することも可能です。注文方法:
図のような場合、
「長辺1辺を糸面取り(ランクC)、残り3辺をミガキ(ランクS)」のようにお伝えいただけると、わかりやすく、助かります。 -
型紙はどんな紙にとればいいですか?
模造紙をご使用ください。伸び縮みしない紙(新聞紙やカレンダーなど)をつなぎ合わせたものでも大丈夫です。
-
小判形のガラスを注文する場合、図面や型紙は必要ですか?

図面や型紙なしでも製作は可能です。図のように、正円を半分にしたような小判形のガラスは、図の(ABC)の寸法を頂ければ、製作可能です。※B−C=Aになっている場合に限ります。B−C=Aになっていない場合は、型紙あるいは図面が必要です。
異形カットのお見積りに必要な寸法について、
詳しくはこちらをご覧ください。 -
ガラスを支給して加工してもらうことは可能ですか?
不可能ではありませんが、運送費が掛かりますので、当社でガラスを調達された方がお安くなる場合がほとんどです。
-
ガラスの「コーナーR加工」の「R」の大きさのイメージが付きません
Rの大きさのイメージしにくい、R30と言われてもどのくらいの大きさか分からない。という方の為に、Rの大きさを測定する「Rの大きさ測定用紙」を作ってみました。PDFファイルで作りましたので、ダウンロードしたり印刷したりして利用が可能です。
コーナーR測定用紙(PDFファイル)
※クリックでPDFファイルが表示されます。サイズ別にご利用ください。
Rの測り方①「懐中電灯を使う場合」
懐中電灯を使ってRを測定する場合は、写真のように「Rの大きさ測定用紙」をテーブルの上にのせ、下から懐中電灯で照らすことで、影が出来てRの大きさを測定できます。
Rの測り方②「紙と色鉛筆を使う場合」
-
ガラス店(サッシ店)でも法人登録は可能ですか?
ガラス店(サッシ店)の方でも、法人登録は可能です。
様々な種類のガラスを元板購入ではなく原寸(希望のサイズ)購入が可能ですので、多くのガラス店やサッシ店の方にご利用いただいております。必要な分のみ購入できると、大変お喜びいただいております。
-
個人事業主でも法人登録は可能ですか?
個人事業主の方でも、法人登録は可能です。
登録には「屋号」が必要になります。所在や職種が確認できない場合は、登録や後払いサービスをお受けできない場合もございますので、あらかじめご了承ください。
-
「デザインガラスサンプル・アソートボックス」はどう注文すればいいですか?

「デザインガラスサンプル・アソートボックス」は数に限りがございますので、お電話でご注文ください。
-
出荷証明書を出してもらう方法を教えて。
出荷証明書をお求めの際は、お電話(0120-12-4466)またはメールにて、ご連絡ください。
-
領収書発行の手続きを教えて。
領収書の発行手続きは、お支払いした方法によって異なります。代金引換でお支払いした場合
銀行振込(前払い)・請求書後払い・クレジットカード決済・Amazon Payでお支払いの場合

-
「キリのよいサイズ」や「定寸サイズ(914ミリ×1829ミリ等)」で注文したほうが安くなりますか?
キリのよいサイズや定寸サイズ(914ミリ×1829ミリ等)で価格が大きく変わることはありません。
当店は面積で価格を決定しているため、500ミリが501ミリになったとしても価格が極端に高くなることはありません。ご希望のサイズでご注文されることをお勧めいたします。
-
定寸サイズ(914×1829ミリ等) で注文したほうが安くなりますか?
当社は面積(大きさ)により価格計算していますので、定寸サイズでご注文いただいても、オーダーサイズでご注文いただいても同じ価格になりますので、ご希望のサイズでご注文ください。
-
万が一、商品到着後にひび割れなどあった場合は返品できますか?
無償で交換させていただきます。当店スタッフが、交換までの流れをご説明しますので、ひび割れ等ありましたらお早めにご連絡くださいませ。
- お電話:0120-12-4466
-
サイズを間違えて注文してしまいました
オーダー品のサイズを間違えて注文してしまった場合、とりあえず直ぐにご連絡ください。製作(切断)開始前ならストップすることが可能ですが、製作(切断)を開始してしまった場合は、ストップすることが出来ません。再製作の場合、無料で製作という訳にはいきませんが、できるだけ原価ギリギリの価格でご協力させていただきます。
-
どんな加工やどんな形まで出来るのですか?
当社で出来ることは、ガラスの加工技術全てと言っても過言ではありませんので、とにかく一度「こんな形に出来ないか?」「こんなガラスに出来ないの?」などご連絡いただければ幸いです。
-
板ガラスを裁断のみで注文した場合、手が切れないように面取りはしてありますか?
裁断のみは無料ですが、手が切れる状態になっています。切断面の処理を選ぶからご希望の処理をお選びください。
-
ガラスのサンプルはありますか?
一部の商品を除いて、商品ごとに「カットサンプル(70×100ミリ前後)」または「レンタルサンプル」をご用意しております。ご希望の方はお問い合わせください。
-
ガラスの厚みを測る方法はありますか?
-
ガラスを処分したいのですが引き取りに来てもらえますか?
処分できます。
※一部対応できない地域がございますのでお問合せください。お問合せ電話番号:0120-12-4466
-
ガラス用の「金物」や「工具」などは販売していますか?
取り扱っています。工具は下記のものを、金物は当店の姉妹店であるガラスのホームセンター「ギヤマン」で取り扱っています。ガラスと一緒にご注文が可能ですので、お気軽にお問い合わせください。
取り扱っています。工具は下記のものを、金物は当店の姉妹店であるガラスのホームセンター「ギヤマン」で取り扱っています。ガラスと一緒にご注文が可能ですので、お気軽にお問い合わせください。
-
施工業者と直接やりとりしてもらう方法を教えて。
ご注文の際、「施工業者と直接打ち合わせ希望」と一言お伝えください。
お客様が建築会社や大工さん、建具店などの施工業者にご依頼されている場合、当店がお客様に代わり施工業者と直接打ち合わせいたします。
-
ガラスを持ってきて、設置していただきたいのですが可能ですか?
地域によっては行けない場所もあります。また出張料金等が別途にかかりますので、一度「場所」「状況」等をご連絡下さい。
ガラスの修理・割れ換えは姉妹店の「ガラス修理屋.com」をご覧下さい。 -
ガラス1枚でも送ってもらえますか?
はい。当社では、個人のお客様、法人のお客様に関わらず、ガラス1枚から全国発送しております。
-
短納期での発送は可能ですか?
できる限りお客様のご要望にお応えできるよう、全力で対応させていただきます!
ガラスの納期は種類等により、即日出荷可能なものから出荷まで約10日前後必要となるものもございます。納期の短縮につきましても可能な限り対応させていただきますので、是非お気軽にご相談ください。 -
商品を取りに行くので、送料を安くできますか?
当社まで直接商品を引き取りにお越しいただいた場合、送料が無料になります。
当社OOKABE GLASS株式会社は、福井県福井市に所在しております。お近くのお客様はご利用ください。(※ご来社の時間を事前にご連絡ください。)
-
急ぎなのですが、すぐに送ってもらえますか?
お急ぎの場合、納期の短縮に可能な限りの対応をさせていただきます。お電話でその旨をお伝えくださるとスムーズです。遠慮されず、まずはご連絡ください。
-
メールマガジンを停止したいのですがどうすればいいですか?
配信されたメールマガジンの下部に配信停止のボタンがありますので、ボタンをクリックして配信停止画面に進み、配信を停止することができます。
-
デザインガラスは外装にも使えますか?
ガラスによって厚みや製作方法が異なり、外装に使えるガラスとオススメできないガラスがあります。 ご希望のガラスが外装に使用できるかどうかについては、お問い合せくださいませ。
-
デザインガラスのサンプルはありますか?
ページ中で、「サンプル請求」が「可」「貸出可」となっているガラスは、無料サンプル請求が可能です。

-
登録したパスワードを忘れてしまいましたが、どうすればいいですか?
パスワードを忘れられた場合は「法人会員パスワード再設定画面」から再設定いただけます。
法人会員パスワードの再設定はこちら -
複数枚購入予定なのですが安くなりますか?
当社ではガラスの購入が複数枚の場合、割引価格が適用されます。

-
カート表示サイズよりも大きいサイズのガラスを購入することは可能ですか?
各商品詳細に記載された最大サイズまでの大きさであればご用意できます。カート表示サイズよりも大きいサイズをお求めの方は、お電話もしくはお見積りフォームよりお問合せ下さい。 -
法人会員のログインはできますか?
ログイン機能は現在中止しております。お客様により良いサービスをご提供させていただくため、システムのバージョンアップを行なっております。法人会員様の特典は引き続きご利用いただけますので、ご安心ください。
-
片面に凸凹のあるガラスをカットする場合の注意点はありますか?
霞ガラスや表面反射鏡など、裏表があるガラスだと一辺カットの切り方でお客様の求めるものと違うものになってしまいます。ツル面かザラ面、どちらから形状なのかも確認してください。

ツル面とザラ面の違いについて
ツル面とザラ面の違いですが、強度的には差がありません。見え方を気にされている方はお好きな方をお選びいただいて大丈夫です。使用用途によって、室内の窓や家具の場合はメインとなる部屋や見せたい面に「ザラ面」、室外窓など汚れがつきやすい場合は屋外側に掃除がしやすい「ツル面」を使うことをオススメします。
実際に型板ガラスの「かすみ(霞)」「梨地」を使用してツル面とザラ面の違いを見てみましょう。

「かすみ(霞)」「梨地」の両方とも、ツル面、ザラ面による見え方の違いはありません。
-
デザインガラスを注文したいのですが、専門的なことがよく分かりません
お客さまが OOKABE GLASS のガラスを使用したい旨を工務店さまにご相談ください。OOKABE GLASS がお客さまに代わり、工務店さまと専門的な打合せをし、無料でサポートさせていただきます。その際、木製建具に入るガラスのサイズ、サッシや枠に合った厚みなどを確認いたします。
他にご不明な点があればこちらのお電話番号(0120-12-4466)までお気軽にご相談ください。

-
デザインガラスで角の丸い水槽を作ってもらうことはできますか?
弊社ではデザインガラスの曲げは行っておりません。また、ガラスの曲げは1方向のみとなりますので、水槽などの製作はできかねます。ご了承ください。 -
デザインガラスに「ステンド加工」はできますか?
デザインガラスに「ステンド加工」はできかねます。ガラスにステンド加工を行う場合は、目隠し効果をご希望であれば、向こうが見えにくい「型板ガラス」、向こう側が見えた方がよろしければ、「透明ガラス」をオススメ致します。
-
デザインガラスに「飛散防止フィルム」を貼ることはできますか?
ガラスによってフィルムが貼れないものもございます。
例えば「チェッカーガラス(リストラルM)」は凸凹が大きいため、飛散防止フィルムを貼ることができません。また、型板ガラス以外のガラスは、フィルム貼り加工の際に気泡が入る恐れがございます。
ガラスによってフィルムが貼れるものもございますので、気になっているガラスがありましたら、お気軽にお問合せください。
-
デザインガラスはガラスカッターでカットできますか?

モールガラス、アルトドイッチェK等の片面がツル面のデザインガラスであれば、ツル面からガラスカッターでカットできます。ただ、チェッカーガラスの様に両面に凸凹があるデザインガラスは切り難く、失敗しやすいため、プロによるカットをオススメします。
弊社ではカット等のガラスの加工サービスも行っておりますので、ぜひご一考ください。
-
アルトドイッチェKとフロートガラスを合わせガラス加工できますか?

アルトドイッチェKに合わせ加工はできかねます。
「合わせガラス」はガラスとガラスの間に中間膜(フィルム)を挟み込んで製作しています。今回ご質問いただいた「アルトドイッチェK」を含む、「両面ともに表面に凸凹があるガラス」は、中間膜(フィルム)との間に気泡が入り込んでしまうため、合わせガラス加工を行うことができません。
-
アクアガラスは取り扱っていますか?

当社の「アルトドイッチェK」が同一商品になります。「アクアガラス」は「アルトドイッチェK」とも呼ばれるガラスです。
弊社から購入いただいたお客さまが寄せてくださった事例がございますので、併せてご覧ください。
-
アルトドイッチェKは、両面に凸凹の柄があるガラスですか?

「アルトドイッチェK」は両面にテクスチャー(凸凹)があります。また、表面、裏面ではテクスチャーの規模が異なります。表面はテクスチャーが多く、裏面はテクスチャーが少ないです。
-
アルトドイッチェKを、柄のうねりの多い箇所でカットできますか?
「アルトドイッチェK」は切り取る箇所によって柄は変わりますが、切り取る箇所の指定はできかねます。ご了承ください。

-
中国産のモールガラスはありますか?また他国と違いはありますか?
当社では中国産のモールガラスの取り扱いはございません。ヨーロッパ産のモールガラスのみの取り扱いとなります。
-
外部サッシにモールガラスを使うと割れやすいですか?

普通のガラスと変わりありません。
「モールガラス」をペア加工し窓に設置するとのことですが、普通のガラスと同様に外部サッシにご利用できます。割れやすさは普通のガラスと変わりありません。
-
「DNA-0819」「CTE-001」のガラスの色は違いますか?
「カラードアンティーク(DNA-0189)」と「クリアテクスチャ(CTE-001)」のガラスは製造元が異なるため、ガラスの色が若干違っております。

-
「DNA-0189」「CTE-001」の無料レンタルサンプルはありますか?
「DNA-0189」「CTE-001」の無料レンタルサンプルはご用意がございません。ご了承ください。

-
ベッドの桟をフロストガラスで隠したいのですが、もっと安いガラスはありますか?
ベッドの桟を隠すのであればカラー合わせガラスの不透明タイプをオススメいたします。不透明タイプのカラーは2色「ディープホワイト」および「ディープブラック」がございます。 不透明なカラー合わせガラスですと価格もフロストガラスの半分ほどになりますので、ご検討ください。
不透明なカラー合わせガラスですと価格もフロストガラスの半分ほどになりますので、ご検討ください。 -
海中にいるイメージのガラスで強度が強いものはありますか?
海のイメージなら「カラー合わせガラス」がオススメです。2枚のガラスの間に色のついたフィルムを挟んだ合わせガラスですので、万が一破損した場合も、フィルムがガラスの飛散を防止する効果がございます。

サイズなどお決まりになりましたらお見積もりをご用意いたしますので、お気軽にお申し付けくださいませ。
-
どのように業者に希望のガラスを伝えればいいですか?

ガラスの品番をお伝えください。
また、すでにお客様がご依頼されている施工業者様(工務店・建具店・大工)と当社でお打ち合わせもさせていただきます。 施工業者様からでも、お客様からご紹介いただいてもどちらでもご対応いたしますので、お気軽にお申し付けください。
-
2枚のデザインガラスの柄の目合わせをしてもらうことは可能ですか?

可能です。お客様より、写真のように建具等のガラスが2枚横に並ぶ場合に「柄の目を揃えたい」とご相談いただいております。
柄の目合わせは1枚のガラスから連続して同じ大きさのガラスが2枚取れる場合のみ可能ですので、在庫のガラスの大きさ等によって、納期や料金等変わる場合がございます。

-
波ガラスは自分で切断できますか?
ガラスカッターというものを使って自分で切断することも可能ですが、凹凸が多いため、切断の失敗の可能性があります。また、「昭和レトロ風ガラス」は切断面から塗料が剥がれるおそれがあります。
高価なガラスのため、自分で切らずに、当社でオーダーサイズでご注文されることをお勧めいたします。 ガラスの切断方法はガラスのホームセンター「ギヤマン」にて動画でご覧いただけます!
-
波ガラスに穴あけは可能ですか?
「昭和レトロ風ガラス」は穴あけは可能です。
その他のガラスは不可能ではありませんが、表面が凸凹しており、失敗が多いのでおすすめしません。
-
波ガラスをペアガラスにすることは可能ですか?
可能です。外装にペアガラス(複層ガラス)として使いたい方が多くいらっしゃいます。 ペアガラスにする場合は外を普通のガラス(あるいは熱線吸収ガラス)内側をデザインガラスにするようにしてください。
ペアガラスのお見積り、お問合せもお気軽にどうぞ! 0120-12-4466
-
波ガラスのサンプルはありますか?
約25 × 50ミリのサンプルガラスを無料でお送りすることが可能なガラスです。
お電話でご請求ください。0120-12-4466
-
一般的な建具(室内ドア・内装窓)のガラスの取り付け方を教えてください

一般的な室内ドアや内装窓の取り付け方法は「抑え縁」をねじ止めしてガラスが固定されています。交換の際は、ビスを外してお取り替えください。
-
ガラスをコーキングで固定する場合、クリアランスはどの位とればいいですか?
ガラスの厚みによって、おすすめの溝のクリアランス(隙間)のサイズが異なります。デザインガラスで一番多い4mm厚のガラスですと、図のように5mm位のクリアランスを取られることをお勧めします。
その他の厚みのガラスをコーキングで固定される場合は、クリアランスのおすすめのサイズが異なりますので、お気軽にお問合せください。
※図は4mm厚のガラスの場合のクリアランスの例です。

-
サンゴバンガラスに穴あけは可能ですか?
不可能ではありませんが、表面が凸凹しており、失敗が多いのでおすすめしません。 -
サンゴバンガラスをペアガラスにすることは可能ですか?
可能です。外装にペアガラス (複層ガラス) として使いたい方が多くいらっしゃいます。 ペアガラスにする場合は外を普通のガラス(あるいは熱線吸収ガラス) 内側をデザインガラスにするようにしてください。ペアガラスのお見積り、お問合せもお気軽にどうぞ! 0120-12-4466
-
サンゴバンガラスのサンプルはありますか?
約25×50ミリのサンプルガラスを無料でお送りできますので、お電話でお申し付けください。
※「ヨーロッパデザインガラスシリーズ」の一部商品はメーカー廃盤・欠品中のためサンプル請求ができません。
-
購入回数・購入金額の累計は何年間有効ですか?
購入回数・購入金額の累計は、現時点から3年前までが対象になります。3年間の累計購入回数、お買上累計金額で会員ランクが決まります。 -
紹介キャンペーンによって割引かれた金額はいつまで有効ですか?
当店がお見積りをお出ししてから30日間有効です。 -
紹介キャンペーンが利用できないケースはありますか?
紹介キャンペーンが利用できないケースは以下の通りです。
- 紹介した方と紹介された方が同一人物の場合
- 紹介された方が、既に当店をご利用いただいている場合
-
レトロなデザインのすりガラスはありますか?

当社では、「障子用ガラス(ぼかし山水)」が、模様付のすりガラスにあたります。「障子用ガラス」という名称の通り、和室の障子との相性が特に良い水墨画風の柄です。

洋室に合うような柄をご希望の方には、すりガラスのようにザラザラしつつ柄・模様がある「型板ガラス」を提案しております。
-
和紙ガラス「極」のサンプルはありますか?
和紙ガラス「極」は、A4サイズでサンプルをお貸しすることができます。ただ、大変人気のガラスですので、サンプルの数が不足する場合があります点ご了承ください。お電話でご請求ください。
-
ガラスの青みが気になります
和紙ガラス「極」はほとんどの方が、裏側にライトを入れてライティングして使われることが多く、ガラス特有の青みを気にされる方はあまりいらっしゃらないようです。また和紙面を表にして使われるかたもいらっしゃいます。どうしても青みが気になる場合は青みのすくない「高透過ガラス」を使った和紙ガラスも製作が可能ですので、お気軽にお問合せください。
-
和紙は両面に貼ってあるのですか?片面ですか?
片面のみになります。

-
和紙ガラスを強化ガラスに加工することは出来ますか?
和紙ガラス「極」を強化ガラスに加工することは可能です。実際にはオーダーサイズの強化ガラスに和紙を貼り付けするのでいろいろな加工が可能です。
-
自由なサイズでデザインガラスを注文できますか?
はい、1ミリ単位のサイズオーダーで注文いただけます。
-
申請する書類として見積書が必要です。作ってもらえますか?
もちろん御見積書をご用意します。
ご希望のステンドグラスの品番、サイズ、デザインイメージなどを私たちにご相談ください。
御見積書を作成し、1営業日以内にご連絡させていただきます。 -
ガラス店(サッシ店)ですが、法人登録は可能ですか?
もちろん可能です。いろいろな種類のステンドグラスを元板購入ではなく原寸(希望のサイズ)購入が可能ですので、多くのガラス店やサッシ店の方にご利用いただいております。必要な分のみ購入できると、大変お喜びいただいております。
-
ステンドグラスの描線は、裏から見た時どのように見えますか?
裏側は写真のように若干白っぽく見えます。左が表面(描線がある側)、右が裏面(描線のない側)です。
FL5(透明ガラス)の場合

F4K(型板ガラス)の場合

-
納期はどのくらい掛かりますか?
最終図案→製作開始してから通常約10営業日になります。
※混雑時は3週間程度かかる場合がございますので、予めご確認下さい。 -
価格の参考価格を教えてください (どのくらい安いの?)
600mm×900mmのサイズで約99,000円99,000円
900mm×1800mm で約210,000円210,000円になります。ステンドグラス工房で普通のステンドグラスを注文すると
600mm×900mmのサイズで約135,000円135,000円
900mm×1800mm で約400,500円400,500円ほどしますので、約半額で製作できることになります。 -
参考価格を教えてください (どのくらい安いの?)

写真のような鏡を本物のステンドガラスで作ると10万円以上しますが、当店の場合 450×600mmのサイズで参考価格 66,257円66,257円、400×1200mmのサイズで参考価格 37,250円37,250円になります。
お客様オリジナルのデザインで、お作りする場合は別途デザイン料がかかります。デザイン料は、お客様から頂いたデザインの複雑さや色の数によって変わります。
右の鏡の場合は、18,750円18,750円になります。
当社オリジナルのデザインでお作りする場合や、同じデザインでの2枚目以降はデザイン料は必要ありませんのでご安心ください。通常のステンドガラスミラーの半額ぐらいの価格で購入が可能です。
-
ステンドグラス風ミラーの表面はどんな感じ?
写真のように鏡の表面に描線が描いてあり、特殊な塗料で色付けしています。
-
どんな図でもステンドグラスを製作することはできますか?
柄の細かいデザインなどステンドグラスに出来ない画像もございます。一度、図を送付していただければ、製作の可否を判断いたします。
-
円形(丸形)のステンドグラスは作れますか?
可能です。円形のペアステンドグラス(ペアガラス加工をした円形ステンドグラス)の製作実績もございます。
丸いステンドグラスも0120-12-4466まで、お気軽にお問い合わせください。
-
円形(丸形)のステンドミラーは作れますか?
可能です。写真は円形ステンドグラスの製作例ですが、円形(丸形)鏡のステンドミラーも製作可能です。
丸いステンドミラーも0120-12-4466まで、お気軽にお問い合わせください。
-
色の種類はどれくらい選べますか?
オーダーステンドグラスに使えるカラーの種類は、下の写真の64色+アイスフロート6種類になります。この色を描線の間に流し込み、高温の窯で焼きつけることで、オリジナルのオーダーステンドグラスは出来上がります。 複数色を使われる場合は、ご注文確定後に、下のカラーサンプルをお送りし、色を決めていただく形になります。
-
【ステンドグラスの配色やデザインができないので、そちらでしてもらえませんか?
デザインのご相談も承ります。ステンドグラスの配色やデザインでお困りの場合は、お気軽にご相談ください。 -
レトロ感を高めた雰囲気のあるステンドグラスに出来ませんか?
写真のようにアイスフロートという技法があります。透明部分をアイスフロートにすることで、レトロ感の高い雰囲気のあるステンドグラスに仕上がります。
色は写真の6種類からお選びいただけます。製造方法の都合上、1枚に対する面積に限界があります。半分程度の面積でお使いいただけるようなデザインで使っていただくとありがたいですが、どうしてもという方はお気軽にお問い合わせください。
アイスフロートのサンプルはカラーサンプルに含まれています。
電話でのサンプル請求も可能です。0120-12-4466 までお気軽にお問い合わせください。
-
レトロ感を高めた雰囲気のあるステンドミラーに出来ませんか?
 写真のようにアイスフロートという技法があります。アイスフロートにすることで、レトロ感の高い雰囲気のあるステンドグラスミラーに仕上がります。
写真のようにアイスフロートという技法があります。アイスフロートにすることで、レトロ感の高い雰囲気のあるステンドグラスミラーに仕上がります。
色は写真の6種類からお選びいただけます。製造方法の都合上、1枚に対する面積に限界があります。半分程度の面積でお使いいただけるようなデザインで使っていただくとありがたいですが、どうしてもという方はお気軽にお問い合わせください。 ご用意できるアイスフロートのサンプルは数に限りがございます。ご希望の方はサンプル請求時に「アイスフロートのサンプル請求希望」とお伝えください。
ご用意できるアイスフロートのサンプルは数に限りがございます。ご希望の方はサンプル請求時に「アイスフロートのサンプル請求希望」とお伝えください。
電話でのサンプル請求も可能です。0120-12-4466 までお気軽にお問い合わせください。 -
枠を付けることはできますか?(枠を付けるといくら?)

ステンドグラスミラーに枠を付けたい方は、枠付けが可能です。
枠の種類は約500種類!当社の運営するアンティークミラー.comの枠よりお選び頂けます。
枠の価格は、枠の種類によって異なります。写真のような枠の場合は
枠あり:736×536mm 87,674円(デザイン費別途)
枠なし:648×448mm 48,610円(デザイン費別途)
になります。お気軽にお問い合わせください。 -
取り付け方を教えて下さい
お薦めなのが、ミラーマットにミラーボンドを併用する方法で、金具を使わないため、施行方法も比較的簡単で見た目も金具がない分、綺麗です。
ミラーボンドの粘着力は強力で約36kgの重量にも耐えることが出来ます。
-
木枠の材質はなんですか?
木枠の材質は「米ヒバ」と呼ばれる、ヒノキ科ヒノキ属の木材です。耐水性に強く、品質の高い木材です。 -
製作できる枠の最大サイズは?
4辺の合計が4,000mmまでになります。
例、1000×1000mmの正方形や、800×1200mm等が合計4000mmになります。 -
ステンドの表面はどんな感じ?(両面描線は可能ですか?)
ご指定がなければ、写真のような片面描線になります。表面には描画線があり、裏側にはありません。両面描線も可能です。
両面描線の価格 通常:片面描線の 50%UP
今なら:片面描線の35%UP
技術的に難しかった両面描線が可能になりました!
-
ラインアートの表面はどんな感じ?(両面描線は可能ですか?)
 ご指定がない場合は、写真のようにガラスの片面に描線が描いてあります。
ご指定がない場合は、写真のようにガラスの片面に描線が描いてあります。
F4K(型板ガラス)の場合はツルツル面に描線が描いてあります。技術的に難しかった両面描線が可能になりました!
価格:片面描線の
50%UP→35%UP
片面描線

両面描線
-
割れないステンドグラスはありますか?
あります。プリズムは強度と耐候性、安全性を活かした「FRP樹脂ステンドグラス」でお作りすることが可能です。
ご希望の方はお問い合わせください。(お電話はこちら:0120-12-4466)
※「FRP樹脂ステンドグラス」は用途に合わせて2種類ご用意しておりますので、下記を参考にご指定ください。
-
柄の色を変える事はできますか?
可能です(別途料金が必要です)。色はカラーサンプルをお送り致しますので、その中からお選び頂けます。 料金はガラスのサイズや柄数の量によって異なりますので0120-12-4466までお問い合わせください。
-
ステンドグラスの柄に色を付けることはできますか?

可能です(別途料金)。当社からカラーサンプルをお送りし、お客様にて色をお選びいただく流れとなります。
料金はガラスのサイズや柄数の量によって異なりますので、当社スタッフにお問い合わせくださいませ。
-
ガラスの種類 (FL3,FL5,F4K) の違いが分かりません
下の写真をご覧下さい。F4Kは型板ガラスの霞というガラス(4mm厚)に描線をしていますので、向こう側が見えません。
FL3とFL5は透明ガラスでFL3は3mm、FL5は5mmになります。※ガラスのご指定がない場合はF4Kになります。 -
ステンドグラスの描線を黒以外で作ることはできますか?
特にお客様からご指定がない場合は、描線の色は「ブラック」になります。お写真のような「ゴールド」「シルバー」「ブロンズ」の描線にも変更できますので、その旨お気軽にお申し付けくださいませ。
尚、現在オーダーサイズでご注文の場合のみ、変更料金を無料にさせていただいております。お気軽にお問い合わせください。

-
ステンドグラスの柄の縮小、拡大はできますか?

当社では、ガラスのサイズに合わせて、ステンドグラスの柄のサイズ縮小・拡大ができます。柄のそのままの拡大・縮小や、横だけを伸縮しての拡大・縮小も可能です。
料金はガラスのサイズ、ガラスの種類によって異なりますので、お電話でお見積りください。
-
縦横比を維持したまま拡大・縮小することはできますか?
縦か横のどちらかを拡大や縮小した場合、①の図のように絵柄の縦横比のバランスが崩れるため、絵柄が潰れたようになってしまいます。②の赤線のように空いた部分に絵柄を追加することで、もとの絵柄の縦横比を維持しつつ、拡大縮小することが可能です。

当社でデザインのご提案もできますので、お気軽にお問い合わせください。
-
ステンドグラスの元板(規格サイズ)からの部分切り出しは可能ですか?

規格サイズ品のカットはできませんが、どの位置か教えていただければ、最初にそのサイズにガラスをカットし、CADで指定位置の図柄を描画します。
料金はガラスのサイズ、柄によって異なりますので、お電話でお見積りください。
お見積り方法 品番と仕上がり寸法のみお伝えください。どの位置でも料金は同じですので、それだけでお見積もりできます。 注文方法 注文が確定された場合は、こちらから郵送で「図柄の正確な縮小図面」をお送りしますので、切り取り位置をご指定ください。最終仕上がり寸法での図柄をお送りすることも可能です。(最終図柄を確認できます) -
ステンドグラスの寸法公差(サイズの誤差)はどれくらいですか?
お客様からのご指定がない場合、寸法公差(サイズの誤差)は±1ミリとなります。
※厚みやガラスの種類によって変わる場合がございます。指定のサイズより大きくなると困る場合は「+0ミリ指定(+0~-2ミリ)」、小さくなると困る場合は「-0ミリ指定(-0〜+2ミリ)」も可能です。
ガラスの種類や厚みによっては、±1ミリよりも少ない範囲での公差の指定もできることがございますので、ご希望の場合はお申し付けください。
-
ステンドグラスの取り付け方を教えてください

内装ガラスの場合は、図のように「押し縁(押さえ縁)」を使う方法が一般的です。外装に使われる場合は、サッシに入れてお使いください。
また、ステンドグラスを「複層ガラス(ペアガラス)」にすることも可能です。外装に使われる場合は、複層ガラスにされることをオススメします。
-
枠を付けることはできますか?
 可能です。ステンドグラスにピッタリのサイズの枠を作る「ステンドグラスフレームサービス」を始めました。枠のカラーは「ナチュラル・カントリーホワイト・アンティークブラウン」の3種類になります。 詳しくは「ステンドグラスフレームサービス」のページをご覧下さい。
可能です。ステンドグラスにピッタリのサイズの枠を作る「ステンドグラスフレームサービス」を始めました。枠のカラーは「ナチュラル・カントリーホワイト・アンティークブラウン」の3種類になります。 詳しくは「ステンドグラスフレームサービス」のページをご覧下さい。
-
ステンドグラスは地震で割れませんか?
ガラス同士を鉛で接着した「通常のステンドグラスと違い」当社のステンドグラスはガラスに描線を描いて作られているため、強度がかなりあります。 ご心配の方はさらに強度のある「強化ガラスタイプ」や「合わせガラスタイプ」もお作りすることが可能ですので、お気軽にお問い合わせください。
-
ステンドグラスを「強化ガラス」にできますか?
当社のステンドグラスは、強化ガラスに加工することも可能です。すぐにお見積りできますので、お気軽にお問い合わせください。
-
ステンドグラスを「合わせガラス」にできますか?
当社のステンドグラスは、合わせガラスに加工することも可能です。すぐにお見積りできますので、お気軽にお問い合わせください。 -
ステンドグラスを「複層ガラス(ペアガラス)」にできますか?
当社のステンドグラスは、「複層ガラス(ペアガラス)」にすることも可能です。すぐにお見積りできますので、お気軽にお問い合わせください。
-
ステンドグラスのサンプルはありますか?

ステンドグラスのサンプルは、当店の姉妹店の建材サンプルサイト「e-sample.jp」で請求いただけます。サイズは、150×200ミリです。
-
ステンドグラスのベースに使えるガラスの種類を教えてください
当社のステンドグラスは、ガラスに描線や塗装を使って作るステンドグラス風装飾ガラスですので、透明ガラスや型板ガラスの他にも、強化ガラスや網入りガラスなど、様々な種類のガラスをベースにしたステンドグラスを作ることができます。
-
ステンドグラス風パネルは自分で切断できますか?
ステンドグラス風パネル、柄(鉛)部分がある為、自分で切断することはできません。当社ではオーダーメードでお客様のご要望に合わせたサイズで制作しております。 -
ステンドグラスは、外装にも使えますか?
塗装面を室内側にすれば、外装に使うことができます。「ペアガラス(複層ガラス)」に加工できます。お気軽にお問い合わせください。
-
ステンドグラス風パネルは、穴開けなど加工することはできますか?
不可能ではありませんが、表面が凸凹している為、失敗が多いので穴開けは不可だと思ってください。 -
納期はどのくらい掛かりますか?
約2週間になります。お急ぎの場合はご相談ください。
※混雑時は3週間程度かかる場合がございますので、予めご確認下さい。 -
木枠のカラーは3色だけですか?
木枠の色は、ナチュラル・カントリーホワイト・アンティークブラウンの3色です。
ナチュラルは、木材のムクの状態ですので、お好みの色に塗装されるお客様もいらっしゃるようです。 -
注文のサイズはどこを指定すればいいですか?
 サイズは、写真のように外寸(外側の寸法)でご指定ください。
サイズは、写真のように外寸(外側の寸法)でご指定ください。 -
木枠の幅のサイズは?
4辺の合計が3000mm迄は、20mm。
4辺合計が3,001〜4,000mmの場合は、強度確保の為25mmになります。 -
木枠の厚みは?
30mmになります。 -
木枠の収まりはどうなりますか?
図面をご確認下さい。
-
枠の幅や厚みを変えてもらうことはできますか?
申し訳ありませんが、現在のところ上の2種類のサイズで対応させていただいております。どうしてもと言われる方はご相談ください。 -
ステンドグラスの「枠付き」の注文方法・お見積もり方法は?
枠付きの場合、注文時の寸法の間違いが多いので、お電話でのご注文やお見積りをオススメしております。フォームからご注文やお見積もりの場合は備考欄に、「枠付きのステンドグラスを希望」とご記入ください。
フォームからのご依頼の場合、寸法の確認のお電話をする場合がございますが、ご了承ください。
- 窓枠に物干し竿を取り付けることはできま…
- 窓枠にガラス棚を取り付けることはできま…
- 障子部分を鏡に変更することは可能でしょ…
- 方眼罫(暗線)の間隔は何ミリですか?
- 中桟はつきますか?
- アクリルも広幅面取り加工はできますか
- なぜインド企業が注目されているのですか?
- このニュースは日本のペロブスカイト開発…
- Waareeはペロブスカイトも作るのですか?
- ペロブスカイトはいつから一般的に使われ…
- なぜガラス加工技術が重要なのですか?
- このカーテンだけで家の電気をすべて賄え…
- 室内でも本当に発電するのですか?
- 発売はいつ頃ですか?
- どのような構造で発電するのですか?
- シリコン太陽電池との決定的な違いは?
- ペロブスカイト太陽電池の寿命はいつ頃解…
- 日本のどの企業が開発をリードしています…
- 「アクアガラス」は取り扱っていますか?
- 「中国産」の「モールガラス」はあります…
- チェッカーガラスを縦・横共に目合わせし…
- 「ぼかし山水」のサイズ(寸法)を変更する…
- 「アルトドイッチェK」とフロートガラスを…
- 「アルトドイッチェK」の「うねり」の多い…
- 「アルトドイッチェK」は両面に凹凸の柄が…
- 外部サッシに「モールガラス」を使うと割…
- 「DNA-0189」、「CTE-001」はガラスの色が…
- 「デザインガラス」に「ステンド加工」は…
- 「デザインガラス」はガラスカッターでカ…
- 「デザインガラス」で「角の丸い水槽」を…
- 家具屋で購入したローボードのすりガラス…
- テレビを載せる耐重量35キロ程度のガラス…
- 「酒瓶」を縦割りにできますか?
- ガラスにミラーシートを貼ることは可能で…
- 桜の花びらの形をしたガラスをべベルのよ…
- スマートフォン等の保護シート(ガラス)の…
- ダイヤモンドカットなどのクリスタルガラ…
- レーザー彫刻のために「ソーダガラス」が…
- 「キッチンディバイダー」の図面のPDFはも…
- 「青板ガラス(フロートガラス)」(10t)を指…
- 車のリヤガラスは作成できますか?
- 透明な板の下にライトを仕込む場合、強化…
- 防犯カメラのケースのガラス交換は可能で…
- ドーム状(半球状)のガラス加工は出来ます…
- 薄板ガラスはガラスカッターで切断できま…
- ガスオーブンレンジのガラスにおすすめの…
- テーブルのガラス天板はフロートガラスと…
- 店舗の「強化ガラス」のドアを「アクリル…
- 腕時計の保護ガラス用の直径14ミリ・R7・…
- ベッドの桟をガラスをフロストガラスで隠…
- 厚み0.5ミリの薄板ガラスを直径10ミリ~15…
- 海中にいるようなイメージのガラスで強度…
- 5ミリ厚ガラス用の「アクリルスタンド」は…
- 障子用ガラスを安く購入する方法を教えて…
- フロストガラスの凹凸面に印刷をすること…
- 「キッチンディバイダー」に厚み5ミリのガ…
- キッチンの油はねを防止するガラスは何が…
- 厚みのあるフロートガラス切りっぱなしの…
- 型板ガラスのルーバー窓を網入りの型板ガ…
- 分割したフロートガラスを合わせると、つ…
- 「ラミネートガラス」は取り扱っています…
- 「床用ガラス」の支えの掛かりはどれくら…
- 室内ドアの「ガラスの取り付け方」を教え…
- 様々な種類のガラスの無料サンプルが欲し…
- 溶接用の遮光ガラスの色指定はできますか?
- サイズが2000ミリを超えるアクリル板は入…
- テーブルトップに「滑り止めシール」を使…
- 床用ガラスを安く購入する方法を教えてく…
- 「遮熱ガラス(熱線反射ガラス)」を使用し…
- 強化ガラスにサンドブラストやエッチング…
- IHクッキングヒーターの前にガラスの間仕…
- 「チェッカーガラス」を「ペアガラス」に…
- ステンドグラスを縮小して注文する際の「…
- 「ステンドグラス」に木枠がある場合・な…
- 縦900ミリ × 横450ミリのステンドグラスを…
- 「DNA-0189」、「CTE-001」の無料レンタル…
- コの字アングルの間仕切りの見積もりで、…
- 「ガラス棚受けブラケット」の図面・サイ…
- プラモデルなどを置く飾り棚の細長い形状…
- 「ガラス棚受けダボ」は石膏ボードでも使…
- 建築業者ですが、ガラスを直接注文できま…
- 工務店・建具店さんにガラスを直接送って…
- ガラスの中で一番薄いものの厚みは何mmで…
- ガラスの無料カットサンプルのサイズを教…
- 届いたガラスが割れていたのですが、返送…
- オーダーガラス板.comのサイトで図面を送…
- お問合せやお見積り等の際、伝えたい事柄…
- 印刷したガラスは、屋外や水回りで使えま…
- オンデマンドフルカラー印刷したガラスは…
- 銀モールガラスはありますか?
- 木枠で区切られている家具扉や建具の形状…
- どんな窓にも内窓インプラスは付けられま…
- 「室内からは外の景色が見え、室外からは…
- 中空ポリカに穴あけ加工はできますか?
- 木製シェルフ(レールタイプ)の取り付け方…
- 木製シェルフ(レールタイプ)の詳細な寸法…
- アルミシェルフ(レールタイプ)の取り付け…
- アルミシェルフ(レールタイプ)の詳細な寸…
- ポリカーボネートで枠のないケースは作れ…
- 一部の面のみ曲がっているケースは作れま…
- テンパードアに飛散防止フィルムを貼るこ…
- ドアのガラス部分を「色ガラス」にするこ…
- アクリルパイプに「穴あけ加工」や「切り…
- 穴あけ加工で「小数点◎ミリ」といった細か…
- 届いた段ボールに記載のある重量は商品の…
- IHトッププレートを交換したいのですが、…
- ポリカーボネートは曲げやすいですか?
- アクリルブロックの製作はできますか?
- アクリルの接着加工はできますか?
- 発行された領収書確認時に「ポップアップ…
- 施工計画書に必要な書類を用意できますか?
- 会員情報のメールアドレスを変更できます…
- 今使っている強化ガラスをカットすること…
- 網入りガラスに穴あけ加工はできますか?
- 極薄板ガラスはハサミでカット可能ですか?
- 万が一ガラスが割れても安全ですか?
- 「キッチン油はねガードセット」はスタン…
- アクリワーロンは曲げ加工できますか?
- アクリルパイプに底板を接着する加工は可…
- 1ミリ以下の薄いガラスを、普通のガラスカ…
- ファイアライトは自分でカットできますか?
- ダブルやコーナーレスの突き合わせ部分は…
- 取付できない場所などはありますか?
- 網戸のメッシュサイズはどれくらいですか?
- ボックスの色は選べますか?
- 縦引き(上から下へのスライド)でも使用で…
- アクリルパイプを水槽として使用できます…
- アイアン窓の寸法公差は?
- ペアガラスは接着加工できますか?
- 割引が適用される基準を教えて。
- インボイス対応の領収書は発行できますか?
- インボイス制度に対応していますか?
- ログイン用のメールアドレスもパスワード…
- ログイン用のパスワードを忘れてしまった…
- パスワードを再設定したいが、再設定用の…
- 支払方法を「掛払い.com」または「後払い.…
- 代金引換で支払った場合、領収書は発行で…
- 会員登録前に注文してしまい会員割引が適…
- 使用用途に最適なガラスの種類や厚みを知…
- 「デザインガラスサンプル・アソートボッ…
- サンプルを請求する方法を教えて。
- 注文可能なガラスの枚数を教えて。
- 特注品の加工・製作が可能か知りたい。
- 板ガラスを裁断のみで注文した場合、手が…
- 会員登録をしたのに割引されていない場合…
- ガラス用の「工具」や「金物」を購入する…
- カートで注文した商品をキャンセルしたい…
- カート注文後、注文確認メールが届かない…
- カート注文後、注文確認メールが届くまで…
- 銀行振込(前払い)をする場合、振込先が書…
- 支払い手数料はいくらかかるのか教えて。
- 利用できる支払方法を教えて。
- 荷揚げ(商品を搬入口から指定の部屋や場…
- カート注文後、商品が発送されるまでの時…
- 商品の配送先を注文後に変更する方法を教…
- 到着時間の指定ができないケースを教えて。
- 到着時間の指定をする場合、指定できる時…
- 到着日は、注文日の何日後から指定できる…
- 注文した商品の到着日が知りたい。
- 希望商品の最短納期が知りたい。
- 納品書を送ってもらうための手続きを教え…
- 返品・返金の手続きを教えて。
- 商品の返品・交換・返金対応をしてもらえ…
- 返金・返品・交換ができるケースや、保証…
- 届いた商品が受け取り時に割れていた場合…
- 商品のサイズを間違えて指定していた場合…
- 届いた商品を自分で割ってしまった場合の…
- 参考納まり図はありますか?
- 現物を確認することはできますか?
- 製品の強度は?
- 浴室扉の飲み込みは何ミリ見ればいいです…
- カウンターチャンネルを使用する場合、ガ…
- ステンレス内装用パネルは、曲げ加工はで…
- アクリル(泡入り)の泡の数を増やしたり減…
- サインスタンド(傾斜タイプ)のガラスの対…
- サウナ用のドアを探しています。テンパー…
- L型バーハンドル GP2670の先端部分(キャッ…
- フローラガラスの目合わせ加工は可能です…
- アクリルと塩ビはどちらの方が傷つきにく…
- スチールボードをチョーク用に印刷加工は…
- 枠を付けた状態でスチールボードを用意し…
- ストライプ柄のビジオサン・エストラド・…
- セッティングブロックはカットできますか?
- フロストガラスやすりガラスなどにフィル…
- 極薄板ガラスの素材は?
- ガラス管の材料証明書は発行可能ですか?
- 石英ガラスの耐熱温度は?
- モールガラスの柄は両面にありますか?
- 中空ポリカは、+0ミリ/-0ミリ指定できます…
- ペアガラスをコーナー用に上から見て45°カ…
- SAG-025 アルトドイッチェKを使用したステ…
- バックアップ材の直径は?
- エッチング加工は屋外で使用できますか?
- ぼかし効果のあるもので、かつ汚れが目立…
- フロストガラスをテーブル天板(直置き)し…
- ZIProllのスポンジテープの厚みは?
- アクリルの乳半は透けないですか?
- ブルーペンガラス(色ガラスブルー)はあり…
- 内窓DIYキットの中空ポリカの種類は透明の…
- 乳白のアクリルパイプは用意できますか?
- アルミ複合板にR加工はできますか?
- テンパックスに名入れ加工はできますか?
- ストライプ柄のビジオサン・エストラド・…
- 内窓DIYキットの中空ポリカは厚み何ミリで…
- ガラス用フィルムのみの購入は可能ですか?
- 枠無しに変更した規格品フィルムミラーを…
- ステンレスキッチンパネルのつなぎ目はど…
- シンプル内窓DIYキットは浴室に設置できま…
- コの字アングルに使用するセッティングブ…
- 強化ガラスはゆっくり割対応可能ですか?
- 色ガラス強化仕様と普通ガラス仕様で色味…
- 木枠選択ガラスシステムの寸法公差は?
- アクリルパイプに目盛加工はできますか?
- 樹脂ガラスは型板仕様でも用意できますか?
- 間仕切りポールH250ミリは製作できますか?
- 交換後のガラスは処分してもらえますか?
- アクリルとポリカはどちらが傷つきやすい…
- 注文したのにマイページの購入履歴があり…
- 領収書DLボタンがありません。
- 会員登録前にカート注文してしまった。購…
- 飛散防止フィルムを貼ることで見え方は変…
- DIY内窓セットの取っ手を入れるコツを教え…
- ポリカとアクリルどちらの方が透明度が高…
- 油はガード ウォールタイプをビス止めでき…
- ガラスの厚み5ミリ用と8ミリ用のコの字ア…
- ポリカーボネートは自分でカットできますか
- デザインガラスを自分でカットする際、ツ…
- キッチンディバインダーは自分でカットで…
- シューズボックスの施工に下地は必要です…
- アソートボックスに入っているガラスを教…
- 油はねガードセットにバックアップ材・セ…
- アルミ樹脂複合板に、印刷加工はできますか
- オンデマンド印刷は屋外で使えますか
- 1216×2432ミリより大きいカッティングマッ…
- 生地の洗濯方法を教えてほしい。
- 使わない生地の保管方法を教えてほしい。
- 切断面を露呈した状態でも使用可能ですか?
- 屋外でも使用可能ですか?
- 「コの字チャンネル」「L字アングル」に同…
- ガラス間仕切りポール用に剥がして使った…
- 高さが300mm以上のガラス間仕切りポールは…
- ガラス間仕切りポールに使用できるガラス…
- ガラス間仕切りポールのポール部分の詳細…
- フロストガラス等、他のガラスは使えます…
- 窓枠・格子のサイズを指定できますか?
- 納まり図の製作は可能ですか?
- 防水加工は可能ですか?
- オイル塗装は可能ですか?
- 抗菌ガラスの効果がある菌・ウイルスを教…
- ワーロンシートの防炎製品である「証明書…
- 一定の位置でガラスを止めることはできま…
- 夜でも交換に来てほしいときの手続きを教…
- 離島まで交換に来てほしいときの手続きを…
- 割れたガラスの種類がわからないときの対…
- ガラスサイズの測り方を教えてください。
- ガラスの厚みを測る方法を教えて。
- 極薄板ガラスの強度について教えてくださ…
- ハニカム・サーモスクリーンは浴室にも使…
- 「ハニカム・サーモスクリーン」がどれだ…
- ペアガラスや樹脂サッシの窓に「ハニカム…
- Centorスクリーンシステムの施工に来ても…
- Centorスクリーンシステムは腰高窓にも使…
- Centorスクリーンシステムは浴室に使用で…
- スペーサーの素材と色はなんですか?
- フレームのシルバーの部分をブラックにす…
- コンベックスガラスは自分で切断できます…
- コンベックスガラスを外装や水周りに使う…
- ハンドクラフトグラスのサンプルを見せて…
- ハンドクラフトグラスを「強化ガラス」に…
- アンティーク合わせガラスは自分で切断で…
- アンティーク合わせガラスに「穴あけ」は…
- アンティーク合わせガラスを「強化ガラス…
- アンティーク合わせガラスのサンプルを見…
- トレヴィガラスを「強化ガラス」に加工す…
- トレヴィガラスをペアガラスにすることは…
- トレヴィガラスに穴あけは可能ですか?
- トレヴィガラスは自分で切断できますか?
- デザインフィルムガラスのサンプルを見せ…
- ガラスの一部のみにフィルムを貼ることは…
- デザインフィルムガラスを強化ガラスに加…
- デザインフィルムガラスに穴あけは可能で…
- 切子風ガラスを他の模様にして作れますか?
- サイトに掲載されている「切子風ガラス」…
- クラックガラスのサンプルを見せていただ…
- クラックガラスの打撃点を複数にすること…
- クラックガラスに穴あけは可能ですか?
- クラックガラスは屋外で使えますか?
- クラックガラスを自分で切断したいのです…
- クラックガラスの断面はどのような仕上が…
- パイプの長さは何ミリですか?
- 転び止め金具では何ミリ厚のガラスまで設…
- 機械の部品用のガラスを大量に購入できま…
- MSDS(安全データシート)や品質証明書の用…
- ケイカル・石膏ボードに貼る場合、どれく…
- 商品に表裏はありますか?
- 耐熱ガラスと防火ガラス(耐火ガラス)の違…
- 防火ガラスをペアガラス(複層ガラス)に出…
- ステンレスキッチンパネルに磁石はつきま…
- ワーロンシートの「強化和紙」「抗菌タイ…
- 取り付け部材のサイズや素材など、詳細を…
- 網入りガラスを曲げること・曲げ加工はで…
- 網入りガラスを「すりガラス」にできます…
- 網入りガラスに防犯性能はありますか?
- 網入りガラスで和紙調のものに加工・製作…
- 網入りガラスに「フロスト加工」はできま…
- 「網入りガラス」と「防音ガラス」で「合…
- 「網入りガラスは熱割れする」と聞いたの…
- 色ガラス(色つき)の「網入りガラス」はあ…
- 「網入りガラス」に目隠し用フィルムを貼…
- 最大サイズより大きな「網入りガラス」を…
- Low-E複層ガラスに、防音性能・遮音効果は…
- Low-E複層ガラスに、防犯性能はありますか?
- 耐熱ガラスを自分で切断することはできま…
- 木製サッシに複層ガラス(ペアガラス)を入…
- 複層ガラスに寿命はありますか?
- ペアガラス(複層ガラス)に内部結露は発生…
- 複層ガラスの「ペアマーク」とは何ですか?
- 複層ガラス(ペアガラス)でも結露は発生し…
- Low-E複層ガラスと、そうでない複層ガラス…
- 「やわらぎ無地」と「やわらぎ雲竜」の違…
- テーブル天板に使用する場合、厚みは何ミ…
- 海外発送はできますか?
- 樹脂ガラスに自分で穴をあける方法を教え…
- 網入りガラス「クロスワイヤ」は、どんな…
- 高窓に設置したいのですが、操作チェーン…
- 表裏を反対にしてZIProllスクリーンタイプ…
- スマートスピーカーなどで電動タイプの昇…
- ZIProllスクリーンタイプは日本製ですか?
- どのような保証がついていますか?
- 電動タイプについて、ひとつのリモコンで…
- 電動での開閉は可能ですか?
- ボックスや生地の色は選べますか?
- スクリーンタイプを正面付けで取り付けた…
- 電動タイプの場合電池切れ・劣化により開…
- 施工まで依頼できますか?
- 取付できない場所などはありますか?
- 無反射ガラスは自分でも切れますか?
- 型板ガラスを自分で切ることはできますか?
- 型板ガラスを強化ガラスにできますか?
- ラコベル ピュアホワイトの厚み、サイズは…
- マテラックの厚み、サイズはどれくらいで…
- 高透過カラーガラス(内装用)の最大サイズ…
- 高透過カラーガラス(内装用)の厚みの種類…
- パイレックスは何に使われていますか?
- パイレックスはどこで作られていますか?
- すりガラスは、自分で切ることができます…
- 昭和レトロガラスの最大サイズ、厚みの種…
- 障子用ガラス(ぼかし山水)が割れてしまい…
- 内装専用カラーガラスを強化ガラスに加工…
- 内装専用カラーガラスに自分で穴を開ける…
- カラーガラスのビトロカラーとはどんなガ…
- 内装専用カラーガラスの最大サイズは?
- 内装専用カラーガラスの厚みの種類は?
- 内装専用カラーガラスの使用する際の注意…
- 石英ガラス管の耐熱温度 (使用可能な温度)…
- 石英ガラスを自分で切ることはできますか?
- バイコールを自分で切ることはできますか?
- 防犯ガラスを自分で切る事はできますか?
- 色ガラス(ブラック・グレー)をテレビボー…
- セラミックプリントガラスの柄・色の種類…
- フロストガラスに自分で穴を開けることが…
- フロストガラスの耐熱温度は?
- フロストガラスは自分でも切れますか?
- 低膨張防火ガラスに熱線反射タイプはあり…
- ゴリラガラス3の電気特性は?
- ゴリラガラス3の性質は?
- ゴリラガラス3の透過率はどのくらいですか?
- ゴリラガラスは穴を開けることが出来ます…
- ゴリラガラスは、自分で切ることが出来ま…
- フロートガラスは急激な温度変化に弱いで…
- フロートガラスはどんな大きさまで作れる…
- 真空ガラス「スペーシア」は熱割れします…
- 開口サイズの測り方を教えてください
- ガラスサイズの測り方を教えてください
- 窓の開き方の種類を教えてください
- 補助金の申請は誰が行いますか?
- 内窓とカバー工法では、どれくらい価格が…
- 先進的窓リノベ事業とこどもエコすまい支…
- 先進的窓リノベ2026事業の補助金は、どの…
- 工事の後に補助金が通らない(却下)の場合…
- 現地調査は、有料でしょうか?
- 親子2世帯で、一つの敷地内に家が2軒あり…
- 乳白合わせの透過率を教えてください。
- カバー工法の後悔やデメリットはあります…
- フロートガラス(透明ガラス)を床用ガラス…
- デザインペアガラス「デザートペア」は自…
- 夜景専用ガラス TEIEN(庭園)は「キリの良…
- 夜景専用ガラス TEIEN(庭園)は「確認用の…
- ガラスが「スペーシア」仕様の内窓はあり…
- 規格品のステンドグラスのカットは可能で…
- 内窓の枠の色はどんなものが選べますか?
- 他社製の内窓(二重窓)の製品と防音効果の…
- デザインペアガラス「デザートペア」のサ…
- 親子2世帯で、一つの敷地内に家が2軒あり…
- 現地調査は、有料でしょうか?
- 工事の後に補助金が通らない(却下)の場合…
- 先進的窓リノベ2025事業と子育てグリーン…
- 「内窓」と「カバー工法」では、どれくら…
- 窓ガラス交換のみで、既存サッシがアルミ…
- ガラス交換のみでも「先進的窓リノベ2026…
- 窓の開き方の種類を教えてください
- ガラスサイズの測り方を教えてください
- 開口サイズの測り方を教えてください
- 内窓の「窓枠の奥行き」はどこを測れば良…
- 既存窓が網入りガラスの場合、内窓を設置…
- 内窓「インプラス」に欠点やデメリットは…
- インプラスの価格はどのくらいですか?
- 取付ビスの必要本数の目安は?
- 波板ポリカの取り付け位置はどのように決…
- ペアガラスの中で内部結露しにくいものは…
- ペアガラスが内部結露しています。DIYで修…
- サンゴバンはどんなガラスをつくっていま…
- 日本電気硝子はどんなガラスをつくってい…
- セントラル硝子はどんなガラスをつくって…
- 日本板硝子はどんなガラスをつくっていま…
- AGCはどんなガラスをつくっていますか?
- 泡の入った、ハンドクラフトグラスはあり…
- ハンドクラフトグラスは、外装に使えます…
- ハンドクラフトグラスは、自分でも切れま…
- コンベックスガラスのサンプルを見せてい…
- 和紙調合わせガラスを曲げること(曲げ加工…
- 和紙調合わせガラスに、穴を開けることは…
- サンユーログレーとは
- 熱線吸収ガラスを曲げること(曲げ加工)は…
- 熱線吸収ガラスの最大サイズは?
- 熱線吸収ガラスの厚みの種類は?
- 開口部に熱線吸収ガラスを使うと、省エネ…
- 熱線吸収ガラスを使用する際の注意点は?
- サンカットΣとは
- サンルックスとは
- 熱線反射ガラスは、強化加工できますか?
- 熱線反射ガラスとは
- 光触媒ガラスの表面に、鳥の糞が付いたら…
- 光触媒ガラスの厚みの種類、最大サイズは?
- 光触媒ガラスを使用する際の注意点は?
- 光触媒ガラスってどんな所に使われている…
- 和紙調合わせガラスは、自分でも切れます…
- ショップカラーとは
- ウォールカラー とは
- フリーデザイン合わせガラスは、屋外で使…
- フリーデザイン合わせガラスはどんな所に…
- フリーデザイン合わせガラスとは
- パンチングメタルガラスの最大サイズは?
- パンチングメタルガラスは自分で加工でき…
- 床用ガラスの最大サイズは?
- ガラスってツルツル滑りませんか?
- 床材を透明にしたいのですが、強化ガラス…
- 高透過ガラスの別名は?
- 高透過ガラスの各厚みごとの、最大サイズ…
- 高透過ガラスの厚みの種類は?
- 高透過ガラスを強化ガラスや防犯ガラスに…
- 高透過ガラスは何によく使われていますか?
- 高透過ガラスとは
- 線入りガラス「プロテックス」は、どんな…
- 網入りガラスを切断加工する場合は、どの…
- AGCの網入りガラスには、どんな製品があり…
- 網入りガラス「ヒシワイヤ」は、どんなガ…
- クリアサイトとは
- 低反射ガラスを曲げる事(曲げ加工)できま…
- 低反射ガラスの各厚みの最大サイズは?
- 低反射ガラスを使いたいのですが、注意す…
- 低反射ガラスは加工が出来ない!と聞いた…
- 低反射ガラスは自分でも切れますか?
- もっと大きな低反射ガラスを使いたいので…
- 低反射ガラスは、どんな大きさまで作れる…
- 低反射ガラスを、強化ガラスにすることは…
- 低反射ガラスの厚みの種類はどんなものが…
- 低反射ガラスは、どんなところに使うので…
- 額縁に使いたいのですが、低反射ガラスを…
- 低反射ガラスは、普通のガラスと見た目は…
- 低反射ガラスとは
- 無反射ガラスの表面の加工は、どちら向き…
- 無反射ガラスを切るときはどちらの面を切…
- 無反射ガラスに穴をあけたり、加工をする…
- もっと大きな無反射ガラスを使いたいので…
- 無反射ガラスは、どんな大きさまで作れる…
- 無反射ガラスを、強化ガラスにすることは…
- 無反射ガラスの厚みの種類は?
- 無反射ガラスは、ショーケースなどに使え…
- 無反射ガラスは、どんなところに使うので…
- 無反射ガラスは、普通のガラスと見た目は…
- 無反射ガラスとは
- ラミトーンとは
- Lamicolle(ラミコレ) とは
- ペアガラスで防音にも優れたガラスは?
- 防音ガラス(合わせガラス)とは、どんな特…
- 防音ガラスの、厚み・大きさは?
- 型板ガラス、網入りガラスの遮音効果は?
- 窓を防音ガラスにしましたが、思っていた…
- 音ってどうやって、伝わってきますか?
- 防音ガラスは自分で切ることができますか?
- 防音ガラスを窓に使うだけで、本当に防音…
- 防音ガラスは、どんな所で使われています…
- 防音ガラスは合わせガラスだと聞きました…
- スクールセーフィーとは、どのようなガラ…
- 石英ガラスの平面度はどれくらいですか?
- 合成石英ガラスの光透過率は?
- 石英ガラス (溶融石英ガラス) の光透過率…
- 溶融石英ガラスと石英ガラスは違うのです…
- 石英ガラスは何℃位で軟らかくなりますか?…
- 合成石英ガラスと石英ガラスは違うのです…
- 石英ガラスはどのように製造されていて ど…
- 石英ガラスが「ガラスの王様」と呼ばれて…
- 着色(カラー)合わせガラスの厚み種類、最…
- 着色(カラー)合わせガラスは自分で切れま…
- 石英ガラスの耐熱温度は何℃ですか?
- 着色(カラー)合わせガラスとは?
- バイコールの透過率は?
- 泡入りガラスはどんな風に製造されている…
- バイコールは多孔質ガラスとは違うのです…
- バイコールは急な温度変化に耐えられます…
- バイコールの耐熱温度は何℃ですか?
- クラックガラスを曲げること(曲げ加工)は…
- バイコールの厚みの種類や製作できる最大…
- クラックガラスの厚みの種類は?
- バイコールはどこで作られていますか?
- パンチングメタルガラスの厚みの種類、最…
- パンチングメタルガラスを使う際の、注意…
- パンチングメタルガラスは、自分でも切る…
- チェッカーガラスの別の名前で呼ばれてい…
- チェッカーガラスは、どんな模様(柄)の種…
- フッ化マグネシウムガラスの最大サイズは?
- フッ化マグネシウム(MgF2)ガラスとは?
- チェッカーガラス(レトロ)の耐熱温度は何℃…
- チェッカーガラス(レトロ)は、外装に使え…
- チェッカーガラス(レトロ)の不規則な模様…
- チェッカーガラス(レトロ)の最大サイズは?
- ガラスとガラスの間に和紙の入った合わせ…
- チェッカーガラス(レトロ)の厚みの種類は…
- 合わせガラスの曲げ加工はできますか?
- 合わせガラスに、装飾タイプのものはあり…
- 合わせガラスは、不燃材ですか?
- 合わせガラスは、紫外線をカットすると聞…
- 合わせガラスに、自分で穴を開ける事はで…
- モールガラスに自分で穴を開ける事は出来…
- フッ化バリウムガラスの光透過率は?
- フッ化バリウムガラスの特性は?
- モールガラスの厚みは、何ミリですか?
- フッ化バリウムガラスの最大サイズは?
- モールガラスの最大サイズは?
- モールガラス(レトロ)の耐熱温度は何℃です…
- フッ化バリウムガラスとは何ですか?
- ラコベルプリュム とは
- モールガラス(レトロ)は、ストライプガラ…
- フッ化カルシウムガラスの透過光領域は?
- フッ化カルシウムガラスの特性は?
- カラードアンティークを強化ガラスにする…
- フッ化カルシウムガラスの最大サイズは?
- カラードアンティークを複層ガラスにする…
- カラードアンティークは合わせガラスにす…
- フッ化カルシウムガラスは、どんな所に使…
- カラードアンティークガラスの耐熱温度は…
- カラードアンティークを戸棚のガラスに使…
- フッ化カルシウムCaF2とは、何でしょうか?
- カラードアンティークガラスには、穴など…
- カラードアンティークは外装に使えますか…
- カラードアンティークには不規則な模様が…
- 放射線遮蔽用鉛ガラスは、自分で切れます…
- 鉛ガラス(放射線遮蔽ガラス)の鉛当量は?
- 鉛ガラス(放射線遮蔽ガラス)の厚みの種類…
- 鉛ガラス(放射線遮蔽ガラス)の最大サイズ…
- 鉛ガラス(放射線遮蔽ガラス)は、どんな所…
- ネオセラムの比熱は?
- ネオセラムの熱伝導率は?
- ネオセラムの特性は?
- 鉛フリー放射線遮蔽ガラスのX線遮蔽性能は?
- 鉛フリー放射線遮蔽ガラスを鉛ガラス含鉛…
- ネオセラムの透過率は?
- ガラスのことならオーダーガラス板.COM 鉛…
- ネオセラムの熱膨張率は?
- ネオセラムの耐熱温度は何℃ですか?
- ラコベル とは
- ネオセラムの厚みの種類や製作できる最大…
- 高反射カラーガラス(内装用)は自分で加工…
- 高反射カラーガラス (内装用) とは
- 熱移動量(断熱性)はどのくらいですか?
- サンバランスにフロートガラス以外を使う…
- サンバランスは家具の色あせを防止できま…
- サンバランスが発売されたのはいつですか?
- サンバランスは「エコガラス」ですか?
- サンバランスの代表的な組み合わせは何で…
- サンバランスに色バリエーションはありま…
- ペアマルチにはにはどんな種類があります…
- ペアマルチには色のバリエーションがあり…
- 色ガラスには、特殊な性能をもったガラス…
- テンパックスの平面度は?
- テンパックスの光透過率(全領域)は?
- テンパックスの光透過率 (UV領域) は?
- テンパックスの屈折率は?
- テンパックスの波長は?
- テンパックスは特殊ガラスに分類されます…
- テンパックスは光学にも使われていますか?
- テンパックスの厚みの種類や製作できる最…
- テンパックスはどこで作られていますか?
- テンパックスの成分(化学組成)は?
- テンパックスの耐熱温度は何℃ですか?
- 抗菌ガラス(ウイルスクリーン)の最大サイ…
- 抗菌ガラス(ウイルスクリーン)の使用、メ…
- 抗菌ガラス(ウイルスクリーン)は強化ガラ…
- 抗菌ガラス(ウイルスクリーン)にはどのよ…
- 安全に暮らすために、必要なガラスは?
- 抗菌ガラス(ウイルスクリーン)の透明度は…
- 防犯ガラスは、絶対に割れず、泥棒に入ら…
- 抗菌ガラス(ウイルスクリーン)はどれぐら…
- 抗菌ガラス(ウイルスクリーン)はどのよう…
- ブラインドグラスの最大サイズは?
- ブラインドグラスの厚みの種類は?
- ブラインドグラスは、自分で切ることがで…
- エコガラスは、自分で切ることができます…
- エコガラスは、どの位地球温暖化防止に貢…
- エコガラスに付いているシールの星の数は…
- 電磁波シールドガラスは、自分でも切るこ…
- 電磁波シールドガラスの厚み種類、最大サ…
- 電磁波シールドガラスは、どんな所に使わ…
- IHクッキングヒーターのトッププレートに…
- 耐熱ガラスの耐熱温度は?
- 耐熱強化ガラスは、どんなガラスですか?
- 日本板硝子製の耐熱ガラスはある?
- 直火を耐熱ガラスにあてると割れる?
- 耐熱ガラスと強化ガラスは違いますか?
- 耐熱ガラスを薪ストーブの窓ガラスに使う…
- 耐熱ガラスは通常のガラスと色が違います…
- 耐熱ガラスは強化ガラスにできる?
- 耐熱ガラスがよく利用されているのはどこ?
- 複層ガラスの共鳴透過現象とは何ですか?
- Low-eガラスのLow-eとは、どんな意味です…
- 複層ガラスを出入りする熱の割合はどのく…
- ペアガラス(複層ガラス)の窓に変えると断…
- 複層ガラス以外の呼称は他にありますか?
- ガラス3枚と中空層2つの複層ガラスは製造…
- 複層ガラス(Low-E)の窓の部屋で植物は育ち…
- ペアガラス(複層ガラス)の「特殊金属膜」…
- ペアガラス(複層ガラス)のラベル「エコガ…
- 色ガラスでペアガラス(複層ガラス)は作れ…
- デザインガラスでペアガラス(複層ガラス)…
- ペアガラス(複層ガラス)は自分で加工でき…
- ペアガラス(複層ガラス)は自分で切ること…
- ペアガラス(複層ガラス)の断熱性は普通の…
- 複層ガラスは結露対策になるって本当です…
- Low-E複層ガラスと低放射複層ガラスは同じ…
- Low-e複層ガラスってどんなガラスですか?
- 複層ガラスに合わせガラスを使うと防犯に…
- ペアガラス(複層ガラス)はどんな所で使わ…
- ニューステンドの模様のサイズを拡大でき…
- ステンドグラス風装飾ガラス(ニューステン…
- ステンドグラス風装飾ガラス(ニューステン…
- ニューステンド(ステンドグラス風装飾ガラ…
- ステンドグラス風装飾ガラス(ニューステン…
- ステンドグラス風装飾ガラス(ニューステン…
- ステンドグラス風装飾ガラス(ニューステン…
- ステンドグラス風装飾ガラス(ニューステン…
- ステンドグラス風装飾ガラス(ニューステン…
- 家のお風呂によく使われるガラスは?
- 型板ガラスを曲げること(曲げ加工)はでき…
- 型板ガラスの各厚みの、最大サイズは?
- サンゴバンマスターガラスとは?
- 型板ガラスを脱衣所の窓に使いたいのです…
- 型板ガラスの模様は、どんなものがありま…
- 型板ガラスとは
- IMAGIN(イマジン)とは
- ヨーロピアンガラスとは
- ラチスグラスとは
- ステンドグラスは切れますか?
- ラインアートとは
- 「マテラック」は、どんなガラスですか?
- 「ラコベル ピュアホワイト」は、どんなガ…
- 高透過カラーガラス(内装用)は、自分で加…
- 高透過カラーガラス (内装用)とは
- 装飾合わせガラスは、どんな所に使われて…
- 装飾合わせガラスは、自分で切れますか?
- 装飾合わせガラスとは、どんなガラスです…
- カラーラミセーフの厚み種類、最大サイズ…
- カラーラミセーフは、自分で切れますか?
- カラーラミセーフとは
- ラミシャットは、どのようなガラスですか?
- Premin DC(プレミン ディーシー)とは
- セラミックプリントガラスを円形加工する…
- セラミックプリントガラスに穴を開けるこ…
- セラミックプリントガラス越しに、リモコ…
- セラミックプリントガラスの耐熱温度は何℃…
- セラミックプリントガラスは水周り(お風呂…
- セラミックプリントガラスは自分でも切れ…
- セラミックプリントガラスは強化ガラスだ…
- セラミックプリントガラスを窓ガラスなど…
- セラミックプリントガラスのストライプ柄…
- セラミックプリントは爪などで引っかいた…
- セラミックプリントはガラスの両面にして…
- セラミックプリントガラスを使う際の良い…
- セラミックプリントガラスの厚みの種類と…
- フロストガラスを曲げること(曲げ加工)は…
- フロストガラスの厚みごとの最大サイズは?
- 両面にフロスト加工されたガラスはありま…
- フロスト加工とタペストリー加工って違う…
- フロストガラスの透過性を下げる為には、…
- 模様の入ったフロストガラスはありますか?
- フロストガラスに自分で穴を開けることが…
- フロストガラスのフロスト加工をストライ…
- フロストガラスを強化ガラスにする事はで…
- フロストガラスをダイニングテーブルの上…
- フロストガラスとすりガラスはどこが違う…
- フロストガラスは急激な温度変化に弱いの…
- フロストガラスで、20ミリ以上の厚いガラ…
- フロストガラスの厚みの種類はどれだけあ…
- フロストガラスで、もっと大きなガラスを…
- デザインガラスのフロストガラスはどんな…
- クラッケルとはどんなガラスですか?
- サンゴバン(saint-goban)とは?
- 木のテーブルの上にデザインガラスをひく…
- 窓ガラスをデザインガラスにすることはで…
- 合わせガラスで、デザインガラスを作るこ…
- ファイアライトの厚みの種類、最大サイズ…
- アトッチ とは
- グレーチングチャンネルとは
- ホームペヤEG とは
- デューカットⅡS とは
- ペアスマート とは
- 真空ガラスに交換する場合サッシ交換も必…
- 真空ガラス スペーシア とは
- ペアマルチホームEAとは
- 高性能熱線反射ガラスを曲げること(曲げ加…
- 高性能反射ガラスの最大サイズは?
- 高性能熱線反射ガラスの、厚みの種類は?
- 高性能熱線反射ガラスは、自分で切ること…
- ペアプラスの断熱性能は?
- ペヤプラスとは
- 寒冷地専用複層ガラスは自分で切れますか?
- 防音複層ガラスの防音性能は?
- 防音複層ガラス は どんな所に使われてい…
- 防音複層ガラスとは
- 寒冷地専用複層ガラスの中空層に、白い粉…
- 寒冷地専用複層ガラスとは
- サンバランス トリプルガラスとは
- サンバランス Eシリーズとは
- 炉内観察用耐熱ガラスの参考価格は?
- 炉内観察用耐熱ガラスの透過率は?
- 炉内観察用耐熱ガラスとは
- パイレックスの熱的特性は?
- パイレックスの紫外線透過率は?
- パイレックスの赤外線透過率は?
- パイレックスは強化ガラスにできますか?
- パイレックスは自分で切ることができます…
- パイレックス(耐熱ガラス)とは
- サンバランスセキュリティーとは
- サンバランス トリプルクールとは
- すりガラスを曲げること(曲げ加工)はでき…
- ぼかし加工したすりガラスはありますか?
- すり板ガラスの厚みごとの最大サイズは?
- すりガラスに、シート(フィルム)を貼って…
- 窓にガラスを入れたいのですが、すりガラ…
- すりガラスの耐熱温度は何℃ですか?
- すりガラスの厚みは、どんなものがありま…
- すり板ガラスの透過率は、普通のガラス(フ…
- すりガラスとフロストガラス、型板ガラス…
- すりガラスを使用する際の注意点はありま…
- すりガラスは、何に使われていますか?
- すりガラス(くもりガラス)とは
- 昭和レトロガラスは、自分で切ることがで…
- 昭和レトロガラスとは
- サンバランス 高断熱タイプとは
- ファイアライトには、どんな種類がありま…
- 網がない防火ガラスはありますか?
- 耐火遮熱積層ガラスの厚み、最大サイズは?
- 耐火遮熱積層ガラスを曲げたり、穴あけは…
- 屋外で耐火遮熱積層ガラスを使うことはで…
- 耐火遮熱積層ガラスは、自分で切る事がで…
- 低膨張防火ガラスのエッジ(縁)の部分の加…
- 低膨張防火ガラスに熱線反射タイプはあり…
- 低膨張防火ガラスの厚みの種類、最大サイ…
- 低膨張防火ガラスに穴あけはできる?
- 低膨張防火ガラスは、自分で切ることがで…
- ゴリラガラスの板厚、サイズは?
- ゴリラガラスのバージョンとは?
- Dragontrail(ドラゴントレイル)の強さは?
- Dragontrail(ドラゴントレイル)の板厚、サ…
- 化学強化ガラスのDOL、CSとは何ですか?
- ガラスに印刷するにはどんな方法がありま…
- 化学強化ガラスは、自分で穴あけすること…
- 化学強化されたガラスの割れ方は?
- ケミカル強化ガラスは、自分で切ることが…
- 化学強化可能なガラスの厚み、最大サイズ…
- 倍強度ガラスの厚みの種類、最大サイズは?
- 倍強度ガラスは、どんなガラスからでも作…
- 倍強度ガラスは、自分で切ることができま…
- 倍強度ガラスは、同じ厚みの強化ガラスの…
- テンパライトの各厚みの最大サイズは?
- 強化ガラスを曲げること(曲げ加工)はでき…
- 強化ガラスに「フロスト加工」はできます…
- 防犯には「強化ガラス」「合わせガラス」…
- 強化ガラスで、白板はできますか?
- 室内の扉でよく見るガラス製の扉は「強化…
- パイレックス強化ガラスとは、どんなガラ…
- 強化ガラスは、どのように作られています…
- 購入したダイニングテーブルの寸法に合わ…
- 強化ガラスの窓が突然「自爆」したのです…
- 木製のダイニングテーブルの上に強化ガラ…
- ガラスの庇に使われているのは「強化ガラ…
- ラックに使われているガラスは「強化ガラ…
- 強化ガラスは、通常のガラス(フロートガラ…
- 自宅にガラス扉をつけたい場合は、強化ガ…
- ガラスの表面に型板模様が入った強化ガラ…
- 強化合わせガラスとは、どんなガラスです…
- ビルや病院などで見るガラスの手摺は「強…
- 強化ガラスは自爆(破損)しますか?
- ガラスの棚板を作りたい場合は、強化ガラ…
- ガラスドアに使われているのは「強化ガラ…
- 強化ガラスかそうではないか、見分け方は…
- 強化ガラスの耐熱温度は何℃ですか?
- ガラスに熱を加えるとどうして強化ガラス…
- 強化加工とは?
- 20ミリ以上の厚めの強化ガラスは作れます…
- 強化ガラスの最大サイズ、厚みの種類は?
- フロートガラスの平面度はどれくらいです…
- フロートガラスの線膨張率はどれくらいで…
- フロートガラスの熱膨張率はどれくらいで…
- フロート板ガラスの熱伝達係数とは?
- フロートガラスの誘電率はどれくらいです…
- フロートガラスの密度はどれくらいですか?
- 常用使用温度・最高使用温度とは ?
- フロートガラスの強度は?
- フロートガラスにフィルムを貼ることはで…
- フロートガラスは、自分でも切れる?
- 合わせガラスとは?
- フロートガラスで20ミリ以上の厚いガラス…
- フロートガラスの厚みの種類は?
- フロートガラスの各厚みの最大サイズは?
- 錫(すず)の上に溶かしたガラスをのせて、…
- ガラスの製造方法「フロート方式」とは、…
- ガラスの組成(原料)は?
- 白板とは?
- 「フロートガラス」「フロート板ガラス」…
- 火鉢の上にのせるガラスは取り扱っていま…
- 石臼の上にのせるガラスは取り扱っていま…
- お店の陳列テーブル用のテーブルマット・…
- 天板を落とし込む円形の机のテーブルマッ…
- 会社の応接室の机のテーブルマット・テー…
- コーヒーテーブル用のテーブルマット・テ…
- レストランのテーブル用のテーブルマット…
- テーブルマットのガラス天板は「強化ガラ…
- テーブルマット用のガラスで、「クリア」…
- 型紙を取るときは、模造紙でないとダメで…
- テーブルの角が段になっている場合は、型…
- 「型紙製作セット」は、どのように注文す…
- テーブルに使う強化ガラスは強度がありそ…
- テーブルトップのガラス天板の厚みの相談…
- ニトリやIKEAのテーブルの天板や、ガラス…
- 寺院の経机用のガラス天板はありますか?
- テーブル用のガラス天板に「飛散防止フィ…
- ガラス天板を交換しても、また割れないか…
- どんな形のガラス管や、どんな加工ができ…
- 太いガラス管(ガラスの筒)もありますか?
- どれくらいの厚みのガラス管を選べば良い…
- ガラス管の見積もりをしてほしいのですが…
- ガラス管を切断しただけの場合、手が切れ…
- ガラス管を自分で切ることはできますか?
- ガラスの「U字管」「T字管」の溶着部は、…
- ミニチュアサイズのガラス管に「丸底封じ…
- テーブル天板にはフロートガラスよりも強…
- 作業テーブルの保護ガラスは「合わせガラ…
- 机が大きい場合は、テーブルトップのガラ…
- テーブル天板のガラス等のサンプルを送っ…
- テーブルトップに「滑り止めシール」を使…
- テーブルトップに複数のガラスを繋ぎ合わ…
- テーブルの傷や汚れを隠したい場合は、ど…
- テーブルトップ用の「滑り止めシール」は…
- ガラスの「片面研磨」「両面研磨」は、そ…
- 何のためにガラスの表面を磨くのですが?
- キッチン油はねガードのスタンド部分の詳…
- ガラスの「OG加工」のサンプルはあります…
- 厚みが15ミリ以外のガラスに「OG加工」は…
- 図面を送れば、図面通りの「丁番加工」に…
- 強化加工できるガラスの種類を教えてくだ…
- 強化加工出来るガラスの最大サイズは?
- 「飛散防止(透明)」「フロスト(乳白)」以…
- 「フロスト加工」したガラスに「飛散防止…
- すり加工したガラスに飛散防止フィルムを…
- ゴリラガラスのような強度を持ったガラス…
- どのような空気層のペアガラスを作れます…
- 「ペア加工」できるガラスの最大サイズを…
- ガラスの「Vカット加工」で曲線加工は可能…
- 加工可能な「Vカット」の幅はどれくらいで…
- ガラスの「Vカット加工」のデザインデータ…
- 人が乗っても大丈夫な「床用の合わせガラ…
- 強化ガラスやデザインガラスの「合わせガ…
- 円形や異形の「合わせガラス」は作れます…
- 手持ちのフィルム、生地、和紙で「合わせ…
- どんな生地、和紙などの素材だと「合わせ…
- ガラスに塗装した塗料は剥がれませんか?
- 「強化ガラス」を円形にカットできますか?
- 円形ガラスの最大サイズを教えてください
- 型紙製作セットはどうやって注文すればい…
- ガラス板の隣り合う2辺を「斜面取り」する…
- 斜面取りしたガラス板の角は尖っています…
- 角度が45度以外のガラスの斜面取りも可能…
- ガラスの接着が乾燥するまで、どれくらい…
- 強化ガラスに「ウォータージェット加工」…
- 複雑な形状の加工の場合、データはどのよ…
- 文字の形でガラスをくり抜くことはできま…
- デザインガラスに引き手加工はできますか?
- 引き手加工のサイズはどれくらいですか?
- 薄いガラスに引き手加工はできますか?
- 引き手の位置は指定できますか?
- ガラスを固定する金具は販売していますか?
- カラーガラスにもエッチング加工(エッチン…
- 塗装なしエッチング加工の仕上がり、色は…
- エッチング加工したガラスは、外装や水回…
- 送った記録メディアは返してもらえますか?
- ラウンドエッジ加工のRの大きさは指定でき…
- 円形や異形のガラスに「広幅面取り」はで…
- R加工したガラスに「広幅面取り」はできま…
- 広幅面取りの幅の最大サイズは?
- ガラスの「広幅面取り加工」の角度は変更…
- 「すり加工」したガラスに「飛散防止フィ…
- 障子用ガラス(ぼかし山水)のサイズは?
- 障子用ガラス(ぼかし山水)の厚みは?
- アクリル (泡入り) とガラスとの違いは?
- アクリルチェッカーとガラスとの違いは?
- アクリルモールとガラスとの違いは?
- 研磨可能なガラスの厚み、サイズを教えて…
- 表面研磨の精度は?
- 1枚ですが研磨していただくことはできます…
- 有機塗料印刷したガラスは、屋外や水回り…
- オンデマンドフルカラー印刷したガラスは…
- オンデマンドフルカラー印刷は、ガラスの…
- オンデマンドフルカラー印刷は、ガラスの…
- 「下地あり」「下地なし」の違いを教えて…
- 強化ガラスやペアガラス等、違う種類のガ…
- セラミックプリント印刷ガラスは屋外や水…
- セラミックプリント印刷部分は爪などで引…
- セラミックプリント印刷は自分で切断でき…
- ガラス印刷の入稿データの作成は、どうす…
- 「セラミック印刷」は、ガラスの表面・裏…
- ガラスに印刷をすると少し青みがかると聞…
- 他のガラス印刷屋さんよりもなぜ安く印刷…
- 強化ガラスやデザインガラス等、他のガラ…
- ガラスへの印刷サンプルを見せてもらうこ…
- 「有機塗料印刷」の入稿データの作成は、…
- 1枚のガラスに「R加工とC加工を混ぜて加工…
- ガラス印刷の入稿データを作るときのPhoto…
- ガラス印刷の入稿データを作るときのIllus…
- ガラス印刷データを作るための、Illustrat…
- どれくらいのサイズの曲げガラスの加工が…
- 支柱の詳細な寸法を教えてください
- 地震などで落下することはありませんか?
- ホームページ掲載以外のサイズのブラケッ…
- ブラケットの厚みは?
- ブラケットの詳細な寸法を教えてください
- 取り付け方法を教えてください
- 既存で使っているブラケットを、御社の支…
- 支柱は自分で切断することはできますか?
- 強化加工(強化ガラス)になると何が違うの…
- ガラスの角を丸くするR加工のサイズを変更…
- オーディオラック、TVラック用のガラス天…
- ガスコンロを上に敷いても大丈夫な テーブ…
- キッチンカウンターに敷くガラス天板はあ…
- テーブルの縁が丸くなっている場合は、ガ…
- ビニールマットのお手入れ方法を教えてく…
- ビニールマットの素材は何ですか?
- ガラスにどんな曲げ加工ができますか?形…
- 鏡(ミラー)の曲げはできませんか?
- 曲げガラスには穴開け加工は可能ですか?
- 梱包はどのようになって配達されるのです…
- 曲げのRの指定は、外側Rと内側Rのどちらを…
- 曲げ加工の「R」を、どれくらいに指定すれ…
- 同じ曲げガラスを2枚購入するとお安くなり…
- 曲げるガラスの元板のメーカー指定はでき…
- 曲げることができるガラスの種類を教えて…
- エッチング加工したガラスのサンプルを見…
- ガラスのエッチング加工「平彫り」の「番…
- ガラスの「エッチング印刷」の入稿データ…
- ガラスの「エッチング加工」で「ゴールド…
- ガラスの「エッチング加工」で色を付ける…
- ガラスの「エッチング加工」で色を付ける…
- 見積が欲しいのですが、図面を送ってもい…
- 曲げ強化ガラスは作れますか?
- 「強化ガラス」に「切り欠き加工」はでき…
- 1枚のガラスの複数箇所に、切り欠き加工は…
- 「フロスト加工」したガラスに「飛散防止…
- ガラスの一部分だけに「フロスト加工」は…
- 切断できるガラスの最小サイズを教えてく…
- 切断できるガラスの最大サイズを教えてく…
- どんな梱包で発送されますか?
- 同業者(ガラス屋)ですが利用できますか?
- 加工したいガラスが大量にある場合は、安…
- サイトに掲載されていないガラス加工の相…
- 法人ではないのですが、ガラス加工をして…
- ガラスを支給して加工してもらうことは可…
- ガラスの注文と一緒に加工もお願いしたい…
- ガラス加工の見積をしてほしいのですが、…
- 手持ちのガラスに穴あけ加工してもらえま…
- ガラスの「穴あけ加工」に、出張で来ても…
- ガラスの「穴あけ加工」の、穴の「最小サ…
- ガラスの「穴あけ加工」の、穴の「最大サ…
- ガラスの切断面はどうなっていますか?
- バイコールがメーカー生産中止とのことで…
- 耐熱ガラス「バイコール」は、水で急激に…
- 透過率の高い「合成石英ガラス」は取り扱…
- 耐熱ガラス「石英ガラス」は、水で急激に…
- 耐熱ガラス「石英ガラス」は、何色ですか?
- 耐熱ガラス「ファイアライト」の「熱膨張…
- 耐熱ガラス「ファイアライト」は、水で急…
- 耐熱ガラス「ファイアライト」は、自分で…
- 耐熱ガラス「ネオセラム」は、水で急激に…
- 耐熱ガラス「ネオセラム」は、自分で切断…
- 耐熱ガラス「テンパックス強化」は、水で…
- 耐熱ガラス「テンパックス強化」は、薪ス…
- 耐熱ガラス「テンパックス強化」は、自分…
- 耐熱ガラス「テンパックス強化」は、何色…
- 耐熱ガラス「テンパックス」は、強化加工…
- 耐熱ガラス「テンパックス」は、水で急激…
- 耐熱ガラス「テンパックス」は、薪ストー…
- 耐熱ガラス「テンパックス」は、自分で切…
- 耐熱ガラス「テンパックス」は、何色です…
- 「最高使用温度」「常用使用温度」の違い…
- 「強化ガラス」は、水で急激に冷やしても…
- キッチンに油はねガードにガラスパネルを…
- 強化ガラスは、どのような色をしています…
- 防火ガラスは扱っていませんか?
- 耐熱ガラスの梱包はどうなるのですか?
- 引き戸枠は付属していますか?
- テンパードアに使用するガラスのサイズの…
- テンパードアの開閉スピードはどのように…
- フロアヒンジを取り付ける際、注意するこ…
- ドアを閉めた際に、ガラス戸が行き過ぎた…
- ドアを開け閉めする際の、音鳴りやガタつ…
- ガラスが割れた場合、上框(ガラスを固定し…
- ポリカーボネートは防火地域・法22条指定…
- すりガラス風のアクリル板は製作できます…
- フロスト調のアクリルはありますか?
- アクリル板に文字入れ・名入れはできます…
- アクリルも広幅面取り加工は出来ますか?
- アクリルでガラスケース用のガラスは作れ…
- アクリルパイプ(アクリル管・アクリル筒)…
- 円形(円盤)のアクリル板の製作はできます…
- アクリルの球、半球(ドーム状)は製作でき…
- 円柱・角柱のアクリルの製作はできますか?
- アクリル板は、引き戸やスライド扉に使え…
- アクリル板は、窓に使えますか?
- キッチンの油はねガードにアクリル板を使…
- アクリル板は、カーポートの屋根などに使…
- アクリル板は、床材に使えますか?
- 室内ドア・扉には「ガラス」「アクリル」…
- テーブル天板に使用する場合、厚みは何ミ…
- テレビボードの扉としてアクリルを使用す…
- アクリル板の重さはどれくらいですか?
- ガラスよりアクリルが「傷が付きやすい」…
- ガラス色アクリルとガラスの見え方の違い…
- アクリルのサンプルはありますか?
- アクリル板の作り方の違いで「押出板」と…
- なぜアクリルよりガラスの方が価格が安い…
- アクリルのお手入れの仕方を教えてください
- アクリルパイプがどれくらい耐えられるの…
- アクリルパイプのお手入れ方法は?
- アクリルパイプを屋外で使っても大丈夫で…
- ガラスドアに使用するガラスのサイズの決…
- ペアガラスは紫外線カット(UVカット)でき…
- 網入りペアガラス(複層ガラス)はできます…
- すりガラスのペアガラス(複層ガラス)はで…
- 外から見えない目隠しできるペアガラス(複…
- 型板ガラスのペアガラス(複層ガラス)、デ…
- 合わせガラスを使ったペアガラス(複層ガラ…
- 合わせガラスとペアガラス(複層ガラス)の…
- ペアガラスからトリプルガラスに交換でき…
- ペアガラス(複層ガラス)に防犯性能はあり…
- 防犯ガラスのペアガラス(複層ガラス)はで…
- ペアガラス(複層ガラス)には、防音・遮音…
- アタッチメント付きのペアガラス(複層ガラ…
- アルゴンガス入りのペアガラス(複層ガラス…
- ペアガラス(複層ガラス)は、台風で割れる…
- 窓をペアガラス(複層ガラス)に交換・リフ…
- 窓に取り付ける際、どれくらいの幅(スペー…
- 波板ポリカを屋根に敷き詰めます。施工の…
- アイアン窓の設置に来てくれませんか?
- Low-E複層ガラスのLow-Eガラスは、室内・…
- 回収料はどのように支払いますか?
- ガラスを注文せず、回収だけしてほしいの…
- カラーガラスや複層ガラスなど、普通透明…
- タッチ用ガラスとしても使用できますか?
- 耐熱ガラスの「溶融石英ガラス」「合成石…
- 耐熱ガラス「石英ガラス」のガラス管はあ…
- 内窓にした場合、防音効果はどれくらい変…
- 納期はどれぐらいですか?
- ガラスの施工を依頼する方法を教えて。
- 窓枠の幅が狭いのですが、二重窓を取り付…
- 窓枠の内側にカーテンレールが付いていま…
- 内窓の遮音性能はどの程度ありますか?
- 細長い窓に内窓を付けられますか?
- お風呂の窓が内窓(引き違い)を付けられな…
- 楽器の音を外に漏らしたくありません。オ…
- 内窓・防音合わせでデザインガラスを使用…
- グリーン住宅ポイントの使用は出来ますか?
- ガスコンロの横など温度が高い場所に内窓…
- 内窓の組み立て方・取り付け方の説明書は…
- アイアンフレームに裏表はありますか?
- 自分でアイアンフレームにガラスを取り付…
- 納期はどれくらいですか?
- 波板のサイズを教えてください
- 希望サイズぴったりに製作は可能ですか?
- 波板を重ねて取り付けする際はどれくらい…
- 流れ(縦)方向に重ねて取り付ける際はどれ…
- 波板ポリカに雪などの荷重がかかるとどう…
- 穴あけ加工は可能ですか?
- ポリカーボネートのお手入れ方法を教えて…
- 断面に違いはありますか?
- 中空ポリカのお手入れは?
- ポリカーボネートと中空ポリカの違いは?
- 中空ポリカの欠点は?
- 中空ポリカに雪などの荷重がかかるとどう…
- ポリカーボネートの欠点はありますか?
- ポリカーボネートのお手入れ方法を教えて…
- しばらく注文をしていないと会員ランクは…
- 今「会員ランク」がどうなっているか、ど…
- 「ブロンズ」から一気に「ゴールド」「プ…
- ダクト穴付き断熱パネルの厚みについて教…
- 単板のサッシに入れることができますか?
- ダクト穴付き断熱パネルは自分で切断して…
- 穴の位置を指定することはできますか?
- ビスは付属していますか?
- コの字チャンネルを「ビスを使わず」取り…
- 緩衝材は何を使えばいいですか?
- コーキングは何を使えばいいですか?
- ステンレスとアルミ、どちらがオススメで…
- ガラスの大きさの決め方は?
- ホームページに載っている以外の形はでき…
- 高さは、50センチから変更できませんか?
- 強化ガラス仕様にできませんか?
- ガラスで手を切ることはありませんか?
- ガラス以外のご用意がありませんか?
- 焼き場近くでも使えますか?
- 和紙ガラス(和風ガラス)は自分で切断でき…
- 和紙ガラス(和風ガラス)に自分で穴を開け…
- 外装にも使えますか?
- ぼかし山水ガラスは自分で切断できますか?
- 障子用ガラス(ぼかし山水)のサイズオーダ…
- オリジナルの柄の障子用ガラスは作れます…
- 障子用ガラス(すりガラス)が汚れた場合の…
- 泡入りガラスはいつ入荷しますか?代替品…
- 泡入りガラスは自分で切断できますか?
- 泡入りガラスのサンプルはありますか?
- 外装にも使えますか?
- 泡入りガラスをペアガラス(複層ガラス)に…
- 昭和型板ガラスは凸凹していますが、自分…
- 昭和型板ガラスには、穴開けなど加工する…
- 昭和型板ガラスをペアガラス(複層ガラス)…
- 昭和型板ガラスのサンプルはありますか?
- 昭和レトロガラスは自分で切断できますか?
- 昭和レトロガラスの歪みはどんな感じです…
- 外装にも使えますか?
- 昭和レトロガラスをペアガラス(複層ガラス…
- 昭和レトロガラスの強化加工は出来ますか?
- 以前販売されていた昭和レトロガラス フル…
- フローラガラスは自分で切断できますか?
- フローラガラスの柄が少し伸びて見えるの…
- フローラガラスのサンプルはありますか?
- 外装にも使えますか?
- フローラガラスをペアガラス(複層ガラス)…
- モールガラスは自分で切断できますか?
- もっとストライプの幅の狭い(広い)モール…
- モールガラスをペアガラス(複層ガラス)に…
- チェッカーガラスは自分で切断できますか?
- チェッカーガラスに引き手加工をすること…
- チェッカーガラスに穴あけは出来ますか?
- チェッカーガラスをペアガラス(複層ガラス…
- チェッカーガラスのデコボコ面両方にある…
- 2枚のガラスの「柄の目合わせ」をしてい…
- 柄の目合わせは「縦・横両方」可能ですか?
- 目合わせをすべきか悩んでいます
- 窓ガラスにしたいですが、凸凹の面は家の…
- アンティークガラスは凸凹していますが、…
- アンティークガラスには、穴開けなど加工…
- アンティークガラスをペアガラス(複層ガラ…
- カラー合わせガラスは外装で使用できます…
- カラー合わせガラスは自分で切断できます…
- カラー合わせガラスに穴あけは可能ですか?
- カラー合わせガラスを強化ガラスに加工す…
- カラー合わせガラスのサンプルはあります…
- カラーのオーダーは可能ですか?
- ガラスに色ムラや小さなホコリがあるそう…
- カラークリアガラスは自分で切断できます…
- カラークリアガラスに穴あけは可能ですか?
- カラークリアガラスを強化ガラスに加工す…
- カラークリアガラスは外装で使用できます…
- ペアガラスにすることは可能ですか?
- カラークリアガラスのサンプルはあります…
- 塗装カラーガラス「彩」は自分で切断でき…
- 接着剤は何を使えばよいですか?
- 塗装カラーガラスを取り付ける下地の色は…
- 塗装カラーガラス「彩」に穴あけは可能で…
- カラーガラス「彩」を強化ガラスに加工す…
- 塗装カラーガラス「彩」を外装や水周りに…
- 塗装カラーガラス「彩」のサンプルはあり…
- カラーのオーダーは可能ですか?
- カラーガラス ラコベルプリュムは自分で切…
- カラーガラス ラコベルプリュムに穴あけは…
- カラーガラス ラコベルプリュムを強化ガラ…
- カラーガラス ラコベルプリュムを外装や水…
- カラーガラス ラコベルは自分で切断できま…
- カラーガラス ラコベルに穴あけは可能です…
- カラーガラス ラコベルを強化ガラスに加工…
- カラーガラス「ラコベル」のサンプルはあ…
- カラーガラス ラコベルを外装や水周りに使…
- ビトロカラーガラスは自分で切断できます…
- ビトロカラーガラスに穴あけは可能ですか?
- ビトロカラーガラスを強化ガラスに加工す…
- ビトロカラーガラスのサンプルはあります…
- ビトロカラーガラスを外装や水周りに使う…
- ホワイトガラスは自分でカット出来ますか?
- ホワイトガラスは屋外で使えますか?
- ホワイトガラスに穴あけは可能ですか?
- セラミックプリントガラスは自分で切断で…
- セラミックプリントはガラスの両面に印刷…
- プリント部分は爪などで引っ掻くと剥がれ…
- ストライプ柄を横向き(ボーダー柄)として…
- セラミックプリントガラスを外装や水周り…
- セラミックプリントガラスは水に濡れると…
- カラードアンティークは自分で切断できま…
- カラードアンティークに穴あけは可能です…
- カラードアンティークの製作可能な最大サ…
- カラードアンティークのサンプルはありま…
- カラードアンティークは外装にも使えます…
- カラードアンティークをペアガラス(複層ガ…
- 熱線吸収ガラスは自分で切断できますか?
- 熱線吸収ガラスに穴あけは可能ですか?
- 熱線吸収ガラスを強化ガラスにすることは…
- 熱線吸収ガラスをテーブルの天板として使…
- サンゴバン型板ガラスは自分で切れますか?
- ヨーロッパデザインガラスのサンプルはあ…
- デザインガラスには、穴開けなど加工する…
- お風呂の窓に使いたいのですが、耐熱温度…
- デザインガラスをペアガラス(複層ガラス)…
- ミストガラスは自分で切断できますか?
- 型板ガラスの耐熱温度は?お風呂でも使え…
- ミストガラスを合わせガラスに出来ますか?
- もっとオシャレな型板ガラスはありません…
- 抗菌ガラスはペアガラスに出来ますか?
- 抗菌効果のある面は、片面ですか?両面で…
- 抗菌ガラスは合わせガラスに出来ますか?
- メンテナンス上の注意はありますか?
- 抗菌ガラスを「まな板」として使えますか?
- カタログはありませんか?
- 光触媒ガラスを強化ガラスに出来ますか?
- 光触媒ガラスはペアガラスに出来ますか?
- 光触媒ガラスは合わせガラスに出来ますか?
- 光触媒ガラス(バイオクリーンガラス)は自…
- 遮光ガラスで皆既日食など、太陽を観るこ…
- 溶接で使う場合、光の色は何色に見えます…
- 遮光ガラスはどのような溶接に向いていま…
- プロタンというガラスは取り扱っています…
- 遮光ガラスの伝導性、吸収性能を教えて下…
- 鉛ガラスの色が「黄色」に見えますが透明…
- 鉛ガラス(放射線遮蔽ガラス)は、自分で切…
- 鉛ガラス(放射線遮蔽ガラス)は穴を開ける…
- 鉛ガラス(放射線遮蔽ガラス)の厚さと鉛当…
- 鉛ガラス(放射線遮蔽ガラス)の性質は?
- 鉛ガラス(放射線遮蔽ガラス)の透過率は、…
- 鉛ガラスはどのように捨てればいいですか?
- 円形よりも四角形の方が高いのはなぜです…
- 耐熱温度が高いようですが、耐熱ガラスと…
- サファイアガラスの物理的特性は?
- 腕時計に使われるサファイアガラスのサイ…
- サファイアガラスにできる加工は?
- ジェムカラーは自分で切断できますか?
- 樹脂ガラスは自分で切断できますか?
- 樹脂ガラスと型板ガラス(梨地)に見え方の…
- 切断面はどのようになりますか?
- 温度変化で伸縮しますか?
- 耐熱温度はどれくらいですか?
- レオフレックスはどの様な加工処理が出来…
- レオフレックスの特性は?(その他の化学強…
- レオフレックスを大量に欲しいのですが、…
- Dragontrail(ドラゴントレイル)は、自分で…
- Dragontrail(ドラゴントレイル)は穴を開け…
- Dragontrail(ドラゴントレイル)の透過率は…
- Dragontrail(ドラゴントレイル)の性質は?
- ゴリラガラスの「未強化品」はありますか?
- ゴリラガラス3は、自分で切ることはできま…
- ゴリラガラス3に、穴を開けることはできま…
- ゴリラガラス3の透過率は、どれくらいです…
- ゴリラガラス3の性質は?
- ゴリラガラス3の電気特性は?
- 化学強化ガラスは、自分で切ることができ…
- 化学強化ガラスは穴を開ける事ができます…
- 化学強化ガラス特性は?(ドラゴントレイル…
- イーグルXGの光学特性を教えてください
- イーグルXGの力学的、機械的特性は?
- イーグルXGの熱的特性を教えて下さい
- 薄板ガラスは表面研磨はできますか?
- 更に薄いガラスはありませんか?
- 薄板ガラスの価格の見方がわかりません
- 薄板ガラスは強化加工することが出来ます…
- 耐熱ガラス「石英ガラス」は自分で切断で…
- 耐熱ガラス「石英ガラス」のサイズオーダ…
- 耐熱ガラス「溶融石英ガラス」「合成石英…
- 溶融石英ガラスと合成石英ガラスの純度の…
- 溶融石英ガラスと合成石英ガラスの性質の…
- 耐熱性を重視する場合、どちらの石英ガラ…
- 薪ストーブの覗き窓は、耐熱温度500℃の「…
- 耐熱ガラスのガラスの色は?
- 耐熱ガラスは、水で急激に冷やしても割れ…
- 耐熱ガラスは強化ガラスに出来ますか?
- 耐熱ガラス「テンパックス」の透過率は、…
- 防音ガラスをペアガラスにすることは出来…
- 夜景専用ガラス TEIEN(庭園)は自分で切断…
- 夜景専用ガラス TEIEN(庭園)を強化ガラス…
- 夜景専用ガラス TEIEN(庭園)に穴あけなど…
- 見えないガラスは外装で使えますか?
- 見えないガラスと低反射ガラスの違いは?
- 見えないガラスの反射率は?
- 見えないガラスのサンプルはありますか?
- 見えないガラスは自分で切断出来ますか?
- 見えないガラスのクリーニング方法は?
- クリアサイトⅡは自分で切断できますか?
- 額縁に使いたいのですがクリアサイトⅡを使…
- クリアサイトⅡを強化ガラスにすることは出…
- クリアサイトⅡに穴あけなどの加工は出来ま…
- 写真撮影や映像の撮影時の反射を抑えるこ…
- 自分で交換できますか?
- 既存の窓ガラスのサイズの測り方は?
- 「シルバーのキャップ」みたいな物がつい…
- 真空ガラスに、ゴム(グレチャン)は付いて…
- 自分で交換できますか?
- 既存の窓ガラスのサイズの測り方は?
- サッシの開口サイズが(9ミリなのか、11ミ…
- ガラスにゴムパッキン(グレチャン)は付い…
- ペアガラス(スリムタイプ)に遮熱効果はあ…
- Low-eってどう読めばいいのですか?
- ステンドグラスやデザインガラスをペアガ…
- 異形の(形が変わった)ペアガラスは作れま…
- 穴の開いたペアガラスは製作できますか?
- ペアガラスは自分で切断できますか?
- 複層ガラス(ペアガラス)と防犯ガラスは同…
- 床用ガラスは自分で切断できますか?
- ガラスの上でジャンプしても割れませんか?
- 床用ガラスの透け具合はどんな感じですか?
- 床ガラスの施工の詳細を教えてください
- 床ガラスを支える「受け」は、どれくらい…
- 保険付き防犯ガラス保証内容を教えて下さい
- フロストガラスなど違うガラスを防犯・防…
- 防犯ガラスをペアガラス(複層ガラス)に出…
- 防犯ガラスを床に使う事はできますか?
- 防犯ガラスは自分で切断できますか?
- 防犯ガラスは屋外でも使用できますか?
- 合わせガラスは自分で切断できますか?
- 合わせガラスは屋外でも使用できますか?
- フロストガラスなど違うガラスを合わせる…
- 合わせガラスを床に使う事はできますか?
- ミラーガラス(プライバシーガラス)は裏と…
- 遮熱ガラス(熱線反射ガラス)は裏と表があ…
- ミラーガラス(プライバシーガラス)は自分…
- 遮熱ガラス(熱線反射ガラス)は自分で切断…
- 透過率の「8%」「20%」で、どれくらい違い…
- プライバシー効果は昼夜逆転するって本当?
- ミラーガラス(プライバシーガラス)をペア…
- 遮熱ガラスに断熱効果はありますか?
- 高透過ガラスは自分で切断できますか?
- 高透過ガラスを曲げガラスにすることは可…
- 高透明ガラスとは高透過ガラスのことです…
- フロストガラスは自分で切断できますか?
- 「すりガラス」「フロストガラス」は、ど…
- フロストガラスをペアガラス(複層ガラス)…
- フロストガラスの耐熱温度は?
- すりガラスは自分で切断できますか?
- すりガラスを強化ガラスにすることはでき…
- すりガラスを外装にも使えますか?
- すりガラスが汚れた場合の掃除方法は?
- すり加工の「グラデーション幅」を指定す…
- 網入りガラスはワイヤーが入っていますが…
- 網入りガラスを「強化ガラス」にできます…
- 網入りガラスをペアガラス(複層ガラス)に…
- 型板ガラスは自分で切断できますか?
- 型板ガラスの耐熱温度は?お風呂でも使え…
- 型板ガラスをペアガラス(複層ガラス)に出…
- オシャレな型板ガラスはありませんか?
- 型板ガラスを強化ガラスにすることは出来…
- 「強化ガラス」は自分で切断できますか?
- 強化ガラスに穴あけなどの加工は出来ます…
- 「強化ガラス」と「防犯ガラス」は同じで…
- 強化ガラスと普通のガラスを割らずに見分…
- フロートガラスの耐熱温度は?
- 20ミリ以上の厚みの厚いガラスは作れます…
- フロートガラスの透過率は、どれくらいで…
- 「確認用の図面」を作ってもらえますか?
- 「キリのよいサイズ」で注文したほうが価…
- 「寸法公差」によってガラスサイズの仕上…
- 処分したいガラスを引き取ってもらう方法…
- テーブルのガラスをずれないようにできま…
- 商品の見積りをする方法を教えて。
- 注文したいのですがどうすればいいですか?
- 「厚み」をどう決めればいいのかわかりま…
- 施工や交換・採寸に出張で来てもらうこと…
- 工具は販売していますか?
- 「L字アングル」や「コの字チャンネル」は…
- ペアガラスってなんですか?
- ガラスに「四角形の穴」をあけることは可…
- 特殊なガラスなのですが穴を開けることは…
- 自分でガラスを交換したいのですがやり方…
- ガラスの「取り付け・交換」に来てもらえ…
- サッシの周りにゴムみたいな物があります…
- 「サッシに隠れている部分」のガラスサイ…
- 無反射ガラスは自分で切断できますか?
- 反射防止ガラスは「額縁の反射防止ガラス…
- ガラスと写真がくっつくことはありません…
- 素人ですが交換は出来ますか?
- どの商品を選べばいいのか迷いますが相談…
- 側面を丸くしたり、装飾したりすることは…
- 楕円形やオーバル(小判形)など複雑な形状…
- ガラスの送料、梱包の料金が知りたいです
- 保証期間を過ぎるとどうなりますか?
- ガラスを支給して加工してもらうことは可…
- ガラスを固定する金具は販売していますか?
- 「グラデーション幅」を指定することは可…
- 飛散防止フィルムは、何℃まで耐えられます…
- 子供がいるのですが手を切ったりしないか…
- 1辺だけ違う加工(切断面の処理)にすること…
- 型紙はどんな紙にとればいいですか?
- 小判形のガラスを注文する場合、図面や型…
- ガラスを支給して加工してもらうことは可…
- ガラスの「コーナーR加工」の「R」の大き…
- ガラス店(サッシ店)でも法人登録は可能で…
- 個人事業主でも法人登録は可能ですか?
- 「デザインガラスサンプル・アソートボッ…
- 出荷証明書を出してもらう方法を教えて。
- 領収書発行の手続きを教えて。
- 「キリのよいサイズ」や「定寸サイズ(914…
- 定寸サイズ(914×1829ミリ等) で注文したほ…
- 万が一、商品到着後にひび割れなどあった…
- サイズを間違えて注文してしまいました
- どんな加工やどんな形まで出来るのですか?
- 板ガラスを裁断のみで注文した場合、手が…
- ガラスのサンプルはありますか?
- ガラスの厚みを測る方法はありますか?
- ガラスを処分したいのですが引き取りに来…
- ガラス用の「金物」や「工具」などは販売…
- 施工業者と直接やりとりしてもらう方法を…
- ガラスを持ってきて、設置していただきた…
- ガラス1枚でも送ってもらえますか?
- 短納期での発送は可能ですか?
- 商品を取りに行くので、送料を安くできま…
- 急ぎなのですが、すぐに送ってもらえます…
- メールマガジンを停止したいのですがどう…
- デザインガラスは外装にも使えますか?
- デザインガラスのサンプルはありますか?
- 登録したパスワードを忘れてしまいました…
- 複数枚購入予定なのですが安くなりますか?
- カート表示サイズよりも大きいサイズのガ…
- 法人会員のログインはできますか?
- 片面に凸凹のあるガラスをカットする場合…
- デザインガラスを注文したいのですが、専…
- デザインガラスで角の丸い水槽を作っても…
- デザインガラスに「ステンド加工」はでき…
- デザインガラスに「飛散防止フィルム」を…
- デザインガラスはガラスカッターでカット…
- アルトドイッチェKとフロートガラスを合わ…
- アクアガラスは取り扱っていますか?
- アルトドイッチェKは、両面に凸凹の柄があ…
- アルトドイッチェKを、柄のうねりの多い箇…
- 中国産のモールガラスはありますか?また…
- 外部サッシにモールガラスを使うと割れや…
- 「DNA-0819」「CTE-001」のガラスの色は違…
- 「DNA-0189」「CTE-001」の無料レンタルサ…
- ベッドの桟をフロストガラスで隠したいの…
- 海中にいるイメージのガラスで強度が強い…
- どのように業者に希望のガラスを伝えれば…
- 2枚のデザインガラスの柄の目合わせをして…
- 波ガラスは自分で切断できますか?
- 波ガラスに穴あけは可能ですか?
- 波ガラスをペアガラスにすることは可能で…
- 波ガラスのサンプルはありますか?
- 一般的な建具(室内ドア・内装窓)のガラス…
- ガラスをコーキングで固定する場合、クリ…
- サンゴバンガラスに穴あけは可能ですか?
- サンゴバンガラスをペアガラスにすること…
- サンゴバンガラスのサンプルはありますか?
- 購入回数・購入金額の累計は何年間有効で…
- 紹介キャンペーンによって割引かれた金額…
- 紹介キャンペーンが利用できないケースは…
- レトロなデザインのすりガラスはあります…
- 和紙ガラス「極」のサンプルはありますか?
- ガラスの青みが気になります
- 和紙は両面に貼ってあるのですか?片面で…
- 和紙ガラスを強化ガラスに加工することは…
- 自由なサイズでデザインガラスを注文でき…
- 申請する書類として見積書が必要です。作…
- ガラス店(サッシ店)ですが、法人登録は可…
- ステンドグラスの描線は、裏から見た時ど…
- 納期はどのくらい掛かりますか?
- 価格の参考価格を教えてください (どのく…
- 参考価格を教えてください (どのくらい安…
- ステンドグラス風ミラーの表面はどんな感…
- どんな図でもステンドグラスを製作するこ…
- 円形(丸形)のステンドグラスは作れますか?
- 円形(丸形)のステンドミラーは作れますか?
- 色の種類はどれくらい選べますか?
- 【ステンドグラスの配色やデザインができ…
- レトロ感を高めた雰囲気のあるステンドグ…
- レトロ感を高めた雰囲気のあるステンドミ…
- 枠を付けることはできますか?(枠を付ける…
- 取り付け方を教えて下さい
- 木枠の材質はなんですか?
- 製作できる枠の最大サイズは?
- ステンドの表面はどんな感じ?(両面描線は…
- ラインアートの表面はどんな感じ?(両面描…
- 割れないステンドグラスはありますか?
- 柄の色を変える事はできますか?
- ステンドグラスの柄に色を付けることはで…
- ガラスの種類 (FL3,FL5,F4K) の違いが分か…
- ステンドグラスの描線を黒以外で作ること…
- ステンドグラスの柄の縮小、拡大はできま…
- 縦横比を維持したまま拡大・縮小すること…
- ステンドグラスの元板(規格サイズ)からの…
- ステンドグラスの寸法公差(サイズの誤差)…
- ステンドグラスの取り付け方を教えてくだ…
- 枠を付けることはできますか?
- ステンドグラスは地震で割れませんか?
- ステンドグラスを「強化ガラス」にできま…
- ステンドグラスを「合わせガラス」にでき…
- ステンドグラスを「複層ガラス(ペアガラス…
- ステンドグラスのサンプルはありますか?
- ステンドグラスのベースに使えるガラスの…
- ステンドグラス風パネルは自分で切断でき…
- ステンドグラスは、外装にも使えますか?
- ステンドグラス風パネルは、穴開けなど加…
- 納期はどのくらい掛かりますか?
- 木枠のカラーは3色だけですか?
- 注文のサイズはどこを指定すればいいです…
- 木枠の幅のサイズは?
- 木枠の厚みは?
- 木枠の収まりはどうなりますか?
- 枠の幅や厚みを変えてもらうことはできま…
- ステンドグラスの「枠付き」の注文方法・…







































































































